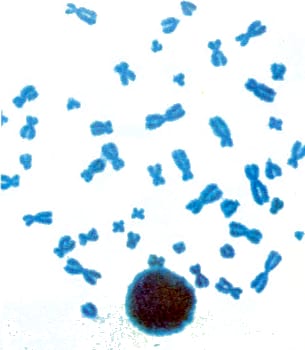

El universo en explosión
Nigel Henbest
«El objeto de estudio de la humanidad debe ser el hombre», escribió Alexander Pope en el siglo XVIII. Pero, por definición, la humanidad es una especie inquisitiva: nunca hemos dejado de estudiar nuestro entorno. No podemos comprender nuestras vidas sin conocer cómo y por qué comenzó la vida o, al menos, sin formularnos la cuestión. Esto nos conduce al Sol, y éste, a su vez, al Universo entero. Por fin ahora, en nuestro siglo, están comenzando a llegar las respuestas.
Hay que decir también que la humanidad es una especie instintivamente científica. Desde tiempos remotos hemos intentado registrar y clasificar las cosas que vemos, como si comprendiéramos que ésta es la única forma de conocerlas, y así es como las ideas de los primeros científicos han sobrevivido para ser confirmadas. La filosofía antigua no conocía límites; sus especulaciones abordaban con libertad áreas que ahora describiríamos como científicas. Epicuro (341-271 aC) adquirió reputación de ateo y hedonista porque fue un materialista, pese a que el autocontrol y la moderación fueran el centro de su filosofía. También fue quien formuló una de las primeras teorías atómicas. Empédocles (siglo V aC) enseñó una teoría de cuatro elementos fundamentales; seguramente no le hubiera desagradado nuestra teoría de cuatro fuerzas fundamentales.
Kepler dio la primera descripción sustancialmente correcta del sistema solar en 1609; formuló las leyes del movimiento planetario, que posteriormente Newton demostró como consecuencia de la gravitación. En su Armonía del mundo (1619) examinó y comparó los vínculos matemáticos existentes tanto en órbitas planetarias como en intervalos musicales y en geometría. Digamos que, aunque la fuerza impulsora de su búsqueda era religiosa, fue perseguido precisamente por las autoridades religiosas de su tiempo. Lo cierto es que una gran mente suele detentar ideas religiosas que trascienden a sus relativamente supersticiosos con temporáneos.
Ahora, las cosas son así: todo el conocimiento debe estar relacionado. Los físicos creían en algo llamado éter; opinaban que nada, ni siquiera la luz, podía viajar a través del vacío; postulaban que el espacio debía estar lleno de una misteriosa sustancia con propiedades tan contradictorias como la de ser más rígida que el acero, pero imposible de detectar. Un experimento destinado a comprobar la existencia de esta sustancia fue lo que condujo a la teoría de la relatividad de Einstein. La idea de éter había sido descartada, aunque muchos científicos no renunciarían a ella hasta el día de su muerte. De forma similar, Max Planck, cuya teoría cuántica contribuyó a alterar nuestro conocimiento de la física tanto como la de la relatividad, empleó el resto de su vida en intentar reconciliar sus propios descubrimientos con la física clásica que amaba. Queda claro que cualquier teoría se puede modificar o descartar a la luz de una evidencia nueva.
El camino del conocimiento descrito por las grandes mentes de la historia tiene, hoy, una continuación en Stephen Hawking, de la Universidad de Cambridge, y en otros muchos científicos de todo el mundo, auxiliados por técnicas y equipos de asombrosa sofisticación. La elegancia filosófica y matemática de sus descubrimientos será el legado más importante que podamos hacer a nuestros descendientes. Sin embargo, los físicos también dicen que existe un límite natural a lo que podemos conocer: sus teorías deben dar cabida a la incertidumbre, así como a los sucesos que exigen la supresión de la incredulidad. El auténtico hombre de ciencia aprende a ser humilde ante la Creación.
Esto no habría sorprendido al teólogo Teilhard de Chardin. «Todo lo que se eleva debe converger», escribió, pensando que los caminos del conocimiento no siempre discurren paralelos, sino que conducen hacia arriba y se encuentran. Este libro es un resumen del conocimiento actual de la Creación y es, también, un tributo a la majestuosa belleza del Universo y a la belleza de la Verdad, lo que quizá sea lo mismo.
Capítulo 1
La exploración del Universo
Todos los esfuerzos científicos contribuyen a la exploración del Universo, porque por definición el Universo lo es todo. En la actualidad, cada científico es un especialista cuyos descubrimientos confirman el trabajo de los demás.

La salida del Sol sobre el mar evoca los cuatro «elementos» de los antiguos filósofos: tierra, agua, aire y fuego. Los descubrimientos modernos han puesto de manifiesto las vinculaciones entre estos diferentes tipos de materia, nos han mostrado por qué el Sol se «quema» tan intensamente y nos han enseñado que nuestra Tierra es sólo un pequeño planeta en un Universo inmenso.
§. El arte de la ciencia
§. Cada vez más complejo
§. El momento del descubrimiento
§. De los púlsares a las partículas
§. Los elementos: las sustancias básicas
§. Los átomos: la base de los elementos
§. Más allá de los átomos: las partículas
§. Partículas de partículas
§. Las cuatro fuerzas
§. Las leyes de la Naturaleza
No es fácil concentrarse descansando en una playa en un día de verano. Los pensamientos acuden a nuestra mente, y salen de ella crispados por los gritos de los niños y sosegados por el latido del mar. En la playa todos somos filósofos. Nos preguntamos vagamente por qué el Sol calienta tanto y por qué el mar está tan frío, y no pocas veces esta idea se diluye antes de que logremos dar con una respuesta. Insistamos, sin embargo, en atrapar algunas de estas cuestiones antes de que se desvanezcan.
¿Por qué el Sol es caliente y el mar frío? ¿Por qué el agua es líquida y sólida la arena? ¿De qué están hechos? ¿Qué es el aire, esa sustancia invisible que es preciso respirar para poder vivir? ¿Cuál es la diferencia entre vida y no vida? ¿Existen otras criaturas vivas en algún remoto lugar del Universo? ¿Tiene un límite el Universo? ¿Cuánto hace que comenzó y cómo?
Las respuestas a estos interrogantes, que todos nos hemos formulado, se pueden encontrar en una enciclopedia o en un libro de consulta. Pero este libro no es una enciclopedia y ni siquiera es, primordialmente, una típica obra de consulta. Es una exploración. Exploraremos la totalidad del Universo, desde el grano de arena hasta el resplandor del relámpago, desde el átomo hasta el quásar, y nos preguntaremos: ¿Por qué esto es así? El conocimiento actual del hombre es sorprendentemente completo, aun cuando explique lo muy grande en términos de lo muy pequeño, o lo muy poderoso en términos de lo inimaginablemente débil. De paso, arrojaremos un poco de luz acerca de cómo el hombre ha satisfecho su instinto inquiridor y se ha apropiado de los secretos que oculta la Naturaleza.
§. El arte de la ciencia
Generaciones de hombres y mujeres han empleado vidas enteras en la búsqueda de soluciones a las aparentemente incontestables cuestiones acerca del Universo, cuestiones que constituyen la esencia de la ciencia. Comprender el Universo y todo lo que en él hay es uno de los principales objetivos del hombre. La búsqueda de la ciencia (que literalmente significa «conocimiento») es, a su manera, arte al igual que la composición de una gran sinfonía, y, para el investigador que accede al conocimiento, está llena de infinita fascinación. Muchos son los que sienten que los descubrimientos científicos del siglo XX serán contemplados por las generaciones futuras como el supremo logro estético de nuestro tiempo.
A pesar de esto, la «ciencia» ha solido tener mala prensa: los científicos son popularmente considerados como fríos e insensibles, al mismo tiempo que se ven sus descubrimientos como una amenaza [rara nuestra existencia. Tales actitudes forman parte de una reacción a la euforia de los años 1950 y 1960, cuando parecía que los descubrimientos científicos iban a poder resolver todos los problemas del mundo. Sin embargo, los fallos han tenido lugar fundamentalmente en los dominios de la política y de la economía: a menudo no es rentable, financiera o políticamente, la utilización de ciencia y tecnología ya disponible. Por el contrario, las naciones «desarrolladas» han hecho suyo, pese a su descomunal coste, el terrorífico poder destructivo de la energía atómica de la bomba H.
Es triste que el nombre de la ciencia quede a menudo ensombrecido por asociación con el viejo monstruo, el mal empleo del conocimiento.
Ciertamente, sería demasiado superficial afirmar que los científicos sólo están para efectuar descubrimientos, y el resto de nosotros para decidir si hay que emplearlos en función del bien o del mal. En el momento presente existe una controversia en el mundo de la ciencia a propósito de la «ingeniería genética» (investigación sobre la recombinación del ADN, por darle su denominación exacta). En el futuro, ella nos permitiría instrumentar las células humanas para determinar el sexo de nuestros hijos, pero igualmente posibilitaría que laboratorios estatales generasen miles de superhombres idénticos que sirviesen como soldados. Incluso en la actualidad existe el riesgo de que la fuga de una sola célula peligrosamente mutada, microscópicamente diminuta, pueda desencadenar una epidemia irreversible que ponga en peligro la vida humana en este planeta. Los científicos que trabajan en los laboratorios de ingeniería genética han contraído una responsabilidad con toda la humanidad.
No obstante, al hombre le consume la pasión de descubrir. El científico siempre estará a nuestro lado buscando el conocimiento, a su manera; pero tan pronto como comencemos a preguntarnos acerca del mundo real, nosotros mismos nos veremos sumidos en la búsqueda de la ciencia.
§. Cada vez más complejo
Desgraciadamente, el ritmo adquirido por la investigación científica lleva a que el científico profesional se aleje paulatinamente de nosotros. Hace uno o dos siglos, una persona instruida podía leer en revistas informes de primera mano acerca de la última investigación científica y comprenderlos; a menudo se publicaban resultados científicos revolucionarios en libros dirigidos al lector en general, por ejemplo, El origen de las especies de Charles Darwin. Hoy, las revistas son tan especializadas que la mayoría de los artículos de investigación sólo los comprenden quienes poseen años de experiencia, y esto sólo si pertenecen a su propio campo. Un astrónomo graduado encuentra tanta dificultad en abordar una revista de biología como cualquier otra persona.
Es importante llenar el vacío que existe entre el quehacer científico y el público. Hasta nosotros llegan muchos resultados de la ciencia y la tecnología actuales: sartenes que no se pegan, calculadoras de bolsillo y relojes digitales, por no citar más que unos pocos. Sin embargo, lo que realmente hacen los científicos, y cómo lo hacen, es un misterio para la mayoría de nosotros. Uno de los problemas consiste, simplemente, en que hay demasiado por conocer. El genio inglés, sir Isaac Newton, afirmaba, hablando de sus notables logros, que si había visto más allá que otros hombres era porque se había encaramado sobre hombros de gigantes. La asimilación de todo el conocimiento de las generaciones precedentes, el de los antiguos gigantes de la ciencia, así como el intento de hallar la mejor forma de indagar en el conocimiento, son procesos que llevan años.

Naves espaciales no tripuladas exploran regiones del sistema solar que el hombre aun no ha alcanzado. Esta nave espacial Viking, lanzada desde Cabo Cañaveral en 1975, contiene un laboratorio automático para buscar vida en Marte.
La antigua máxima escolar de que la ciencia consiste en una memorización de hechos es una etapa necesaria en el camino hacia las fronteras del conocimiento; el que la experiencia escolar sea a veces aburrida no es algo totalmente imputable al método científico.
§. El momento del descubrimiento
Sin embargo, los científicos de vanguardia consideran que la naturaleza de la ciencia tiene un matiz más vivo. Una vez en posesión del conocimiento anterior, el asalto a los misterios de la Naturaleza se convierte en un acontecimiento genuinamente creativo. Cualquiera que sea el campo de investigación, existen siempre áreas parcialmente inexploradas que contienen cabos sueltos que es preciso anudar. El momento crucial para cualquier científico es aquél en el que esos hechos inexplicables se contemplan como parte de un todo: al igual que la resolución de las disonancias en música, tales hechos constituyen etapas hacia una visión más armoniosa. La luz puede hacerse en el momento más inesperado: para Arquímedes, en el baño (¡Eureka!), y, para el químico Kekulé, mientras viajaba soñoliento en un autobús y vio en su sueño ligero cómo se formaban las moléculas de benceno. Desde un punto de vista retrospectivo, la nueva teoría siempre parece obvia, al modo de la solución de un crucigrama, pero esto sólo es una pequeña parte de la historia. La inspiración únicamente llega tras meses o años de trabajo, y debe ir seguida de muchos experimentos que confirmen las nuevas ideas.
El resultado es un fragmento del conocimiento, un rincón más que se ilumina en el Universo.
En su mayor nivel, la ciencia es una actividad humana increíblemente excitante, y son los años de estudio, más que los hallazgos, los que conducen a ella. Las auténticas revoluciones sólo las consiguen científicos de enorme imaginación, capaces de ver a través de las complejidades de un resultado experimental, o bien de la enrevesada trama de teorías previas, seleccionando únicamente los aspectos más importantes. «Frío» e «insensible» son palabras que difícilmente sirven para describir a un científico eminente, quien, más bien, es un buscador apasionado del conocimiento, un soñador inspirado.
Pero tras la excitación que produce un nuevo descubrimiento, una revolución científica, no siempre resulta fácil explicar su importancia al mundo en general. En realidad, es más fácil decir que un grupo de científicos ha culminado felizmente su investigación que explicar sus progresos al público, aun cuando es éste quien paga la investigación. En astronomía, esto sucede de una forma un tanto diferente que en otras ciencias (a excepción de la biología), ya que los descubrimientos astronómicos son comparativamente más fáciles de comprender. No es demasiado difícil intuir que los pulsares, objetos celestes que emiten una señal de radio con un «tic-tac» regular, son diminutas estrellas que giran rápidamente; y el descubrimiento figura en todos los periódicos. Sin embargo, cuando los físicos encuentran un cuarto quark uno de los pilares básicos que constituyen la materia, no hay mayor eco en la prensa. Algunas nociones de astronomía forman parte del conocimiento general, pero los libros científicos de divulgación y los textos escolares no recogen la explosión de conocimientos del mundo subatómico en los últimos años.
§. De los pulsares a las partículas
Ciertamente, existe tanta agitación en el mundo de lo inimaginablemente pequeño como en el de los astrónomos. Los físicos creen que pueden decir por fin cuáles son la mayoría de las partículas fundamentales los pilares básicos más pequeños que constituyen el Universo y por qué se comportan como lo hacen. Pueden mostrar cómo estas partículas (incluyendo los quarks a los que antes nos referíamos) constituyen los átomos de la materia habitual, mientras que las fuerzas existentes entre las partículas dan lugar a la energía eléctrica, a la bomba H y a la gravedad que nos mantiene sobre la superficie de la Tierra.
Quizás el hecho más sorprendente de todos sea que la materia es la misma, y se comporta de la misma forma, en todo el Universo. Los descubrimientos de los astrónomos se pueden explicar con el mismo tipo de partículas, las mismas fuerzas y las mismas leyes de la Naturaleza que los físicos encuentran en un laboratorio terrestre.

Un alquimista del siglo XV y sus ayudantes en plena tarea. Los modernos laboratorios de química cuentan con instrumental desarrollado a partir del de los alquimistas, a ejemplo del alambique de la parte inferior izquierda.
Esto resulta aún más asombroso cuando se conocen algunos de los extraños objetos con que en la actualidad se enfrentan los astrónomos: estrellas enteras condensadas en una bola de tan sólo unos kilómetros de diámetro; agujeros negros donde la gravedad es tal como para arrancar la materia del resto del Universo; el violento holocausto del corazón de una estrella; y la persistencia de ondas de radio desde el nacimiento del propio Universo.
Aunque este libro se refiere al Universo, no trata simplemente del Universo que contemplan los ojos de los astrónomos: los nuestros harán una exploración diferente. A lo largo del mismo veremos que todas las cosas del Universo están constituidas por unas cuantas partículas fundamentales que interaccionan entre sí por medio de unas pocas fuerzas, e incluimos a objetos cotidianos como la tiza y el queso, los balones de playa y los equipos de televisión; objetos mucho más complicados a los que conocemos como «vivos»; y, luego, el resto del Universo que se extiende mucho más allá de nuestro entorno, que, aunque nos parezca importante, no deja de ser un pequeño nicho. Al preguntarnos por qué el Universo es como es, nos encontraremos con que la ciencia actual posee un conjunto notablemente consistente de soluciones, pero también con que existen aún muchas cuestiones a las que el científico ha de responder. Parte de nuestra búsqueda contemplará algunos caminos aún inexplorados, y nos maravillaremos de cómo ellos pueden modificar nuestras ideas acerca del Universo.

El dispositivo de sir Humphry Davy para análisis de gas: sus investigaciones sobre gases condujeron al descubrimiento de la lámpara de, seguridad de los mineros. Los descubrimientos de los elementos sodio, boro y potasio son otras de sus muchas realizaciones.
§. Los elementos: las sustancias básicas
Los antiguos griegos fueron los primeros que intentaron encontrar soluciones a los enigmas de la Naturaleza, pero carecían de instrumentos precisos con los que comprobar sus teorías, y sus ideas generalmente se sostenían o se derrumbaban por su aceptabilidad filosófica más que por su confirmación experimental. La más avanzada de sus teorías fue la propuesta por el filósofo y místico Empédocles en el siglo V aC, que pensó que el Universo estaba compuesto por cuatro elementos - tierra, agua, aire y fuego y que los diferentes tipos de materia que conocemos diferían simplemente por la proporción de los elementos que los constituían. En la Tierra nunca se podrían encontrar estos elementos en estado puro: por ejemplo, el agua ordinaria estaría fundamentalmente, pero no por completo, compuesta del elemento «agua». Además de sus elementos,-el mundo de Empédocles contenía dos fuerzas opuestas, amor y odio, que gobernaban tanto los objetos inanimados como las criaturas vivas.
Por cierto que existe una lógica en su esquema, en especial en su noción de que los elementos se presentan naturalmente en un criden determinado: la tierra está abajo; el lugar natural del agua se halla sobre ella; más arriba se encuentra el dominio del aire; y, por encima de todos, aparece el fuego. Como cada elemento tiende a su propio lugar, un trozo de tierra cae a través del aire y del agua, y las gotas de agua caen a través del aire; mientras que las burbujas de aire suben a través del agua y el fuego se eleva en el aire. Los dioses (si existen) deben vivir en la ardiente capa que se encuentra por encima de todas, y una leyenda sostenía que Empédocles, tras retirarse a una vida solitaria en las altas inmensidades del monte Etna, se creyó él mismo un dios y se arrojó al ardiente cráter del volcán.
Las ideas de Empédocles fueron populares durante dos mil años, c incluso hoy las usamos en sentido figurado cuando nos referimos a una violenta tormenta como «la cólera de los elementos». El mayor filósofo griego, Aristóteles, incorporó los cuatro elementos a su esquema ilustrativo del Universo e incluyó un quinto elemento más sublime: el «éter». Está éste situado encima de la capa de fuego y no se extiende más allá de la órbita de la Luna, ya que es incompatible con la corrupta Tierra.
En Europa, durante todo el Medievo, Aristóteles fue la luz que guió a los hombres de ciencia. Tomás de Aquino concilio sus ideas con la Biblia, y, a partir de ese momento, el procedimiento de los estudiosos medievales para responder a cuestiones científicas consistió, sencillamente, en consultar los trabajos de Aristóteles. Solamente un estudioso excepcional consideraba necesario realizar un experimento real. Por ejemplo, Aristóteles había establecido que una roca pesada cae más deprisa que una ligera, y fue preciso un genio de la talla de Galileo para, en efecto, arrojar dos rocas y probar la falsedad de Aristóteles. (De paso, no es cierto que las arrojara desde la pintoresca forre Inclinada de Pisa, como afirma el mito popular.)
Mientras tanto, los alquimistas obtenían notables resultados con los cuatro elementos accesibles. Manifestaban un interés particular en la estructura de la materia, ya que la meta de la alquimia se centró muy rápidamente en la transformación de metales «básicos» en el metal más noble, el oro. Si los diferentes tipos de materia diferían en las mezclas de los cuatro elementos básicos, la transmutación debería consistir entonces, simplemente, en alterar las proporciones. El árabe Jabir ibn Hayyan, conocido en Europa occidental como Geber, abordó la «Gran Obra». El azufre, la asfixiante piedra amarilla, era la esencia de la combustibilidad (fuego), mientras que el metal líquido de mercurio, o plata viva, constituía la esencia de la fusionabilidad («capacidad de licuarse»). Combinando formas impuras de los mismos resultarían metales básicos como cobre o plomo, pero purificándolos antes de combinarlos se produciría el oro. A un mayor nivel de pureza, la combinación se convertiría en la Piedra Filosofal. Esta «piedra», el fin último de los alquimistas medievales, transmutaría por sí misma metales básicos en oro; y por analogía con esta «purificación» de metales, purificaría el cuerpo y el alma humanos. Al eliminar todas las enfermedades, incluyendo la vejez, la Piedra Filosofal aseguraba la inmortalidad, por lo que recibió el nombre alternativo de Elixir de la Vida.
El aliciente de las ideas de los alquimistas sobre la mente humana fue inmenso. El edificio de la alquimia sólo comenzó a resquebrajarse hace tres siglos, cuando sir Isaac Newton y sus predecesores establecieron las leyes de la física y las ideas básicas de la astronomía. Los alquimistas serios continuaron sus prácticas hasta 1800, y se dice que Adolfo Hitler empleó a un alquimista con la esperanza de- reforzar las reservas de oro del T ercer Reich.
Sin embargo, las mentes más sagaces del siglo XVII advirtieron que las sustancias ordinarias no podían des- componerse en tierra, aire, agua y fuego, de lo que se suponía estaban hechas. La razón principal para creer en los elementos de Empédocles era el inmenso respeto con que los hombres medievales contemplaban a los filósofos antiguos. En la década de 1660, el científico anglo-irlandés Robert Boyle, quizás el primer investigador más «químico» que «alquimista», sugirió que los «elementos» que constituían todas las sustancias eran, en sí, sustancias ordinarias. Desde este moderno punto de vista, el metal líquido mercurio y el no metal amarillo azufre, por ejemplo, son elementos que no pueden descomponerse por reacción química en otros más simples. Sin embargo, pueden reaccionar juntos para formar el compuesto rojo cinabrio (sulfuro de mercurio) pero no para dar oro, que, por derecho propio, es un elemento.
A comienzos del siglo XIX, sir Humphry Davy, el inventor de la lámpara de seguridad de los mineros, amplió la tabla de los elementos químicos. Haciendo pasar una corriente eléctrica a través de los compuestos fundidos los descompuso en sus elementos. La sal ordinaria de cocina se descompuso en un gas tóxico, el cloro, y en un nuevo metal, el sodio, tan reactivo que se mostraba efervescente y se disolvía instantáneamente en el agua. Para comprobar este análisis, pongamos en contacto estos dos impetuosos elementos y en un instante obtendremos cloruro sódico: sal de cocina.
En la época de Davy se conocían 47 elementos; el total en la actualidad es de 105. De ellos, solamente 88 se encuentran en la Naturaleza, el resto los obtiene el hombre en reactores nucleares. Algunos de estos últimos tienen una vida muy breve, y es más el físico que el químico quien confirma su existencia.
§. Los átomos: la base de los elementos
Al tiempo que Davy descomponía nuestras sustancias cotidianas en sus elementos básicos, comenzaba a quedar en claro que éstos no se componían de un material continuo («sólido»), sino de un enorme número de diminutas partículas individuales llamadas átomos.

En los núcleos centrales de los átomos reside una enorme fuente de energía, tul corno muestra este ensayo de una bomba atómica norteamericana en el Atolón de Bikini el 1 de julio de 1946. Obsérvese los barcos de guerra capturados (abajo izquierda) expuestos a los efectos de la explosión.
La teoría atómica de la materia había existido desde la época de los griegos, pero no había encontrado el favor de Aristóteles y, en consecuencia, se la había ignorado en la Europa medieval. En el curso del siglo XIX, los químicos determinaron que los elementos se combinan en ciertas proporciones definidas. A partir de la antigua idea según la cual las sustancias eran continuas si se cortase un grano de arena por la mitad un número infinito de veces, cada trozo, más y más diminuto, seguiría siendo arena, los elementos químicos debían poder combinarse en cualquier proporción.
Los nuevos experimentos exactos de química fueron llevados a cabo por vez primera, en el siglo XVIII, por el padre de la química moderna, Antoine Lavoisier, que mostró que debía existir una partícula muy pequeña de cada elemento y que estos átomos se debían combinar en cada caso particular, en relaciones simples, para dar lugar a los compuestos químicos que encontramos en la vida cotidiana, tales como sal, arena o agua. Se había elucidado, por tanto, la arquitectura de la materia. Si nos fuera posible dividir nuestro grano de arena hasta un tamaño suficientemente pequeño, encontraríamos su unidad básica consistente en dos átomos del elemento oxígeno combinados con un átomo de otro elemento, el silicio. Este sencillo trío es la molécula básica de dióxido de silicio, el compuesto del que está constituida la arena ordinaria y que se repite innumerables veces —trillones de ellas- fiara formar un grano de arena de la multitud que existe en la playa.
§. Más allá de los átomos: las partículas
Pero la energía eléctrica, con la que Davy había separado los átomos de cloro y sodio de la sal, habría de relacionarse después con el desprendimiento de las capas más externas de los propios átomos. Las descargas eléctricas en un gas muy tenue producían una lluvia de «rayos catódicos», corrientes de partículas subatómicas con carga eléctrica negativa. Estos electrones (como hoy los denominamos) son los diminutos proyectiles lanzados desde la parte posterior del tubo de un receptor de televisión, que producen puntos luminosos y oscuros cuando barren la pantalla de fósforo. Cuando se los descubrió, en 1897, constituyeron un enigma. ¿Cómo encajaban estas partículas cargadas dentro del esquema de los elementos químicos?
Solamente después de que se hubo asentado la polvareda de la revolución científica que, a comienzos del siglo XX, había desencadenado las nuevas teorías fundamentales del mundo físico, las primeras desde los tiempos de Newton (la cuántica y la de la relatividad), se aclaró el papel de los electrones. Los átomos no son precisamente bolas de billar en miniatura que se unen entre sí fiara dar lugar a las moléculas que constituyen la materia ordinaria, sino que tienen una estructura interna: en la parte exterior del átomo los electrones, cargados negativamente, se hallan en órbita alrededor de un núcleo central cargado positivamente, de forma parecida a como los planetas giran en torno al Sol (si bien no de forma tan uniforme, razón por la que en los átomos un conjunto de electrones se designa como una «nube»). El propio núcleo se compone de dos tipos de partículas, los protones, cargados positivamente, y los neutrones, eléctricamente neutros, es decir sin carga. La construcción del Universo parecía ser tan notablemente simple que únicamente requería tres partículas fundamentales diferentes, electrones, protones y neutrones que se asociaban para formar los átomos.

Un ejemplo espectacular de la fuerza eléctrica: cuando una lámina de plástico altamente cargada se conecta a tierra, los electrones fluyen por la lámina a lo largo de canales semejantes a helechos.
Los diferentes elementos químicos se diferenciaban por tener distinto número de protones en el núcleo, así como de electrones, cargados opuestamente, en órbita. El número de protones y electrones en un átomo debe ser igual, a fin de que sus cargas eléctricas se cancelen. Puesto que el comportamiento de los electrones más externos es el que controla la unión de los átomos en moléculas, los distintos elementos diferirán en sus propiedades químicas.
Un mundo realmente sencillo; en la década de 1930 parecía haberse resuelto la estructura del Universo. Sin embargo, los físicos experimentales continuaban investigando el mundo subatómico, y muy pronto sus resultados comenzaron a satisfacer a los teóricos. Aunque no cabía duda de que la estructura del átomo se había comprendido correctamente, pronto se tuvo la evidencia de que existían muchas otras partículas «fundamentales». La mayoría de estas nuevas partículas sólo eran estables durante una fracción de segundo, «desintegrándose» rápidamente en otras diferentes y emitiendo radiación. Eran claramente diferentes del electrón, el protón y el neutrón y, para asombro de los físicos de partículas, así se denomina a quienes estudian el mundo subatómico —, su número creció ininterrumpidamente durante la década de 19.50. Lo que antes había parecido un notable logro, explicar los ciento y tantos elementos en términos de tres partículas fundamentales, se convirtió en una terrible ironía cuando los físicos verificaron que el protón, el neutrón y el electrón eran sólo tres de casi un centenar de partículas diferentes que podían existir en la Naturaleza.
§. Partículas de partículas
¿Pueden todas estas partículas «fundamentales» estar constituidas por otras aún más diminutas? Si así fuera, ¿podríamos explicarnos por qué sólo unas cuantas son estables, mientras que la mayoría de las partículas de la Naturaleza se desintegran rápidamente en otras? Desde 1960, los físicos de partículas han vivido obsesionados con estas cuestiones, y el esquema básico de la Naturaleza, tal y como se presenta en la actualidad, se ha simplificado relativamente. Se considera que el protón, el neutrón y la gran mayoría de las restantes partículas subatómicas están constituidas por combinaciones de cuatro quarks diferentes.
El destacado físico americano Murray Gell-Mann escogió el término «quark» en 1964, cuando pensaba que únicamente iban a precisarse tres tipos de partículas básicas para construir las más fresadas («Three quarks for Muster Mark», dice James Joyce en Finnegans Wake). George Zweig, colega de Gell-Mann, propuso llamarlas «ases», pero el nombre nunca se aceptó, aun cuando ahora se haya «encontrado» un cuarto quark. (Realmente, los últimos experimentos indican que puede existir otro y, posiblemente, un sexto.)
Los cuatro quarks constituyen la gran mayoría de las partículas subatómicas cuando se combinan de dos en dos o de tres en tres. Sin embargo, hay cuatro partículas que también deben ser consideradas: el electrón, su hermano más pesado, el muón, y dos tipos de neutrinos que constituyen una familia aparte, la de los leptones. Al contrario de lo que sucede con los quarks, los leptones no se agrupan para formar partículas más pesadas, sino que viven existencias separadas y solitarias.
A la pregunta «¿De qué están hechas las cosas?», el físico moderno respondería: el Universo consta, en último término, de sólo ocho clases de partículas pertenecientes a dos campos: cuatro quarks que se unen para dar lugar a partículas más pesadas, como protones y neutrones; y cuatro leptones, entre los que se incluye nuestro viejo amigo el electrón. Los protones y los neutrones se combinan en un núcleo que, arropado por los electrones que se hallan en su órbita, forman un átomo; los átomos se agrupan en moléculas que se unen por medio de sus nubes de electrones arremolinados para componer todos los objetos de nuestro mundo cotidiano.
§. Las cuatro fuerzas
¿Y en qué quedaron las fuerzas' de Empédocles, amor y odio? Les fue algo mejor que a sus elementos, ya que constituyen el segundo ingrediente del Universo tal y como hoy lo ven los científicos. Cada partícula fundamental del Universo se encuentra afectada por el movimiento de las demás, es atraída o repelida por una o más de las cuatro fuerzas conocidas en la física de nuestros días. Dos de estas fuerzas nos son familiares a todos: la gravitación y el electromagnetismo, mientras que las otras dos, las nucleares, operan solamente a escala atómica.
Soltemos el libro y caerá al suelo: decimos que ha sido atraído por la gravedad de la Tierra. De hecho, cada partícula del libro es atraída por cada partícula de la Tierra, y viceversa, y es su mutua atracción gravitatoria la causante de que se reúnan. Naturalmente, el libro se mueve mucho más que la fierra, ya que contiene mucha menos materia; pero la Tierra también se mueve, elevándose 0,0000000000000000000001 milímetros para encontrarse con el libro que cae.
La gravedad nos sujeta firmemente a la Tierra: para alejarse de: la Tierra, una nave espacial debe alcanzar la tremenda velocidad de 11 kilómetros por segundo, 40.000 kilómetros por hora. Nuestro propio globo se mantiene en órbita alrededor del Sol, fuente de vida, por la poderosa atracción gravitatoria de este último; y a una escala aún mayor, la fuerza gravitatoria constriñe a nuestro Sol a una órbita circular a través de nuestra Galaxia, constituida por cien mil millones de estrellas (todas sostenidas entre sí por sus mutuas atracciones gravitatorias), a pesar de su velocidad de unos 250 kilómetros por segundo alrededor del centro de la Galaxia.
Por todo ello, resulta bastante sorprendente enterarse de que la gravitación es, con mucho, la fuerza más débil de la Naturaleza. A escala astronómica es suprema sólo porque se trata de una fuerza de largo alcance que lo atrae todo. Las dos fuerzas nucleares, aunque mucho más intensas, operan únicamente entre partículas extremadamente próximas, tan cercanas una a otra como los [motones y neutrones en el núcleo de un átomo. La fuerza electromagnética es, asimismo, mucho más intensa que la gravedad y tiene largo alcance. Sin embargo, las fuerzas entre los protones cargados positivamente y los electrones cargados negativamente se cancelan en la práctica, si bien en algún momento habremos de tratar con cantidades de materia mucho mayores que un átomo.
La tremenda intensidad de la fuerza electromagnética, el término «electromagnético» describe a ambas fuerzas, eléctricas y magnéticas, que están de hecho muy relacionadas puede mostrarse con un sencillo experimento. Frotemos un peine de plástico en nuestra manga y situémoslo sobre unos cuantos trozos de papel: veremos que éstos saltan. En el acto de frotar, una minúscula proporción de electrones de los átomos que constituyen la manga se ha transferido a los del peine, y esto ha ocasionado un exceso de carga eléctrica negativa. Aunque la cantidad extra de electrones que pasa al peine viene a ser aproximadamente tan sólo de uno por cada billón de átomos que posee el peine, esta concentración de electricidad, que es realmente minúscula, origina la fuerza suficiente para que los trozos de papel sean impulsados hacia arriba, superando la oposición que representa la atracción gravitatoria que ejercen constantemente los átomos de la Tierra.
Lo primero que aprendemos acerca de las fuerzas eléctricas es que «cargas iguales se repelen» y que «cargas distintas se atraen». Por lo tanto, un protón cargado positivamente atrae a los electrones cargados negativamente, pero dos protones se repelerán uno a otro. La atracción entre protones y electrones mantiene a los electrones de los átomos en órbita alrededor del núcleo, tal como, a una escala mucho mayor, la fuerza gravitatoria, siempre atractiva, mantiene a la Tierra en órbita alrededor del Sol y a la Luna en órbita alrededor de la Tierra. A fin de comparar las intensidades relativas de las fuerzas eléctrica y gravitatoria, supongamos que pudiésemos hacer desaparecer a voluntad todos los electrones. Si entonces agrupásemos en sendas dunas, situadas sobre la Tierra y la Luna, a los protones que las constituyen, la repulsión entre las dunas cargadas positivamente excedería a la atracción gravitatoria entre la Tierra y la Luna y despediría a nuestra Luna al espacio.
Volviendo a aspectos más mundanos, la fuerza eléctrica es la causante de que los electrones fluyan, en forma de corriente eléctrica, a lo largo de un alambre. Esta propiedad es vital para nosotros, pues sin electricidad la vida en el siglo XX, tal y como la conocemos, sería imposible. En un metal, los electrones no están fuertemente ligados a sus propios átomos, y una ligera fuerza eléctrica, un voltaje, ocasiona su desplazamiento a lo largo de un hilo metálico. En el alambre hay siempre tantos electrones como protones, de forma que la conducción no hace al propio alambre ni positivo ni negativo. Sin embargo, el flujo de electrones transporta energía, lo mismo que una corriente de agua, y esta energía se puede utilizar en la gran variedad de propósitos que asociamos con la palabra electricidad: calefacción, iluminación y comunicaciones, por sólo citar unos cuantos.
Una carga eléctrica en movimiento produce también la un tanto misteriosa fuerza del magnetismo. Históricamente, esta fuerza se asoció en principio con el imán, un mineral natural al que ahora se le llama magnetita, una forma del mineral de hierro. Se le dio esa denominación (que significa «piedra de rumbo») porque señalaba aproximadamente el norte-sur cuando era suspendido libremente. Las brújulas de imán, y posteriormente de materiales magnéticos, fueron inapreciables para los marinos europeos a partir del siglo XIII. El magnetismo se parece a la electricidad, pero con sutiles diferencias. Al igual que las cargas eléctricas, existen dos tipos de polos magnéticos, llamados «norte» (N) y «sur» (S) según la dirección en que se orientan cuando funcionan como brújulas; además, polos iguales se repelen, mientras que polos distintos se atraen. No obstante, el magnetismo se diferencia en que los polos jamás pueden existir aislados. Un imán, por ejemplo, nunca tiene un único polo N, sino que siempre tiene polos N y S de igual intensidad. Si cortamos un imán por la mitad, los extremos cortados pasan a tener polaridad opuesta a la de los polos existentes en cada mitad.
Cuando, a comienzos del siglo XIX, comenzaron a estudiarse ampliamente las corrientes eléctricas, se encontró un curioso eslabón entre la electricidad y el magnetismo. Las cargas eléctricas en movimiento que constituyen la corriente crean un campo magnético alrededor del conductor, y, recíprocamente, se puede establecer una corriente moviendo simplemente un conductor a través de un campo magnético. El primero de estos efectos tiene una utilización práctica importante en el electroimán, en el que una bobina que transporta una corriente se comporta exactamente como un enorme imán, con la ventaja de que en un electroimán el operador puede hacer cesar la fuerza magnética simplemente interrumpiendo el paso de la corriente eléctrica, inestimable, por ejemplo, en los cementerios de automóviles para el traslado de los coches viejos.
El segundo efecto es aún más importante en nuestra vida cotidiana, ya que supone el principio del generador eléctrico. En una central eléctrica, la energía generada por combustión de carbón o petróleo, hidráulica o nuclear, se utiliza para hacer girar una bobina en un campo magnético. La energía mecánica que se emplea en hacer girar el generador (o dinamo) se transforma, por medio de la bobina que gira, en corriente eléctrica. De esta forma se la puede enviar por medio de una red de distribución eléctrica y reconvertirla en energía mecánica, o en luz, calor, etc., en el hogar o en la fábrica.
El comportamiento de los imanes permanentes se clarificó cuando se verificó que un átomo está constituido por un torbellino de electrones que giran alrededor de un núcleo central. Los electrones originan una corriente que circula de la misma forma que el flujo de electrones en la bobina de un electroimán, de manera que cada átomo se comporta como un minúsculo electroimán con sus polos N y S. De hecho, la circulación de la multitud de electrones hace que se cancelen los campos magnéticos en la mayoría de los átomos; pero existe un puñado de elementos el hierro es el más común de ellos, en los que los electroimanes atómicos individuales no sólo son intensos, sino que pueden orientarse en el bloque sólido de la sustancia, los polos N por un lado y los polos S por otro, de forma que un extremo del bloque actúa como polo N y el otro como polo S.
La electricidad y el magnetismo son, por tanto, manifestaciones diferentes de la misma fuerza fundamental, el electromagnetismo. De las cuatro fuerzas de la Naturaleza, ésta, la segunda más intensa, liga los electrones a los átomos y construye las moléculas de las sustancias cotidianas a partir de las interacciones de las nubes electrónicas entre átomos vecinos. Nuestro mundo ordinario es, en gran parte, un mundo electromagnético.
Las dos fuerzas restantes las nucleares «fuerte» y «débil» pueden parecer hallarse, en principio, muy alejadas de nuestra vida cotidiana; sin embargo, son tan importantes en la determinación de la estructura del Universo como la gravitación y el electromagnetismo. La fuerza fuerte mantiene unidos los quarks. Los mantiene unidos de dos en dos o de tres en tres en las antiguas partículas fundamentales, y con una intensidad tal que, en la actualidad, los físicos no han sido capaces de aislarlos. Casi como una reflexión tardía, los restos de esta fuerza colosal se filtran desde el interior del protón y del neutrón para mantener unidas estas partículas en el núcleo de un átomo.
La necesidad de algún tipo de fuerza de atracción en el núcleo resultó obvia tan pronto como los físicos dieron con que en el mismo núcleo podían convivir varios protones. Cuando estas partículas, cargadas positivamente, se encuentran muy próximas, la fuerza de repulsión eléctrica entre ellas es inmensa. Dos protones se repelen uno a otro, en el diminuto núcleo de un átomo de hierro, con una fuerza igual al peso de este libro. Obviamente, en el núcleo debe estar actuando una fuerza mucho más intensa capaz de mantener unidos los protones (y neutrones), y debe de ser unos cientos de veces más intensa que la fuerza electromagnética.
Algunos aspectos de la fuerza nuclear fuerte nos son bastante familiares. La poderosa atracción de los protones y de los neutrones se puede liberar en forma de estallido mortífero en la bomba de hidrógeno, cuando se forman nuevos núcleos a partir de otros más pequeños. El mismo proceso, la fusión nuclear del hidrógeno, tiene lugar en el núcleo del Sol y de otras estrellas, aunque en este caso la fuerza fuerte, es decir su energía convertida en luz y calor, llega hasta nosotros, desde una distancia que implica seguridad, como un influjo benigno.
La fuerza débil ha sido, desde hace mucho tiempo, la más misteriosa de las cuatro fuerzas de la Naturaleza. No tiene efecto obvio en nuestro mundo cotidiano, e incluso en el laboratorio de- física moderna sus acciones están generalmente enmascaradas por la mil .veces más intensa fuerza electromagnética, o por la aún más potente fuerza fuerte. La mayoría de los efectos de la fuerza débil se ponen más de manifiesto en las reacciones que ocasiona que en la atracción o repulsión entre las partículas. Un neutrón libre, por ejemplo, solamente vive por término medio quince minutos.

Todas las fuerzas de la Naturaleza se vinculan entre sí. La electricidad y el magnetismo están íntimamente ligados, y actualmente se relaciona esta fuerza electromagnética con la fuerza nuclear débil. Los físicos confían m encontrar sus vínculos con la fuerza nuclear fuerte y con la gravitación.
A continuación se desintegra en un protón, un electrón y un esquivo antineutrino (la antipartícula equivalente al neutrino «ordinario») y en esta reacción interviene la fuerza nuclear débil; la teoría muestra que ésta no tendría lugar si la gravitación, el electromagnetismo y la fuerza nuclear fuerte fueran las únicas fuerzas de la Naturaleza. Virtual mente, la fuerza débil es quizá la más importante en el gobierno de las primeras etapas de la fusión del hidrógeno en las estrellas: sin ella, las estrellas nunca brillarían, o bien explotarían apenas nacer, como veremos cuando examinemos más de cerca los núcleos de las estrellas en el capítulo 8.
Sin embargo, la fuerza débil puede constituir otro aspecto de la fuerza electromagnética. Hemos visto cómo la aparentemente misteriosa fuerza magnética pasó a ser otro aspecto de la fuerza eléctrica; en 1967, Steven Weinberg y Abdus Salam propusieron que la fuerza débil también podía estar relacionada con ellas. La teoría subyacente a esta unificación no es sencilla, pero hace pensar que en la Naturaleza hubiese solamente tres fuerzas, una de las cuales, el «nuevo electromagnetismo», se manifestaría de formas diferentes: fuerza eléctrica, magnética o nuclear débil. Existe una fundada esperanza entre los físicos de partículas de que en sólo unos cuantos años se pueda incorporar la fuerza fuerte a este esquema. Esta «superfuerza» combinaría las fuerzas fuerte, débil y electromagnética como formas diferentes de describir todos los efectos que abarcan. Solamente la gravitación plantea aún un problema importante en la reconciliación de las fuerzas.
§. Las leyes de la Naturaleza
Ocho partículas y cuatro fuerzas (¿quizá pronto reducidas a dos?) constituyen la materia prima del Universo, tal y como lo ven hoy los ojos de los científicos modernos. Hay además un ingrediente más sutil: las leyes de la Naturaleza. Si deseáramos desembarazarnos de la Luna mediante la repulsión eléctrica existente entre dos dunas, tendríamos que destruir una gran cantidad de energía eléctrica en forma de electrones, lodos los experimentos efectuados desde siempre muestran que la Naturaleza no nos permite destruir la carga eléctrica. Esta «ley de conservación de la carga eléctrica» es sólo un ejemplo de las leyes de la Naturaleza que gobiernan el comportamiento de las partículas.
El término «leyes» de la Naturaleza es algo impreciso, ya que en realidad se trata de generalizaciones acerca del comportamiento del Universo. Al contrario de lo que sucede con las leyes humanas, cuando los científicos encuentran una reacción que transgrede una «ley» científica establecida, esta «ley» es la que resulta dañada, ¡y nunca el culpable! Las leyes de la Naturaleza son de muchas clases, frecuentemente del tipo de «conservación», como la que se aplica a las cargas eléctricas. Muestran que en el mundo natural existe un orden. Las partículas y las fuerzas constituyen el esqueleto y los músculos del Universo, pero implicarían un caos si no existiera una arquitectura que las estructurase.
Y ahora iniciemos la exploración del Universo...
Capítulo 2
Examen de las profundidades del espacio
La naturaleza del Universo infinito, que examinamos desde la diminuta, mota de nuestro planeta, requiere humildad. Incluso nuestro Sol, al que el hombre primitivo adoraba como fundamento de todas las cosas, es una estrella muy común.

Una extensa nube de gas (nebulosa) en la constelación Serpeas está iluminada por estrellas muy brillantes. Tomadas recientemente, visibles cerca del centro. Las nubes de polvo que se destacan en forma de glóbulos oscuros y «trompas de elefante» pueden llegar a condensarse en planetas alrededor de las estrellas en formación. (©Copyright del Instituto de Tecnología de California y la Institución Carnegie de Washington. Reproducido con permiso de los Observatorios Hale.)
§. Familias de estrellas
§. Entre las estrellas
§. Los planetas
§. La medida de las distancias
§. Astrofísica: la historia natural de las estrellas
§. Las estrellas ¿conformistas
§. La exploración de otras galaxias
§. El «Big Bang»
Nuestro planeta Tierra es una mera mota en la inmensidad del Universo. Desde el espacio, el tenue disco de la Tierra aparece inundado por el resplandor del Sol, nuestra estrella local que nos abastece de luz y calor. Sin el Sol, la superficie terrestre se congelaría hasta 270° C, temperatura próxima al cero absoluto. No obstante, el Sol pasa claramente desapercibido en el conjunto de las estrellas, pues en una noche clara veremos muchas de ellas diez mil veces más intensas, que titilan pausadamente, aunque reducidas a puntos luminosos a causa de las enormes distancias que las separan de nosotros.
Los grupos de estrellas del cielo nocturno constituyen las constelaciones de los antiguos, bautizadas con nombres de héroes (Orion, Hércules) o de animales (Taurus, el Toro; Delphinus, el Delfín). Entre la confusa multitud de estrellas visibles en una noche clara, unas tres mil, las constelaciones representan aún la forma más sencilla de orientación en el cielo, así como de identificación de las estrellas consideradas individualmente. Pese a que ahora sabemos que todas las estrellas del «diagrama» de una constelación no se relacionan por lo general entre sí algunas, estrellas débiles, estarán relativamente próximas, mientras que otras, luminarias brillantes, estarán distantes, los astrónomos las siguen empleando para definir de forma aproximada las regiones del cielo. Aunque la astronomía es en el fondo una ciencia moderna, contiene todavía referencias fascinantes a su pasado. El contraste es mayor porque la tecnología ha avanzado y ha permitido que los astrónomos capten otras radiaciones procedentes de los cielos. Sensibles instrumentos enviados en un cohete, en 1962, descubrieron rayos X provenientes de un punto del cielo cuya posición no se pudo determinar entonces con precisión, pero dado que su dirección era la de la constelación de Scorpius, la fuente se denominó Scorpius X-l y fue la primera fuente de rayos X en la constelación del Escorpión.
Para el astrónomo moderno, las estrellas son algo más que puntos luminosos o puntos fijos en el cielo, útiles para la navegación. La batería de instrumentos de que hoy disponen los astrónomos ha llevado a que las demás estrellas sean casi tan familiares como el Sol, y su variedad es sorprendente. Aunque algunas brillan miles de veces más que el Sol, la mayoría de ellas son mucho más débiles que nuestra estrella. Otras son cientos de veces mayores que el Sol, pero su materia está esparcida tan tenuemente en sus enormes volúmenes que la mayor parte de esas estrellas es un millón de veces más sutil que el aire que respiramos. Y otras son pequeñas, con tanta materia como la del Sol comprimida en un cuerpo del tamaño de la Tierra.
§. Familias de estrellas
Muchas estrellas se presentan a pares, en órbita permanente una alrededor de la otra. En algunos sistemas de binarias (estrellas dobles) próximas, la atracción gravitatoria de una arranca las capas más externas de la otra, atrayéndolas hacia su superficie o haciéndolas girar cual remolinos de gas caliente en el espacio. Otras son bastante más gregarias y viven en enormes cúmulos de más de un millón de estrellas, en órbita una alrededor de otra, conformando una especie de cósmico enjambre de abejas.
Cada estrella, incluido el Sol, pertenece a un único sistema de estrellas, una galaxia. Nuestra propia galaxia es un enorme disco aplanado de estrellas que gira alrededor de un «centro» situado en la dirección de la constelación austral de Sagitario. Al observar el cielo, vemos muchas más estrellas distantes cuando dirigimos la visual hacia el interior del disco de nuestra galaxia que cuando miramos en direcciones alejadas del mismo. El disco de nuestra galaxia aparece, por tanto, como una-débil banda luminosa alrededor del cielo, constituida por la suma de la luz de millones de estrellas distantes demasiado débiles como para ser percibidas individualmente. Se puede apreciar, en una noche clara, el efecto de perspectiva de las estrellas más débiles (más distantes) apiñándose en esta banda resplandeciente, especialmente desde las latitudes meridionales, desde donde es visible el «centro». Los antiguos griegos atribuyeron la débil banda blanca a la leche derramada del seno de Juno, y su denominación, «la Vía Láctea» (gala en griego significa «leche»), se ha mantenido desde entonces. Nuestra galaxia, de la que el Sol es sólo un miembro insignificante, se designa a menudo como la Galaxia de la Vía Láctea o, simplemente, la Galaxia.
Existen otras galaxias de estrellas mucho más allá de la nuestra. Algunas son planas como la Galaxia de la Vía Láctea; otras, redondas; y algunas, de forma completamente irregular. Todas están constituidas por estrellas que, básicamente, no difieren de las de la Vía Láctea. El estudio de otras galaxias nos ha enseñado que la nuestra es una especie muy típica, así como el Sol es una estrella muy típica dentro de la Galaxia y la fierra un planeta bastante ordinario. La astronomía moderna ha enterrado la idea medieval de que la fierra era el centro y la parte más importante del Universo.
Irónicamente, es mucho más difícil decir cómo están dispuestas las estrellas en nuestra Galaxia que en las demás. El problema consiste simplemente en que nosotros nos encontramos entre las estrellas de la Vía Láctea, y, para situarlas, hemos de determinar sus distancias. Por el contrario, la forma y la estructura de las galaxias distantes se hacen patentes echando un vistazo a una fotografía. En esencia, es la misma diferencia existente entre determinar la forma, la extensión y las posiciones de los árboles de un bosque estando en él, o sobrevolándolo en un avión. Sin embargo, la acción coordinada de las modernas técnicas astronómicas ha hecho considerables aportes a la resolución del problema.
Así, se ha determinado que la Galaxia es plana y circular con un bulto en el centro, como dos huevos fritos unidos por detrás. El Sol se, encuentra a aproximadamente dos tercios del centro. Todas las estrellas que constituyen el disco giran en órbitas circulares alrededor del centro de la Galaxia, tal como la fierra lo hace alrededor del Sol, pero a una escala enormemente mayor y con la diferencia de que en el centro de la Galaxia no hay un único cuerpo muy masivo que controle las órbitas de la estrellas.

Este mapa del conjunto del cielo muestra todas las estrellas visibles y realza el aspecto de la Vía Láctea. Esta banda brumosa es la combinación de luz de millones de distantes estrellas de nuestra Galaxia, demasiado débiles para ser distinguidas individualmente.
Cada estrella de la Galaxia está sometida a la atracción gravitatoria de las demás, y estas atracciones se promedian, de forma que la atracción total sobre una estrella más externa, por ejemplo el Sol, ocasiona el mismo efecto que el de un gran cuerpo situado en el centro de la Galaxia. El Sol gira en órbita en la Galaxia a una velocidad de 250 kilómetros por segundo, pero nuestra Vía Láctea es tan vasta que emplea 225 millones de años en completar una vuelta.
Gran parte de las estrellas más brillantes del disco de la Galaxia se concentra en una estructura de espiral doble. Este descubrimiento no ha sorprendido demasiado a los astrónomos, ya que la mayoría de las galaxias planas muestran estructuras espirales en el disco constituidas por estrellas brillantes. Por cierto, las galaxias de disco plano se denominan en general galaxias espirales como reconocimiento de su bella forma. Las fotografías de estas espectaculares galaxias tienden a destacar los brazos espirales, ya que la mayor parte de las estrellas del disco, estrellas enanas tenues, están repartidas mucho más uniformemente. La astronomía teórica ha demostrado, recientemente, que las estrellas que se mueven en un disco tenderían a concentrarse en brazos espirales bajo la influencia de sus mutuas atracciones gravitatorias. Estos cálculos se han verificado por simulaciones en ordenador: un programa específica cómo se mueve inicialmente una estrella en un disco de varios miles de ellas, y el ordenador determina cómo el efecto gravitatorio de cada estrella afecta el movimiento de las restantes. El resultado se muestra como una película, y puede apreciarse que las estrellas se agrupan casi milagrosamente en una espiral doble mientras circundan la «galaxia».
Aunque la mayoría de las estrellas que vernos pertenecen al disco de la Galaxia, no son los únicos miembros de la Vía Láctea. En torno al disco, «por encima» y «por debajo», hay viejas estrellas débiles dispuestas en un inmenso volumen esférico de espacio, el hala. Gran parte de ellas se agrupa en densos cúmulos globulares de estrellas que contienen, cada uno, más de un millón de miembros. Estos cúmulos y el resto de las estrellas del halo fueron las primeras estrellas que nacieron cuando se formó nuestra Galaxia; pero en la actualidad son débiles, reliquias seniles del pasado de la Galaxia que se desvanecen lentamente mientras el disco permanece joven y vigoroso.
§. Entre las estrellas
La juventud de las estrellas del disco se debe a un ingrediente muy importante no mencionado hasta ahora: el gas existente entre las estrellas. Este gas interestelar se compone fundamentalmente de hidrógeno y helio y es enormemente tenue, mucho más que el mejor «vacío» que (rueda obtenerse en la fierra. En promedio, hay una media docena de átomos en un volumen del tamaño de una caja de cerillas, pero la Galaxia es tan gigantesca que la cantidad total de este gas puede dar lugar a 10.000 millones de soles. Y este gas, precisamente, genera estrellas. Grandes nubes de gas incandescente, nebulosas, más densas que la media, se agrupan entre ellas por atracción gravitatoria y se condensan en cúmulos de estrellas. Las estrellas se hallan en continua formación: los astrónomos han visto «encenderse» dos estrellas débiles en los últimos cincuenta años. Los brazos espirales son los primeros lugares de formación de estrellas, ya que ahí la estructura de los campos gravitatorios comprime el gas en densas nubes. En otras galaxias vemos claramente que los brazos espirales están constituidos por tiras de nebulosas, así como por brillantes estrellas de reciente formación. Existe suficiente gas en la Vía Láctea como para crear estrellas durante miles de millones de años, de forma que la Galaxia mantendrá durante mucho tiempo su juventud.
Mezclados con el hidrógeno y el helio existen otros elementos constituidos por diminutos granos sólidos. Estas partículas de «polvo» son aproximadamente del tamaño de las del humo de un cigarrillo, c interceptan la luz de una forma similar. El polvo mezclado con el gas general oscurece las regiones distantes del disco de la Galaxia; por dar un ejemplo, la luz procedente de regiones próximas al centro de la Galaxia es atenuada 100.000 millones de veces por el mismo. Afortunadamente, los astrónomos modernos pueden emplear la radiación emitida en las longitudes de onda del infrarrojo y de las ondas de radio para estudiar esas regiones, ya que estos rayos pueden penetrar el velo de polvo.
§. Los planetas
El polvo se hace más patente cuando forma pequeñas nubes oscuras delante de las nebulosas de brillantes estrellas en formación. Estas nubes aparecen silueteadas como bandas oscuras, pequeños glóbulos redondos o «trompas de elefante» contra el resplandeciente fondo de la nebulosa. Los planetas como la Tierra se han formado a partir de estos granos de polvo, que se agrupan cuando el gas se colapsa para formar una estrella. La materia que constituye todos los objetos cotidianos, incluidos nuestros cuerpos, oscureció alguna vez, en forma de diminutos granos interestelares, la visión de algún astrónomo extra terrestre hace varios miles de millones de años.
En 1977, unos astrónomos que observaban en las longitudes de onda del infrarrojo descubrieron un sistema planetario, otro sistema solar, en estado de formación en una nube de gas en la constelación de Cygnus. La naturaleza de la radiación sugiere que la estrella central de este sistema tiene menos de mil años y que los planetas se están condensando ahora a partir de un disco de gas y polvo. Nuestro propio sistema solar nació de esta forma hace 4.600 millones de años. Según la edad de algunos meteoritos, las rocas más antiguas del sistema solar, los granos de polvo dieron lugar gradualmente a nueve planetas mayores y a sus lunas, dejando una cierta cantidad de restos rocosos alrededor del sistema. Los planetas más alejados del Sol, como el masivo Júpiter, atrajeron hacia ellos, debido a la gravedad, al hidrógeno y al helio que los rodeaban, acumulando enormes atmósferas hasta el punto que han llegado a tener más atmósfera que núcleo rocoso. Así nació la familia de los planetas exteriores, los gigantes gaseosos. Por el contrario, los planetas interiores, incluida la Tierra, estaban demasiado próximos al Sol, que los iluminaba entonces más intensamente que ahora, como para poder mantener alguna atmósfera. Cualquier tipo de gases que hubieran retenido se habría «evaporado» por el calor del Sol, dando lugar al mundo rocoso que hoy contemplamos. Más adelante, los gases que escaparon de los volcanes dotaron de atmósfera a Venus, la Tierra y Marte, mientras que los cuerpos pequeños, Mercurio y nuestra Luna, tenían muy poca gravedad para retener esta segunda atmósfera frente al calor del Sol.
Nuestro conocimiento del sistema solar se ha acrecentado recientemente con el empleo de las sondas espaciales, que pueden sobrevolar un planeta, situarse en su órbita o, incluso, posarse en su superficie. En las dos últimas décadas se ha duplicado virtualmente nuestro conocimiento de los planetas; y a finales de este siglo los planetas interiores estarán tan bien estudiados como la Tierra (en términos astronómicos), mientras que los exteriores (a excepción del pequeño Plutón) habrán sido visitados por sondas que los investigarán muy de cerca. Una consecuencia muy importante de ello es que el estudio de la «planetología comparada» podrá decirnos mucho más acerca de la fierra.

La Nebulosa de la Cabeza de Caballo en Orion es una extensa nube de partículas de polvo que intercepta la luz proveniente de una brillante nube de gas más distante, que aparece aquí como un fondo rojo. (Copyright del Instituto de Tecnología de California y la Institución Carnegie de Washington. Reproducido con permiso de los Observatorios Hale.)
Sus similitudes con planetas próximos mostrarán cuáles son las características comunes en cuanto a formación y geología planetaria, mientras que sus diferencias arrojarán luz sobre las razones por las que la Tierra ha llegado a ser lo que es, y, en particular, por qué parece ser el único planeta con vida.
§. La medida de las distancias
Un requisito previo muy importante al planificar una misión de sondeo planetario es un conocimiento preciso de la distancia al planeta que constituye el blanco; en consecuencia, las distancias planetarias se deben medir, en este caso, con una precisión mucho mayor que la requerida, por la astronomía. Dado que las trayectorias de los planetas están controladas por la atracción gravitatoria del Sol, la ley de la gravitación puede poner de manifiesto las distancias relativas de los planetas con mucha precisión cuando se conocen sus periodos orbitales («años»). Se pueden calcular todas las distancias del sistema solar a partir de la medida de una de ellas. El método empleado en la actualidad es el radar, que en principio es exactamente igual al radar de un avión. Una onda de radio transmitida desde la Tierra se refleja en un planeta, y se recoge y amplifica el débil eco que retorna. Es posible medir con extrema precisión el tiempo transcurrido entre la transmisión de la señal y el retorno del eco; multiplicando luego este tiempo por la velocidad de la luz (la velocidad a que se desplazan las ondas de radio) se obtiene la distancia total cubierta por la onda, o sea el doble de la distancia al planeta.

La distancia a una estrella próxima se puede medir a partir de su paralaje anual, el cambio aparente de su posición cuando la Tierra gira alrededor del Sol. El movimiento se mide por referencia a estrellas muy distantes (cuyas propios paralajes son despreciables) y aquí aparece muy exagerado.
Generalmente se utiliza Venus como blanco, ya que está más próximo a la Tierra que cualquier otro planeta y tiene una superficie comparativamente mayor apta para reflejar la señal de radar. Pese a la enorme velocidad de la onda de radio, 300.000 kilómetros por segundo, emplea unos cinco minutos en retornar a través del espacio interplanetario.
A partir de la distancia a Venus y del «modelo a escala» del sistema solar que se obtiene de las leves de la gravitación, se puede calcular la distancia de la Tierra al Sol. (No se puede utilizar el propio Sol como blanco para el radar, pues la intensa radiación de su atmósfera predominaría sobre la débil señal reflejada.) Esta fundamental distancia, que los astrónomos llaman unidad astronómica, es posiblemente la cantidad que se mide con mayor precisión en astronomía: su valor es 149.597.870 kilómetros. La escala del sistema solar se conoce ahora con enorme precisión, la equivalente a conocer la distancia entre la Torre Eiffel y la Columna de Nelson, en Londres, con una precisión del orden de un centímetro.
Pero cuando extendemos nuestra escala a distancias exteriores al sistema solar, nos damos por satisfechos si conocemos las distancias con una precisión de una parte en cien. Muchas veces los astrónomos se contentan con saber que, por ejemplo, la distancia a una galaxia recientemente descubierta está dentro del 50% del valor correcto. No es obvio a primera vista que se pueda medir la distancia de las estrellas, ya que el radar no sirve: el contacto más lejano efectuado, dentro del sistema solar, ha sido con los anillos de Saturno. Sin embargo, los astrónomos modernos disponen aproximadamente de al menos una docena de métodos para calibrar las distancias a las estrellas. Algunos sólo pueden emplearse con determinados tipos de objetos conocidos, por ejemplo cúmulos de estrellas o estrellas pulsantes, pero cada uno tiene su aplicación y los astrónomos los pueden contrastar midiendo por ejemplo la distancia a una estrella pulsante en un cúmulo de estrellas.
El método más antiguo utilizado, y quizá todavía el más importante, es el paralaje. Veamos cuál es su principio: situemos un dedo delante de la nariz, y al cerrar sucesivamente uno y otro ojo nos parecerá que se mueve de un lado a otro respecto a un fondo distante a medida que varía nuestra visual. Cuanto más alejado esté el blanco, menor será el movimiento aparente. Ensayemos el «guiño» con el marco de una ventana al otro lado de la habitación cuando miramos la casa de enfrente, y veremos que el mismo se mueve menos que el dedo; si el blanco es un árbol y tomamos como fondo la Luna, el movimiento es difícilmente detectadle. Midiendo el ángulo que aparenta describir el blanco es posible calcular su distancia si se conoce la distancia entre los ojos.
Antaño, los astrónomos medían la distancia a la Luna por paralaje desde dos observatorios muy separados, determinando su posición precisa respecto al fondo estrellado. La tecnología moderna ha superado este modo de determinación, y ahora la distancia a la Luna se puede medir con una precisión de 30 centímetros cronometrando impulsos de láser reflejados por reflectores, especialmente diseñados, depositados sobre la superficie lunar por naves espaciales tripuladas y no tripuladas. Medir el paralaje de una estrella, sin embargo, es un procedimiento mucho más dificultoso. La distancia entre dos observatorios terrestres no es una línea de base suficientemente larga como para producir una variación apreciable en la posición de una estrella, y los astrónomos han de recurrir a la órbita que la Tierra describe alrededor del Sol.
Un observatorio toma una fotografía de la supuesta estrella próxima, por ejemplo en junio, y otra en diciembre, seis meses más tarde. La fierra se encuentra entonces en el lado más alejado de su órbita, 300 millones de kilómetros respecto a su posición en junio, y, si la estrella está relativamente próxima, parecerá que se ha movido ligeramente cuando se la compare, con las estrellas del fondo. Otra fotografía tomada en el siguiente mes de junio mostrará a la estrella en su posición original, confirmándose así que la variación se debe al paralaje. Midiendo el ángulo y conociendo la dimensión de la órbita de la Tierra, se calcula fácilmente la distancia de la estrella.
En la práctica, el procedimiento es más complicado. Tanto el Sol como la estrella describen trayectorias rectas a través del espacio, por lo que la estrella no se volverá a encontrar exactamente en su posición original. Es como observar a alguien que pasea por el real de una feria desde un caballito del tiovivo. Su posición respecto al fondo es bastante complicada, pero podemos separar su movimiento real del movimiento de vaivén debido a que nuestra visual varía continuamente. De la misma forma, los astrónomos siguen año tras año a las estrellas próximas y, finalmente, pueden separar el movimiento intrínseco («movimiento propio») de la «oscilación» anual debida al paralaje. Esta «oscilación» es increíblemente pequeña incluso para la estrella más próxima: si, con el fin de lograr el mismo pequeño vaivén, guiñásemos los ojos mirando un árbol proyectado contra la Luna, sería necesario que el árbol se hallase a 10 kilómetros.
Pacientes observaciones, miles de miles de ellas, desde observatorios de todo el mundo, han suministrado en la actualidad las distancias de las mil estrellas más próximas con todavía mayor precisión. La «estrella» más próxima de todas es, en realidad, un sistema triple de estrellas. Alpha Centauri. Las dos más brillantes están muy próximas una de otra y constituyen una brillante estrella del hemisferio austral, conocida por los astronautas como Rigil Kent, La tercera es tan débil que sólo resulta visible con un telescopio y está ligeramente más próxima a nosotros. Por ser la estrella más cercana conocida, esta débil estrella enana ha recibido el nombre de Próxima Centauri.
A la hora de evaluar distancias estelares, la inmensidad del espacio hace que el kilómetro o la milla sean unidades insignificantes. Incluso en el sistema solar manejamos millones de kilómetros, ¡rúes Próxima Centauri está a 40 billones de kilómetros del Sol, mientras que nuestra Galaxia tiene un trillón de kilómetros de diámetro. Ametales cifras, los astrónomos han optado por unidades más convenientes, bien basadas en el método del paralaje (utilizando una unidad llamada parsec), bien en la distancia que recorre la luz en un año (en cuyo caso la unidad es el año luz). Suelen emplearse en astronomía ambas unidades, para confusión del lector ocasional; con todo, nosotros optaremos por los años luz. Próxima Centauri está a 4,2 años luz, dato que no sólo nos informa acerca de su distancia sino, también, de que su luz que vemos en la actualidad corresponde realmente a la de hace unos cuatro años. (Comparativamente, la luz del Sol sólo emplea 8 1/3 minutos en llegar a la tierra.)
El método de paralaje, aun cuando se emplee cuidadosamente, sólo es válido para estrellas que se encuentren a 70 años luz del Sol. Más allá, la insignificante desviación anual comienza a ser demasiado pequeña como para poder ser medida. El volumen de espacio que contiene a nuestras mil estrellas más próximas es, sin embargo, minúsculo comparado con la extensión total de 100.000 años luz de nuestra Galaxia de 100.000 millones de estrellas. Afortunadamente, los otros métodos mencionados, en especial el que se aplica a los cúmulos de estrellas, pueden profundizar más en la Galaxia. Y una vez averiguadas las distancias a muchas estrellas, resulta evidente que, pese a las aparentemente enormes diferencias entre ellas, existe un sistema ordenado tras sus peculiaridades.
§. Astrofísica: la historia natural de las estrellas
Supone por cierto una inmensa tarea el intentar interpretar los brillantes y parpadeantes puntos luminosos de nuestro cielo nocturno como auténticos Soles, así como encontrar su semejanza y lo que hay en su interior. Los antiguos astrónomos se contentaron simplemente con medir las posiciones de las estrellas, pero su interpretación no comenzó en realidad hasta hace un siglo, cuando los astrónomos comenzaron a medir las distancias a las estrellas. Surgió una nueva rama de la astronomía cuyo propósito consiste en deducir las propiedades de las mismas aplicando las leyes de la física a las observaciones astronómicas. Pronto se la conoció con el nombre de astro física.
A la larga, los astrofísicos pretenden saber cómo nacen las estrellas, cómo brillan, cambian, envejecen y, finalmente, mueren. Estas cuestiones sólo pueden contestarse comenzando por observarlas. Si observamos cuidadosamente las estrellas más brillantes en una noche clara, advertiremos que tienen diferentes colores. Unas son rojas (Betelgeuse en Orion, Antares en Scorpius); otras, anaranjadas (Arturo en Los Boyeros); otras más, amarillentas (el Sol, Capella en Auriga); mientras que las hay de un blanco puro (Vega en Lira) y blancoazuladas (Rigel en Orion). (A lo largo de una noche notaremos que estas estrellas centellean también con otros colores, pero esto, lo mismo que el «parpadeo», es un efecto de la atmósfera de la Tierra.) El color de una estrella es simplemente una medida de la temperatura de su superficie. Cualquier objeto suficientemente caliente radiará luz, tal como lo hace un atizador incandescente en un crepitante fuego, y el color varía con la temperatura: rojo a bajas temperaturas, cambiando a naranja, amarillo, blanco y, finalmente, a azul a temperaturas sucesivamente más altas. Los astrónomos modernos disponen de instrumentos para medir el color con mayor precisión que la del ojo humano, pero el principio de medida de la temperatura es el mismo.
Una diferencia más obvia entre las estrellas es su brillo aparente.

Durante un eclipse total de Sol, la Luna intercepta la intensa luz del disco solar y hace visible su tenue atmósfera externa. Aunque el Sol es la única estrella que podernos estudiar con tanto detalle, las similitudes y diferencias globales entre las estrellas dicen mucho a los astrónomos acerca de corno éstas, incluido el Sol, nacen y mueren.
Los griegos clasificaron originalmente a las estrellas en seis clases de brillos, de forma que las más brillantes eran de magnitud uno, y las más débiles, visibles todas a simple vista, de magnitud seis. Las técnicas astronómicas modernas permiten subdividir estas clases en otras mucho más sutiles que las posibles para el ojo, ya que los grandes telescopios pueden detectar estrellas mucho más débiles. Siguiendo la tradición, las estrellas más débiles son las de mayor magnitud (las de magnitud 23 son las más débiles observables en la actualidad con grandes telescopios), mientras que los objetos muy brillantes tienen magnitudes negativas. Así, la estrella más brillante del cielo, Sirio, tiene una magnitud de —1,4. El Sol se puede medir con el mismo sistema y acaba teniendo una magnitud de —26,8; es interesante señalar que las estrellas más débiles que los astrónomos pueden detectar son tan débiles respecto de Sirio como ésta lo es respecto del Sol. El amplio rango de magnitudes estelares, desde — 1,4 a 23 (y presumiblemente más débiles), se debe por un lado a las diferentes distancias a que se encuentran las estrellas de nosotros, y, por otro, a que realmente tienen brillos diferentes. Si se conoce la distancia a una estrella, resulta fácil medir su flujo real de luz, o sea su luminosidad.
Las estrellas más brillantes son un millón de veces más intensas que el Sol, pero estas luminarias celestes son muy raras: sólo hay una media docena en toda la Galaxia. Las estrellas muy débiles son la variedad más común, pero obviamente no es fácil distinguirlas en el abigarrado cielo. La estrella más cercana. Próxima Centauri, es una de estas estrellas enanas débiles, diez mil veces menor que el Sol, y que pasaría inadvertida de no estar tan próxima.
Con los primeros datos de una estrella la temperatura de su superficie y su luminosidad bien establecidos, el astrofísico puede comenzar su investigación. Hay una ley física que relaciona el brillo de cualquier objeto caliente, con su temperatura y su tamaño. Por tanto, puede calcularse el radio de una estrella. Algunas estrellas son gigantes, Betelgeuse es cuatrocientas veces mayor que el

Dos cúmulos próximos de estrellas, las Híades (izquierda) y las Pléyades o Siete Hermanas (derecha). A simple vista destacan bastante los colores de estrellas brillantes como éstas. Van desde un blanco azulado hasta un rojo, pasando por amarilla, dependiendo el color de la temperatura de la estrella. (Cortesía de Ian Robson.)
Sol y otras enanas, no mayores que un planeta (pero con la diferencia crucial de que están calientes y emiten luz por sí mismas, mientras que un planeta está frío y sólo puede reflejar la luz procedente de una estrella).
Cuando un físico se encuentra con dos cantidades medidas, tales como las temperaturas y las luminosidades de las estrellas, su primer propósito es dibujar una gráfica, lista puede resultar frecuentemente confusa para una persona distinta de la que la ha dibujado, pero si es buena puede mostrar relaciones ocultas entre la gran cantidad de datos de la tabla original. En una gráfica de luminosidades y temperaturas estelares, cada estrella aparece como un punto cuya posición en dirección vertical denota su luminosidad, y cuya distancia en dirección horizontal corresponde a su temperatura. Significativamente, los puntos correspondientes a la mayoría de las estrellas están situados en la gráfica en una estrecha banda. Esta secuencia principal de estrellas muestra de forma gráfica que las estrellas gradualmente más calientes que el Sol son gradualmente más brillantes, mientras que las más frías son progresivamente más débiles. Veremos más adelante que esta uniformidad se debe a la manera en que brillan las estrellas. (Incidentalmente, la gráfica de luminosidad, temperatura se denomina «diagrama de Hertzsprung-Russell», los dos primeros astrofísicos que lo utilizaron a comienzos de este siglo.)
En la esquina inferior de esta gráfica hay puntos que representan estrellas muy calientes, no obstante ser muy pequeñas y débiles. Estas enanas blancas son cadáveres de estrellas que se han apagado hace mucho tiempo pero que continúan luciendo débilmente a medida que radian al espacio su calor almacenado.

El diagrama de Hertzsprung- Russell clarifica las estrellas según su luminosidad (brillo intrínseco) y su temperatura. Las estrellas más laminosas se hallan en la parte superior del diagrama, las calientes (azules) a la izquierda y las frías (rojas) a la derecha. La mayoría de las estrellas se agrupan según una diagonal, la secuencia principal; arriba a la derecha se encuentran unas cuantas estrellas grandes (gigantes),y otras muy pequeñas (enanas blancas) abajo a la izquierda. Este gráfico de las propiedades de las estrellas permite que los astrofísicos comprendan cómo brillan y cómo varían las estrellas durante miles de millones de años.
Una enana blanca contiene tanta materia como el Sol, concentrada en una esfera cien veces menor: un trozo de materia de una de ellas, del tamaño de una caja de cerillas, pesaría más de diez toneladas.
En la esquina opuesta de la gráfica luminosidad-temperatura se encuentran las gigantes rojas y las super gigantes, cientos de veces mayores que el Sol. Sin embargo, una gigante roja típica no contiene más materia que el Sol; simplemente, se encuentra esparcida en un volumen enorme. La periferia de la estrella está tan alejada del centro que la gravedad es muy débil, y las capas externas de una gigante roja flotan continuamente por el espacio. Las gigantes rojas son, de hecho, estrellas ordinarias que pasan por una fase temporal de expansión a proporciones gigantes, antes de morir como diminutas enanas blancas.
La medida de la masa de las estrellas, la cantidad de materia que contienen, es muy importante para su conocimiento total. La única manera de medir la masa de una estrella se basa en el efecto de su atracción gravitatoria; en la práctica, esto significa que únicamente podemos «pesar» estrellas que pertenezcan a un sistema doble, en el cual ambas «irán una alrededor de la otra en órbitas determinadas por la fuerza gravitatoria. Afortunadamente para los astrónomos, la mayoría de las estrellas se presentan como binarias el Sol pertenece a la minoría, y se ha establecido que el rango de masas estelares se extiende desde las que son veinte veces más ligeras que el Sol hasta las que son cincuenta veces más pesadas. A lo largo de la secuencia principal, de abajo arriba, observarnos que las estrellas más luminosas y más calientes son asimismo las más pesadas. Datos posteriores sobre el estado interno de las estrellas clarificarán los secretos de las de la secuencia principal, tal como mostraremos en el capítulo 8. El astrofísico muestra esta relación en otra gráfica, la de masa-luminosidad, en la que las estrellas de la secuencia principal ocupan una estrecha banda.
§. Las estrellas inconformistas
Estas dos gráficas resumen adecuadamente las observaciones acerca de las estrellas normales: se trataría de una «crisis demográfica» de los «ciudadanos» ordinarios de la Galaxia. Sin embargo, lo extravagante, los miembros inconformistas de la sociedad, proporcionan en general el sabor y la variedad de la vida, y nuestra Galaxia tiene muchas estrellas de este tipo. Anteriormente vimos que las gigantes rojas no pueden controlar sus capas más externas de forma muy efectiva, y la mayoría de ellas pulsan lentamente con un periodo de meses. La más famosa de todas es Mira (nombre latino de «la Maravillosa», así llamada por los astrónomos medievales) en la constelación de Cetus.

La clasificación de las estrellas según su luminosidad (hacia arriba) y su masa da lugar a otro gráfico. Las estrellas más masivas («pesadas») van hacia la derecha, como lo indican los tamaños de las cajas. La secuencia principal es también diagonal, pero las estrellas gigantes quedan fuera por no ser tan pesadas como algunas de las estrellas de la secuencia principal, pese a su enorme tamaño. La teoría muestra que las propiedades de una estrella dependen principalmente de su masa y de su edad: las gigantes y las enanas blancas son estrellas viejas.
Generalmente es demasiado débil para poder reconocerla a simple vista, pero en su máxima luz es una de las estrellas más brillantes dentro de su región celeste. Las gigantes amarillas, más calientes, pulsan más rápida y regularmente; son las llamarlas Cefeidas, y se han hecho famosas porque se emplean para medida de distancias fuera de nuestra Galaxia.
Entre las estrellas cuya luz parece variar hay algunas falsas. Su oscurecimiento se debe simplemente a que una estrella de un sistema binario pasa delante de la otra y oculta su luz. La más famosa de estas «binarias eclipsantes» es Algol, en la constelación de Perseus. Su nombre significa, en árabe, «el Demonio», y su posición en la constelación representa la cabeza de la monstruosa Gorgona Medusa. Así es como los antiguos explicaban su regular oscurecimiento. Sin embargo, la primera descripción aceptable del comportamiento peculiar de Algol fue dada por el astrónomo británico sordomudo John Goodricke en el siglo XVIII. Hay muchas binarias, como Algol, demasiado cercanas como para ser «resueltas» por un telescopio, y su doble naturaleza • se determina por métodos indirectos. Guando las estrellas están extremadamente próximas, se distorsionan por las interacciones mutuas, y cada una se alarga hasta adoptar una forma oval; si pudiéramos viajar a la estrella Sheliak, en Lyra, contemplaríamos un par de huevos luminosos unidos por los extremos y girando alrededor de un punto situado a medio camino entre ellos.
Cuando una estrella es mucho más pequeña que la otra puede producirse un comportamiento aún más extraño. El gas arrancado de la mayor de las estrellas forma un disco que gira alrededor de fa estrella más pequeña (una enana blanca o incluso una estrella de neutrones más pequeña, como veremos más adelante), algo parecido a una enorme versión de los anillos de Saturno en forma gaseosa. El gas caliente emite grandes cantidades de rayos X detectables mediante satélites de «astronomía de rayos X». Ocasionalmente, el gas incidente sobre la superficie de una enana blanca podría explotar repentinamente como una bomba H a escala cósmica. El resplandor de la explosión sería miles de veces más intenso que el del sistema de estrellas original, y veríamos así aparecer en nuestros ciclos una «estrella nueva» o nova, «nuevo» en latín.
Sin embargo, las novas no son los fuegos artificiales más espectaculares que ofrece la Naturaleza. En ocasiones, una estrella podría explotar totalmente en una explosión de supernova, volviéndose temporalmente miles de millones de veces más brillante que el Sol. Semejante cataclismo cósmico puede superar en brillo, por algún tiempo, al de la galaxia entera de estrellas de la que ella había sido hasta entonces un miembro inadvertido. Después de una explosión de supernova, el núcleo colapsado de la estrella puede constituir una minúscula estrella de neutrones. Imaginemos la masa del Sol concentrada en una bola de sólo unos cuantos kilómetros de diámetro y tendremos una idea de la extraordinaria densidad de una estrella de neutrones; un trozo de materia del tamaño de una cabeza de alfiler pesaría un millón de toneladas. Alternativamente, el centro sería aún más compacto, dando lugar a un ente misterioso, un agujero negro. En esta compacta región del espacio, más pequeña que una estrella de neutrones, la materia está tan concentrada que su atracción gravitatoria alcanza una intensidad irresistible. Ni siquiera la propia luz puede escapar de un agujero negro, y cualquier cosa que cayera en él desaparecería para siempre del Universo. Sin embargo, no es aún seguro que existan agujeros negros en el Universo; después de todo, es realmente imposible ver uno, pero hay paulatinamente más evidencias indirectas de que existen estas extrañas especies.
En torno al lugar de la explosión de una supernova, los gases expandidos en la explosión pueden originar una bella nebulosa resplandeciente perdurable miles de años después de aquélla. La nebulosa del Cangrejo en Taurus es la más famosa, con una estructura filamentosa retorcida procedente de una supernova que los chinos vieron explotar en 1054 (aunque la explosión real tuvo lugar unos 6.000 años antes). Por el contrario, los restos de las explosiones de novas, mucho más débiles, desaparecen pronto.
Otro tipo notable de nebulosas rodean a algunas estrellas antiguas. Se las llama, impropiamente, nebulosas planetarias (de hecho, no tienen nada que ver con los planetas, pero se asemejan a discos parecidos a planetas cuando se las observa con un telescopio pequeño): son las capas externas de una gigante roja arrojadas mansamente al espacio, sin el alboroto ni la furia de la explosión de una nova o de una supernova. Las nebulosas planetarias son generalmente redondas y reciben nombres como el Anillo, la Pesa y las Nebulosas del Búho. Estos nombres datan de la época de la astronomía descriptiva; los descubrimientos modernos acaban generalmente en un número de catálogo, o, en el mejor de los casos, en un nombre como «Rectángulo Rojo».
§. La exploración de otras galaxias
Ventaja de vivir en el disco de nuestra galaxia es que, aunque no podamos abarcar de un vistazo cómo está dispuesto su contenido, podemos estudiarlo con gran detalle. Las demás galaxias que pueblan el Universo, hasta donde puede alcanzar el telescopio, parecen estar constituidas por los mismos tipos de objetos que vemos en nuestra propia Galaxia. Algunas están formadas únicamente por estrellas, sin gas; otras tienen mucho más gas y polvo que la Galaxia de la Vía Láctea. Pero nuestro conocimiento de las estrellas y de las nubes de gas de nuestra propia Galaxia constituye una buena guía para saber lo que ocurre en las distantes galaxias del Universo.
Varios son los métodos para medir, con distintos grados de precisión, las distancias a las otras galaxias. La mayoría de ellos se basan en el hecho de que conocemos el brillo real, la luminosidad, de ciertos objetos («candelas patrones») de nuestra propia Galaxia, y cuando identificamos estos objetos (tales como las Cefeidas variables o las explosiones de novas) en otras galaxias, su acentuación relativa nos informa de inmediato acerca de la distancia de la galaxia. Se desprende de ello que nuestra Galaxia no está aislada en el Universo, sino que forma parte de un pequeño grupo de galaxias. Este Grupo Local incluye las dos galaxias más próximas, las Nubes de Magallanes, visibles sólo desde el hemisferio austral, y descritas por vez primera por Fernando de Magallanes, en la primera vuelta al mundo (1519-1522). La galaxia de Andrómeda, visible a simple vista en una noche clara, y la más débil de las galaxias próximas, la del Triángulo, están también situadas en el Grupo Local, y son espirales como la Vía Láctea. La Galaxia de Andrómeda, realmente el objeto más lejano que podemos ver a simple vista, está a 2 1/4 millones de años luz. La luz que vemos, procedente de esta Galaxia, es anterior a la aparición de seres humanos sobre la Tierra.
Moviéndonos más allá, en las profundidades del espacio, el dominio de las galaxias se extiende hasta donde pueden llegar los telescopios mayores. Literalmente, millones de ellas han sido fotografiadas, y éstas serlo sondas más brillantes: hay muchas más, demasiado débiles para ser percibidas. Hay un gran cúmulo de galaxias en la constelación de Virgo, algunos de cuyos miembros se pueden ver con prismáticos. La luz que vemos, procedente de ellos, es de la época de la desaparición de los dinosaurios. En fotografías de larga exposición de las galaxias más lejanas, las vemos realmente como eran antes de que la Tierra naciera. Los astrónomos que estudian las profundidades del Universo son viajeros en el tiempo. Lo quieran o no, contemplan una época anterior del Universo y comparan estos resultados con datos similares de las galaxias más próximas que pueden ser engañosos. Realmente, mirando atrás en el tiempo tos astrónomos encuentran cada vez más quásares, galaxias que han sufrido una gran explosión central. Los quásares son, probablemente, galaxias muy jóvenes, y las [rodemos considerar como los «recién nacidos» del Universo.
§. El «Big Bang»
Sin embargo, el hecho más sorprendente acerca de las galaxias es que se están alejando. La interpretación usual dice que el Universo entero se expande y arrastra a las galaxias con él, como las pasas de un pastel de frutas cuando se expande en el horno. Por cierto, las observaciones confirman esta interpretación y, con ella, la implicación de que el Universo debe haber sido «más pequeño» en el pasado. Realmente, parece que hace aproximada- mente 15 mil millones de años, el Universo entero estaba concentrado en una [requería e increíblemente densa bola que hizo explosión. La continua expansión a partir de este «Big Bang» inicial se vuelve bastante evidente en la carrera de las galaxias.

Una galaxia espiral lejana compuesta por miles de millones de estrellas en la constelación Sculptor. (Todas las estrellas individuales visibles son estrellas de nuestra propia Galaxia.) Si pudiéramos ver nuestra Galaxia desde fuera nos parecería muy similar a ésta. (Copyright del Instituto de Tecnología de California y la Institución Carnegie de Washington. Reproducido con permiso de los Observatorio Hale.)
Aun cuando esta idea es fantástica, los astrónomos han encontrado que encaja con muchos acontecimientos astronómicos aparentemente no relacionados: las edades de las estrellas o la abundancia de algunos elementos en el espacio, e incluso con un débil fondo de microondas que ha permanecido probablemente desde el infierno del Big Bang.
Los cosmólogos que estudian los orígenes del Universo han intentado retroceder para encontrar lo que sucedió en la primera fracción de segundo posterior al Big Bang. El problema consiste en que la materia era muy densa, más concentrada que en una enana blanca, e incluso más densa que la materia de una estrella de neutrones. En aquellas condiciones no podía existir la materia tal y como la conocemos. Ciertamente, los átomos tampoco: habría electrones «libres», protones y neutrones. Pero si en las condiciones en las que los cosmólogos investigan ni siquiera estas partículas son estables: ¿de qué estaría hecha la materia? La única esperanza de poder resolver esta cuestión se halla en los experimentos de los físicos de partículas en los laboratorios terrestres, donde escudriñan paulatinamente de modo más profundo las partículas cada vez más pequeñas que constituyen la materia. Llegará un día en que serán capaces de decir cómo era la misma en las condiciones del Big Bang.
Y así se cerrará el círculo. En nuestra minúscula mota, la Tierra, una pequeña especie atareada, llamada Homo sapiens, construye complejos instrumentos que permitirán ver el corazón de la materia. En última instancia, su objetivo consiste, simplemente, en encontrar de qué está hecha cada cosa. Sólo cuando los astrónomos se asoman fuera de nuestro sistema planetario, a través de las estrellas de nuestra Galaxia y fuera de ella, en las extensiones del espacio intergaláctico, descubren que el Universo comenzó en condiciones más parecidas a las del blanco de un experimento de física de partículas que a las del vacío de la inmensidad de las extensiones aisladas, que asocian generalmente con el Universo. Mediante la investigación de las partículas fundamentales en un laboratorio, el físico ayuda al astrofísico a explicar cómo, a partir de un colosal Big Bang que tuvo lugar hace quince mil millones de años, nuestro Universo ha llegado a la asombrosa expansión de hoy.
Capítulo 3
La receta del Universo
Todas las cosas, desde una brisa de verano hasta el violento infierno del interior de una estrella, están constituidas por unos cuantos tipos de partículas. Como sabe todo buen cocinero, el secreto reside en la receta y en la cantidad de calor adecuada.

Un haz de electrones, confinado por campos magnéticos, sigue una estrecha trayectoria a través de una cámara de vacío. Ensayos semejantes conducirán al control del «gas» muy caliente llamado plasma y, posiblemente, a la generación de enormes cantidades de energía por fusión de los núcleos de átomos de hidrógeno.
§. La diversa familia de los leptones
§. Los quarks: los cuatro prácticamente idénticos
§. El mundo especular de la antimateria
§. Los núcleos: la clave de la diversidad
§. Los inestables núcleos gigantes
§. La agrupación adecuada: los estados de la materia
Desde el punto de vista de los físicos, el Universo, como sella mencionado anteriormente, está constituido por sólo unos cuantos tipos de partículas fundamentales: los miembros de las familias de los quarks y de los leptones. La diversidad de nuestro entorno y las maravillas que se encuentran en las profundidades del espacio son simplemente resultado de que los ingredientes básicos de la Naturaleza, bajo la influencia de sus fuerzas mutuas, se disponen de formas diferentes.
§. La diversa familia de los leptones
Anteriormente efectuamos una breve introducción a la familia de los leptones. Desde el punto de vista práctico, el más importante, con mucho, es el atareado electrón. Bien sea girando alrededor del núcleo de un átomo, bien moviéndose a través de un alambre en tanto que corriente eléctrica, bien agrupando los átomos en moléculas, o desplazándose a través del vacío de un tubo de televisión para formar una imagen, el electrón nos resulta indispensable pese a ser una insignificante partícula, 1.836 veces más ligera que el [trotón (leptos, en griego, significa «pequeño»).
Un electrón transporta una unidad de carga eléctrica negativa. En la vida diaria pensamos en la carga eléctrica; la de un peine de carey, por ejemplo) como algo cuyo valor podemos variar a voluntad. La Naturaleza, sin embargo, ha decretado que la carga se presente únicamente en paquetes de un tamaño determinado, y cada electrón constituye una de estas unidades básicas de carga.
En física moderna, la idea de, una unidad básica de algo, un'«paquete» tan pequeño como sea posible, o cuanto, es bastante natural. Desde que la teoría cuántica revolucionó la física a comienzos de este siglo, los científicos han aceptado que la mayoría de las magnitudes, incluida la energía, se presentan en «¡jaqueles» discretos, es decir, constan de unidades simples y sólo pueden aumentar o disminuir en saltos de una unidad. Por ejemplo, otra propiedad de las partículas, también cuantizada de esta forma, es el spin o grado de momento angular que posee una partícula. Sin embargo, la escala de nuestro mundo es tan grande en comparación con estas unidades básicas que sus variaciones nos parecen continuas. Si desconectamos un tocadiscos, su plato se irá deteniendo gradualmente hasta que la fricción lo pare. En realidad, está perdiendo unidades enteras de spin una a una y deteniéndose a saltos, pero como el número inicial de unidades de spin era tan grande, el plato pierde unos diez quintillones de estas unidades por segundo, por lo que da la impresión de que el frenado es continuo.
Los cambios discontinuos en la Naturaleza sólo pueden detectarse con experimentos muy sensibles. El célebre físico americano Robert Millikan fue el primero en medir la minúscula carga eléctrica de los electrones en 1912 equilibrando gotitas de aceite cargadas eléctricamente entre dos fuerzas: la atracción de la gravedad hacia abajo y un campo eléctrico aplicado que empujaba estas gotas, cargadas negativamente, hacia arriba. Observaba la gota en un microscopio, y al alcanzar el equilibrio crítico, la misma quedaba suspendida en el aire, inmóvil; Millikan podía entonces calcular la carga de la gota, y así encontró que siempre era múltiplo entero de una determinada cantidad, pues cada gota tenía más de un electrón.
La realización del experimento no fue tan sencilla, ya que mientras observaba una gota su carga ¡jodía cambiar en una unidad si perdía un electrón o ganaba otro de sus alrededores, perturbándose su equilibrio crítico y comenzando a oscilar hacia arriba y hacia abajo, por lo que Millikan tenía que reajustar rápidamente el campo eléctrico; pero al hacerlo, las gotas se cargaban de forma diferente dando otro resultado. Por tanto, la forma más eficiente de llevar a cabo el experimento era seguir el curso de una única gota. En una ocasión Millikan estuvo observando en su microscopio una minúscula gota de aceite durante ¡dieciocho horas seguidas!
Habida cuenta su importancia en la constitución de la materia, el electrón es el miembro más estudiado de la familia de los leptones. Su hermano mayor, el muón, siempre ha sido mucho más enigmático. Fue descubierto en 1937 mientras los físicos buscaban otra partícula, y se malinterpretó su naturaleza durante muchos años («muón» es la abreviatura de «mesón-mu», clasificándosele desde el principio como un mesón, una partícula de «tamaño medio», del griego mesos, «medio»). Al reconocer que se trataba de un leptón, pese a ser 207 veces más pesado que el electrón, su existencia resultó bastante embarazosa para los físicos. ¿Por qué tendría «necesidad» la Naturaleza de otro leptón tan particularmente inestable como el muón, que vive únicamente un par de millonésimas de segundo antes de desintegrarse en un electrón y dos neutrinos? Las teorías modernas sugieren que el número de tipos de leptones se relaciona con el número de quarks diferentes, y ciertamente es interesante que al mismo tiempo que experimentos muy recientes han comenzado a mostrar la evidencia de un quinto quark, otros investigadores hayan encontrado indicios de otro leptón aún más pesado que el muón. Este leptón de vida extremadamente breve parece ser unas .3.500 veces más pesado que el electrón.
Dos tipos de neutrinos completan la familia de los leptones (hasta el presente), uno de ellos asociado al electrón y el otro al muón (aunque presumiblemente exista otro asociado al nuevo leptón pesado). Los neutrinos son las partículas más extrañas descubiertas por los físicos de partículas, pues no tienen masa ni carga eléctrica y se mueven siempre a la velocidad de la luz. La primera y la última característica se relacionan mediante la famosa teoría de la relatividad de Einstein, que prohíbe que cualquier partícula con masa viaje a la velocidad de la luz; recíprocamente, esto supone que una partícula sin masa (como un neutrino) sólo pueda moverse a la velocidad de la luz. En este caso, la teoría muestra que la partícula transportará energía a pesar de su falta de masa.
Los neutrinos, por tanto, tienen energía aun cuando son notablemente esquivos. No responden a ninguna de las dos fuerzas más fuertes (nuclear fuerte y electromagnética) y sólo se manifiestan, muy ocasionalmente, cuando reaccionan con otro leptón por intermedio de la fuerza débil. Los neutrinos son muy específicos en sus afinidades. Así, el neutrino asociado al electrón únicamente se asociará con electrones, y el neutrino asociado al muón, con un muón.

Un chorro de partículas cargadas eléctricamente entra en la cámara de burbujas del CERN, en Ginebra, dejando trazas de burbujas microscópicas.
Por ejemplo, cuando un muón se desintegra en un electrón se producen dos neutrinos: un neutrino asociado al muón original y un neutrino asociado al electrón resultante. (Estrictamente hablando, este último es un antineutrino asociado al electrón, como veremos más adelante).
La familia de los leptones es un cajón de sastre, ya que resulta posible «intuir» cómo son un electrón o un muón, pero los neutrinos parecen desafiar al sentido común. Aceptemos sin embargo a estos díscolos miembros tal como la Naturaleza nos los ha dado, y conozcamos a la otra familia de partículas.
§. Los quarks: los cuatro prácticamente idénticos
Los quarks parecen un grupo mucho más homogéneo a primera vista. Los cuatro quarks no parecen diferir mucho entre sí, sino lo suficiente para distinguirlos. Este hecho proviene en realidad de nuestra incapacidad para observarlos como quarks aislados. Al contrario de los leptones, los quarks, ligados por la fuerza fuerte, son una familia enormemente gregaria y hasta ahora los físicos no han logrado descomponer una partícula compuesta (como un protón) en sus quarks constituyentes. Lo que conocemos acerca de los quarks se ha deducido de su comportamiento como grupo.
Los nombres que han recibido los quarks son menos «clásicos» que los de los leptones, lo que refleja la perspectiva menos tradicional de los físicos de los años 1960 y 1970. Los cuatro quarks establecidos se denominan arriba, abajo, extraño y encantado. Los dos primeros son los quarks «cotidianos»; constituyen los protones y neutrones que forman el núcleo de los átomos ordinarios y básicamente se diferencian en su carga eléctrica.

El positrón o antielectrón se descubrió sobre esta histórica fotografía tomada por Carl D. Anderson en 1932. Un positrón, procedente de un chaparrón de rayos cósmicos, entra en la cámara de niebla (precursora de la cámara de burbujas) por la derecha, y es frenado por la placa de plomo central. Un campo magnético aplicado le obliga a describir una trayectoria curva. La curvatura hacia abajo prueba que está cargado positivamente y que, por tanto, no es un electrón ordinario (cargado negativamente).
El quark extraño tiene una propiedad adicional, tan desconcertante para los físicos que la descubrieron flor primera vez que la llamaron sencillamente «extrañeza».
El quark extraño puede transformarse espontáneamente en un quark arriba o abajo bajo la influencia de la fuerza débil, pero no de la fuerza fuerte. Las vidas medias de las partículas que contienen un quark extraño son por tanto mucho mayores de las esperadas: una vida «larga» en este contexto significa una mil millonésima de segundo.
De forma similar, el cuarto quark tiene otra propiedad relacionada con su desintegración en otros quarks, pero en 1974, momento de su descubrimiento, la teoría ya había predicho su existencia y dio a la nueva propiedad el nombre de «encanto».
(El juego de los nombres continúa con la probabilidad de existencia de otros dos quarks. Para el quinto y el sexto compiten un par de nombres: bien belleza y verdad, bien fondo y cima. Está por verse el que los físicos de la generación actual prefieran la denominación caprichosa o la práctica.)
Lo más extraño de los quarks, además de la aparente imposibilidad de aislarlos individualmente, es que sus cargas eléctricas no son unidades enteras de carga: la cantidad de carga es 1/3 o 2/3 la del electrón. Sin embargo, cuando otras partículas están constituidas por quarks, su carga total es siempre cero, 1 ó 2 unidades básicas (la del electrón). Los experimentos actuales sólo pueden estudiar partículas constituidas por quarks y no los propios quarks individualmente y, por tanto, las cargas de todas las partículas detectadas realmente en los experimentos se basan en la misma unidad que la del electrón. Por ejemplo, el protón está constituido por dos quarks arriba (cada uno con carga +2/3) y un quark abajo (carga —1/3), de forma que la carga total es 2/3 +2/3—1/3= + 1 unidad de carga. En el neutrón, las cargas de los dos quarks abajo (cada una de —1/3) cancelan la carga de un quark arriba (+ 2/3) dando una carga total nula.
Otras partículas «pesadas» (bariones, del griego barys, «pesado») pueden estar constituidas por combinaciones diferentes de tres quarks unidos por la fuerza nuclear fuerte. Las combinaciones que contienen uno (o más) quarks extraños son las «partículas extrañas», que trajeron de cabeza a los físicos de partículas en la década de 1950 por su extraña forma de desintegrarse.

La evidencia de un cuarto tipo de quark, pues esta interacción no tendría lugar si sólo existieran tres tipos. Un neutrino penetra en la cámara de burbujas del CERN en A e interacciona con un neutrón produciendo una insólita lluvia de fragmentos, que incluye una partícula inalterada «extraña» (S); ésta se desintegra en dos partículas que emergen en la estrecha formación V. Las trazas señaladas con e+ y u— se originan por un positrón y un muón.
Uno de los más recientes éxitos de la teoría de los quarks fue la predicción de un barión constituido por tres quarks extraños, que tendría una extrañeza de menos tres y una carga eléctrica de menos uno. En 1964 se encontró una partícula semejante, llamada omega minus, con la masa predicha, coronándose así los esfuerzos de Murray Gell-Mann y colaboradores e integrándose en la larga tabla de las viejas partículas «fundamentales» en términos de una simple estructura de quarks.
Deben existir asimismo bariones que contengan el cuarto tipo de quarks, los encantados, aunque en los pocos años transcurridos desde el descubrimiento del encanto sólo se han encontrado una o dos de estas esquivas partículas encantadas.
A pesar de la generosidad de la Naturaleza al suministrar ocho partículas primarias, cuatro quarks y cuatro leptones (que posiblemente se incrementen a un total de doce si se confirman los recientes descubrimientos), la materia ordinaria únicamente utiliza tres o cuatro: los quarks arriba y abajo y el electrón, con la contribución muy ocasional del neutrino asociado al electrón. Los quarks arriba y abajo se combinan para constituir los protones y neutrones de los núcleos atómicos, mientras que los electrones se sitúan en órbita a su alrededor dando lugar a los átomos y a las moléculas de la materia; o bien pueden proseguir sus propios caminos en las rigurosas condiciones existentes en las lejanas extensiones del Universo.

El planeta Tierra fotografiado desde nuestra vecina Luna por los astronautas del Apolo. En la Luna un hombre pesa sólo un sexto de su peso normal, y en el espacio puede ser totalmente ingrávido, aunque la cantidad fundamental de materia siga siendo la misma, esta es lo que los físicos llaman «masa».
¿Qué necesidad hay entonces de los quarks extraño y encantado y del muón, por no mencionar los nuevos quarks y leptones? Todas estas partículas son inestables y se desintegran en una fracción de segundo. Sólo se las puede estudiar generándolas en un moderno acelerador de partículas y registrando el breve momento de su existencia. Sin embargo, estas efímeras partículas contienen importantes pistas {jara quienes investigan en las fuerzas nucleares fuerte y débil.
Por ejemplo, la unificación de las fuerzas electromagnética y débil, debida a Steven Weinberg y Abdus Salam, no hubiera sido posible si, como entonces se pensaba, sólo hubieran existido tres quarks.
La audaz suposición de un cuarto quark con una nueva propiedad (encanto) resolvía el problema teórico y, efectivamente, se encontraron posteriormente partículas conteniendo un quark encantado. Iros teóricos creen ahora que los diferentes tipos de quarks y leptones se manifestarán como un producto secundario de la forma en que se relacionen las fuerzas de la Naturaleza. Una síntesis semejante, que relacione las partículas fundamentales con las diferentes formas en las que una sola fuerza unificada produzca los efectos de las cuatro fuerzas «patrones», constituye una de las metas más importantes de la física moderna.
§. El mundo especular de la antimateria
Volviendo a las partículas fundamentales, los físicos han descubierto un nuevo campo de la existencia: el misterioso mundo de la antimateria. Cada tipo de partícula fundamental tiene una antipartícula cuyas propiedades son exactamente opuestas.
Si, por ejemplo, tomamos el electrón, con su carga de 1 unidad, el antielectrón tiene una carga de +1; o bien, si consideramos el recientemente descubierto quark encantado, que tiene una carga eléctrica de +2/3 y un encanto de + 1 unidad, el antiquark encantado tiene una carga de — 2/3 y un encanto de — 1. Existe un antiquark por cada tipo de quark y un antileptón por cada tipo de leptón; y cada antipartícula refleja las propiedades de la partícula correspondiente. ¿Deberíamos, pues, ampliar la tabla de
las partículas fundamentales a fin de incluir las antipartículas? Podría pensarse que nuestro conjunto de cuatro quarks y cuatro leptones debería duplicarse para dar cabida a cuatro antiquarks y cuatro antileptones.
Afortunadamente para la simplicidad básica del Universo, no hemos de hacerlo, pues cada antipartícula se opone tan fielmente a la partícula correspondiente que es evidentemente la «otra cara» de nuestras partículas familiares.
Sobre esta base, el gran físico británico Paul Dirac predijo hace unos cincuenta años, cuatro antes de que se encontrara experimentalmente la primera antipartícula, que debería existir la antimateria. Al combinar la teoría de la relatividad de Einstein con la teoría cuántica, que describe cómo se comportan las partículas a muy pequeña escala, encontró con sorpresa que era bastante posible que existieran partículas exactamente opuestas a las ordinarias. (Matemáticamente, era como resolver una ecuación cuadrática con una solución positiva y otra negativa.) Sus ideas se consideraron en principio como un resultado matemático interesante sin ningún significado real, pero el descubrimiento en 1932 del antielectrón (normalmente llamado positrón a causa de su carga eléctrica positiva; y posteriormente de otras antipartículas, dejó claro que las antipartículas eran definitivamente reales. De hecho, las actuales teorías de partículas fundamentales no son válidas sin la inclusión de las antipartículas.

Albert Einstein fue el primero en verificar que puede considerarse a la materia corno una Joma de energía, abriendo así el camino al descubrimiento de la antimateria. En la fotografía, Einstein impartiendo un seminario informal.
El problema que se presenta al estudiarse antipartículas reside en que son exactamente «anti». Todas sus propiedades son un reflejo preciso de las de la partícula correspondiente: carga eléctrica, extrañeza y encanto, como hemos visto anteriormente, y también de otras propiedades que los físicos puedan asignarles. Así, cuando una antipartícula producida en un laboratorio se encuentra con su partícula correspondiente de materia «ordinaria», se cancela cada una de sus propiedades. Por ejemplo, si un antiquark encantado colisiona con un quark encantado, el encanto de — 1 de la primera de las partículas se destruye con el encanto +1 de la otra, y su carga eléctrica de —2/3 se aniquila con la carga +2/3 del quark ordinario. Toda propiedad que distingue una partícula de otra se destruye con una sola excepción: su masa.
La masa, en este sentido, no se corresponde con el término que utilizamos habitualmente. Vulgarmente hablando es «la cantidad de materia que contiene un cuerpo» y tiene dos efectos. Uno es la gravitación. La fuerza gravitatoria que atrae a dos cuerpos depende de sus masas. Una persona adulta es más masiva que un gato, de forma que la fierra le atraerá con una fuerza mucho mayor, como puede demostrarse con una simple báscula de baño. Supongamos, sin embargo, que llevamos la báscula a la Luna. Como ésta tiene menos masa que la fierra, la fuerza gravitatoria entre aquellos cuerpos y la Luna será solamente un sexto de la que ejerce la Tierra en el baño de nuestra casa, y la báscula demostrará que los pesos son proporcionalmente menores.
Esto no significa que seamos más delgados por el mero hecho de estar en la Luna: la cantidad de materia de nuestros cuerpos, la masa, es la misma. Por tanto, la fuerza gravitatoria no es evidentemente la mejor forma de medir masas, y los científicos prefieren definir la masa de una forma diferente: en términos de inercia, resistencia a la aceleración. Si damos una patada a un balón de fútbol y a una pelota de tenis con la misma fuerza, esta última saldrá disparada con más facilidad ya que su masa es mucho menor, e incluso en la ingravidez del espacio nos encontraríamos exactamente con el mismo efecto, ya que la masa es una de las propiedades fundamentales de un objeto, independientemente de donde se encuentre.
Un aspecto aparentemente extraño de la antimateria es que, pese a sus «anti» propiedades, una. antipartícula tiene la misma masa que su correspondiente partícula, es decir, no tiene masa negativa. Si fabricásemos un balón de fútbol de antimateria, sería atraído por la gravedad terrestre con la misma intensidad que un balón de fútbol ordinario. Existe sin embargo un problema mayor al chutar un antibalón: la aniquilación explosiva de las partículas (de nuestro zapato) con las antipartículas (del «antibalón») arrasaría el zapato, el campo de fútbol y la propia ciudad en un cataclismo de proporciones similares al de la bomba H (en realidad esto ocurriría en el instante en que el antibalón hiciera su aparición en el mundo real).
Albert Einstein fue el primero en mostrar, a finales de 1907, que teóricamente es posible convertir masa en energía, y, además, en una asombrosa cantidad de energía. Para calcularla se multiplica la masa en cuestión por la velocidad de la luz y de nuevo por la velocidad de la luz: Energía (E) = masa (m) × velocidad de la luz (c) × velocidad de la luz (c), o, matemáticamente, E = m × c × c, que abreviada constituye la ecuación más famosa de la ciencia: E = mc2. La ecuación de Einstein muestra que teóricamente podríamos destruir un kilogramo de materia de cualquier clase con el fin de producir la energía suficiente para alimentar durante un año una central gigante, sustituyendo así, materialmente, millones de toneladas de carbón o de fuel.
Afortunadamente, un kilo de azúcar no se convierte por sí solo, de forma espontánea, en energía. Las partículas primarias que constituyen el azúcar, quarks arriba y abajo y electrones, tienen carga eléctrica y otras propiedades que no pueden desaparecer' ¡tara dar «masa pura» capaz de convertirse en «energía ¡jura». La materia ordinaria por sí sola es por tanto inmune a la destrucción total. No obstante, hemos visto que cuando una partícula y su antipartícula se encuentran, todas las propiedades «conservadas» (como la carga eléctrica) se cancelan por completo, pero la partícula y la antipartícula tienen masa positiva y toda ella se transforma en un instante en energía.
Por esta precisa razón, a los físicos les es difícil estudiar las antipartículas; no existe posibilidad de mantenerlas, pues tan pronto como se ponen en contacto con la materia real se destruyen. Sin embargo, los físicos pueden crear antipartículas invirtiendo el proceso. Cuando se concentra suficiente energía en un punto e$ posible que se convierta espontáneamente en masa. No sería posible crear una única partícula, por ejemplo un electrón, de esta forma, ya que ello conllevaría la creación de carga eléctrica de la nada. Ahora bien, puede darse la creación simultánea de un electrón y su antipartícula, un positrón, pues como uno tiene carga negativa y otro positiva no contribuyen a aumentar la carga total del Universo. La «producción de pares» de partículas y antipartículas es un proceso común en los actuales aceleradores de partículas de altas energías, y realmente constituye la única forma de «fabricar» antipartículas.
Al igual que los quarks ordinarios, los antiquarks no se han encontrado individualmente, sino sólo unidos en partículas más pesadas. Los antibariones están constituidos por grupos de tres antiquarks, como el antiprotón (2 antiarriba, 1 antiabajo) con una carga eléctrica negativa, y el antineutrón (1 antiarriba, 2 antiabajo) que no tiene carga eléctrica. Superficialmente, el neutrón y el antineutrón parecen muy similares, con la misma masa y carga. Sin embargo, los quarks constituyentes del 'neutrón ordinario (1 arriba, 2 abajo) son claramente diferentes de los del antineutrón, y es evidente que un neutrón que encontrara una partícula de idéntica masa y sin carga «reconocería» por sus quarks si es neutrón o antineutrón: amigo o enemigo.
La agrupación de tres quarks es bastante extraña, ya que no se encuentran combinaciones de quarks y antiquarks en el mismo barión. Obviamente, una disposición semejante no sería permanente, ya que como el protón es el único barión de larga vida y cualquiera de las otras partículas son de vida breve, se transformarían en último término en protones. Por otra parte, es posible que un quark y un antiquark (bien del mismo tipo o de tipos diferentes) formen un par de vida breve. Estas combinaciones de quarks y antiquarks se llaman mesones y constituyen una familia aparte dentro de la antigua clasificación (que se hizo paulatinamente más complicada hasta que se comprendió sólo en términos de unos cuantos quarks). El nombre de mesón se aplicaba a partículas de masa media (del griego mesos, «medio») en contraposición con los bariones más pesados (barys, «pesado») y con los leptones más ligeros (leptos, «pequeño»). En la actualidad, estos términos no tienen el mismo significado y un barión se define ahora como una partícula compuesta de tres quarks y un mesón, como un par quark-antiquark, mientras que los leptones constituyen una familia aparte, diferente de los quarks. En consecuencia, las masas de las diferentes clases ahora se solapan, discrepando totalmente de sus significados originales; por ejemplo, el «quinto leptón» recientemente descubierto tiene una masa que es el doble de la del más ligero de los bariones, el protón.
El mesón más común es el pión, una partícula que encontraremos de nuevo relacionada con la fuerza nuclear fuerte. Fue predicho mucho antes de su descubrimiento, y aunque durante algún tiempo se lo confundió con el muón (que tenía una masa próxima a la predicha), el ¡)ión se detectó con éxito en 1947. En estos primeros experimentos, los aceleradores de partículas de que se disponía no eran suficientemente potentes como para producir partículas de esta clase, y los experimentadores se vieron obligados a confiar en los titánicos aceleradores de partículas naturales: las estrellas en explosión. En estas formidables y poco comunes explosiones de supernova, los protones son acelerados a enormes velocidades y, tras una larga travesía espacial, algunos colisionan con la atmósfera de la Tierra. Los núcleos de los átomos del aire aguantan la violenta embestida y en las colisiones de alta energía se crean muchas partículas y antipartículas nuevas. Positrones, mitones y piones fueron de los primeros restos de estos «chubascos» de rayos cósmicos.
Tampoco en los aceleradores de partículas modernos se pueden alcanzar las energías de los protones más rápidos de rayos cósmicos, pero estas máquinas tienen la gran ventaja de producir un haz rápido con una concentración de partículas mucho mayor. Asimismo, permiten que el experimentador elija el tipo de partículas que se lanzan a través del acelerador, así como que se modifique el blanco.
Es como usar una antorcha para orientarnos en una noche oscura en vez de esperar los relámpagos, mucho más luminosos pero menos frecuentes.

Sobre la parte superior de la atmósfera inciden de continuo partículas de rayos cósmicos; experimentos llevados a cabo por medio de globos pueden detectar algunas partículas mucho más energéticas que las de los aceleradores de partículas de los físicos. Puesto que las partículas eléctricamente cargadas son desviadas por el campo magnético terrestre, los rayos cósmicos se concentran en las regiones polares norte y sur.
Antes de abandonar el ámbito de las antipartículas, veamos la posibilidad que existe de encontrar antimateria a gran escala. Teóricamente no hay ninguna razón por la que antiprotones y antineutrones no se puedan agrupar por medio de la fuerza fuerte para originar antinúcleos cargados negativamente. Los positrones se hallarían en órbita alrededor de estos antinúcleos y constituirían los antiátomos de los distintos elementos. Químicamente, los antiátomos reaccionarían con otros exactamente de la misma forma que los átomos correspondientes, y podrían constituir antimateria a escala macroscópica (tamaño ordinario). Serían posibles el antiagua, la antiarena e incluso antipersonas que vivirían en un antiplaneta que se hallaría en órbita alrededor de una antiestrella.
¿Existen realmente estas antiestrellas y estos sistemas antiplanetarios en el Universo? Ciertamente no pueden existir en nuestra Galaxia, ya que serían gradualmente aniquilados por el tenue gas existente entre las estrellas. La energía de aniquilación originaría rayos gamma, y estos rayos (no confundirlos con los «rayos cósmicos» que son en realidad partículas, fundamentalmente protones) habrían sido detectados por satélites construidos con este propósito.
Argumentemos, sin embargo, a una escala más distante. Aunque nuestra Galaxia —{Manetas, estrellas y gas interestelar - debe estar constituida en su totalidad por materia ordinaria, ¿podrían otras galaxias estar constituidas totalmente de antimateria? La luz emitida por la antimateria sería exactamente la misma que la de la materia, por lo que resulta imposible decirlo observando una galaxia, ni siquiera analizando su luz con detalle. Sin embargo, existe un gas extremadamente tenue que llena el espacio entre las galaxias, y de nuevo podríamos esperar detectar rayos gamma procedentes de galaxias que estén errando en las regiones de antigás, o bien de antigalaxias rodeadas de gas ordinario. Como estos rayos gamma no se han detectado, los astrónomos están en general de acuerdo en que nuestro Universo debe estar constituido totalmente por materia ordinaria: la antimateria es una curiosidad de laboratorio creada sólo para desaparecer rápidamente otra vez, al aniquilarse con una partícula de materia ordinaria.
§. Los núcleos: la clave de la diversidad
Si se considera el Universo en conjunto, la inmensa mayoría de la materia consta de protones y electrones. Aunque se encuentran en igual número (para que se cancele la carga eléctrica total), la mayor parte de la masa del Universo está contenida en los protones, que son más pesados. Esta situación no es sorprendente, ya que protones y electrones son las únicas partículas fundamentales estables (aparte de los neutrinos), y aun cuando el Universo hubiera estado formado en una época anterior por una mezcla de partículas, como sugieren las teorías modernas, las otras se habrían desintegrado en la actualidad.
Los muones y otros posibles leptones habrían degenerado rápidamente en electrones, mientras que los quarks que constituyen los bariones habrían evolucionado progresivamente al «estado de energía» más bajo, dos quarks arriba y un quark abajo, que es el que caracteriza al protón. (Volveremos sobre la cuestión de los estados de energía en este capítulo.)

Las trazas de las partículas cargadas producidas por los aceleradores del CERN se fotografían en esta gran cámara de burbujas. Contiene 35.000 litros de hidrógeno liquido que se mantiene a -254 °C a baja presión, con el fin de que las partículas provoquen la formación de una lima de burbujas. Las partículas penetran a través de las ventanas de metal delgado del centro.
Incluso el neutrón no es intrínsecamente una partícula estable, ya que después de una vida media de un cuarto de hora, un tiempo enormemente largo comparado con las vidas esperadas de otras partículas, uno de los quarks abajo cambiará espontáneamente a un quark arriba alterando la configuración de un quark arriba y dos abajo de la partícula, hasta dos arriba y uno abajo, estado de quarks de un protón. En el proceso se liberarán un electrón, que transporta una unidad de carga negativa para equilibrar la carga positiva del nuevo protón creado, y un antineutrino asociado al electrón.
Entonces, ¿por qué el Universo no está únicamente ocupado por protones y electrones? (En términos químicos, esto constituiría el gas hidrógeno; véase más abajo.) En tal caso, el Universo sería un lugar incoloro, sin planetas y sin vida. Afortunadamente, los neutrones pueden estabilizarse, preservándose de la desintegración, cuando se combinan con protones en pequeños cúmulos ligados por la fuerza nuclear fuerte. Cúmulos de este tipo son los que constituyen el centro, núcleo cargado positivamente, de todos los átomos excepto del de hidrógeno (cuya carga central positiva se debe a un único protón).
En el inmenso Universo exterior a la Fierra, y en la acción controlada del acelerador de partículas de un físico, los núcleos se pueden presentar sin los electrones circundantes que constituyen los átomos, y que son los que determinan sus propiedades químicas. Un núcleo recibe generalmente el nombre del átomo que formaría, aun cuando se encuentre en una situación en la que ha sido despojado de todos sus electrones. Por ejemplo, en el corazón incandescente de una estrella se pueden fusionar tres minúsculos cúmulos, conteniendo cada uno dos protones y dos neutrones, para dar un cúmulo de seis protones y seis neutrones. Los cúmulos originales son idénticos a los núcleos que se encuentran en él gas helio, mientras que el producto es el núcleo de un átomo de carbono. Por tanto, la reacción puede describirse 3 He—>C, donde los símbolos se refieren a los cúmulos protón-neutrón, a la sazón no necesariamente situados en los centros de los átomos.
Para explicar la razón de que los neutrones sean estables en cúmulos (núcleos) pero no fuera de ellos, debemos primero preguntarnos por qué los neutrones «libres» son inestables. Básicamente, se trata de una cuestión de energía. En una interpretación muy simple, siempre que por cualquier procedimiento la energía se escapa, intenta expandirse. El Sol produce una gran cantidad de energía por segundo como consecuencia de las reacciones nucleares que tienen lugar en su núcleo, y la radiación calorífica y luminosa de su superficie expande esta energía por el Universo. Por acudir a otro ejemplo, el aire a presión en el interior de un globo hinchado tiene un exceso de energía; al deshincharse el globo, las moléculas de aire que escapan esparcen el exceso de energía por la habitación. De igual forma, la configuración de quarks del neutrón se halla en un «estado de energía» mayor que la del protón y puede perder energía convirtiendo un quark abajo en un quark arriba. El exceso de energía se transporta y se expande como energía de movimiento del electrón y del antineutrino, y también como la masa del electrón (según la ecuación masa-energía de Einstein).
A propósito, esta degradación de la energía se conoce como segundo principio de la termodinámica y se estudió primero en relación con diversos tipos de máquinas. ¿Por qué no es capaz un transatlántico de bombear agua del mar a la cubierta, extraer su energía calorífica para mover sus máquinas y arrojar luego el agua fría al océano? liste tipo de proceso es, sin embargo, imposible, ya que implicaría concentrar espontáneamente energía en un lugar a partir de una fuente extensa. Según el segundo principio, sólo pueden ocurrir espontáneamente aquellos procesos que produzcan expansión de energía; jamás se podrá esperar que el aire de una habitación se comprima de pronto en un globo y que éste explote de forma espontánea. A muy largo plazo, el segundo principio predice que toda la energía del Universo se expandirá por igual; no habrá ninguna parte más caliente o más fría que otra, por lo que no será posible generar energía y el Universo acabará en una «muerte térmica».
El concepto de entropía es otra forma de expresar el segundo principio. La entropía de un sistema es una medida de su desorden; en otras palabras, la energía siempre pasa de un estado aprovechable a otro no aprovechable. Cuando quemamos carbón en una central eléctrica, transformamos la energía latente del carbón en energía eléctrica, pero el resultado es una pérdida neta de energía aprovechable: el carbón se ha consumido y su energía latente no se puede recuperar. Lo más interesante de la entropía es que determina la dirección del tiempo: el tiempo viaja siempre en la dirección en que aumenta la entropía. Si tomamos una película de un péndulo que oscile, no habrá diferencia en que la película se mueva hacia adelante o hacia atrás; pero si filmamos un péndulo cuya oscilación se amortigua como consecuencia de una fricción, será obvio de inmediato el sentido en que debe pasarse la película.
Volviendo al neutrón, podemos prevenir su desintegración llevándole a una situación en la que para desintegrarse necesite tomar energía. Dos protones y dos neutrones ligados por la fuerza fuerte forman un núcleo de helio. Si uno de los neutrones se desintegrara, el cúmulo contendría tres protones y un neutrón y pasaría a ser una agrupación de mayor energía que el núcleo original de helio. Aunque la fuerza nuclear de enlace permanecería esencialmente invariable, existirían entonces tres protones cargados positivamente en lugar de dos, repeliéndose unos a otros por una repulsión del «tipo» de la de las cargas eléctricas. Así, mientras que la desintegración de un neutrón llevaría al propio neutrón a una energía inferior, dejaría al núcleo en un estado de energía superior. Sumando las columnas del debe v haber de la energía, concluiríamos en que tal desintegración requeriría un aporte de energía al núcleo; el segundo principio de la termodinámica prohíbe, pues, la desintegración de los neutrones cuando están encerrados en un núcleo de helio.
De igual forma, cualquier pequeño cúmulo de protones y neutrones es estable mientras el número de protones y neutrones sea prácticamente el mismo. Cuando estos núcleos están revestidos de electrones, constituyen los átomos de los elementos químicos, como el carbono, el oxígeno o el hierro. Las propiedades químicas de los elementos dependen sólo del número de electrones que se hallan en órbita, que debe ser igual al número de protones cargados positivamente del núcleo con el fin de asegurar que el átomo sea un conjunto eléctricamente neutro. A ello se debe que podamos caracterizar un núcleo por el nombre de un elemento, aun cuando, estrictamente hablando, el término «elemento» se refiera al comportamiento químico.)
Nótese que el número de neutrones no participa del razonamiento, por lo que es posible tener dos átomos con idénticas propiedades químicas pero con diferente número de neutrones en el núcleo. Por ejemplo, todos los átomos de carbono tienen seis electrones en órbita y seis protones (-ti el núcleo. Casi todos los átomos de carbono tienen seis neutrones en el núcleo, pero uno de cada cien tiene siete, listos átomos más pesados se comportan químicamente como átomos de carbono ordinario y sólo se pueden poner fie manifiesto mediante sensibles medidas físicas de masas atómicas. Los núcleos con el misino número de protones y lo tanto con el mismo nombre químico;, pero diferente número de neutrones, se llaman isótopos del griego «igual lugar», que es el que les corresponde en la tabla química de los elementos : los podemos distinguir escribiendo el número total de partículas nucleares a continuación fiel nombre químico. Así, el carbono ordinario es carbono-12, mientras que el isótopo más pesado es carbono-13.
Cuando los núcleos de los isótopos no son estables, nos pueden ser muy útiles; estos isótopos radiactivos «radioisótopos» se comportan químicamente como elementos normales, pero se pueden detectar por las radiaciones que emiten cuando sus núcleos cambian espontáneamente a variedades más estables. Los radioisótopos suelen emplearse en medicina; por ejemplo, la actividad de la glándula tiroides, que acumula yodo, se puede controlar inyectando una pequeña cantidad de radioisótopo de yodo en el torrente sanguíneo y midiendo la radiactividad de la glándula.
La física y la química aplicadas también se han beneficiado del empleo de los radioisótopos de innumerables formas, y su aplicación ha alcanzado incluso al campo de la arqueología. El isótopo de los arqueólogos es el carbono-14, un núcleo inestable originado por los impactos de las partículas de rayos cósmicos, procedentes del espacio, sobre los núcleos de átomos de carbono del gas dióxido de carbono de las capas altas de la atmósfera terrestre. A resultas de ello, las moléculas de dióxido de carbono del aire contienen un porcentaje pequeño, pero prácticamente constante, de carbono-14, ya que los núcleos de carbono-14 recientemente formados reponen las existencias quise desintegran constantemente. El núcleo de carbono-14 tiene demasiados neutrones (ocho) para sus seis protones, y cuando eventualmente se desintegra un neutrón deja al núcleo con siete protones y siete neutrones, configuración estable del nitrógeno-14.
El químico americano Willard Libby señaló que la presencia natural de carbono-14 podría permitir que los arqueólogos fechasen restos que contuvieran carbono, principalmente madera, huesos y cenizas. Mientras vive, una planta o un animal intercambian carbono con su entorno, y, al igual que en el aire, se mantiene constante la proporción del isótopo de carbono inestable; pero tan pronto como el organismo muere y cesa el aporte de carbono-14 nuevo, no se reemplaza el que se desintegra en los restos y la proporción disminuye gradualmente. Puesto que se conoce el ritmo al que se desintegra el carbono-14 en nitrógeno-14, un científico puede medir la proporción de carbono-14 en una pequeña muestra orgánica (20 gramos son suficientes para un análisis) y calcular cuánto hace que murió. Las fechas calculadas por este procedimiento se remontan a 60.000 años en el pasado del hombre.
Sin embargo, hicieron falta diez años para que los arqueólogos aceptaran por completo que la joven ciencia de la física nuclear podía ayudarles en su campo de investigación. Realmente, su aceptación final de la datación con carbono-14 conllevó un replanteamiento completo de la prehistoria europea, ya que muchos de los monumentos megalíticos (tales como Stonehenge) pasaron a asociarse con restos de madera y animales un millar de años más antiguos que las fechas que los arqueólogos les habían adscrito a partir de la escasa evidencia que tenían antes. Los arqueólogos aceptan ahora que los constructores de estos monumentos pertenecían a una civilización anterior, altamente avanzada, del noroeste de Europa, en vez de, como pensaban originalmente, a una cultura posterior que habría copiado burdamente los magníficos templos de las civilizaciones del Mediterráneo oriental.
§. Los inestables núcleos gigantes
Cuando tratamos con núcleos mayores, encontramos que a medida que se incrementa su tamaño se hace regularmente mayor el número de neutrones que el de protones. Por ejemplo, el isótopo más común del oxígeno tiene 8 protones y 8 neutrones; pero el hierro tiene 26 protones y 30 neutrones; y el isótopo más común del plomo contiene 82 protones y 126 neutrones. El desequilibrio se origina en la batalla que mantienen las fuerzas fuerte y electromagnética con las que nos hemos encontrado anteriormente al hablar del núcleo de helio.
La fuerza electromagnética tiene largo alcance, por lo que cada protón está sometido a una repulsión eléctrica por parte de cada protón del mismo núcleo; sin embargo, la fuerza nuclear fuerte, que mantiene unidos los núcleos, tiene alcance sumamente corto, y un protón experimenta una fuerza atractiva únicamente por parte de los protones y neutrones más próximos. Esto no tiene importancia en núcleos más pequeños, ya que todas las partículas están muy próximas, pero los núcleos mayores deben contener una mayor proporción de neutrones, eléctricamente neutros, que proporcionen una fuerza de enlace mayor sin la adición de cargas positivas.
Para núcleos mayores que el plomo, incluso la ayuda de los neutrones extra no es permanente, y, más pronto o más tarde, estos núcleos superpesados se rompen en un proceso de desintegración radiactiva. Esta radiactividad es mucho más espectacular que la de núcleos pequeños del tipo del carbono-14, ya que la fuerte repulsión entre los protones rompe el núcleo en pedazos consistentes, cada uno de ellos, en un núcleo de helio: dos protones y dos neutrones.
Un núcleo desproporcionadamente superpesado, como el uranio-238, perderá ocho núcleos de helio sucesivamente antes de alcanzar un estado estable transformándose en plomo. Una de las primeras aplicaciones de este flujo continuo de partículas de alta velocidad procedentes de núcleos [tesados consistió en suministrar energía a las esferas y a los símbolos luminosos de los relojes. Cuando un núcleo de helio colisiona con una sustancia fluorescente mezclada con el elemento radiactivo, emite luz; y si se lo observa con gran aumento, permite percibir los minúsculos destellos debidos a los núcleos de helio individuales.
Sin embargo, durante los cuarenta años siguientes al descubrimiento de los elementos radiactivos, éstos fueron considerados como una novedad de gran interés científico pero de escasa importancia práctica. Evidentemente, había una gran cantidad de energía encerrada en los núcleos gigantes, pero los isótopos naturales se desintegraban tan lentamente que la «energía atómica» —o, más estrictamente, la «energía nuclear» parecía un sueño imposible. Sin embargo, en 1938 la situación cambió drásticamente. Los científicos alemanes Otto Hahn y Fritz Strassmann descubrieron que si un núcleo superspesado como el uranio era golpeado suavemente por un neutrón que se moviera lentamente, se podía dividir en dos trozos de aproximadamente el mismo tamaño (núcleos de bario y kriptón). Los nuevos núcleos más pequeños se repelían con enorme fuerza debida, una vez más, a la repulsión eléctrica, y al salir disparados colisionaban con otros núcleos y transformaban esta energía en calor (vibración de átomos). Afortunadamente para los Aliados, el gobierno nazi no advirtió en un principio las implicaciones de la investigación que se llevaba a cabo en el Instituto del Káiser Guillermo, y la información llegó, a través de los medios de comunicación científicos, a los Estados Unidos.
Allí, el recién llegado físico italiano Enrico Fermi encajó la pieza crucial en el rompecabezas (Fermi fue quien descubrió y dio nombre al neutrino o «un pequeño neutro»). Como los núcleos más pesados contienen relativamente más neutrones, la división de un núcleo de uranio liberaría parte del exceso de neutrones. Estas partículas colisionarían a su vez con otros núcleos de uranio dividiéndolos y liberando más neutrones, cada uno con potencial suficiente como para romper otro núcleo. La «reacción en cadena» resultante produciría un suministro continuo de energía si se controlaban adecuadamente el número y la velocidad de los neutrones, o un cataclismo instantáneo si no se los controlaba.
Era exigencia fundamental que cada fisión de un núcleo de uranio produjera al menos un neutrón libre. Leo Szilárd (que había tenido que emigrar de la Alemania nazi) era uno de los físicos que buscaba la evidencia de la liberación del neutrón, utilizando para ello un aparato en el que los neutrones producían minúsculos destellos sobre una pantalla.

Un núcleo de helio es estable pese a la repulsión entre sus protones cargados positivamente (en rojo), ya que los neutrones (en gris) lo mantienen unido. Si se reúnen dos protones y dos neutrones se libera energía en forma de la fuerza fuerte que los une: para romper un núcleo de helio habría que suministrarle la misma cantidad de energía.
Según sus propias palabras: «Giramos el interruptor y vimos los destellos. Los contemplamos un momento, apagamos todo y nos fuimos a casa. Aquella noche no me cabía ninguna duda de que el mundo estaba abocado a la desgracia.»
El resto es historia. Enrico Fermi construyó el primer reactor nuclear en un campo abandonado de squash de la Universidad de Chicago: a las 3h 45 m de la tarde del 2 de diciembre de 1942 retiró las barras de control de absorción de neutrones y la reacción en cadena se mantuvo por sí misma: había comenzado la era nuclear. Una bomba nuclear requería material fisionable muy activo, por lo que los americanos comenzaron la extracción a gran escala del isótopo uranio-235, menos estable, a partir de la mezcla natural, y comenzaron a producir grandes cantidades de un elemento radiactivo artificial, el plutonio (que tiene dos protones más que el uranio). Los apremios de la guerra condujeron al despliegue de medio millón de personas en el proyecto, y en julio de 1945 se hizo explotar un prototipo de bomba cerca de Alamogordo, Nuevo México. Al cabo de un mes, la energía nuclear se descargó coléricamente cuando las bolas de fuego nuclear hicieron su aparición sobre las ciudades japonesas de Hiroshima y Nagasaki.
§. La agrupación adecuada: los estados de la materia
Hasta el momento han aparecido, en el escenario del Universo, los principales actores: los sencillos electrones, los furtivos neutrinos y las partículas complejas de los núcleos, todos ellos librando su lucha interna entre las fuerzas fuerte y electromagnética y ocultando sus constituyentes básicos, los misteriosos quarks. En los momentos más dramáticos ha efectuado una breve aparición entre bastidores una plétora de otras partículas: partículas extrañas, partículas encantadas y la siniestra cuadrilla de las antipartículas.
La prolija trama, a veces ordenada, a veces aparentemente caótica, sigue reglas estrictas: las relaciones entre los actores están gobernadas por cuatro fuerzas y no se deben transgredir las leyes de la Naturaleza. Cuando estudiamos el gran drama del Universo con más detalle, descubrimos que las cuatro fuerzas parecen ser expresiones de una sola interacción básica entre los personajes: el odio es amor si tenemos la suficiente percepción para comprenderlo así.
Para completar la analogía, cada uno de nosotros constituye una trama secundaria. En nuestros cuerpos se ha congregado una combinación especial de partículas- actores que representa un minúsculo rincón de la historia del Universo antes de dispersarse y reagruparse en la acción de otra trama. Pueden haber transcurrido siete edades de la vida humana, pero la Naturaleza tiene un número inconmensurable de ellas.
Nuestro específico rincón del Universo es bastante insólito, porque está extremadamente bien ordenado. Los electrones giran en órbitas alrededor de los núcleos para constituir los átomos, y los átomos se agrupan de forma ordenada para originar las moléculas. La disposición regular de los átomos de sodio y cloro que forma los perfectos cristales cúbicos de la sal ordinaria parece casi un milagro: cada cristal consta de 100 trillones de átomos, y cada uno encaja exactamente en su lugar. También las rocas contienen cristales, a menudo brillantemente coloreados; e incluso hay virus —como el germen infeccioso de la gripe que tienen una bella forma cristalina a escala microscópica.
El impresionante orden que nos rodea proviene del hecho de que las órbitas de los electrones están estrictamente controladas. Al contrario de lo que sucede con un satélite que circunda la Tierra, al que podemos situar en la órbita que deseemos, la teoría cuántica muestra que, a la diminuta escala atómica, los electrones sólo [Hieden girar alrededor del núcleo con «unidades de spin» enteras, por lo que sólo les están permitidas determinadas órbitas. Cuando las órbitas permitidas de cada elemento se cubren con el número correcto de electrones, se obtienen las diferentes disposiciones electrónicas entre ellos, y, así, las propiedades químicas, que dependen de los electrones más externos, varían de elemento a elemento.
Consideremos nuevamente la sal común. Los químicos nos dicen que un átomo de sodio tiene un electrón externo poco ligado, del cual toma posesión ávidamente el átomo de cloro para completar el conjunto de electrones que se hallan en su órbita. Acabada esta transferencia, que tiene lugar en forma de fogonazo explosivo si se ha vertido el metal sodio en el gas cloro, el sodio ha perdido una carga negativa y es ahora eléctricamente positivo, mientras que el átomo de cloro es ahora negativo. Los átomos así cargados se llaman iones; los dos se adhieren, ya que las cargas opuestas se atraen y, finalmente, se unen como una gran red cristalina.

La ciudad de Nagasaki dos meses después del bombardeo, los edificios que aún se mantienen en pie, en primer plano y en el fondo, señalan los límites del área de destrucción total: la región plana entre ellos era el centro de la ciudad.
Los átomos también pueden unirse compartiendo electrones. En el gas cloro, los átomos tienden a tal punto a completar sus conjuntos de electrones que se asocian a pares, haciendo oscilar a sus electrones externos, de forma que cada uno de ellos dé la impresión de un conjunto completo. Lo mismo hacen otros átomos de gas: el oxígeno y el nitrógeno del aire no son átomos individuales, sino un par de moléculas (O2 y N2). También en los sólidos se comparten los electrones, y el carbono es el ejemplo más notable de ello. La materia viva está constituida por largas cadenas y lazos de átomos de carbono, con oxígeno, nitrógeno e hidrógeno ocasionalmente, todos ellos ligados por electrones compartidos. A partir de las acciones mutuas de la fuerza electromagnética entre los electrones compartidos, los electrones ligados a los átomos y la atracción positiva de los núcleos atómicos, las moléculas adquieren una forma definitiva. Desde estos orígenes se llega a la belleza y complejidad de los organismos vivos.
La materia que conocemos se clasifica tradicional mente en tres estados. En los sólidos, las fuerzas entre moléculas (o entre átomos cargados, en el caso de los cristales) son tan fuertes que suelen mantener sus formas, mientras que, en los líquidos, las moléculas se atraen unas a otras suficientemente como para mantenerse unidas, pero pueden deslizarse. En los gases, las moléculas son completamente independientes unas de otras y circulan sin impedimento.
Sabemos que los estados de la materia cambian con el calor. Para considerar el caso más familiar, calentemos hielo sólido y se fundirá en agua líquida, calentemos a su vez el agua y se evaporará en forma de gas. Cada vez que aportamos energía calorífica, las moléculas se empujan entre sí más violentamente, ya que vibran con mayor energía. Primeramente, el orden de un sólido se pierde al fundirse; y después, al evaporarse, las moléculas se mueven con suficiente rapidez como para perder contacto con sus vecinas y escapar como moléculas de gas libre.
Así pues, toda la materia de la fierra es un conjunto ordenado de átomos en moléculas, bien se trate de moléculas ligadas o que se mueven libremente en un gas. Sin embargo, la Tierra es sólo una minúscula parte del Universo y constituye una especie de refugio, ya que la mayor parte de la materia del Universo se halla en regiones infernalmente calientes en las que el rango de temperaturas varía desde miles de grados hasta cientos de millones.

Los tres estados de la materia: el hielo y el agua son los estados sólido y' líquido de la misma sustancia. El aire es un gas compuesto de diversas moléculas, nitrógeno y oxigeno. El cuarto estado de la materia, el plasma, no existe en forma natural sobre la Tierra.
Bajo estas rigurosas condiciones, el movimiento de los átomos y de las moléculas da lugar a una serie de colisiones enormes; las moléculas se fraccionan en átomos, pero ni siquiera éstos pueden sobrevivir como tales, ya que las colisiones los despojan de sus electrones dejando que los núcleos desnudos y los electrones libres prosigan caminos independientes.
Este tipo de materia —núcleos y electrones moviéndose libremente - se denomina plasma y es el estado en que se encuentra la mayor parte de la materia del Universo; a veces se le llama «el cuarto estado de la materia». Los científicos pueden producir pequeñas cantidades de plasma en el laboratorio, pero el plasma a alta temperatura es una sustancia difícil de tratar; sólo se la puede concentrar por medio de un campo magnético y, apenas se concentra, el campo se hace inestable y arroja la sustancia, intensamente caliente, al interior del aparato.
En el Universo exterior, la materia puede adquirir formas aún más extrañas si se dan las condiciones adecuadas. Si se comprime suficientemente el plasma que constituye una estrella, puede lograrse un estado en el que la presión se mantenga por agrupación de electrones; si se lo comprime aún más, los electrones se combinan con los protones para dar lugar a una estrella de neutrones aún más diminuta. Imaginemos, en el primer caso, una estrella como el Sol comprimida al tamaño de la Tierra, y, en el segundo, al tamaño de Malta o Brooklyn. Estas son las ideas que tienen in mente los astrónomos y los físicos modernos; más adelante veremos que existen estas singularidades, ya que se trata de restos de una estrella muerta.
Los cuatro planetas más próximos al Sol, incluida la Tierra, tienen muchas cosas en común, pero los demás son realmente lugares muy extraños. Desde los fósiles salpicados de cicatrices hasta los gigantes gaseosos, la 'Tierra es el único paraíso que conocemos.

Saturno, con su vasto conjunto de anillos, es el planeta más bello del sistema Solar. Los anillos están compuestos por millones de rocas y fragmentos de hielo, que se hallan en órbita en torno al planeta como satélites independientes.
§. La datación de las rocas
§. Una plétora de relojes
§. Otros sistemas solares
§. Los comienzos
§. Las inmensidades heladas del sistema solar
§. Las lunas de las bolas de nieve
§. Anillos brillantes y deslustrados
§. Los cometas: mensajeros de allende los planetas
§. Un planeta frustrado: los asteroides
§. La Luna y Mercurio: fósiles con cicatrices
§. Marte: ¿un lugar con vida?
§. Venus: el planeta infernal
§. El planeta Tierra
«Este es un pequeño paso para un hombre, pero un salto gigantesco para la humanidad.» El 21 de julio de 1969, Neil Armstrong se convertía en el primer ser humano que pisaba un mundo exterior al suyo: después de tres mil millones de años de permanencia sobre la Tierra, la vida, tal como la conocemos, había comenzado a desplegar sus alas interplanetarias. ¿Conducirá este notable logro a la colonización humana de sistemas planetarios de otras estrellas, o bien a vinculaciones con otras civilizaciones celestes? Por el momento, esto es sólo una especulación apasionante. Sin embargo, los vuelos tripulados Apolo a la Luna han aportado una enorme cantidad de información científica que ayuda actualmente a los astrónomos a atar los cabos de la historia anterior del sistema solar.
Nuestro sistema planetario consta de nueve planetas mayores e inmensas cantidades de peñascos más pequeños, rocas, granos y polvo, los «desechos» del sistema solar, todos en órbita alrededor del Sol, nuestra estrella local. Antes de examinar cada planeta en detalle, seguiremos la historia del sistema solar. Comenzando con su formación a partir de una gigantesca nube de polvo y gas, podemos rastrear las historias de los planetas y descubrir la razón por la cual en la actualidad son tan diferentes unos de otros: Júpiter, el gigante gaseoso y líquido; el abrasado y estéril Mercurio; el caliente y venenoso Venus; o, el más próximo al Paraíso, el planeta Tierra.
La familiar Tierra, la cuna de la humanidad, es, naturalmente, el planeta mejor estudiado; podría parecer el lugar idóneo desde donde comenzar a investigar las pistas del origen de los planetas. Sin embargo, a pesar de la dedicación de los geólogos y de otros «científicos terrestres», nuestro planeta guarda celosamente su misterioso pasado. Las rocas aparentemente permanentes que nos rodean son, todas, bastante recientes en comparación con la gran antigüedad de la Tierra, y muchas de ellas apenas si tienen la décima parte de su edad. La superficie de la Tierra cambia constantemente. El ritmo es demasiado lento como para que nos demos cuenta de ello en el corto espacio de una vida humana, pero para el geólogo que maneja etapas de mil millones de años es drásticamente rápido. Los continentes terrestres y los suelos oceánicos se desplazan y empujan hacia arriba a las cadenas montañosas corrías que chocan; las calientes rocas del interior son expulsadas por los volcanes y abren «costurones» en los lechos de los océanos; las rocas del suelo oceánico son absorbidas al interior de la Tierra, a las profundidades del océano; el terreno se desgasta continuamente debido a la persistente erosión del agua, y la roca erosionada acabará devuelta al océano, donde permanecerá hasta que otra manifestación paroxismal la arranque para formar parte, en calidad de nuevo trozo, del suelo «sólido». Maravilla por consiguiente que los geólogos puedan decir algo acerca del nacimiento o la infancia de la Tierra.
Debemos buscar los indicios del comienzo de la Tierra y de los demás planetas en otra parte. No hay duda de que todos los planetas se formaron prácticamente al mismo tiempo, y podemos establecer comparaciones entre ellos. La Luna parece un buen punto de partida. Aparte de ser el único cuerpo alcanzado por expediciones tripuladas, es un soberbio museo fosilizado de las etapas anteriores de la vida de un planeta. Los «planetólogos» consideran a la Luna como un planeta, ya que no desentona en la sociedad de planetas rocosos próximos al Sol. Con un diámetro que es la cuarta parte del de la Tierra, es mucho mayor en relación con el planeta que la controla que cualquier otro satélite; un astrónomo imaginario situado en Marte vería la Tierra como un «planeta doble» algo desproporcionado.
La superficie de la Luna no sufre el constante desgaste ocasionado por la deriva de los continentes, y carece de agua o de aire que puedan erosionar las rocas de su superficie. Los científicos esperaban que las rocas que acarreasen los astronautas de la Apolo, aproximadamente un tercio de tonelada, fueran realmente muy viejas. Sin embargo, las rocas lunares son únicamente tan antiguas como las más viejas de la Tierra. Como era de esperar, la Luna apenas tiene rocas jóvenes, pero cuenta también con algunas extremadamente viejas. La razón estriba en que la superficie lunar sufrió un continuo bombardeo de rocas procedentes del espacio, durante cientos de millones de años desde su nacimiento, qué originaron los cráteres que vemos en la actualidad y que dieron lugar a su superficie original.
Sin embargo, los planetólogos están agradecidos al escombro rocoso esparcido por nuestro sistema planetario. La 'Tierra actúa como un gigantesco cubo de basura en el que se depositasen fragmentos de rocas a un ritmo de cien toneladas diarias. Los fragmentos pequeños, del tamaño de granos de arena, se inflaman al entrar en contacto con el aire y brillan brevemente como «estrellas fugaces» o meteoros, mientras que los trozos gruesos, que son menos frecuentes, pueden iluminar todo el cielo cual una bola incandescente; aunque gran parte se evapora a su ardiente paso por la atmósfera, una pequeña parte puede sobrevivir y chocar con la Tierra: es ésta la caída de un meteorito.
Existen unos extraños tipos de meteoritos que constituyen el «certificado de nacimiento» del sistema solar. Estas rocas desmenuzadas, que reciben el complicado nombre de condrilas carbonáceas, son las rocas más viejas que se conocen y permiten que los científicos sitúen el momento del acontecimiento hace 4.600 millones de años.
§. La datación de las rocas
A primera vista no resulta obvio afirmar cuál es la edad de una roca, ni, incluso, decidir lo que entendemos por su «edad». Una roca recogida en el jardín no muestra indicios claros, pero una roca sedimentaria como la caliza puede contener fósiles de criaturas o plantas que murieron y se asentaron en el cieno del lecho-del mar, comprimiéndose posteriormente en forma de roca. La identificación de fósiles es el método de datación «clásico» en geología, ya que en el pasado determinadas especies vivieron únicamente en épocas específicas. Sin embargo, donde no existen fósiles, como en las rocas volcánicas y en las muy antiguas, por no mencionar las muestras lunares y los meteoritos, la determinación de fechas requiere exámenes más sutiles.
La radiactividad proporciona la clave. Dado que los núcleos inestables de átomos, como el uranio, presentes en pequeñas cantidades en la roca, se desintegran continuamente en otros más estables, como el plomo, a un ritmo medido ya por los físicos nucleares, el principio de la datación radiactiva parece muy sencillo.

El astronauta James Irwin con el Rover lunar del Apolo 15. Este vehículo recorrió un total de 28 kilómetros sobre la Luna, y los astronautas recogieron 76 kilogramos de rocas de la superficie en la región de Hadley Rille.
Se miden los niveles actuales de uranio y plomo en la roca, y se calculan los años que deben haber transcurrido para que se haya desintegrado la proporción de uranio.
Sin embargo, en la práctica el principio no es tan sencillo. Existe el problema de determinar la cantidad de plomo que había en la roca originalmente, y que no se ha formado por la desintegración de uranio. Además, a lo largo de la historia de la roca, parte de los átomos de plomo pueden haber emigrado de sus lugares de origen. Afortunadamente, la Naturaleza nos ayuda a resolver estos problemas; existen dos isótopos distintos de uranio que se desintegran en isótopos diferentes de plomo. El uranio-238 pierde ocho núcleos de helio para transformarse en plomo-206, mientras que el uranio-235, de vida más corta, el material activo de la primera bomba «atómica», se desprende únicamente de siete núcleos, de helio para acabar como plomo-207. (Incidentalmente, la escasez de este segundo isótopo de uranio se debe a que su vida media es mucho más corta: durante la existencia de la Tierra, aproximadamente el 99% del uranio-235 original se ha transformado en plomo, mientras que sólo se ha desintegrado la mitad del uranio-238.) Ambos tipos de uranio habrán experimentado las mismas reacciones químicas, por lo que los planetólogos disponen de dos «relojes» diferentes para efectuar comparaciones: ambos «se ponen en hora» al mismo tiempo y funcionan a ritmos distintos, pero conocidos. Resulta bastante irónico que el problema principal con que se enfrentan en la actualidad los laboratorios de datación de las universidades sea el nivel de contaminación aéreo de plomo procedente de los escapes de los automóviles.
La edad del uranio-plomo de los meteoritos más antiguos es, aproximadamente, de 4.600 millones de años. Esta fecha nos informa de cuándo adquirió su forma actual el material del meteorito, ya que cualquier mezcla importante o fusión completa redistribuiría el uranio y el piorno y «reajustaría» los relojes. Por esta razón, las demás rocas del sistema solar resultan ser más jóvenes. La superficie de la Luna data de unos 3.200 a 4.200 millones de años, muy posterior a la formación de la Luna, de la época en que las rocas que caían conformaban sus cráteres y pulverizaban su superficie. Las rocas terrestres supervivientes más antiguas que conocemos se han encontrado en Groenlandia occidental, y se formaron hace 3.800 millones de años.
El primer capítulo de esta historia del sistema solar, los primeros cientos de millones de años no figura en los registros rocosos de los planetas, y sólo los sucios y frágiles meteoritos carbonáceos pueden suministrarnos indicios reales.
§. Una plétora de relojes
Los relojes de uranio-plomo no son los únicos indicadores radiactivos que usa el planetólogo: puede serlo cualquier átomo radiactivo con vida media de unos cientos de millones de años. En esta escala de tiempos, el torio se desintegra en plomo y el rubidio en estroncio, y estos relojes suministran una comprobación válida de las edades de las rocas.
Otro reloj radiactivo importante es un extraño isótopo del potasio, cuyo núcleo puede ser desintegrado por el insólito procedimiento consistente en capturar uno de los electrones que se hallan en su órbita, convirtiendo de esta forma uno de sus protones en un neutrón (de hecho, éste es precisamente el proceso opuesto a la desintegración de un neutrón «libre», pero favorecido, en términos de estados de energía, en este núcleo). El resultado es el argón-40. El argón es el tercer gas más abundante de los que componen la atmósfera terrestre después del nitrógeno y del oxígeno, y el 1 % del argón del aire que respiramos proviene de la desintegración de átomos de potasio-40 de la corteza terrestre durante los periodos geológicos, tiene una importante aplicación práctica por ser inerte, esto es, extremadamente reacio a tomar parte en reacciones químicas, por lo que se lo emplea para llenar los bulbos de las lámparas eléctricas.
En los últimos años, los planetólogos han logrado retroceder al periodo anterior a la formación del sistema solar gracias a una extensión del método del reloj radiactivo. Todos los núcleos pesados, incluyendo los radiactivos, se formaron en el interior de estrellas y fueron expulsados al espacio por fantásticas explosiones de supernovas. Los núcleos individuales que se desintegran radiactivamente son, por tanto, considerablemente más antiguos que el sistema solar. Esto es irrelevante para los métodos de datación radiactiva tradicionales, ya que comparan las cantidades relativas de núcleos radiactivos y de los «hijos» producidos desde que los átomos padres fueron atrapados por la roca. Sin embargo, las supernovas también arrojan al espacio núcleos inestables: isótopos con una vida media de aproximadamente un millón de años. Si el sistema solar se hubiera formado inmediatamente después de una explosión de supernova cercana, estos núcleos se hallarían incluidos en meteoritos primitivos, y sus productos de desintegración, los núcleos hijos, estarían aún encerrados, aun cuando se hubiesen desintegrado hace mucho los núcleos inestables originales.
Los primeros análisis sugirieron que habría transcurrido un lapso de unos cientos de millones de años entre la explosión de una supernova, la nube de gas del presistema solar y el nacimiento de nuestro sistema planetario. Sin embargo, en los últimos años, Gerald Wasserburg y Typhoon Lee, del Instituto de Tecnología de California, descubrieron una gran cantidad inesperada de magnesio- 26, el producto hijo del inestable aluminio-26, en un antiguo meteorito carbonáceo que cayó cerca de la ciudad mexicana de Allende, en 1969.

La nebulosa Trifid en la constelación Sagitario está parcialmente oscurecida por tres bandas de polvo, granos de polvo como éstos son el material original a partir del cual se formaron los planetas. (Copyright del Instituto de Tecnología de California y la Institución Carnegie de Washington. Reproducido con permiso de los Observatorios Hale.)
El aluminio-26 original debería provenir de una supernova que explotó sólo unos cuantos millones de años antes de que se formara el meteorito: esto supone una escala de tiempo suficientemente corta en términos astronómicos como para que se puedan relacionar la explosión de la supernova y el nacimiento del sistema solar.
§. Otros sistemas solares
Parece natural que retrocedamos y contemplemos la formación del sistema solar desde un punto de vista más cósmico. Ya que nuestro Sol es una estrella muy típica, podemos considerar que otras estrellas poseen también séquitos planetarios; si examinásemos las densas nubes de gas en las que se forman las estrellas, podríamos aprender algo acerca del proceso general por el que nacen los planetas. Cuando los científicos desarrollan la historia completa de cómo nacieron la Tierra y el resto de la familia del Sol, lo hacen relacionando la historia referida por los antiguos meteoritos y los descubrimientos efectuados por los astrónomos que investigan el nacimiento de otros sistemas planetarios mucho más distantes, en las profundidades de nuestra Galaxia.
Durante muchos años, los astrónomos pensaron que el nacimiento del sistema solar fue un suceso casual, originado quizás en la aproximación, una entre un millón, de otra estrella al Sol. En la actualidad, esta opinión se ha modificado y, según la teoría moderna, es rara la estrella formada sin planetas. ¿Podríamos responder directamente al interrogante observando si las estrellas más próximas tienen planetas que las acompañen? Desgraciadamente, esto está lejos del alcance de los actuales telescopios. Puesto que los planetas carecen de luz propia, los miembros de otros sistemas planetarios brillarían únicamente por la luz reflejada de la estrella central, y la luz de la estrella dominaría el tenue resplandor de los planetas.
Sin embargo, existe una forma indirecta de encarar este problema. Peter van de Kamp, del Observatorio de Sproul, Pennsylvania, ha dedicado su vida a estudiar el lento movimiento de las estrellas por el cielo, y acabó convenciendo a muchos astrónomos de que algunas estrellas próximas tienen sistemas planetarios. Una estrella cercana seguiría una trayectoria recta en su lento camino a través del cielo. Sin embargo, si la estrella está acompañada por un planeta, estrella y planeta se hallan en realidad en órbita alrededor de su «centro de gravedad», el punto de equilibrio del sistema. La estrella se mueve en una órbita mucho menor que el planeta, que es mucho más ligero, pero el profesor van de Kamp puede medir la lenta y minúscula oscilación de la estrella a uno y otro lado de su trayectoria recta media, señal inequívoca de que la estrella cuenta con un compañero de órbita inobservable. De la cuantía de la oscilación deduce la masa del planeta inobservable, y demuestra así que una proporción bastante considerable de estrellas cercanas tienen al menos un planeta, unas cuantas veces más pesado que Júpiter.
Peter van de Kamp ha descubierto que la segunda estrella más cercana al Sol (después del sistema triple Alpha Centauri) tiene dos planetas de aproximadamente la masa de Júpiter; puesto que se los podría considerar comparables a Júpiter y Saturno en nuestro propio sistema, se piensa que la estrella de Barnard tiene asimismo un grupo de planetas más pequeños. Esta estrella lleva el nombre de uno de los astrónomos modernos más agudos, E. E. Barnard, y posee el récord de velocidad en el cielo (relativa a la Tierra), ya que emplea sólo 180 años en recorrer el diámetro aparente de la Luna.
Parece, por tanto, que los sistemas planetarios son corrientes, lo que concuerda suficientemente con las modernas teorías de formación de estrellas. Estas predicen la existencia de gran cantidad de granos de «polvo» sólido junto con nubes de gas en órbita alrededor de una estrella en formación. En fecha tan reciente como 1977, astrónomos que estudian la radiación infrarroja (calor) de una nebulosa con estrellas en formación en la constelación del Cisne, han encontrado la evidencia de que un disco de este tipo, de polvo y gas, rodea a una reciente estrella en formación. Los planetas se formarían, por tanto, a partir de este nuevo material en órbita.
Para completar esta rápida revisión de la prehistoria del sistema solar, anticiparemos algo de la historia de la formación de las estrellas, que continuaremos con más detalle en el capítulo 8. En nuestra Galaxia, las grandes nubes de gas son bastante estables, ya que la presión de los átomos de gas que zumban en su interior es suficiente para impedir que la atracción gravitatoria entre los mismos comprima la nube cada vez más. Una nube de este tipo sólo comenzará a colapsarse y formar estrellas si se comprime repentinamente, y una de las formas más eficientes de que esto suceda es que choque con los gases de alta velocidad expulsados por la explosión de una supernova.
Por consiguiente, los extremos se tocan. Aproximadamente hacia la tercera parte de la vida de la Galaxia, o sea hace 4.600 millones de años, una gran nube de gas interestelar se comprimió y comenzó a colapsarse bajo la fuerza de su propia gravitación. Así como los astrónomos observan que otras nubes de gas se colapsan en la actualidad, este material reciente se dividió en varios cientos de estrellas, cada una de ellas rodeada por un disco en rotación de partículas de polvo y átomos de gas. Una de estas estrellas era el Sol, y de su disco se formaron la Tierra y el resto de los planetas. La compresión inicial bien pudo haberse debido a la onda de choque de la explosión de una estrella cercana; tanto la teoría de formación de estrellas como los recientes e interesantes resultados sobre el aluminio-26 de los meteoritos sugieren que el nacimiento de nuestro sistema solar fue el legado de una cercana estrella suicida que se autodestruyó en una colosal explosión de supernova.
§. Los comienzos
A esta altura de la saga, los acontecimientos no están aún completamente claros. Los astrónomos concuerdan en cuanto a que, en sus comienzos, el Sol debía estar rodeado por un disco en rotación de partículas de polvo y gas, y que los planetas se formaron de alguna manera a partir de la materia del disco, pero siguen en discusión los detalles exactos.
La historia bien podría haber ocurrido como en la versión sostenida por A. G. W. Cameron, de la Universidad de Harvard, los minúsculos granos de polvo del disco en rotación serían las mismas partículas de polvo que se encuentran en el espacio interestelar y que bloquean la luz de las estrellas distantes, pero los granos de polvo y los átomos de gas no son los únicos ocupantes del espacio interestelar. Los radioastrónomos han descubierto que las densas nubes de gas y polvo en que se forman las estrellas son ricas en diferentes tipos de moléculas mezcladas con los átomos de gas. Estas moléculas se pueden identificar rápidamente porque cada tipo «radia», emite radiación, en una particular longitud de onda de radio que el astrónomo puede sintonizar, tal como si se tratara de distintas emisoras cósmicas.
Probablemente las moléculas recubren cada minúsculo grano de polvo con una fina película pegajosa, aunque en realidad es probable que los átomos de gas reaccionen para formar las moléculas sobre las superficies de los granos. Al hallarse muy próximos en el disco del presistema solar, colisionaron y se agruparon para constituirse en paquetes de polvo poco compacto de hasta un centímetro de longitud, tan livianos y' esponjosos como el escardillo del cardo. En esa época se formaba asimismo el propio Sol a partir del gas del centro del disco, y aún no había comenzado a brillar; el sistema solar era una nube de gas muy oscuro, repleto de incontables millones de sucias bolas de polvo que giraban en torno a su centro.
Considerado desde el fundamental punto de vista de partículas y fuerzas, la historia del sistema solar es un proceso bastante simple. En los granos de polvo originales y en sus pegajosos recubrimientos comenzaban a agruparse los átomos en moléculas y en cristales mayores; y la acumulación de polvo en planetas es equivalente al apilamiento de más y más átomos.
Hemos considerado anteriormente que la gravitación es la fuerza básica que mantuvo unida la nube de gas original. Los remolinos aleatorios de la gigantesca nebulosa original se resolvieron en cientos de estrellas nuevas al desgajarse cada uno de sus fragmentos colapsantes más pequeños que giraban levemente, y entre los que se incluían el que dio origen a nuestro Sol y a nuestro sistema solar. Cuando la gravitación la redujo a un volumen cada vez más pequeño, la velocidad de rotación se incrementó a fin de conservar constante el valor del «giro» (momento angular) total del sistema, y por esta razón no pudo contraerse en el centro para pasar a formar parte del Sol en formación, sino que quedó girando como un disco en torno a él.

Interpretación artística de la formación del sistema solar. La materia de la nebulosa original se agrupa en un disco en rotación: los planetesimales mayores recogieron a los más pequeños hasta alcanzar el tamaño de planeta. Finalmente, el sistema solar actual quedó constituido por pequeños planetas rocosos interiores y por grandes planetas liquido-gaseosos exteriores, con un espacio virtualmente vacío entre ellos.
Cuando los granos de polvo colisionaron y se unieron, la gravitación cedió su puesto, ya que dicha unión constituye una interacción entre las nubes electrónicas de los átomos puestas violentamente en contacto, tal como se adhieren a una hoja de papel los átomos de la superficie de una cinta adhesiva; es [x>r tanto la fuerza electromagnética la que adopta una de sus múltiples formas y juega un papel vital en la formación de los planetas.
Sin embargo, una vez que ha alcanzado el estadio del sucio escardillo del cardo, la gravedad asume nuevamente el papel de arquitecto. Un disco de partículas de este tamaño en rotación no puede sobrevivir largo tiempo: los cálculos muestran que la atracción gravitatoria entre las bolas de polvo, aunque pequeña, las haría agruparse en trozos de aproximadamente un kilómetro de tamaño.
Estos trozos rocosos pueden a su vez agruparse para dar lugar a cuerpos cada vez mayores, pero entonces tienen ya suficiente tamaño como para que también las colisiones sean destructivas. En vez de mantenerse juntos bajo las acciones mutuas de sus atracciones gravitatorias, dos «planetesimales», como se denominan, pueden hacerse pedazos uno al otro. La construcción de los planetas a partir de planetesimales fue una carrera demoledora en torno al Sol en formación, al colisionar torbellinos de trozos rocosos destrozándose o amalgamándose en el proceso. Los planetesimales mayores tenían menos posibilidad de romperse, y eventualmente preponderaron al capturar a la mayor parte del resto de los planetesimales para acabar constituyendo planetas rocosos. Así se formaron los planetas más interiores, ordenándose por tamaños desde la Luna a la Tierra. Este conjuntó interior se completó con los de tamaño intermedio, Mercurio y Venus, más próximos al Sol; y Marte, que circula por el exterior de la órbita terrestre.
Como vimos antes, la Tierra y la Luna constituyen realmente un planeta doble, y los astrónomos dudan todavía en cuanto a la explicación de la formación de este sistema doble, único en el sistema solar. Antes se pensaba que la lama podía haber [orinado parte de la Tierra, pero la composición de las rocas que se trajeron de la Luna es significativamente diferente de las de la superficie de la Tierra. Ahora se cree (pie la Luna debió haber comenzado como un auténtico planeta, amaine nadie sabe si nació junto a la Tierra o si se trasladó desde otro lugar del sistema solar interior, siendo «capturada» por ella.
Los planetas del sistema solar exterior son muy diferentes: están constituidos casi en su totalidad por sustancias que conocemos como gases, pero comprimidos al estado líquido. Esto nos retrotrae muy a los comienzos del sistema solar, porque las pegajosas partículas de polvo que constituían el disco del presistema solar estaban rodeadas de vastas cantidades de gas; realmente bien podía haber habido tanto gas en el disco como el que había en el centro condensándose para formar el Sol. Sin embargo, no todo el gas del disco estaba a la misma temperatura. Cerca del centro, donde se formaba el Sol, las temperaturas se elevaron hasta 1.500° C. c incluso a la distancia de la Tierra eran de unos 300 °C, mucho más altas que la de un horno «muy caliente». En estas tórridas condiciones, sólo podrían permanecer condensados sobre las superficies granulosas los sólidos con alto punto de vaporización, y los recubrimientos helados que originariamente tuvieran se habrían evaporado. Por eso los planetas interiores son de composición «rocosa».
Sin embargo, a la distancia de Júpiter, y más allá, los granos retuvieron sus recubrimientos de hielo y de amoniaco congelado, y las bolas de «escardillo» que se formaron se parecerían más a sucios copos de nieve y, en consecuencia, los planetesimales exteriores también habrían estado helados como enormes bolas de nieve purulentas de varios kilómetros de diámetro. Más exteriormente, donde la temperatura era baja, los átomos de gas de la nebulosa se movían más lentamente, y los planetas exteriores fueron capaces de capturar este hidrógeno y este helio para añadirlo a su mole. El gigantesco Júpiter llevó esto a tales extremos que se convirtió en aproximadamente trescientas veces más pesado que la Tierra, estando constituida prácticamente la totalidad de su masa por hidrógeno.
Los otros gigantes gaseosos, Saturno, Urano y Neptuno, no tuvieron tanto éxito como Júpiter en la recolección del gas que les rodeaba y acabaron como mundos más pequeños, aun cuando cualquiera de ellos empequeñezca a la Tierra. (Como veremos más adelante, el más remoto de los planetas, Plutón, constituye una excepción: un enano en la familia de los gigantes gaseosos).

Una fotografía próxima de Júpiter tomada por el Pioneer 10 muestra los finos detalles de las blancas nubes de amoníaco cristalizado, situadas en amplias «zonas» por encima de la atmósfera ligeramente coloreada. La Gran Mancha Roja es probablemente un huracán mayor que la Tierra, que ha estado soplando al meaos durante 300 anos. La mancha negra es la sombra de uno de los cuatro mayores satélites de Júpiter.
§. Las inmensidades heladas del sistema solar
Equipados con algunos conocimientos sobre la historia de la familia, encarémonos ahora con los planetas individuales de los hermanos del sistema solar, y comencemos con la mente libre de los prejuicios de nuestro natural «chauvinismo terrestre». Para un visitante ajeno a nuestro sistema planetario, Júpiter sería, con diferencia, el planeta dominante, ya que pesa más del doble que el resto de los planetas juntos. (De hecho, Júpiter podría dar motivo a la visita del ser interplanetario. A la distancia de la estrella de Barnard, por ejemplo, un astrónomo con instrumentos semejantes a los nuestros sería capaz de detectar las doce oscilaciones anuales en la posición del Sol cuando Júpiter describe su órbita. Y sospecharía que si el Sol tiene un gran planeta, puede contar asimismo con otros más pequeños, demasiado pequeños para causar una oscilación mensurable del Sol, pero de tamaño suficiente para implicar vida.)
Júpiter es tan masivo que algunos astrónomos le llaman «estrella frustrada». En su colapso inicial a partir de planetesimales y gas, el centro de Júpiter se calentó como consecuencia de la presión, al modo del aire en una bomba de bicicleta, pero no lo suficiente para que se desencadenaran las reacciones de fusión nuclear que mantienen brillando a una estrella como el Sol. En vez de los millones de grados necesarios, la temperatura en el centro de Júpiter es «sólo» de 30.000° C.
A pesar de su elevada temperatura central, las capas exteriores de Júpiter están bajo las gélidas condiciones que eran de esperar por hallarse alejado del Sol. La atmósfera tiene nubes de amoniaco congelado a -140 ℃ y aún serían más frías si no se calentaran por el calor que escapa desde el interior, de donde procede tanto calor como el que recibe del Sol, v algunos astrónomos piensan que la elevada temperatura central se mantiene por una contracción gradual del planeta. Desgraciadamente, resulta difícil verificar esta idea, ya que la contracción correspondiente es de sólo ¡un milímetro al año!
El interior de Júpiter es un extraño lugar. Además de su elevada temperatura, el enorme peso de las capas superpuestas comprime el centro a presiones enormes, cien millones de veces la presión de la atmósfera terrestre. Como la mole de Júpiter, aparte posiblemente de un pequeño corazón rocoso, está constituida de hidrógeno capturado en forma de gas de la nebulosa original, dicha presión lo aplasta hasta darle una forma muy poco familiar, el metal hidrógeno líquido. El hidrógeno líquido ordinario que puede obtenerse a bajas temperaturas y altas presiones en un laboratorio es sólo un compacto paquete de moléculas de hidrógeno; pero en las extremas condiciones del centro de Júpiter, tales moléculas se disocian en átomos de hidrógeno. En un conjunto tan denso de átomos pueden liberarse algunos electrones individuales que conduzcan corrientes eléctricas al igual que un metal. La continua agitación del núcleo de Júpiter produce grandes corrientes, y éstas generan un campo magnético de la misma forma que un electroimán ordinario. Las sondas espaciales Pioneer 10 y 11 midieron este campo, unas diez veces más intenso que el terrestre, cuando sobrevolaron el planeta en 1973 y 1974.
La acción más espectacular de los Pioneers consistió en enviar fotografías en color extremadamente detalladas de Júpiter en las que se muestra la parte superior de su atmósfera, ya que Júpiter no tiene superficie real. Bajo una espesa atmósfera de un millar de kilómetros, repleta de nubes de todos los tipos, hay un espesamiento gradual de capas de nubes que se sumergen en un profundo «mar» de hidrógeno molecular líquido. Más abajo aún, la presión es suficientemente alta como para que se forme el hidrógeno líquido metálico. Aparte de un posible núcleo rocoso no mayor que la Tierra, Júpiter es un planeta líquido cuyo borde externo se sumerge en su capa atmosférica relativamente delgada.
Las sondas espaciales Voyager, en la actualidad camino de Saturno, Urano y Neptuno, revelarán los secretos de estos mundos más distantes. Su estructura interna debe ser bastante parecida a la de Júpiter, si bien no tan caliente ni comprimida en el centro. Sin embargo, cada: uno de estos planetas tiene sus características peculiares. Saturno está constituido fundamentalmente por hidrógeno, pero no sometido a la intensa compresión interna de Júpiter, y su densidad es más baja que la de cualquier planeta. Al ser menos denso que el agua, Saturno flotaría si se pudiera encontrar un océano suficientemente grande como para dejarle caer en él. Urano gira alrededor de un eje perpendicular a su órbita, rodando alrededor del Sol, por lo que desde la Tierra a veces contemplamos el ecuador y a veces los polos; y Neptuno, aunque más pequeño que Júpiter, también parecería generar algo de calor interno.
§. Las lunas de las bolas de nieve
No podemos terminar con los planetas gigantes sin mencionar sus fantásticos y maravillosos satélites. Como corresponde a su majestad, Júpiter tiene el mayor número de lunas: trece conocidas definitivamente y una decimocuarta cuya existencia se sospecha. Cuatro de los satélites son suficientemente grandes como para ser vistos con prismáticos, e incluso en buenas condiciones atmosféricas algunas personas pueden reconocerlos a simple vista. En realidad, estos cuatro satélites serían fácilmente visibles si no estuvieran abrumados por el deslumbrante brillo de Júpiter. Aun siendo minúsculos comparados con Júpiter, los cuatro satélites mayores no son enanos, pues todos son mayores que nuestra Luna, y dos de ellos más grandes que el planeta Mercurio.
Aun cuando los satélites de los planetas exteriores parezcan apenas puntos luminosos en los telescopios terrestres, tienen mucho más carácter e individualidad que el satélite rocoso de la Tierra. En las profundidades exteriores del sistema solar se acumulan, en los satélites, tanto partículas de polvo rocosas como de hielo, por lo que las temperaturas son suficientemente bajas como para que algunos puedan mantener una atmósfera. Para tratar de comprender esto, atendamos al pequeño planeta Mercurio, chamuscado por su proximidad al Sol. Mercurio ha perdido cualquier tipo de atmósfera que alguna vez hubiera podido tener, ya que, debido a su alta temperatura, los átomos de gas constituyentes de su atmósfera habrían sido muy energéticos y, por tanto, se habrían movido tan rápidamente que habrían sido despedidos al espacio pese a la atracción gravitatoria del planeta. Si suponemos a Mercurio en las extensiones exteriores del sistema solar, incluso su débil gravedad sería suficiente para mantener los átomos inactivos a estas temperaturas por debajo de cero, cubriendo al planeta con una atmósfera.
Io, el tercero de los satélites mayores de Júpiter, es uno de los miembros más extraños del sistema solar. Aproximadamente del tamaño de nuestra Luna, es el cuerpo más pequeño conocido que posee atmósfera, aunque mil millones de veces más tenue que la de la Tierra. Su superficie es de color marrón rojizo, virando al rojo oscuro en los polos, y está cubierto de cristales de sal común, depositados probablemente cuando se secaron sus antiguos océanos. Io se mueve en una órbita interior al campo magnético de Júpiter, y está sometido por tanto a una continua acometida de protones y electrones, partículas cargadas procedentes del Sol, capturados por dicho campo magnético. Los astrónomos teóricos habían predicho que estas partículas expulsarían átomos de sodio de la superficie cristalina de lo, dando lugar a una gigantesca nube de sodio en torno al satélite. Todos hemos visto alguna vez el resplandor amarillo de vapor de sodio de las farolas de la calle. Pues bien, Robert Brown, de la Universidad de Harvard, descubrió luz amarilla de sodio en las proximidades de lo. En 1974 se confirmó su hallazgo: lo está realmente rodeado por una lámpara de sodio a escala cósmica, una resplandeciente nube amarilla muy tenue que circunda al rojizo satélite.

La apariencia de los anillos de Saturno varía con la posición del planeta respecto a la Tierra. Aquí se ven bajo un ángulo pequeño, y resulta fácilmente visible el achatamiento del globo de Saturno debido a su rápida rotación. La zona ecuatorial blanca es inusitadamente prominente.
Visto desde la «salina» superficie ocre, el cielo nocturno aparecería de un amarillo resplandeciente, con Júpiter suspendido en el cielo cual un gigantesco óvalo listado.
Una escena de ciencia ficción quizás, alguna vez, presenciable por los hombres; pues si bien es imposible un aterrizaje tripulado sobre los planetas gigantes líquido-gaseosos exteriores, sus satélites son bases naturales en la exploración del hombre.
Un satélite que pretende ser más extraño aún es Titán, el miembro mayor de los diez de la familia de Saturno. Gigante entre los satélites, de tamaño intermedio entre los planetas Mercurio y Marte, Titán posee una atmósfera tan espesa como la de la Tierra, pero compuesta de hidrógeno y metano. Sobre esta letal atmósfera flotan nubes de color marrón rojizo, y sobre su helada superficie existen lagunas de amoniaco líquido. Esta imagen de Titán se basa en gran parte en la interpretación de observaciones efectuadas desde la Tierra, pero nuestro conocimiento de este mundo aumentará drásticamente cuando el Voyager 1 pueda contemplarlo de cerca al sobrevolar Saturno. Puede que también se resuelva el enigma de Iapetus, un pequeño satélite de Saturno brillante como la nieve por un lado, y negro como el carbón por el otro.
Pasando rápidamente por Urano, con cinco lunas bastante pequeñas, nos encontramos con que una de las dos de Neptuno es una gran luna, similar en tamaño a Titán; por similitud se la denomina Tritón, y bien podría ser el mayor satélite de todos, pero a causa de su distancia sus secretos se mantienen ocultos para nosotros, lis bastante extraño que t ritón se halle en órbita de Neptuno en sentido contrario al resto de los grandes satélites de otros planetas, v en esto puede residir la clave de otro misterio: el de Plutón, el diminuto planeta más externo.[1]
Aunque se encuentra en el dominio de los gigantes gaseosos, Plutón es un mundo diminuto, de tamaño inferior a la mitad de la Tierra. Recientes medidas indirectas sugieren que quizá sea sólo del tamaño de nuestra Luna, y su órbita en torno al Sol dista mucho de ser circular. Durante veinte años de los 248 que dura su viaje alrededor del Sol, Plutón se encuentra dentro de la órbita de Neptuno; por ejemplo, entre enero de 1979 y marzo de 1999 Neptuno será el planeta más externo del sistema solar.
Algunos astrónomos relacionan estos hechos y plantean la fascinante sugerencia de que Plutón pudo haber sido antes, simplemente, un satélite de Neptuno, y que tanto Plutón como Tritón se hallaban en órbita alrededor del planeta en sentido «correcto». Sin embargo, según esta teoría, los dos satélites se encontraban en órbitas que se perturbaban mutuamente a causa de sus atracciones gravitatorias, hasta que un catastrófico choque final lanzó a Tritón a circundar a Neptuno en sentido opuesto, mientras que Plutón, mucho más ligero, fue despedido al espacio para vivir una existencia separada como auténtico planeta.
§. Anillos brillantes y deslustrados
Aunque todos los planetas exteriores parecen globos similares, Saturno tiene una característica que lo sitúa aparte: un exquisito conjunto de anillos que rodean su ecuador. Visto en un pequeño telescopio, Saturno es el planeta más bello, y hay quienes afirman que la visión más mágica del cielo. Para un habitante de Saturno que viviera encima de las capas de nubes de su planeta, sus anillos serían como un glorioso y permanente arco iris desplegado sobre el cielo.
Pese a su apariencia en fotografías y a través del telescopio, los anillos no son una lámina sólida, sino que constan de incontables millones de diminutos fragmentos de hielo y roca, que van desde aproximadamente un centímetro de tamaño hasta un metro y que describen su propia órbita en torno al planeta. Brillantes copos y bolas de nieve de agua helada reflejan poderosamente la luz y hacen que los anillos brillen; los grandes trozos de roca oscuros sólo se ponen de manifiesto cuando los astrónomos reflejan ondas de radio en los anillos y las reciben como débiles ecos de radar. Aunque el diámetro total de los anillos mide 275.000 kilómetros, sólo tienen unos pocos kilómetros de espesor: una hoja de papel de igual proporción en espesor y anchura tendría que tener 5 metros de largo.
Visto al telescopio, Saturno es el único planeta con anillos. Sin embargo, en 1977, unos astrónomos que sobrevolaban el Océano Indico lograban, gracias a la combinación de azar y cuidadosa planificación, una revolución científica: descubrieron que Urano también posee anillos. La historia comenzó en 1973, cuando Gordon Taylor, del Real Observatorio de Greenwich, calculó que Urano pasaría por delante de una estrella débil el 10 de marzo de 1977. Los astrónomos mostraron su alegría por la posibilidad de observar este infrecuente suceso, pues la forma en que desaparece una estrella cuando un planeta pasa delante de ella puede suministrar mucha información acerca de la atmósfera del mismo. Sin embargo, apenas un mes antes de la fecha predicha, una serie de cuidadosas medidas mostraron que el suceso completo únicamente podría verse desde el Océano Indico meridional, donde no había observatorios astronómicos. La solución fue dada por la instalación del Observatorio Aéreo Kuiper, un globo de altura equipado con un telescopio estabilizado y bautizado con el nombre de uno de los más importantes planetólogos del siglo XX.
En la noche del 10 de marzo, el Observatorio Aéreo salía de Perth, en Australia, para realizar un viaje de 10 horas a 12.500 metros sobre el desolado océano. Todos los ojos estaban fijos en el telescopio donde se podía ver el diminuto disco de Urano muy próximo a la distante estrella. Las observaciones habían comenzado una hora antes con el fin de prevenir cualquier ligero error en la predicción, y esta cuidadosa planificación dio un fruto inesperado. Cuarenta minutos antes de la ocultación (estando ocultándose), la estrella «parpadeó» de pronto, brevemente, y unos cuantos minutos después otra vez, y después, otra más. Cinco veces en total cuerpos invisibles habían pasado delante de la estrella y habían interceptado su luz.
El experimento planificado para ver desaparecer la estrella detrás de Urano se llevó a cabo puntualmente, pero la expectación se centró en las inesperadas desapariciones. ¿Se repetirían al otro lado del planeta cuando la estrella reapareciera detrás de Urano? El observatorio sólo disponía de una hora, y era muy probable (que la estrella desapareciera de nuevo a idénticas distancias del disco planetario.
Los astrónomos debían vigilar la reaparición de la estrella desde detrás del planeta en Sudáfrica, por lo que enviaron un mensaje a través del mundo, vía Perth y Cambridge, Massachusetts, para advertir a los astrónomos africanos a fin de que se mantuvieran en observación y confirmaran los repentinos parpadeos. Cuando se recopilaron todos los resultados, la conclusión lúe ineludible: Urano está rodeado por cinco o seis anillos constituidos presumiblemente por pequeños fragmentos que se hallan en su órbita, lo mismo que en el caso de Saturno. Pero la semejanza acaba aquí; los anillos de Saturno son anchos, la región que rodea al ecuador de Saturno está repleta y sólo hay unos cuantos claros que separan los anillos.

El cometa West exhibía dos colas cuando pasó por el Sol en 1975. La cola azul está compuesta por gases incandescentes, y la blanco-rojiza, por partículas de polvo que simplemente reflejan la luz solar.
Sin embargo, los de Urano son estrechos, cada uno de sólo aproximadamente diez kilómetros de ancho (y probablemente de igual espesor). Como no pueden apreciarse al telescopio, ni con fotografías de muy larga exposición, deben estar constituidos por fragmentos mucho más oscuros que los de Saturno; debe haber muy pocos copos y bolas de nieve en los anillos de Urano. Si representáramos los anillos de Saturno con una hoja de papel circular de 5 metros de diámetro, los anillos de Urano a la misma escala serían círculos concéntricos de hebras de algodón negro, el mayor de ellos de dos metros de diámetro.
¿Están constituidos estos anillos por fragmentos rocosos y helados de restos de satélites desintegrados que se hallaban muy próximos a sus planetas padres? ¿O bien son materiales que se agruparon en satélites? ¿Por qué son tan diferentes los anillos de Saturno y Urano? ¿Tiene también Neptuno anillos débiles? La nave Voyager 2 puede ayudarnos a contestar estos interrogantes, pues si todo se desarrolla según lo previsto, pasará por estos tres planetas durante la década de 1980 y enviará una inestimable información.
§. Los cometas: mensajeros de allende los planetas
Más allá de las órbitas de los planetas conocidos se encuentra el helado dominio de los cometas. La idea que la mayoría de la gente tiene de un cometa es la de un grandioso espectáculo de luz que atraviesa el cielo con una larga cola que se despliega en dos. Ciertamente, algunos cometas adquieren esta notable apariencia, contemplada por nuestros antepasados como signo de perdición, cuando pasan por delante del Sol, pero esto no es más que una exhibición. El cometa propiamente dicho es una bola de hielo y polvo aproximadamente del tamaño de Malta o Brooklyn, y la mayor parte de su vida se mantiene invisible en las regiones más profundas del sistema solar en una órbita que, según lo que sabemos en la actualidad, lo más probable es que se encuentre a mitad de camino de la estrella (pie esté situada más cerca del cometa de que se trate.
El origen de los cometas es aún un rompecabezas. Su helada composición indica que el mismo debe hallarse en las zonas más externas del sistema solar. ¿Fueron quizás arrancados de su lugar de nacimiento, próximo a Júpiter, por la gravedad del gigantesco planeta? ¿O son restos de sistemas planetarios frustrados que comenzaron a formarse alguna vez cerca de la familia del Sol? O tal vez se han formado recientemente a partir de gas errante por el espacio y acabaron siendo capturados por el Sol cuando se desplaza a través de las nubes de gas interestelares. Independientemente de la forma en que comenzaran, debe haber en la actualidad millones de cometas describiendo enormes órbitas en los lugares más extremos del sistema solar.
A veces, un cometa se ve perturbado quizá por la gravedad de una estrella, y se aleja de su camino en dirección al Sol. Adquiriendo continuamente velocidad, cabecea al pasar por los planetas exteriores. Una vez dentro de la órbita de Júpiter, el Sol le calienta lo suficiente para que parte de sus hielos se evaporen, y estos gases originan una gigantesca cabeza resplandeciente, miles de veces mayor que la bola de hielo original. Al aproximarse más al Sol, el gas es arrastrado desde la cabeza por la continua corriente de protones y electrones que de él proceden, y forma una larga y resplandeciente cola. En tanto, las partículas de polvo desprendidas por los hielos evaporados son arrastradas por la presión de la luz solar y dan lugar a una segunda cola. (A pesar de su impresionante apariencia, estas colas son tan tenues como un buen vacío en la Tierra: en 1910 la Tierra pasó sin consecuencias a través de la cola del cometa Halley.)

Antes de que el Marinee 10 alcanzara Mercurio, en 1974, nada se sabía acerca de su superficie. Estas fotografías de la sonda espacial mostraron que el pequeño planeta sin aire tiene tantos cráteres como la Luna; en esta fotografía se lo podría confundir, a primera vista, con ella.
Después, el cometa ascendente remonta el Sol y retorna a las remotas profundidades. Como las colas deben estar siempre dirigidas al Sol, el cometa viaja con la cola por delante.
Dado que un cometa se mueve en una órbita muy larga, no debería volver a pasar por el Sol hasta dentro de miles de años, pero en ocasiones la órbita puede modificarse al aproximarse mucho a uno de los planetas gigantes debido a la gravedad propia de éstos.
Al girar en una órbita más pequeña, el cometa circundará al Sol en sólo unos cuantos años o docenas de años. Y a partir de ese momento su suerte estará echada, ya que en cada vuelta en torno al Sol, parte de su masa se consume por ebullición, comenzando a disminuir y a debilitarse gradualmente. Por último, puede desintegrarse en su totalidad, o bien su centro puede convertirse en una «escoria» destinada a girar indefinidamente en torno al sistema solar interior.
Sin embargo, el polvo de un cometa es el más duradero de los legados. Los pequeños granos sólidos atraídos por la Tierra y que se inflaman al atravesar la atmósfera dan lugar a meteoritos o «estrellas fugaces», y están constituidos por polvo procedente de cometas acabados. Durante su vida, un cometa desprende polvo a lo largo de su órbita: el tan célebre pero decepcionantemente débil cometa Kohoutek de 1973/1974 desprendió aproximadamente unas mil toneladas por segundo. Cuando la Tierra intercepta la órbita de un cometa atrae copiosas cantidades de polvo, y puede verse un enorme número de meteoritos. Estas lluvias de meteoritos se repiten en aproximadamente las mismas fechas de cada año; el comienzo de agosto, por ejemplo, es una buena época para la observación de meteoritos. Otras lluvias varían en intensidad de año en año. La más espectacular que se recuerda fue la del 17 de noviembre de 1966, cuando, durante varios minutos, observadores de los Estados Unidos fueron sorprendidos por un auténtico chaparrón de meteoritos que caían a un ritmo de cuarenta estrellas fugaces por segundo.

La superficie de la Luna muestra las cicatrices de los cráteres perforados por los planetesimales que cayeron sobre ella en las últimas etapas de su nacimiento. La suave llanura es lava solidificada que brotó a continuación. Esta fotografía fue tomada por el Orbiter lunar 3 en 1967.
Así pues, los cometas enlazan el conjunto del sistema solar: llegan desde las partes más alejadas conocidas y, eventualmente, mueren próximos al Sol esparciendo sus cenizas, que, atraídas por los planetas interiores de nuestro sistema, vuelven a esta región interna y cálida del espacio próxima al Sol.
§. Un planeta frustrado: los asteroides
Al recorrer la primitiva historia del sistema solar consideramos a los planetas interiores como planetesimales rocosos que habían colisionado y se habían fragmentado y aglomerado gradualmente en cinco planetas: Mercurio, Venus, la pareja Tierra-Luna y Marte. Más allá de la órbita de Marte existe una región, el cinturón de asteroides, repleta aún de fragmentos procedentes del nacimiento del sistema solar. Estos asteroides o planetas menores no han llegado a tener el tamaño de un planeta, y en realidad sólo existe en el cinturón de asteroides materia suficiente para constituir un cuerpo que implicaría la décima parte del diámetro de la Tierra. La mitad de esta masa está localizada en el mayor de los asteroides, Ceres, de 1.000 kilómetros, mientras que el resto de los asteroides tienen tamaños inferiores a los 500 kilómetros. Se estima que los telescopios modernos pueden localizar 50.000 asteroides y, de ellos, los dos mil más brillantes tienen órbitas que se conocen con precisión y nombres individuales. Los primeros se bautizaron con nombres de diosas de la mitología clásica: Ceres, Palas, Juno y Vesta, pero éstos se agotaron rápidamente y la lista de nombres de asteroides incluye en la actualidad los de países, esposas de astrónomos c, incluso, apellidos de astrónomos en femenino.
Existen unos cuantos asteroides fuera del cinturón principal, a los que se les ha asignado nombres masculinos; a los dos grupos que siguen la misma órbita que Júpiter alrededor del Sol se les denomina como a los héroes de las guerras troyanas: griegos a los que anteceden a Júpiter, y tróvanos a los que le siguen (excepto Héctor, que, en cierto modo, se encontraba en el campo griego. Más allá, circulando en torno al Sol entre las órbitas de Saturno y Urano, se halla el asteroide Chirón, descubierto en fecha tan reciente como 1977, Aunque es demasiado pequeño como para llamarle planeta, su naturaleza exacta es un enigma: podría ser simplemente un asteroide extraviado, o bien el más brillante de un nuevo cinturón de asteroides del sistema solar exterior, o, incluso, el núcleo muerto de un cometa acabado.
Ciertamente, muchos de los aproximadamente veinte «asteroides» cuyas órbitas se hallan dentro de la terrestre se cree que son cometas muertos. Entre ellos se cuenta el diminuto Toro, trasladado por la gravedad terrestre a una órbita en la que gira en torno al Sol exactamente cinco veces por cada ocho órbitas de la Tierra. A causa de esta referencia a la gravedad terrestre, la prensa sensacionalista informó que los astrónomos habían encontrado la «segunda Luna» de la Tierra, una interpretación completamente errónea del descubrimiento ya que Toro gira en torno al Sol, y no en torno a la Tierra.)
Y a propósito de lunas, dos diminutos satélites de Marte son probablemente asteroides capturados. Así, en recientes fotografías, logradas gracias al éxito de las sondas espaciales Viking, se nos muestran en forma de patata y con cráteres, lo que les da la apariencia de asteroides típicos.
Los ordenadores han prestado una ayuda inestimable a los astrónomos en los últimos veinte años, sobre todo en el monótono trabajo del cálculo de órbitas de asteroides a partir de las observaciones de sus posiciones en el cielo. Semanas de cálculo se han reducido así a una fracción de segundo, y sólo de esta forma los astrónomos pueden seguir el rastro de los dos mil asteroides registrados. Él análisis de ordenador muestra asimismo que los asteroides se presentan en «familias» con órbitas básicamente similares. Al parecer, las purulentas bolas originales de la región comprendida entre Marte y Júpiter se acumularon para constituir a humos de los cincuenta asteroides mayores o planetesimales, como les llamamos antes, pero ninguno de ellos llegó a ser suficientemente grande como para atraer a los demás, como en el caso de un planeta. En lugar de esto, las colisiones los desintegraron en las miríadas de fragmentos que hoy contemplamos.
Sin embargo, en el ínterin se desarrollaron importantes cambios. En el centro de los planetesimales se encontraba atrapado el calor procedente de la desintegración de núcleos radiactivos, que fundió el material rocoso original. El hierro líquido, más pesado, se sumergió en el centro, mientras que las rocas más ligeras ascendieron hacia la superficie, por lo que cuando, luego, los asteroides se fragmentaron, los fragmentos eran muy diferentes. Algunos son exclusivamente metálicos, una mezcla de hierro- níquel procedente del núcleo de un planetesimal; otros son mezclas de metal-roca o trozos de roca procedentes de una parte más externa; pero los más comunes son los fragmentos de la zona más próxima a la superficie del planetesimal, aún en estado inalterado. Los estudios de la luz solar reflejada por los asteroides muestran las características esperadas de semejante mezcla de fragmentos.
Podemos apreciar los interiores de los asteroides desintegrados en las exposiciones de meteoritos de algunos museos geológicos o de historia natural. Estas «piedras espaciales» son minúsculos trozos de asteroide extraviados en la trayectoria de la Tierra, que han sobrevivido durante un breve viaje a través de la atmósfera terrestre cual una brillante bola de fuego. Podemos ver «hierros», «hierros pétreos», «piedras» y «piedras carbonáceas» procedentes de estratos sucesivamente más altos de los planetesimales originales. Es difícil no sentir un estremecimiento en presencia de las rocas procedentes del espacio exterior, el único material extraterrestre que la mayoría de nosotros podrá ver. Resulta irónico que la gente permanezca en pie durante horas para ver una pizca de polvo lunar traído por los astronautas del Apolo, cuando en las secciones de meteoritos de nuestros museos se exhiben permanentemente rocas espaciales mucho mayores, que han viajado mucho más y que* tienen mayor antigüedad.
§. La Luna y Mercurio: fósiles con cicatrices
Cuando los planetesimales colisionaron para formar los «auténticos» planetas, se fragmentaron en verdaderos mundos incluso antes de formarse aquéllos. Los colosales impactos originaron vastas explosiones que dieron lugar a los cráteres, agujeros circulares de empinadas laderas. El planeta más pequeño,' Mercurio, y la Luna de la Tierra, sobrevivieron inalterados desde este bombardeo, y sus superficies están generosamente salpicadas de antiguas cicatrices. Los mayores cráteres dé la Luna, de doscientos o trescientos kilómetros de diámetro, pueden apreciarse con prismáticos, pero no son éstas sus mayores cicatrices. Las extensiones oscuras que constituyen la «cara de la Luna» son enormes llanuras de lava de varios cientos de kilómetros, que se originaron por impactos de bloques de roca del tamaño de asteroides, hace aproximadamente 4.000 millones de años. La superficie de lava negra que hoy vemos fluyó gradualmente hasta rellenar los enormes agujeros que habían fundido los átomos radiactivos en la roca subyacente de la superficie lunar.

Vista de la región de Marte donde se posó la nave no tripulada Viking 2. El horizonte tiene unos 3 kilómetros de largo, y el rosa del rielo se debe a finas partículas do polvo rojo suspendidas en la atmósfera. La cubierta (izquierda) tapa el brazo que extrae automáticamente muestras del suelo para comprobar si existen signos de vida.
El último bombardeo de planetesimales y el flujo de lava fueron los que «pusieron en hora» los relojes radiactivos que los científicos emplean para fechar la superficie lunar, y que han mostrado que es más joven que los antiguos meteoritos de 4.600 millones de años.
Mercurio, el planeta más interno, parece ser, según las fotografías obtenidas por la sonda Mariner 10 en 1974 y 1975, notablemente similar a la Luna. Sin embargo, Mercurio está arrugado como una manzana vieja. Las largas y tortuosas arrugas que serpentean por sus llanuras de lava muestran que Mercurio se ha estado encogiendo ligeramente desde que se formó. La razón, probablemente, esté relacionada de modo indirecto con la proximidad de Mercurio al Sol: cuando se formó, el calor era allí tan intenso que sólo se podían condensar las sustancias de alto punto de ebullición, en particular el hierro. Por ello Mercurio tiene un gran núcleo de hierro, que a medida que se enfrió se contrajo más que el núcleo rocoso de la Luna, arrugando la superficie del planeta.
El estudio de Mercurio por el Mariner 10 fue literalmente una revelación. Hasta entonces, las observaciones de los astrónomos del diminuto disco del planeta, siempre próximo al Sol en el cielo, habían mostrado únicamente vagas manchas oscuras que recibieron nombres místicos, como «El desierto de Hermes Trimegisto». Las manchas eran tan difíciles de ver que los astrónomos se despistaban por completo cuando intentaban determinar el periodo de rotación del planeta. Durante mucho tiempo se pensó que Mercurio ofrecía siempre la misma cara al Sol, de forma que mientras que un hemisferio estaba permanentemente cocido, el otro estaba siempre congelado, un fascinante escenario que dio lugar a muchas historias de ciencia- ficción: no obstante, cuando los radioastrónomos reflejaron ondas de radio en el planeta, en 1965, los «ecos» mostraron que el planeta gira rápidamente exactamente tres veces por cada dos órbitas alrededor del Sol.
Como la órbita de Mercurio no es completamente circular, un mercuriano vería que el Sol describiría un extraño camino en el Cielo. Si, por ejemplo, viviera en la gran llanura llamada Laguna, de Calor i s, vería que el Sol sale por el Este, se desplaza lentamente por el cielo durante 33 días terrestres y desciende después lentamente más o menos hacia el Sur.
Sin embargo, el cuadragésimo día se detendría y comenzaría a retroceder durante ocho días antes de terminar su lenta jornada en el Oeste, después de transcurridos 88 días terrestres. De cualquier forma, nuestro mercuriano tendría que ser una criatura robusta, ya que «a mediodía» la temperatura alcanza aproximadamente los 400, calor suficiente para fundir el plomo, mientras que la superficie se enfría a las temperaturas del aire líquido durante la noche.
§. Marte: ¿un lugar con vida?
Marte, el siguiente planeta más pequeño, siempre ha sido considerado el lugar más apropiado para encontrar vida fuera de la Tierra: el apelativo «marciano» ha llegado a ser sinónimo de invasores extraterrestres. A través del telescopio, Marte aparece ciertamente como el planeta más semejante a la Tierra. Tiene desiertos rojos y casquetes polares blancos, evidentemente de alguna dase de hielo, que crecen y se contraen con las estaciones. Las regiones más oscuras de la cara del planeta varían asimismo ligeramente con las estaciones marcianas, y en un principio se pensó que eran mares y, posteriormente, vegetación. Aunque Marte está más próximo que cualquier otro planeta, excluido Venus, los detalles de estas manchas oscuras son esquivos; para apreciarlos adecuadamente se requiere un buen telescopio y vista aguda.
Esto nos conduce a la historia de Percival Lowell, un astrónomo americano que dedicó su vida a observar Marte. Partiendo de una información italiana acerca de las delgadas y oscuras líneas de Marte, Lowell tuvo a su disposición un observatorio para estudiar el planeta, y realmente pudo ver cientos de esas estrechas líneas que vinculaban las mayores áreas oscuras de Marte.
Lowell estaba convencido de que eran obra de marcianos inteligentes y de que existían extensos espacios de vegetación a orillas de los canales que deberían transportar el agua desde los casquetes polares hasta los áridos desiertos del ecuador.

Marte fotografiado por el Orbiter Viking l en 1976. Las manchas brillantes (debajo del centro) son regiones de hielo próximas al polo sur marciano. Es fácilmente visible el gran impacto circular del cráter Argyre. Por encima del centro se encuentran los grandes cañones de las regiones ecuatoriales, mientras que la neblina de arriba es una formación nubosa situada sobre uno de los enormes, pero extinguidos, volcanes.
Pensaba que los «canales» eran tan rectos que debían ser artificiales y, si se tenía en cuenta que Marte parecía ser un mundo seco, ¿qué cosa más natural que llevar a cabo esas obras de irrigación a tan gran escala? Las mentes más imaginativas comenzaron a temer que los marcianos pudiesen abandonar su planeta moribundo y emigrar a nuestro húmedo mundo. Esto fue lo que inspiró a H.G. Wells la historia de La guerra de los mundos (1898) que, adaptada para radio por Orson Welles en 1938, resultó tan convincente que muchos oyentes creyeron que se trataba de un noticiario.
Sin embargo, también en la época de Lowell (murió en 1916) los astrónomos eran escépticos. Ni siquiera el ojo de águila de E. E. Barnard pudo apreciar los canales, ni aun con telescopios mayores que los de Lowell. Después de la muerte de éste, comenzó a parecer más evidente que Marte era muy seco, que tenía menos atmósfera de la que se pensaba y que las áreas oscuras se parecían cada vez menos a vegetación. Los marcianos inteligentes parecían quedar excluidos, pero ¿podrían existir en Marte formas de vida sencilla, como la de los líquenes?
La primera de las tres sondas espaciales enviadas a Marte en la década de 1960 mostró un planeta aún más estéril de lo que se había esperado. Las fotografías obtenidas mostraban una superficie de cráteres de tipo lunar, y no había rastro de canales rectos. Sin embargo, sucedió que todas estas antiguas naves «de paso» habían fotografiado las partes menos interesantes del planeta, y la situación cambió cuando se situó al Mariner 9 en órbita alrededor de Marte en 1971. Sus sorprendentes fotografías incluían un enorme sistema de cañones en el ecuador de 5.000 kilómetros de longitud, con un valle principal de 75 kilómetros de ancho y 6.000 metros de profundidad. La comparación con el Gran Cañón del Colorado es completamente inadecuada, ya que en este valle marciano habría sitio de sobra para los Alpes completos.
Cerca, existen cuatro gigantescos volcanes que empequeñecen a cualquier volcán terrestre. El mayor, Olympus Mont (Monte Olimpo), tiene aproximadamente 600 kilómetros de diámetro y 25.000 metros de altura, una montaña que cubriría a España entera y que es tres veces más alta que el Everest. Lo más interesante de todo, para quienes esperaban encontrar vida en Marte, residió en que el Mariner 9 descubrió una serie de canales estrechos y serpenteantes, indudablemente lechos de ríos secos. Las regiones oscuras de Marte carecen de vegetación y son, simplemente, áreas en las que los vientos estacionales remueven el brillante polvo de la superficie. No obstante, existía todavía razón para el optimismo en la búsqueda de vida. Los canales sugieren que alguna vez corrió el agua por la superficie de Marte, y, si así fue, la atmósfera debía entonces ser más densa; bajo estas condiciones más hospitalarias podían haberse desarrollado formas de vida simples, como bacterias, que podrían permanecer aún latentes en el suelo.
Las dos naves Viking que se posaron en Marte en el verano de 1976 llevaron a cabo experimentos biológicos sencillos con el fin de comprobar si existía semejante tipo de vida. Los resultados inmediatos fueron muy confusos, ya que las diferentes pruebas dieron conclusiones contradictorias; y lo más probable era que los resultados «positivos» se debieran a reacciones químicas con el inesperadamente reactivo suelo marciano. El experimento decisivo consistió en una sensible prueba destinada a detectar la presencia de compuestos de carbono, elemento en que se basa la vida. No se encontró ninguno en el suelo, y este resultado excluye a las células vivas del tipo de las que conocemos en la Tierra. La mayoría de los científicos llegó, a su pesar, a la conclusión de que, al menos en los dos sitios en donde se posaron los Vikings, Marte es un mundo muerto.
§. Venus: el planeta infernal
Aun cuando Venus es el planeta más próximo a la Tierra, siempre ha sido un mundo misterioso.

Las persistentes nubes de Venus muestran, cuando se fotografían con luz ultravioleta, estructuras de circulación atmosférica. El Mariner 10 tomó esta cercana fotografía cuando sobrevoló Venus en su camino hada Mercurio.
Todo lo que podemos apreciar a través de los telescopios es la parte superior de la continua nube que lo cubre, resplandeciendo tan brillantemente a la luz solar que le hace ser el objeto más luminoso de nuestros ciclos después del Sol y la Luna. Venus es de casi igual tamaño que la Tierra, y los astrónomos del último siglo imaginaban que bajo sus nubes existía un paraíso. No obstante, ahora sabemos que la superficie de Venus es muy semejante al Infierno, y es opinión de los planetólogos que nuestra bella Tierra hubiera seguido el mismo camino de haberse hallado más próxima al Sol.
Así como las sondas espaciales americanas hicieron muchos progresos en el estudio de Marte, fue una nave soviética la que llegó hasta la superficie de Venus. Las primeras naves que intentaron posarse fueron aplastadas por una atmósfera mucho más espesa que lo esperado; pero, por último, otras firmemente reforzadas lograron su objetivo. En 1975, dos de ellas sobrevivieron durante una hora y enviaron las primeras fotografías de la superficie de Venus. Estos resultados soviéticos, más los de las sondas de paso de los americanos, desaniman a cualquiera que piense en viajar a Venus.
Las maravillosas nubes probablemente estén constituidas por pequeñas gotas de ácido sulfúrico concentrado. La atmósfera es cien veces más espesa que la de la Tierra, y da lugar sobre la superficie de Venus a una presión atmosférica igual a la que experimentaría un submarino a 1.000 metros de profundidad en los océanos terrestres.
La atmósfera está constituida principalmente por el irrespirable gas dióxido de carbono, y la superficie tiene una temperatura constante próxima a los 500° C, más caliente aún que la de Mercurio «a mediodía».

Las ondas de radio pueden penetrar a través de las nubes de Venus, y este mapa en «seudocolor» de la superficie de Venus se ha establecido utilizando pulsos de radar. Las regiones amarillas son tierras altas, y las azules, bajas; mapas más detallados ponen de manifiesto cráteres y montanas individuales. Observaciones de radar llevadas a capo por el Observatorio de Arecibo. (Cortesía de NAIQ/NSE.)
Las fotografías de la superficie la muestran salpicada de rocas y con llanuras estériles que se extienden hasta el horizonte en un planeta sorprendentemente luminoso, habida cuenta su masiva cubierta de nubes, ya que es comparable a un día encapotado en Moscú.
Los datos de las sondas espaciales se han complementado con resultados de radar. Las ondas de radio pueden penetrar las nubes, y los «ecos» de radar mostraron, allá por 1962, que el planeta gira muy lentamente y en dirección contraria a los demás. Si no existieran nubes, un venusiano vería salir el Sol por el Oeste y ponerse por el Este después de transcurridos 60 días terrestres. Análisis más detallados de los ecos de radar ponen de manifiesto enormes cráteres y montañas. El estudio geológico de Venus está aún en su infancia, mientras los planetólogos esperan con ilusión poder efectuar comparaciones entre la Tierra y este planeta de tamaño similar.
Pero ¿por qué Venus es tan diferente de la Tierra? La respuesta reside en que realmente la Tierra es la singular: en días remotos nuestro planeta fue, probablemente, muy parecido a Venus en su estado actual. Así pues, dejemos al hostil Venus un mundo en el que un intrépido astronauta simultáneamente se asaría, sería aplastado, envenenado y corroído por el ácido y retornemos al único planeta del sistema solar realmente amigable: la Tierra.
§. El planeta Tierra
Nuestro planeta es el tercero a partir del Sol y el mayor de los planetas rocosos. A un viajero del espacio, la Tierra le parecería única también en otros aspectos. Es el único planeta rocoso sin cráteres evidentes, el único con agua líquida, el único con abundancia de oxígeno en la atmósfera y el único planeta con vida. Por cierto, todas estas singularidades se relacionan entre sí. Estudiando otros planetas, los astrónomos han llegado a la conclusión de que la Tierra y nuestra existencia gozan de sus privilegios gracias a dos factores. Uno es que la gravedad terrestre resulta suficientemente intensa como para mantener una atmósfera; el otro es que, debido a que la Tierra se encuentra a la distancia apropiada del Sol, su temperatura es la adecuada.
Una Tierra demasiado pequeña para mantener una atmósfera habría acabado siendo muy [carecida a nuestra lúgubre compañera, la Luna. Sin embargo, la atmósfera de Venus, un planeta virtualmente del tamaño de la Tierra, está constituida por un gas asfixiante cien veces más denso que el de la Tierra. ¿Por qué ha atinado la Tierra con su justo medio? Para responder a este interrogante hemos de retroceder a su nacimiento.
La antigua Tierra, al igual que el resto de los planetas interiores, debe haber experimentado un bombardeo final de planetesimales hace unos 4.000 millones de años. En aquel tiempo debía ser como una enorme bola cubierta de cicatrices, muy semejante a una superficie lunar. En aquella época, ningún planeta podía tener atmósfera, ya que fue por entonces cuando el Sol comenzó a brillar y sobrevino un periodo de superactividad. Los protones y electrones procedentes de su superficie se abrían paso a través del antiguo sistema solar, arrastrando al espacio todo el gas que no se había incorporado a los planetas gigantes, incluida cualquier antigua atmósfera terrestre. Sin embargo, cuando la actividad llegó a su estado actual, de relativa tranquilidad, los volcanes de la Tierra comenzaron a cubrir al planeta con una segunda atmósfera. Al igual que en la actualidad, los volcanes debieron expulsar gases irrespirables, principalmente vapor de agua y dióxido de carbono, pero con constituyentes minoritarios desagradables como compuestos de azufre, dióxido de carbono y cianuro de hidrógeno.
La Tierra y Venus debieron tener en aquella época atmósferas similares, pero pronto se manifestó el efecto crucial de la distancia al Sol. La Tierra estaba bastante fría como para que el vapor de agua pudiera condensarse en pequeñas gotas de agua, pero Venus seguía demasiado caliente. La atmósfera de dióxido de carbono de Venus se hizo cada vez más espesa y se cubrió de nubes de gotas de ácido sulfúrico. El dióxido de carbono actúa como el cristal en las ventanas de un invernadero: deja pasar la energía del Sol en forma de luz, pero cuando esta energía calienta la superficie, la radiación calorífica (infrarrojo) no puede atravesar el gas para escapar al espacio. En consecuencia, el calor quedó atrapado en la superficie y la temperatura de Venus se elevó rápidamente hasta el punto de fusión del plomo. Mientras tanto, todo el vapor de agua de Venus, probablemente descompuesto por la luz solar en la parte superior de su atmósfera, escapó al espacio en forma de átomos de oxígeno e hidrógeno.
La Tierra se salvó de este destino. El vapor de agua condensado en nubes cayó en forma de lluvia, y el dióxido de carbono se disolvió en el agua; aunque nuestra atmósfera estaba constituida por los gases expulsados por los volcanes, la mayoría de éstos eran susceptibles de disolverse en los mares y, a diferencia de lo que sucedió en Venus, no se acumularon. De esta forma, los océanos salvaron a la Tierra de una catástrofe calorífica, aunque también alteraron su faz, ya que la erosión de las corrientes de agua es tan grande que acabó borrando la huella de los antiguos cráteres terrestres, convirtiendo a la Tierra en el menos «recortado» de los planetas interiores.
La otra fuerza geológica que modeló la superficie terrestre fue la suma de lentos movimientos de partes de su corteza. La mayoría de los escolares suele advertir en sus mapas que la «panza» oriental de Sudamérica encajaría perfectamente en la costa occidental de África; sin embargo, hasta la década de 1960 los geólogos no se persuadieron de que, efectivamente, hubo un tiempo en que esto era así y que los continentes derivan sobre la superficie de la Tierra, desgajándose y modificándose. Según la moderna teoría de la deriva continental, denominada «tectónica de placas», la corteza terrestre está constituida por al menos quince «placas» separadas (siete de, ellas muy extensas), todas en vinculación y moviéndose gradualmente una respecto de otra. Muchas de las placas son porciones de suelo oceánico, pero algunas de las mayores transportan los continentes más ligeros sobre sí, y a medida que se mueven, sus «pasajeros» continentales se desplazan a través de la Tierra.
Guando dos placas chocan, evidentemente ha de suceder algo. En la práctica, una de las placas se sumerge bajo la otra y desaparece en el interior caliente de la Tierra, donde se funde. La fricción de una placa con otra origina terremotos, y la roca recién fundida se abre paso a través de la capa superior y reaparece dando lugar a un rosario de volcanes. El suelo del Océano Pacífico es una gigantesca placa que se desplaza de norte a oeste; cuando se sumergió bajo la placa que transporta a Asia dio lugar a un rosario de volcanes que se convirtieron en una ringlera de islas volcánicas propensas a los terremotos: el Japón es «los restos de tal colisión».
Las placas que soportan los contienen de América del Sur y África son, como lo sugiere el globo terráqueo, los restos de un gran «supercontinente» que se hallan en un verdadero proceso de alejamiento.

El aspecto de la Tierra se modifica en el curso de millones de años, a medida que los continentes derivan .sobre su superficie. Los geólogos llaman Panguea al supercontinente original que tenia un gran golfo, el Mar de Tetis. Panguea se dividió en dos extensas masas de tierra, Laurasia y Gondwamlandia, que posteriormente se fragmentaron en los continentes que hoy conocemos. 1. La superficie aparentemente estática del mundo actual se mueve, en realidad, muy lentamente. El hecho de que las dos costas del Océano Atlántico encajaran cual piezas de un rompecabezas condujo de inmediato a la idea de un gran supercontinente. 2. Hace 50 millones do años, de acuerdo ron la evidencia de los fósiles y del magnetismo de las rocas, Australia estaba próxima a la Antártida, y la India derivaba hacia el Norte para colisionar con Asia. El Atlántico crecía no menos de 10 centímetros por año. 3. Hace 100 millones de años, la India había anidado entre África y la Antártida. Las tres partes se combinaron con América del Sur y Australasia hasta formar un enorme continente, y América del Norte con Eurasia para formar el otro. 4. Hace 170 millones de años, el mundo contenía una enorme masa de tierra que, se cree, era resultado de una deriva anterior. El mar de Tethys, que separaba Eurasia de África, llegó más adelante a ser el Mediterráneo. La otra cara del globo muestra el antiguo Pacífico. 3.
El vacío que dejan en el Océano Atlántico se rellena con rocas recién fundidas que ascienden desde el interior y se solidifican, originando una cordillera que se extiende a lo largo de todo el océano y que llega a emerger a la superficie, dando lugar a islas aisladas como la Isla de Ascensión y St. Paul Rocks. Más adelante, esta roca se divide hacia uno y otro lado, constituyendo parte del suelo oceánico, mientras que en el centro emergen nuevas rocas. El suelo del Océano Atlántico es, por tanto, más joven en el centro, y las muestras obtenibles son tanto más viejas cuanto más alejadas están del centro hacia uno y otro lado. Esta diferencia de edad convenció finalmente a muchos geólogos do que debía considerarse seriamente la teoría de la tectónica de placas.
Otro argumento de peso proviene de) estudio del magnetismo que poseen las rocas continentales desde que se formaron. Si se calculan las posiciones de los polos magnéticos terrestres a partir del magnetismo de estas antiguas rocas, los resultados no concuerdan. Sin embargo, si hacemos que los continentes se muevan y giren, se puede lograr un buen ajuste, y las posiciones de los continentes en diversas épocas del pasado acaban concordando con los movimientos deducidos. En el relativamente breve lapso de diez años, los geólogos cambiaron totalmente de opinión sobre la cuestión de la deriva continental: a partir de una idea fantástica, surgió la teoría de la tectónica de placas como la forma más aceptada de explicar los movimientos de la corteza terrestre.
Como las placas se sumergen continuamente unas bajo otras hasta refundirse, y rocas nuevas surgen en las cordilleras mesoceánicas, ninguno de los suelos oceánicos tiene más antigüedad que unos cuantos cientos de millones de años, menos de la décima parte de la edad de la Tierra. Esto no sucede en los continentes, constituidos por rocas más ligeras que suelen permanecer arriba. Cuando dos placas que transportan continentes se encuentran, una de ellas cabalga sobre la otra. La gradual compresión eleva los bordes en gigantescas cadenas montañosas, como la del Himalaya, que se levantó cuando la India colisionó con Asia hace «sólo» cincuenta millones de años.
Hay algo de fascinante trabajo detectivesco en el hecho de relacionar las pistas suministradas por el suelo de los océanos, el magnetismo de las rocas continentales y las edades de las antiguas cadenas montañosas, mudos testimonios de las pasadas colisiones, para formarnos una imagen de la Tierra en el pasado. Aproximadamente hace 200 millones de años, todos los continentes formaban un gigantesco supercontinente al que denominamos «Pangæa» (que en griego significa «la totalidad de la Tierra») y que, subsecuentemente, se fraccionó en los que hoy conocemos. La propia Pangæa se constituyó por una serie de colisiones entre los continentes preexistentes durante los 200 millones de años precedentes. Los geólogos piensan ahora que las placas estuvieron desplazándose desde hace por lo menos 2.700 millones de años, y que los continentes que las acompañaban se desplazaron a su vez sobre la Tierra, a veces como un supercontinente, y otras, como un gran número de rocas individuales más ligeras.
Pero ¿qué hace que las placas de la corteza terrestre se desplacen? Ciertamente, es necesaria una gran cantidad de energía para mover un continente entero a una velocidad de uno a diez centímetros por año, y la opinión de los expertos está dividida. Últimamente se piensa que la fuente puede ser el calor liberado en el interior de la Tierra por los átomos radiactivos, pero aún no está claro cómo se transforma este calor en movimiento de la placa.
En el interior de la corteza terrestre, el calor liberado por el uranio, el torio y el potasio-40 da lugar a que la temperatura se eleve. Bajo la corteza, a unos 35 kilómetros por debajo de la superficie del continente, las rocas se funden parcialmente para formar una capa «fangosa». Esta capa lubrica el deslizamiento de las placas de la corteza sobre las subyacentes, y hace considerablemente más fácil la deriva. Más abajo aún, la temperatura es todavía más elevada, pero el peso de las capas superiores comprime las rocas en forma sólida. Esta zona, el «manto», constituye la mayor parte del interior de la Tierra que rodea a un núcleo central de hierro-níquel. Las partes externas del núcleo metálico son líquidas y, al igual que el núcleo de hidrógeno metálico de Júpiter, las corrientes eléctricas generan el campo magnético que rodea a nuestro planeta.
Los planetólogos están intrigados por la masiva actividad geológica de la Tierra. ¿Tiene cualquier planeta de igual masa que la de la Tierra una superficie de placas deslizantes? Cuanto más se estudie a Venus, su comparación con la Tierra ayudará a que los geólogos comprendan mejor a ésta. Se ha efectuado ya una comparación entre los volcanes de Marte y los de la Tierra, lo que nos ha revelado algo acerca de los volcanes de «punto caliente».
Los continentes de la Tierra derivan al ser transportados sobre grandes «placas» en movimiento. El Océano Atlántico sur se dividió en placas que transportan a América del Sur y a África, que se han separado. De la Cordillera mesoatlántica surgen nuevas rocas, mientras que los Andes se han elevado al cabalgar América del Sur sobre la placa del Pacífico.

Una mirada al mapa de las costas atlánticas de Europa, África y las dos Américas pone de manifiesto la sorprendente similitud de sus contornos, advertida ya por generaciones de escolares al considerarlas como piezas de un rompecabezas. En 1908, el geólogo americano Frank Taylor publicó una teoría según la cual había habido un tiempo en el que los continentes constituían una masa de tierra. El científico alemán Alfred Wegener publicó en 1915 un libro sobre este tema. El geólogo sudamericano Alexander du Toit fue uno de los que comenzó a acumular evidencias. Hacia 1960 se, descubrió el mecanismo de la tectónica de placas, y la teoría de la deriva continental resultó ampliamente aceptada.

No todos los volcanes terrestres se han originado, como en el caso de Japón, en el hecho de que una placa se haya sumergido bajo otra. Hawai es un volcán del centro de la placa del Pacífico, y, al parecer, se ha originado como consecuencia de un flujo ascendente continuo de roca caliente, procedente del manto, que se eleva siempre en el mismo lugar. A medida que la placa del Pacífico ha derivado en dirección norte-oeste, sobre este «punto caliente», la columna ascendente de roca ha ido taladrando una serie de perforaciones en la placa, mientras que los antiguos conos volcánicos se desplazaban a lo largo de una línea norte-oeste de islas y montículos marinos (montañas bajo el agua que no alcanzan la superficie). Cada volcán originado por el punto caliente hawaiano sólo puede crecer hasta un tamaño determinado antes de alejarse del suministro de roca. Marte no muestra ningún signo de tectónica de placas, y el enorme tamaño de sus volcanes puede simplemente deberse a la acumulación continua de lava por encima de un punto caliente al estilo hawaiano. Quizá los puntos calientes puedan desarrollarse en una amplia variedad de mundos, desde Marte a la Tierra diez veces más pesada, pero la tectónica de placas sólo tiene lugar en los mayores planetas rocosos. El estudio de la Tierra en tanto que planeta es una ciencia todavía en pañales, y no cabe duda de que aún reserva muchas sorpresas.
Capítulo 5
La vida: organización de los átomos
¿Cómo puede combinarse un puñado de partículas fundamentales para dar lugar a la maravilla que llamamos vida? ¿Por qué ha sucedido en la Tierra este milagroso accidente... y qué ocurre en los planetas de otros sistemas solares?

La compleja disposición de los átomos en las moléculas de ADN (que se muestran en este modelo en colores diferentes) transporta toda la «información» necesaria para crear y mantener cualquier ser vivo, desde el microscópico plancton hasta el hombre.
§. Las sustancias químicas de la vida
§. El carbono: átomo esencial de la vida
§. La unidad de control de la célula
§. La decodificación del mensaje de la vida
§. La alimentación de la célula
§. El lugar de la vida en el Universo
§. Vida a partir de la no vida
§. Hacia lo mejor
§. Los refugios de la vida
§. La comunicación a través del espacio interestelar
§. Viaje a las estrellas
¿Qué diferencia existe entre un elefante y un tallo de ruibarbo? Si contestamos «muy poca», puede que el tendero nos mire con extrañeza, aunque ésta es precisamente la respuesta que tendría que dar un científico moderno que estudiase la vida.
El planeta Tierra es probablemente el único del sistema solar que mantiene vida. A pesar de su enorme variedad de apariencias, las formas de vida en la Tierra son sorprendentemente similares en su constitución básica. Esta es la conclusión a que han llegado, tras siglos de estudios, los biólogos; y, más recientemente, los bioquímicos que investigan la química de la vida. Estos experimentos han dado lugar a un enorme acopio de información acerca de cómo se originan y funcionan las formas terrestres de vida.
La astronomía moderna ha abierto nuevos caminos al estudio de la vida. En primer lugar, los astrónomos y planetólogos han elaborado rápidamente una detallada imagen de la formación de la Tierra, y en la actualidad pueden decir cuáles fueron las condiciones que debieron existir cuando aparecieron sobre la Tierra los primeros seres vivos. Esto, combinado con los pormenores sobre la química de la vida, elucidados paulatinamente en la actualidad por los bioquímicos, tiende a que se resuelva rápidamente el misterio del origen de la vida en nuestro planeta. Otra nueva perspectiva es la confirmación de que muchas otras estrellas poseen planetas similares a la Tierra, por lo que parece muy improbable que la vida se limite al nuestro. Muchos astrónomos afirman que nuestra Galaxia es fecunda en vida, y que sólo las inmensas distancias entre las estrellas nos mantienen apartados de nuestros hermanos del espacio.
¿Será semejante la vida en otro planeta? O bien, ¿se basará en compuestos químicos y reacciones totalmente diferentes de las formas de vida terrenales? Ciertamente, los escritores de ciencia ficción han inventado todo tipo de extrañas criaturas, pero nosotros comenzaremos observando de cerca el tipo de vida que conocemos: la existente en la Tierra.
Los biólogos que observan la materia viva al microscopio descubren que todos los seres vivos, plantas o animales, están constituidos por minúsculos paquetes o células. Una brizna de hierba está compuesta por millones de células; la mayor criatura viva, la ballena azul, por billones de ellas. Los organismos más sencillos están constituidos por una única célula; multitud de microscópicas algas unicelulares atestan los pantanos, y las células simples de las bacterias nos son bien conocidas como «gérmenes» necesarios para la vida, aunque algunas veces puedan ser portadores de enfermedades. En los organismos «superiores», las células se han especializado en el desempeño de distintos cometidos. A lo largo de las células nerviosas circulan señales eléctricas por nuestros cuerpos; las células musculares tienen la capacidad de contraerse cuando se les solicita; y las células blancas de la sangre flotan en nuestros cuerpos para capturar y destruir las bacterias que los invaden. Sin embargo, todas tienen la misma constitución básica. El cuerpo humano se puede comparar a una gran ciudad: cada trabajador, célula o ciudadano, es fundamentalmente similar, pero cada uno desempeña su propio papel en el mantenimiento del organismo o de la ciudad a fin de que éstos funcionen de manera eficaz.
Como veremos posteriormente, una vez que observemos el interior de las células la similitud resultará aún más marcada. Por el momento, investiguemos las sustancias químicas de que estamos hechos.
§. Las sustancias químicas de la vida
Supongamos que pudiéramos descomponer un cuerpo humano en sus átomos y extraer éstos elemento a demento; la tarea sería ardua, ya que cada uno de nosotros está compuesto por unos 1027 átomos. Para empezar, descubriríamos que más de la mitad, de los átomos son de hidrógeno, el elemento más sencillo. Nuestros cuerpos contienen tanto hidrógeno que, si se encontrara en su forma habitual de gas, un globo lleno con esta cantidad sería capaz de elevarnos del suelo.
El siguiente en abundancia es el oxígeno. Dado que los átomos de oxígeno son sesenta veces más pesados que los de hidrógeno, hay que atribuirles la mayor parte del peso del cuerpo, aproximadamente las tres cuartas partes del total.
El tercero es el carbono, que constituye una décima parte del peso del cuerpo, suficiente, si se encontrara en forma pura de grafito, para suministrar minas a tres mil lapiceros. Y a continuación, el nitrógeno, el gas más abundante del aire, seguido por pequeñas cantidades de fosforo, hierro, calcio, azufre y otros elementos que constituyen una minúscula proporción del peso del cuerpo, pero esenciales para su buen funcionamiento.
Estos cuatro elementos más importantes para la vida: hidrógeno, oxígeno, carbono y nitrógeno, son también los más abundantes en el Universo (si excluimos el gas no reactivo helio), por lo que somos auténticos hijos del cosmos. Todas las criaturas vivas de la Tierra poseen un equilibrio similar de elementos, y esto refleja el hecho de que toda la vida que conocemos está constituida por células muy similares.
Dejemos el escenario de los átomos y consideremos cómo se agrupan en moléculas. Después de todo, la suma del puñado de elementos antes citados no constituye por sí sola un cuerpo humano, de igual forma que una pila de ladrillos, mortero, madera y tejas tampoco constituye una casa. Las interacciones, los enlaces químicos y las reacciones entre átomos, confieren a la vida sus propiedades únicas. Desde no hace mucho, los científicos creen que es necesaria una «fuerza vital» para conformar un organismo vivo: las intrincadas estructuras de las moléculas implicadas en la vida, así como las enormemente complicadas reacciones químicas en la célula, indican que la vida es una actividad muy diferente de otra cualquiera que tenga lugar en el mundo inanimado, aunque los átomos y las fuerzas involucradas sean los mismos.
En rigor de verdad, la única fuerza implicada en el proceso de la vida es la electromagnética. A la química de la vida no le incumbe la minúscula escala de los núcleos atérmicos en los que operan las dos fuerzas nucleares, y la fuerza de la gravedad es demasiado débil para afectar a las reacciones químicas del interior de las células. Lo que mantiene unidos a los átomos en una molécula y rige el curso de las reacciones que transforman una molécula en otra, son las interacciones entre los electrones que se mueven en el campo eléctrico de sus núcleos, o sea manifestaciones de la fuerza electromagnética.

Un cristal de vitamina A, sustancia química esencial para el normal funcionamiento de las células humanas, las sustancias químicas implicadas en los procesas vitales no difieren básicamente de las otras; Únicamente son más complicadas
Los átomos aislados, sin carga, tienen electrones suficientes como para ser eléctricamente neutros; los electrones en órbita, cargados negativamente, igualan en número y cancelan a los protones del núcleo cargados positivamente.
No obstante, en muchos elementos estos electrones no llenan por completo las órbitas que les están permitidas por la teoría cuántica. Para completar estas órbitas, sin perder su neutralidad eléctrica, los átomos recurren a la estratagema de compartir electrones con sus vecinos. Los átomos adyacentes se ligan entonces firmemente por medio de un par de electrones compartidos, cedido uno por cada átomo, y forman parte de una molécula.
En el caso del sencillo gas metano (gas de los pantanos) tenemos cuatro átomos de hidrógeno ligados a un átomo central de carbono; por tanto,

El carbono tiene cuatro electrones en sus órbitas más externas, pero las leyes cuánticas le permiten completarlas con otros cuatro. Al compartir un electrón de cada átomo de hidrógeno, el átomo de carbono se encuentra rodeado por su número total permitido de ocho electrones, y como cada electrón está compartido, la carga negativa media en torno al núcleo de carbono es sólo la equivalente a cuatro electrones. Un átomo de hidrógeno está completo con dos electrones, por lo que a cada átomo de hidrógeno del metano le basta con su propio electrón y con uno de los cuatro del carbono. Los cuatro átomos de hidrógeno que rodean a un átomo de carbono dan lugar a una configuración muy estable, una molécula.
Cada par de electrones compartidos por dos átomos próximos constituye un enlace químico. Por tanto, el carbono [ruede formar cuatro enlaces; y el hidrógeno, uno. Las estructuras electrónicas de los átomos de oxígeno y nitrógeno exigen que formen dos y tres (o bajo ciertas circunstancias, cinco), respectivamente.

El diamante es una forma de carbono puro en la que los átomos se encuentran firmemente ligados en una sólida red, por lo que es la sustancia más dura que se encuentra en la Naturaleza. Este diamante en bruto, ligeramente coloreado por impurezas, está exactamente tal como se lo extrajo de la mina. La estructura de otra forma del carbono, el grafito. Las capas de átomos están únicamente ligadas cual las hojas de una pila de papel, por lo que el grafito es blando y se emplea en la fabricación de minas de lapicero y como lubricante.
Es fácil advertir que este número permitido de enlaces químicos puede originar moléculas sencillas: un átomo de oxígeno y dos de hidrógeno constituyen el agua (H—OH); uno de nitrógeno y tres de hidrógeno, el amoniaco:

uno de carbono y dos de oxígeno, el dióxido de carbono (O=C=O); en este último compuesto, el átomo de carbono comparte dos pares de electrones con cada átomo de oxígeno para formar enlaces dobles.
Así, a partir de átomos unidos por enlaces químicos se constituyen todas las moléculas de las células vivas. Por simplicidad, las fórmulas de las moléculas generalmente se abrevian: el agua es H2O; el amoniaco, NH3, y el dióxido de carbono, CO2. El orden de los símbolos atómicos es el tradicional para estos compuestos bien conocidos, aunque el agua también podría escribirse OH2, y el amoniaco, H3N. Sin embargo, para compuestos mayores únicamente tiene sentido expresar los símbolos de una forma que corresponda a su estructura. La estructura del alcohol es


(cada "—" representa un par de electrones compartidos) y podría escribirse C2H6O; pero está fórmula también es aplicable a

un miembro de la familia del éter que sería claramente inoportuno en cualquier bebida. Por consiguiente, la fórmula del alcohol se escribe CH3CH2OH, o C2H5OH, y la de esta molécula de éter, CH3OCH3.
§. El carbono: átomo esencial de la vida
Esta breve digresión acerca de la forma en que los químicos representan y abrevian compuestos de carbono, así como otros, mediante fórmulas, nos sitúa ante cómo se construyen las complicadas moléculas involucradas en la vida y ante el modo en que registran los bioquímicos sus descubrimientos en términos razonablemente sencillos. No es mera coincidencia el énfasis puesto en los compuestos de carbono, pues éste es el elemento de la vida. Entre los ciento y tantos elementos conocidos, el carbono es único desde el punto de vista químico. Únicamente los átomos de carbono se combinan entre sí formando largas cadenas, extensos esqueletos de átomos a los que pueden adherirse otros para dar lugar a una enorme variedad de compuestos. Las moléculas mayores de las células vivas contienen varios miles de millones de átomos, y el hecho fundamental consiste en que cada uno de ellos es importante para el buen desarrolló de la célula. Después de todo, un grano de arena consta de muchos átomos, todos ellos dispuestos en una red bien proporcionada que constituye un cristal; pero a pesar de su tamaño, la molécula gigante de .un grano de arena es muy simple, ya que consiste en una unidad básica constituida por un átomo de silicio y dos de oxígeno que se repiten una y otra vez. Al contrario, a lo largo de las grandes moléculas de una célula viva no se repiten disposiciones idénticas de átomos, sino que cada parte de una molécula es diferente de las demás, y estas diferencias motivan la complejidad de un organismo vivo.
Dado que estos complicados compuestos de carbono se hallan en el interior de las células vivas, pero no se presentan fuera de ellas en estado natural, la química de los compuestos de carbono se ha conocido desde siempre como química orgánica, denominación mantenida hasta la fecha. El gran número de reacciones posibles con los numerosos compuestos de carbono ha dado lugar a que, en muchas universidades, la química de este único elemento se estudie en un departamento de química orgánica, tan grande como el correspondiente a química inorgánica, dedicado a la química del resto de los elementos.
La diversidad de los compuestos de carbono es esencial para la vida que conocemos. Pensemos en la cantidad de información que se requiere para describirnos a nosotros mismos como diferentes de cualquier otra persona o de otro ser vivo: cuando un ser humano ha sido concebido, esta enorme cantidad de detalles desde el número de dedos de los pies hasta el funcionamiento del hígado es transmitida en código por una única célula, pero de moléculas enormemente largas. Sin embargo, y pese a su tamaño, estas moléculas son bastante estables: la información de la herencia puede transmitirse a los descendientes con modificaciones muy pequeñas incluso después de algunas décadas (aunque, por supuesto, se sume a la información del otro progenitor). Las moléculas que presentan esta resistencia al cambio son importantes para la vida también por otras razones. Las moléculas orgánicas que constituyen las capas externas de las células deben formar una barrera resistente que mantenga a la célula intacta y le permita resistir el ataque de las sustancias químicas exteriores. Las células especializadas que forman nuestra piel, o las que constituyen la corteza de los árboles, están adaptadas para producir en cantidad este tipo de moléculas.

Un exacto modelo a escala de una diminuta sección de la molécula de la herencia, el ADN. Los retorcidos cúmulos externos de átomos de oxigeno (rojos) e hidrógeno (blancas) señalan la doble hélice del «esqueleto» del azúcar-fosfato: las unidades centrales azules y negras representan los grupos atómicos que transportan la información genética.
No obstante, la vida necesita moléculas que puedan variar dadas ciertas circunstancias. La energía puesta en juego cuando una planta puja a través de la tierra, o cuando un atleta lanza un disco, proviene de moléculas que se alteran, o, en otras palabras, que experimentan una reacción química. Un ser humano ingiere «combustible» (azúcar, por ejemplo) y éste se descompone en las células musculares al reaccionar con el oxígeno, con lo que produce dióxido de carbono y agua, liberando energía durante el proceso para potenciar el músculo. Esta reacción no es directa, sino que existen docenas de moléculas diferentes implicadas en un amplio espectro de reacciones.

La molécula de ADN efectuando una réplica por división de sus dos hebras. Cada una atrae pequeñas moléculas complementarias del fluido en el que están inmersas, que son soldadas por las enzimas y dan lugar a dos moléculas completas de ADN, cada una de ellas idéntica a. la original.
De aquí que los compuestos de carbono deban ser adaptables, ya que si fueran completamente inertes químicamente, los procesos vitales resultarían imposibles.
En definitiva, el carbono es el elemento ideal para la vida. Es abundante en el Universo, y sus compuestos son sorprendentemente diversos y conjugan la estabilidad y la capacidad de reacción. Si se encuentra vida en otro lugar del Universo, lo más probable es que esté constituida por moléculas basadas en cadenas de átomos de carbono.
§. La unidad de control de la célula
Comencemos nuestra investigación de la célula propiamente dicha por el centro, donde un pequeño cuerpo redondo llamado el núcleo (no confundirlo con el núcleo de un átomo) actúa como la unidad de control de la célula. Aquí están almacenados los «cianotipos», que clan cuenta de cómo está construida la célula y de cómo tienen lugar, en cualquier parte de la misma, las reacciones químicas que la mantienen en funcionamiento. El núcleo coordina las actividades de la célula para asegurar su supervivencia y, a su debido tiempo, da la señal para que se reproduzca, lo que ella realiza de la forma más sencilla posible: dividiéndose en dos células idénticas, pero más pequeñas.
El núcleo de la célula es también una vasta «biblioteca». En el interior del núcleo de cada célula del cuerpo se encuentran los planos de todo el cuerpo. Estos detallados planos le fueron necesarios a la célula original a partir de la cual el cuerpo comenzó a desarrollarse en la concepción, y han sido transmitidos fielmente a todas las células subsiguientes. Por tanto, cada núcleo celular incluye más información de la que necesita para el funcionamiento habitual, y, teóricamente, es posible tomar cualquier célula del cuerpo, como el óvulo fertilizado presente en la concepción, e impedir su desarrollo. El resultado sería otro ser humano exactamente igual al donante de la célula. En un controvertido libro americano se ha publicado recientemente que un millonario excéntrico había pagado a un médico para que hiciera exactamente esto, y que ahora tiene un hijo que es una «fotocopia» suya. Aunque muchos científicos han denunciado esta pretensión particular, concuerdan en que esto (el proceso se conoce con el nombre de clonación) no es imposible con nuestros conocimientos actuales de los mecanismos celulares.
Los «cianotipos» del núcleo de la célula se presentan en forma de una molécula bastante poco común, el ácido desoxiribonucleico, un nombre incómodo de pronunciar y que los bioquímicos prefieren abreviar como ADN. Las moléculas, inmensamente largas, están arrolladas de forma que se acoplan fácilmente al núcleo de la célula. Si pudiéramos desenrollar todo el ADN de una microscópica célula humana v extenderlo, su longitud total sería de aproximadamente un metro.
Pero ¿cómo está registrada nuestra información en la molécula de ADN? ¿Cómo se decodifica? ¿Cómo se transmite de forma tan precisa a las células «hijas»? El primer progreso importante en la comprensión de este mecanismo de la vida tuvo lugar en 1953, cuando James Watson y Francis Crick descubrieron que los átomos de la molécula de ADN están dispuestos en una «doble hélice», al igual que los dos hilos enrollados del cordón de una lámpara.

Una fotografía electrónica de un gen, la unidad básica de la herencia. Consiste en una larga molécula de ADN que se enrolla para reducir su longitud e incrementar su anchura.
Esto supuso, realmente, un alarde de imaginación, ya que resulta imposible apreciar directamente estos detalles en una molécula: el ADN es una molécula demasiado estrecha como para que se la pueda ver con un microscopio convencional, e incluso los electrónicos más potentes la muestran simplemente cual una cinta oscura.
Crick y Watson necesitaban radiación de longitud de onda suficientemente corta para que penetrara entre los átomos de la molécula. Los rayos X fueron la solución.

Un esquema del ADN que muestra los apareamientos de los «dientes» que transportan el mensaje genético, así como la doble hélice del «esqueleto».
Sin embargo, las técnicas de difracción de rayos X no dan fotografías claras de la molécula, sino una especie de fotografía que hay que interpretar; algo parecido a lo que sucede con un holograma, un conjunto de puntos aparentemente sin significado hasta que se lo «interpreta» iluminándolo con un haz de láser. Watson y Crick se adelantaron en poco a sus colegas a descifrar los resultados de los rayos X sobre el ADN y su hazaña mereció los laureles de la fama, incluyendo un premio Nobel.
Una buena analogía para el ADN es la de una cremallera retorcida enormemente larga. Las tiras de tela de ambos lados que forman los dos esqueletos que soportan los clientes se componen de grupos de átomos que se repiten. Estos grupos son, en realidad, pequeñas moléculas idénticas que se han agrupado por millones para formar los largos esqueletos; cada grupo es una combinación de átomos de fósforo y oxígeno (fosfato) con una molécula orgánica llamada desoxirribosa. Esta última sustancia es conocida como azúcar, porque químicamente es muy parecida al azúcar «ordinario», sacarosa para los químicos, y a otros tipos de azúcares como, por ejemplo, la glucosa. Así pues, estos grupos fosfato-azúcar se repiten una y otra vez formando un esqueleto estable a cada lado de la cremallera.
El contenido de la información es transmitido por los dientes, de los que existen cuatro tipos diferentes; cada uno agrupa a aproximadamente diez átomos y, al igual que muchas moléculas y grupos biológicos, responden a los poco eufónicos nombres de adenina, citosina, guanina y timina. Los bioquímicos los abrevian A, C, G y T. (Téngase en cuenta que estos símbolos no son símbolos químicos atómicos: C representa aquí un grupo de doce átomos que constituyen la citosina. Generalmente, el contexto suele dejar en claro el tipo de abreviaturas a que nos refiramos.)
Aunque estos cuatro tipos de grupos unen ambos esqueletos, la analogía con la cremallera no es exacta porque los clientes no encajan unos en otros, sino que se unen por los extremos y, además, con fuertes preferencias. Un diente de adenina de un esqueleto sólo se unirá con un cliente de timina del otro; y la citosina, sólo con la guanina. Existen por tanto dos tipos de uniones, A—T y C—G; y a causa de esta complementariedad, una secuencia por ejemplo AACGT de uno de los esqueletos debe unirse con la secuencia TTGAC del otro.
De esta forma puede desvelarse uno de los misterios del ADN, a saber: cómo se transmiten las copias exactas a las células hijas. Cuando una célula está a punto de dividirse, cada molécula de ADN del núcleo comienza a abrirse.
En cuanto cada diente queda al descubierto, recoge a un compañero de entre los dientes «sueltos» que flotan en el núcleo; si, por ejemplo, el descubierto es un T, recogerá a un A suelto; pero cada diente suelto estaba ligado a un segmento de esqueleto. Cuando se alinean a lo largo del ADN abierto, unas pequeñas y activas moléculas denominadas enzimas sueldan entre sí a todos los segmentos de esqueleto, constituyendo de esta forma una nueva mitad continua que complementa a cada una de las semicremalleras existentes. Resultan así dos nuevas cremalleras por cada una de las antiguas. Además, no hay lugar a error, pues cada diente se sitúa sobre un compañero determinado ya que la mitad de la nueva cremallera ha de ser un complemento exacto de la mitad antigua que se forma enfrente. Así, una única molécula es perfectamente apta para transmitir las instrucciones de la vida.
Pero ¿cómo se transmiten las instrucciones? La respuesta parece demasiado sencilla para ser cierta. El código de la vida es simplemente el orden en que se presentan los diferentes tipos de dientes en cada esqueleto. Cada grupo de tres dientes sucesivos incluye un mensaje particular; por ejemplo, la secuencia AAT indica que la célula es un tanto diferente de la ATA. La decodificación efectiva tiene lugar en cuerpos especiales situados en la parte de la célula exterior al núcleo, y la célula ha desarrollado una hábil manera de enviar sus instrucciones desde el ADN a los centros decodificadores, mientras este último permanece seguro dentro del núcleo: lo que hace es enviar un ácido mensajero.
El mensajero es una molécula muy parecida al ADN, excepto en cuanto que su esqueleto contiene un azúcar ligeramente diferente, ribosa, en lugar de desoxirribosa.

El mensaje genético del ADN es extraído del núcleo de la célula por el ARN mensajero. En el «centro de decodificación», un ribosoma, las moléculas de proteína se agrupan por intermedio de moléculas de ARN de transferencia, que aparea las secuencias apropiadas sobre el ARN mensajero: cada tipo de ARN de transferencia lleva un aminoácido diferente.
Se denomina ácido ribonucleico o ARN (existe asimismo otra pequeña diferencia en la constitución química de los «dientes», pero podemos ignorarla aquí). Para la salida de un mensaje, se abre un pequeño segmento del «cianotipo» original de ADN que atrae a los dientes complementarios que forman parte del esqueleto de ribosa. Estos están soldados en una porción del ARN «mensajero» cuyos clientes se aparean con una minúscula parte de la larga molécula de ADN. Cuando el mensaje está completo, el ARN mensajero se separa del ADN y se dirige hacia la parte exterior de la célula, mientras que el ADN vuelve a cerrar ese pequeño segmento, salvaguardando su información vital.
§. La decodificación del mensaje de la vida
Dispersos en la parte exterior de la célula existen miles de centros decodificadores (ribosomas). Sin embargo, antes de que podamos comprender el proceso de decodificación, debemos referirnos a la segunda clase de moléculas mayores (después de los ácidos nucleicos ADN y ARN) esenciales para la vida.
Forman este grupo las proteínas, también largas moléculas compuestas de muchas unidades menores, pero aquí acaba su parecido con el ADN. Las unidades de una proteína están simplemente ensartadas por los extremos, y muestran la sencilla apariencia de una ristra de salchichas en contraposición con la complicada estructura de esqueleto y dientes del ADN.
Las «salchichas» individuales se diferencian asimismo de las unidades que constituyen los ácidos nucleicos. Se las denomina aminoácidos, y son grupos orgánicos formados principalmente por átomos de carbono e hidrógeno, pero con átomos de oxígeno y nitrógeno próximos a un extremo. Estos últimos son vitales, ya que aseguran que los enlaces químicos entre los aminoácidos que se agrupan en proteínas sean resistentes, pero no tan fuertes como para no ser susceptibles de cambios. (Incidentalmente, el término «ácido» del aminoácido y del ácido nucleico no significa que éstos sean sustancias particularmente corrosivas; sólo denota una cierta similitud química con los ácidos fuertes.)
Las células vivas contienen únicamente veinte clases de aminoácidos, pero cuando éstos están ensartados en órdenes diferentes y en cadenas de distintas longitudes, el número total posible de proteínas es inmenso. Virtualmente, todos los procesos vitales son llevados a cabo por las proteínas, que constituyen el vasto ejército de voluntariosos trabajadores que siguen las instrucciones de las moléculas de ADN del núcleo. Si observamos la constitución del cuerpo humano, no en términos de átomos sino de tipos de moléculas, nos encontramos con la sorpresa de que la mayoría de sus moléculas son de agua (hay que atribuir al agua las tres cuartas partes del peso de nuestro cuerpo; y como la mayor parte del peso de una molécula de agua se debe a su átomo de oxígeno, la abundancia de agua origina que el oxígeno contribuya mayoritariamente al peso, del cuerpo). La inmensa mayoría de las moléculas restantes son proteínas.
Las proteínas (junto con moléculas de grasa) constituyen el sólido recubrimiento exterior de las células, en el que se incluye la materia córnea que se acumula en el pelo y en las uñas. Las reacciones de la vida se deben a reacciones de cadenas de proteínas más pequeñas, que flotan en el interior acuoso de las células. Además de reaccionar entre sí, las proteínas tienen mucha injerencia en el control y promoción de reacciones entre otras moléculas. Cuando juegan este papel de mediadores entre dos moléculas reacias distintas (el proceso equivalente a la catálisis en química inorgánica), a las proteínas se las denomina enzimas. Una enzima suelda el esqueleto de las moléculas que constituyen el ADN; y prácticamente cualquier reacción química de la célula es auxiliada por una enzima especialmente adaptada a ese trabajo.
Los mensajes desde el ADN central se relacionan específicamente con la manufacturación de proteínas a partir del material en bruto de aminoácidos de la célula. El mensaje puede ser: reúnanse algunos aminoácidos en tal y tal orden; y el resultado que se obtiene es una proteína determinada, capaz de realizar una misión específica en la célula. Tal como se describió anteriormente, la base del código de ADN son grupos sucesivos de tres «dientes». El mensaje se transmite en forma de dientes complementarios mediante el ARN mensajero, y cuando llega al centro de decodificación es descifrado de una forma sencilla: cada conjunto de tres dientes es el código de un determinado aminoácido; así, la secuencia GCT (en el ADN original que pasa a ser GGA en el ARN mensajero) significa «el siguiente aminoácido que hay que añadir es glicina»; GTA significa «añadir histidina». El mensaje comienza con una secuencia «inicial», TAC o CAC, y acaba con una «final», ATT o ATC. (Existen en la actualidad 64 formas posibles de disponer cuatro tipos diferentes de dientes en tríos, y únicamente 20 aminoácidos, por lo que la célula ha incorporado «sinónimos»: por ejemplo, los códigos GTA y GTG de la histidina.)
Los trabajadores del centro de decodificación son cortas unidades en forma de L de un tercer tipo de ácido nucleico, llamado ARN «de transferencia». El extremo del trazo largo de esta molécula en L tiene tres dientes para que se apareen con los del ARN mensajero, y el otro extremo tiene una estructura química que enlaza al aminoácido apropiado con su conjunto de dientes descubiertos. El ARN mensajero desliza lentamente su larga molécula por el pequeño centro de decodificación, y a medida que pasa, el ARN de transferencia apropiado identifica cada grupo de tres dientes y se aparea temporalmente a ellos. El aminoácido del otro extremo se suelda entonces a la cadena de proteína en formación por medio de enzimas especializadas. El ARN mensajero continúa circulando, y el ARN de transferencia, ya despojado de su aminoácido, es desechado. A continuación, otro se aparea con los tres dientes siguientes y libera el siguiente aminoácido. Así se, transmite con seguridad el mensaje del núcleo y se fabrica la proteína requerida.
Los científicos piensan que con el descifrado del código celular se comprende ya el proceso vital; sin embargo, las reacciones implicadas son tan complejas que la descripción completa es aún un lejano sueño. Recientes investigaciones han mostrado, por ejemplo, que se, omiten porciones considerables del mensaje del ADN cuando está reunido con el ARN mensajero. ¿Cómo «sabe» las partes que ha de omitir? Incluso en este correcto proceso de copia deben tener lugar reacciones. No obstante, los científicos conocen ahora dónde y cómo se almacena la información de la vida, cómo se transmite fielmente a las células hijas y el modo en que la célula traduce el código en proteínas.
Según el punto de vista que se adopte, algunas de las implicaciones son casi milagrosas, o bien desastrosas. Es posible trocear el ADN de las células y reagruparlo a fin de alterar el mensaje que transmite, así como insertar las porciones de ADN de una célula en las de otra. Estas técnicas de «ingeniería genética» (un gen es la información total heredada transmitida por una porción de ADN) abren posibilidades tanto al bien como al mal. Si se insertase en una célula que se reproduce rápidamente una porción de ADN que ordene la producción de una proteína útil, por ejemplo la insulina, esencial para los diabéticos, se obtendría en poco tiempo un depósito rejileto de células de insulina. A un nivel aún más profundo, cuidadosos experimentos sobre la alteración del ADN podrían suministrarnos más información acerca de la herencia y ayudarnos a comprender las enfermedades hereditarias.
Sin embargo, también existen peligros.

El azúcar es una fuente potencial de energía que se libera al arder en presencia de oxígeno. Las células de los animales «queman» azúcar poco a poco en mitocondrias de intrincada estructura, a fin de suministrar esta energía a la temperatura del cuerpo.
Muchas bacterias son inocuas, y algunas viven tranquilamente en nuestro sistema digestivo, como la favorita de los ingenieros genéticos, la Eschicheria coli. Supongamos que un experimentador alterase el ADN de una única célula de E. coli de forma que llegue a hacerse letalmente tóxica, y que esta célula escapase del lugar donde está confinada; podría entonces multiplicarse indefinidamente, donando su fatal característica a su descendencia. En este caso extremo, el espantoso resultado de un descuido momentáneo en el laboratorio podría ser una epidemia de una enfermedad sin cura conocida. A la vista de estos peligros se han introducido, en los últimos años, nuevas medidas de seguridad en todos los laboratorios de genética del mundo; y la preocupada opinión pública comienza a ejercer presión sobre los científicos implicados en este tipo de investigación.
§. La alimentación de la célula
Una célula viva no puede funcionar sin aporte de energía. Al considerar la forma en que una célula recibe su energía, descubrimos la gran división que separa la vida de los animales y la de las plantas, todos los demás procesos celulares la reproducción del ADN, la síntesis de proteínas y su código asociado son idénticos en todas las formas de vida, desde la de la bacteria unicelular hasta la de los seres humanos, desde la de los elefantes hasta la de la planta de ruibarbo común. Sin embargo, las plantas y los animales reciben su energía de formas diferentes.
La energía de las células de los animales procede de la combustión del azúcar. La energía que utilizamos proviene principalmente de sustancias químicas, como el azúcar ordinario, esté o no incluido en nuestra dieta, o de la descomposición de moléculas de grasa en la célula. Y, realmente, se trata de una combustión. Calentemos un terrón de azúcar en una llama de gas: después de fundirse y carbonizarse se habrá consumido completamente, transformándose en gas dióxido de carbono y vapor de agua. Una célula animal absorbe azúcar y oxígeno del exterior, convirtiéndolos también en dióxido de carbono y agua y liberando energía, aunque de una forma menos espectacular.
La diferencia entre quemar azúcar en una llama de gas y en nuestras células es sólo una cuestión de temperatura; pero, en cualquier caso, la combustión del azúcar suministra energía. Una taza de azúcar que se encuentre en el aire a la temperatura del cuerpo no se convierte espontáneamente en dióxido de carbono y agua, ya que se necesita un cierto aporte de energía para que se inicie la reacción. Esto lo podría lograr una llama, algo innecesario en nosotros porque nuestras células disponen de enzimas que «queman» el azúcar a la relativamente baja temperatura de nuestro cuerpo. Las enzimas controlan y facilitan una serie completa de reacciones por medio de las cuales el azúcar se descompone sucesivamente en moléculas más sencillas, antes de finalizar transformándose en dióxido de carbono y agua.
Estas reacciones tienen lugar en el interior de cavidades tubulares, una especie de «centrales eléctricas» situadas en la parte exterior de la célula. En las etapas finales de la combustión del azúcar, la membrana que encierra este pequeño cuerpo se carga; la corriente eléctrica total que carga todas las «centrales eléctricas» de nuestros cuerpos sería suficiente para iluminar ininterrumpidamente una bombilla de cien vatios. Esta energía se almacena en forma de diferencia de voltaje entre el interior y el exterior de las centrales eléctricas, de forma análoga a la diferencia de tensión que existe entre los bornes de una batería. Sin embargo, la célula no puede emplear la energía eléctrica directamente; necesita un «portador» químico para transportarla dondequiera que la célula la necesite.
La molécula que utiliza es el ATP (trifosfato de adenosina), en esencia uno de los dientes sueltos que pueden unirse a una cadena de ARN; el cliente propiamente dicho es adenina (A) y porta un grupo fosfato ribosa. Existen en el ATP otros dos grupos de fosfatos, formando un total de tres. El grupo de fosfato final está sólo ligeramente enlazado, y cuando se «estimula» la molécula de ATP, ésta liberará dicho grupo acompañado de energía. La molécula que lo ha liberado retrocede a las centrales eléctricas, en donde la energía eléctrica repone otro grupo de fosfato; y así, el ATP reconstituido puede vagar por la célula hasta que se requiera su energía.
Las células de las plantas también utilizan el ATP como portador de energía, pero lo hacen de manera opuesta. Toman dióxido de carbono y agua, y a partir de ellos forman azúcares y expulsan oxígeno. Las células de las plantas deben enfrentarse a la ardua tarea de tomar energía del exterior, obteniéndola a partir de la luz solar por mecho del casi milagroso proceso de la fotosíntesis. Las pequeñas centrales eléctricas de las células de las plantas han de ser evidentemente distintas de las de las células de los animales: una clara diferencia se manifiesta en el color, pues son las centrales eléctricas verdes de las células las que otorgan a las plantas su color característico. Una molécula llamada clorofila absorbe fotones de luz roja al comienzo del proceso de fotosíntesis, y la luz reflejada, luz blanca sin rojo, parece verde.
Cada fotón de luz expulsa un electrón de una molécula de clorofila; y éste tiene suficiente energía como para desencadenar una serie de reacciones cuyo resultado final es cargar la membrana exterior de la central eléctrica. Esta energía eléctrica es la empleada nuevamente para reagrupar las moléculas de ATP. Tanto en las células de las plantas como en las de los animales, una fuente de energía carga una membrana, y a partir de este momento los procesos de producción y transporte de energía son los mismos.
Así pues, pese a que los animales tomen los «productos de desecho» de las plantas, oxígeno y azúcares, y las células de las plantas se desarrollen a partir de los desechos de los animales, dióxido de carbono y agua, existe muy poca diferencia en sus mecanismos internos celulares, es decir en los «cianotipos» de ADN, en el proceso de decodificación, en los tipos de aminoácidos utilizados en la síntesis de las proteínas, o bien en las etapas posteriores de producción de energía.
Existe una unidad asombrosa entre las formas de vida terrestre.
§. El lugar de la vida en el Universo
La complejidad del proceso de la vida es algo asombroso. En las secciones anteriores hemos visto apenas parte de las complicadas moléculas y de las reacciones químicas que las eslabonan y que confieren a la vida sus propiedades únicas. Con todo, no es tan importante la complejidad de una célula viva como su organización. Cuando se observa al microscopio un bloque de granito, aparece como una mezcla compleja de diminutos cristales, pero carentes de organización; podríamos reordenarlos, y la roca seguiría siendo granito. Sin embargo, si alterásemos la estructura de una célula viva, jamás seríamos capaces de devolverle sus reacciones vitales. En las criaturas pluricelulares, como el hombre, la organización llega a tales extremos que, por ejemplo, la capacidad de pensar nos está dada por la interconexión de diez mil millones de células nerviosas de nuestros cerebros.
Por ello, aun cuando podamos explicar los procesos vitales en términos de partículas fundamentales y de la fuerza electromagnética, y aunque asimismo mostremos como lo haremos en la sección siguiente, el modo en que la vida puede aparecer en la evolución astronómica del Universo, ella constituye realmente una faceta aparte del mismo. Además de la investigación de lo muy pequeño y de lo muy grande, existe una frontera del conocimiento vinculada con la noción más abstracta del desarrollo de la organización. Resulta muy fácil dejarse impresionar por los tamaños extremos, grande o pequeño; pero esto puede ser engañoso. El Sol es un objeto enorme y poderoso, pero realmente muy simple: un astrónomo podría consignar todos los datos esenciales acerca del Sol en una página, y con esta información (teóricamente) podría construir una estrella idéntica. Sin embargo, la información necesaria para obtener una célula microscópica llenaría varios tomos de una enciclopedia. Sin falta de modestia, podemos afirmar que los objetos más maravillosos del Universo no son ni los quásares, ni los agujeros negros, ni los quarks, sino nosotros mismos.
Con esta perspectiva, retornaremos a nuestros orígenes: al comienzo de la vida sobre la Tierra.
§. Vida a partir de la no vida
La superficie de la Tierra antigua era una imagen del Infierno. Hace unos 4.000 millones de años (600 millones después de comenzar a formarse), la Tierra había alcanzado aproximadamente su tamaño actual, pero aparte de esto nos resultaría irreconocible. Enormes rocas caían desde el cielo, al ser atraídos por la Tierra los fragmentos finales de los restos del espacio próximos a ella. Sus impactos horadaban enormes cráteres de cientos de kilómetros de extensión. La radiactividad calentaba las rocas terrestres dando lugar a enormes mares de lava fundida al rojo, que fluían y se esparcían por la superficie; mientras tanto, los nocivos gases de los volcanes cubrían la Tierra con una espesa atmósfera repleta de nubes y desgarrada por continuas tempestades. Acto seguido, llegó la lluvia. La inmensa cantidad de vapor de agua expulsado por los volcanes se condensó, y cayó como un continuo aguacero sobre la ardiente superficie terrestre, enfriándola, hasta acumularse finalmente en extensos océanos.
No era aquél la clase de lugar que escogeríamos para pasar unas vacaciones; sin embargo, tan inhóspitas condiciones fueron las idóneas para nuestros más remotos antepasados. La vida debe de haberse iniciado a partir de la no vida, y en las aparentemente benignas condiciones actuales no ha lugar para este tipo de génesis. Si se expusieran a la atmósfera de hoy, rica en oxígeno, las moléculas orgánicas complejas que se encuentran en nuestras células, acabarían descomponiéndose en dióxido de carbono en vez de amalgamarse para producir organismos vivos. Cualquiera que haya contemplado un incendio forestal sabe muy bien lo inestables que son las sustancias químicas de la vida en presencia de oxígeno. Después de todo, los animales obtienen su energía a partir de la lenta combustión de los compuestos orgánicos por aspiración de oxígeno; la triste mirada de un hombre hambriento es, literalmente, el resultado de la combustión de las moléculas de su cuerpo en un intento desesperado por abastecerse de energía.
Por otra parte, la primitiva atmósfera terrestre carecía de oxígeno libre, mientras que era rica en gases volcánicos: dióxido de carbono, monóxido de carbono, sulfuro de hidrógeno, amoniaco y cianuro de hidrógeno. Aunque estos gases son venenosos para nosotros, fueron el hálito vital de los primeros seres vivos. En el atroz entorno de la primitiva Tierra, estos compuestos reaccionaron entre sí creando nuevas moléculas, sustancias químicas orgánicas mayores y más complejas que los gases originales.

El primer estadio del crecimiento de una criatura compleja: la célula fertilizada se divide en dos. Este óvulo de rata se ha dividido a los dos días de ser fertilizado, y una división posterior transformara estas células en un ser vivo, una rata que nacerá en solo 20 días.
Semejantes ideas no constituyen sólo una elegante teoría. En un famoso experimento realizado en 1953 por el químico americano Stanley Miller, éste preparó una mezcla de gases similares a los de la antigua atmósfera terrestre y los sometió a una descarga de 60.000 voltios durante una semana, es decir, a un relámpago artificial. Para asombro de todos, el líquido que quedó en el fondo del matraz era un caldo rico en compuestos orgánicos que incluían cuatro aminoácidos. Espoleados por los resultados de Miller, otros científicos investigaron distintas mezclas de gases sometidas a diferentes perturbaciones, similares a las que deberían haber tenido lugar en la primitiva atmósfera terrestre. Estas incluían ondas de choque («estampidos sónicos» de los asteroides y meteoritos que caían), radiación ultravioleta (del Sol) o, simplemente, intenso calor (de las rocas fundidas). Todos estos experimentos produjeron las moléculas más simples de la vida, y, además, en profusión. El «océano prebiótico» del fondo de los matraces del laboratorio contiene todos los aminoácidos necesarios para la formación de proteínas, las unidades individuales a partir de las que se forman el ADN y el ARN; contiene asimismo otros compuestos, algunos de los cuales se encuentran en las células actuales; y otros más que, evidentemente, no han participado en el proceso de la vida.
Así pues, la producción de pequeñas moléculas orgánicas en la antigua Tierra parece casi inevitable. Aun cuando en la década de 1950 esto constituyó una sorpresa, la astronomía moderna nos muestra que las moléculas orgánicas son sorprendentemente comunes en el Universo. Los radioastrónomos han detectado señales emitidas por varias moléculas orgánicas a las longitudes de onda de radio desde distantes nubes de gas. Hasta ahora se han identificado en el espacio unas cincuenta moléculas diferentes, y como ninguna es muy compleja, su mera existencia muestra que la química orgánica sigue avanzando en las nubes de gas interestelares, algo insospechable hace veinte años. Estas reacciones tienen lugar, probablemente, en las superficies de minúsculos granos de polvo de la nube; y existe la posibilidad de que puedan existir moléculas más complejas que las encontradas en la superficie de los granos.
El material hereditario humano está contenido en los 46 cromosomas de cada núcleo celular (la burbuja negra es el núcleo de otra célula). Cada célula reproductora contiene únicamente 23, por lo que un óvulo fertilizado se completa con la mitad del de cada progenitor. A esto se debe la variedad de la descendencia.
Los astrónomos han encontrado también moléculas orgánicas en algunos de los meteoritos caídos a la Tierra. Como vimos en un capítulo previo, las «condrilas carbonáceas» constituyen el material más antiguo del sistema solar, inalterado durante 4.600 millones de años. Tales meteoritos han sido investigados en detalle sólo recientemente, ya que, aunque son muy comunes en el espacio, sólo unos cuantos sobreviven al ardiente paso a través de la atmósfera terrestre. Una vez que aterrizan, estos restos se desgastan rápidamente, a menos que se les vea caer y se les traslade inmediatamente al laboratorio.
El último domingo de setiembre de 1969, una luz brillante relampagueó en el cielo mañanero cercano a Melbourne, Australia. El meteorito explotó sobre la pequeña ciudad de Murchison con un estampido semejante al trueno, y llovieron fragmentos de roca. Fue recogido, y se analizaron un total de 82 kilogramos; entre el porcentaje de compuestos de carbono, los científicos encontraron varios tipos de aminoácidos, los componentes de las proteínas. De una u otra forma, las unidades básicas de la vida se habían reunido en el espacio durante la formación del sistema solar, o incluso antes, en la nube de gas de la que finalmente se condensaron los planetas.
No resulta difícil comprender cómo pudieron haber aparecido sobre la Tierra moléculas orgánicas de la complejidad de los aminoácidos, o de los grupos que constituyen los ácidos nucleicos. Algunas pudieron haber sobrevivido a la caída de los meteoritos carbonáceos, mientras que enormes cantidades deben haberse sintetizado a partir de la antigua atmósfera volcánica. Según el bioquímico Leslic Orgel, los antiguos océanos fueron un «caldo prebiótico» con la consistencia de un ligero caldo de pollo, que hubiera podido oler a laboratorio químico.
La siguiente etapa de la historia de la vida es la más oscura. Durante 500 millones de años, estas moléculas simples debieron agruparse para constituir el ADN, el ARN y las proteínas; pero esto es apenas una parte de la historia. En él laboratorio pueden formarse fácilmente moléculas grandes a partir de otras más pequeñas, pero el resultado no es la vida: también han de desarrollarse reacciones químicas interdependientes. Las enzimas (proteínas «abren» al ADN con el fin de permitirle reproducirse y exponer su mensaje a la decodificación; y, recíprocamente, este mensaje constituye una planificación para la producción de proteínas. De alguna forma, una serie de reacciones entre los ácidos nucleicos simples y las proteínas simples deben haber incrementado gradualmente su complejidad, originándose en el proceso moléculas mayores y más complejas: el proceso de la vida se desarrolla por sus propios medios; y el mecanismo de producción de energía basado en las enzimas debe también haberse desarrollado simultáneamente. Había algo disponible para todas estas reacciones: en el abundante medio del caldo prebiótico, generador de vida, existía una fuente de materiales puros y de «combustible».
Las células de fósiles más antiguos fueron halladas en los cuarzos de Fig Tree, en Suazilandia, pero son sólo los más antiguos que han dejado huellas, cosa que no sucede con la mayoría de los organismos unicelulares). Fechados hace 3.400 millones de años, estos organismos simples muestran que la vida comenzó muy pronto en la historia de la Tierra. Si reducimos la escala del pasado de la Tierra a sólo 46 años en vez de sus 4.600 millones, podemos decir que pasó su primera infancia bajo un continuo bombardeo de rocas procedentes del espacio; pero a los siete años se habría formado la corteza de la Tierra, y habrían comenzado a constituirse moléculas orgánicas simples en la atmósfera. En su octavo cumpleaños, a lo sumo, habrían llegado las lluvias y los océanos inundaron la Tierra; las rocas más antiguas conocidas datan de esta época y muestran signos de la acción del agua. En los cuatro años siguientes se habrían formado las sustancias químicas de la vida en las primeras células independientes, cada una con un sistema químico enormemente complicado. Por consiguiente, la Tierra guardó formas de vida desde su temprana adolescencia hasta su actual edad adulta, es decir durante aproximadamente 34 años de un periodo de vida de 46.
Muy pronto, estas células primitivas se enfrentaron a una crisis. Después de haber consumido ávidamente los ingredientes orgánicos del caldo que les rodeaba, no era obvio que tuviesen otra fuente de alimentación. Únicamente ofrecía alguna esperanza el dióxido de carbono de la atmósfera y el disuelto en el mar. El desarrollo de la fotosíntesis salvó a las células vivas de devorarse entre sí hasta la extinción, y por fin pudieron utilizar la luz del Sol para transformar dióxido de carbono y agua en moléculas orgánicas, asegurándose así una fuente de energía permanente.
Sin embargo, el producto secundario de la fotosíntesis es el oxígeno, y a lo largo de miles de millones de años este «residuo» de las células de las plantas reemplazó gradualmente al dióxido de carbono de la atmósfera, haciendo que ésta se alterara lentamente. El espeso velo inicial de dióxido de carbono había disminuido de espesor al disolverse en los mares y al reaccionar con las rocas descubiertas; ahora, el resto habría de descomponerse por acción de las células de las plantas. El resultado total de la fotosíntesis consistió en situar los átomos de carbono del gas en las criaturas vivas, dejando el oxígeno en la atmósfera. Puesto que el oxígeno es un gas reactivo, pronto descompuso al resto de los gases nocivos que quedaban de la primitiva atmósfera volcánica. El nitrógeno, relativamente inerte, constituyó una excepción, ya que aunque se encontraba en cantidades pequeñas comparadas con la abrumadora cantidad de dióxido de carbono, no se disolvió en el mismo grado en los océanos ni reaccionó con las rocas descubiertas; ni tampoco con el oxígeno, el nuevo ingrediente atmosférico. Guando los demás gases se agotaron y nuestra atmósfera disminuyó su espesor, el nitrógeno detuvo este proceso y acabó siendo el gas más abundante en el aire hoy en día, del que constituye casi cuatro de cada cinco moléculas. Una de las cinco es de oxígeno; mientras que el argón, resultante de la desintegración del potasio radiactivo, se halla en tercer lugar, constituyendo el 1 % del aire. El dióxido de carbono forma en la actualidad sólo una molécula de cada tres mil de la atmósfera terrestre, contrastando fuertemente con las atmósferas primitivas de Venus y Marte, compuestas todavía casi por completo de este gas.
Al desaparecer el dióxido de carbono del aire, las células de las plantas hubieron de enfrentarse a una segunda crisis, la asfixia por su propio residuo de oxígeno. Sin embargo, las células animales restablecieron el equilibrio, pues consumieron las células de las plantas «quemando» su oxígeno para restituir a la atmósfera el dióxido de carbono. Aún hoy se mantiene este equilibrio, ya que las plantas absorben el dióxido de carbono que exhalamos, y nosotros ingerimos sus compuestos de carbono y respiramos su residuo de oxígeno.
El oxígeno de la atmósfera produjo otra gran revolución en la vida, pues la extraña molécula de tres átomos de oxígeno, el ozono, formó una capa en la parte superior de la atmósfera que filtró la nociva longitud de onda corta ultravioleta del Sol. No había ya necesidad de servirse de la protección del agua del mar como pantalla, y la vida emergió sobre la Tierra. A partir de este momento, las plantas y los animales no fueron ya, durante mucho tiempo más, células simples.
§. Hacia lo mejor
Evidentemente, la vida ha dado un gran paso adelante desde el día en que todos los seres vivos eran células microscópicas que nadaban en los océanos. Fósiles de plantas y animales de complejidad creciente comienzan a aparecer en rocas de hace unos cuantos cientos de millones de años. Una vez que las células hubieron desarrollado la habilidad de agruparse en tanto que organismo pluricelular, apareció sobre la Tierra una enorme variedad de diferentes clases de vida: animales, desde los insectos hasta los dinosaurios; y plantas como los gigantescos «helechos» del carbonífero, cuyos restos fósiles se desentierran en la actualidad en forma de carbón.
Pero ¿cómo pudo la vida haber seguido caminos tan diversos cuando la ingeniosa «apertura» del ADN parecía garantizar que todas las células hijas serían exactamente como sus padres? La respuesta se fundamenta en primer término en la mutación. La radiación procedente del espacio, o de los elementos radiactivos del suelo, ocasionalmente desorganiza y cambia el ADN de una célula, alterando sutilmente su mensaje. Experimentos como los realizados con la mosca del vinagre de rápida reproducción, Drosophila melanogaster, y otras especies, muestran que una mutación sólo se presenta una vez por cada millón de copias de ADN, lo que no es un mal ritmo si, por ejemplo, pensamos en términos de copias de discos de gramófono. Además, como cada ADN de la célula transmite tanta información como la contenida en varios tomos de una enciclopedia, el hecho equivale a reproducir una estantería de libros un millón de veces con únicamente un error.
La inmensa mayoría de las mutaciones son perjudiciales: el ADN alterado no puede controlar correctamente a la célula, y ésta pronto muere. Sin embargo, existe la excepción, que dota a la célula de alguna ventaja sobre sus antepasados y parientes: medrará a sus expensas y, finalmente, sus descendientes sobrevivirán allí donde no podía hacerlo el tipo de célula original. El desarrollo de la fotosíntesis en las células debe haber sido resultado de varias mutaciones ventajosas que produjeron, en último término, células que pudieron sobrevivir cuando se hubo consumido el caldo prebiótico.
Los organismos vivos de la Tierra compiten continuamente por alimento y espacio vital: es ésta la segunda fuerza impulsora de la proliferación de formas de vida. En la lucha por la supervivencia, es más probable cute una criatura que ha heredado una característica útil alcance la edad de la reproducción, y sus descendientes, que poseen esta misma característica, reemplacen gradualmente al tipo original. Así pues, las clases o especies de vida en nuestro planeta cambian continuamente. Nuestras especies actuales de perros, elefantes o velloritas no son más permanentes que las de los dinosaurios o los helechos gigantes del carbonífero.
Charles Darwin fue el primero en enunciar esta idea de la evolución por selección natural del más apto en su famoso y controvertido libro de 1859, El origen de las especies. Aunque a nosotros hoy nos pueda parecer obvia, su herética idea de que las especies de plantas y animales no habían sido establecidas por Dios en la Creación le enfrentó con las ideas de la Iglesia, que también eran mantenidas por los científicos ortodoxos de entonces. El propio Darwin no había deseado iniciar una controversia, mas la amarga disputa religiosa y científica continuó durante décadas. Le fueron dispensados honores en todo el mundo, pero el único honor que recibió del Gobierno de la Reina Victoria fue el entierro en la Abadía de Westminster.
Por proceso de evolución, la vida surgió desde las células simples hasta llegar a las complicadas formas de vida actual. Hace unos centenares de millones de años - época muy reciente en la historia de la Tierra, algunas células desarrollaron la sutileza de vivir en común constituyendo colonias permanentes. Fue ventajoso para estas células emprender tareas especializadas: en los animales, unas digerían los alimentos, otras transportaban las sustancias químicas por la colonia -o «cuerpo», como ahora lo llamamos—; y otras más emprendieron la tarca de la locomoción, mientras que algunas se especializaron en la transmisión de señales eléctricas. Se desarrolló un grupo especial de células para llevar a cabo la tarea de la reproducción.
Durante esta extensa etapa de la evolución aparecieron, en la escena de la vida, dos factores nuevos y fundamentales. Los organismos pluricelulares inventaron el envejecimiento y el sexo. Las antiguas criaturas unicelulares eran, efectivamente, inmortales: se mantenían dividiéndose en pares de células hijas idénticas (salvo alguna ocasional mutación; y, a menos que fuera devorada o le fallara el alimento, la célula original «sobrevivía» indefinidamente en la forma de su propia prole. Las células simples carecen de edad y se reproducen de la forma más sencilla posible, dividiéndose.
Sin embargo, los organismos pluricelulares enfrentan un gran problema con la reproducción. No pueden dividir cada célula de su cuerpo en dos, ya que entonces serían dos criaturas mezcladas. Así pues, tanto en los animales como en las plantas, parte del organismo está dedicado a la reproducción. Desde la perspectiva de la Naturaleza, éste es el grupo de células más importante del cuerpo: mediante él heredamos la información genética en el nacimiento, y la transmitimos a las siguientes generaciones. El resto del cuerpo es sólo un intrincado sistema dedicado a salvaguardar y nutrir a los órganos sexuales hasta que hayan madurado suficientemente como para crear futuras generaciones. Y desde este punto de vista, el envejecimiento es parte muy importante de la evolución. Cada nuevo organismo comienza como una célula simple, y debe desarrollarse hasta la edad adulta dividiéndose la célula inicial una y otra vez para constituir la nueva «colonia». Sin embargo, si todos los adultos de las especies fueran inmortales, pronto crecería su número hasta el punto de monopolizar las fuentes de alimento, y las nuevas generaciones no sobrepasarían la infancia. Por el proceso de evolución, los adultos sólo son necesarios durante el tiempo en que se reproducen; después deben morir de muerte natural y dejar la escena libre para sus descendientes. De esta forma evoluciona el aún poco conocido proceso de la vejez.
Cada réplica se desarrolla a partir de una célula simple producida por los fundamentales órganos sexuales de los padres.

Cuando los seres pluricelulares evolucionan, las células adquieren Junciones especializadas. Una célula nerviosa, que aquí aparece teñida y muy aumentada, tiene largos filamentos que transportan señales eléctricas hacia y desde el cerebro. El propio cerebro es una vasta red de células nerviosas interrelacionadas.
No obstante, la diversidad de vida puede acrecentarse mezclándose el ADN de los padres, y el sutil proceso de la reproducción sexual se desarrolla de modo que las células de ambos padres se unen y se combinan para dar lugar a una única célula con caracteres mezclados. La «información» del ADN de cada padre - sea el color de los ojos o la altura del tallo de una planta tiene que competir en el núcleo de la nueva célula. A la ciencia de la genética le concierne el averiguar por qué se acaba seleccionando una unidad de información, un gen, en vez de otro.
Con el advenimiento de los organismos pluricelulares, primero en el mar y luego en tierra firme, quedaba presta la escena para un enorme incremento del número de especies de vida al ritmo marcado por la evolución. Todo esto es muy reciente en la larga vida de la Tierra. En nuestra escala de tiempo reducida a 46, años, las primeras células se formaron cuando la Tierra tenía unos 12; pero las formas de vida pluricelular no aparecieron hasta hace unos pocos «años». A los 42 aparecieron las plantas y los animales; y hace sólo un año que los dinosaurios mandaban en la Tierra y que surgieron las primeras plantas con flores. Hace un par de semanas, simios sin pelo comenzaron a utilizar las herramientas y el fuego; y en los últimos segundos han adquirido la tecnología para abandonar la Tierra, nuestro planeta-hogar, en diminutas cápsulas metálicas, al tiempo que han comenzado a preguntarse: ¿existe otra vida en el Universo?
§. Los refugios de la vida
El tipo de vida que conocemos necesita un planeta-hogar como la Tierra, un mundo acuoso. Las reacciones químicas de la vida tienen lugar en el agua: tanto la original, la aparentemente milagrosa combinación de las moléculas en las primeras células vivas en los océanos primitivos, como el proceso vital actual en nuestras propias células. Químicamente, el agua es un disolvente muy versátil, y nuestra vida química depende casi tanto de las propiedades de la molécula de agua como de las del átomo de carbono.
Al observar nuestro sistema solar, los inhóspitos climas de los demás planetas nos llevan a considerar a nuestra acuosa Tierra como un lugar excepcional. Los pequeños Mercurio y la Luna no tienen gravedad suficientemente intensa como para mantener una atmósfera, y su agua se evaporó en el vacío cercano del espacio. Venus, que comenzó probablemente cual gemelo de la Tierra, estaba demasiado próximo al Sol, excesivamente caliente como para que el vapor de agua cayera en forma de lluvia; y, además, la atmósfera de dióxido de carbono le arropó aún más, hasta que la temperatura de su superficie alcanzó el punto de fusión del plomo. Marte, que gira alrededor del Sol en una órbita exterior a la de la Tierra, es demasiado frío. El agua quedó allí atrapada en los casquetes polares y en las rocas de la superficie en forma de hielo permanente. Aunque los canales de su superficie parecen cauces de ríos secos, y muestran que el agua fluyó alguna vez sobre Marte, no es cierto que fuera la suficiente para generar vida; y los experimentos del Viking no han encontrado compuestos de carbono en el suelo marciano.
¿Y en cuanto a los planetas gigantes? En la atmósfera de Júpiter, reacciones del tipo de las de la Tierra primitiva deben de haber originado una amplia gama de compuestos orgánicos; pero al no haber océanos ni costas rocosas, la mayoría de los bioquímicos dudan de que se pudieran formar células. Impertérrito ante esto, Cari Sagan, el mayor optimista de la Universidad de Cornell, ha formulado la hipótesis de que en la atmósfera de Júpiter pueden vivir gigantescas criaturas gaseosas flotando en los espesos gases al igual que los peces en el agua.
Sin embargo, para encontrar vida afín a la nuestra debemos dirigir nuestra mirada fuera del sistema solar. En nuestra Galaxia hay unos cientos de miles de millones de estrellas, y las teorías astronómicas actuales muestran que la mayoría poseen planetas. El especialista en ordenadores Stephen Dole simuló la formación de los planetas en un gran ordenador y descubrió que los planetas rocosos como la Tierra se forman generalmente cerca de la estrella, y los gigantes gaseosos, lejos de la misma. En un porcentaje razonable de casos se obtiene un planeta del tamaño de la Tierra a una distancia tal de la estrella que el agua es líquida, primer requisito para que comience el proceso de la vida. Señalemos que aun siendo bastante pesimistas como para pensar que sólo una estrella entre un millar posee un planeta familiar confortable, habida cuenta el gran número de estrellas de nuestra Galaxia, esto significaría que aún podemos tratar con cien millones de «'Tierras».
Un planeta de este tipo acabaría indudablemente contando con océanos de «caldo» orgánico como los de la Tierra primitiva. Y aquí ingresamos ya en el dominio de la especulación: ¿se desprende inevitablemente la vida de una mezcla semejante, o su presencia en la Tierra se debió a un capricho que llevó a unirse a las moléculas que no habían podido repetirse por sí mismas? La notable similitud de todos los procesos vitales parece indicar que todas las células vivas pueden descender de una célula viva original, quizá sólo una afortunada coincidencia de moléculas que no se repetiría en ningún otro planeta del millón semejantes a la Tierra. No obstante, los optimistas arguyen que la vida sobre la Tierra se inició de una forma sorprendentemente rápida, en sólo un centenar de millones de años; esto sugiere que siguió una secuencia inevitable de acontecimientos. En verdad, no se conocen todavía suficientemente los comienzos de la vida como para que podamos decidir nada al respecto.
Este argumento puede repetirse para cada una de las crisis de la vida. ¿Fue inevitable que las células inventaran la fotosíntesis cuando el «caldo» comenzó a ser demasiado tenue? Esas células animales que respiran oxígeno, ¿surgieron para impedir que se asfixiaran las células de las plantas? ¿Fue inevitable, asimismo, que se desarrollara una especie inteligente que deseara conocer el Universo? ¿O todo esto es sólo fruto del azar?
El optimista concluiría en que todo ello sucedió en la forma adecuada, y que existen millones de planetas con vida inteligente; el pesimista podría acabar pensando que somos la única forma de vida inteligente en el Universo.
§. La comunicación a través del espacio interestelar
Entre los optimistas se encuentran muchos científicos dispuestos a pasar a la acción. Si se acepta que existen otras civilizaciones «fuera de aquí», algunas, seguramente, intentarían establecer contacto con otras razas inteligentes. Por ello, durante los últimos veinte años todos los astrónomos del mundo han buscado señales inteligentes procedentes del espacio.
Al ignorarlo todo acerca de los posibles extraterrestres, podría parecer que nuestra búsqueda de señales se realiza a ciegas: sólo podemos argumentar a partir de nuestra propia experiencia. Los científicos planetarios mantienen contacto con sondas distantes por medio de ondas de radio, y ésta fue la primera posibilidad que se tomó en consideración. En 1960, Frank Drake inició la primera investigación de señales extraterrestres: diseñó su «Proyecto Ozma» para tratar de detectar una comunicación inteligente desde las dos estrellas más cercanas semejantes al Sol.
Durante tres meses «escuchó» con el gran radiotelescopio de 26 metros de Greenbank, en Virginia Oeste, pero los resultados fueron tan vanos como el país de Oz, homónimo del proyecto.

Todas las criaturas levas deben su existencia a la energía de la luz solar. Las plantas verdes se alimentan de dióxido de carbono y agua, utilizando la energía solar absorbida en el proceso de la fotosíntesis. Los animales obtienen la energía de las moléculas así sintetizada por las células de las plantas.
A pesar de todo, la radio constituye un medio eficiente para enviar mensajes a través de la Galaxia. El mayor radiotelescopio del mundo en Arecibo, Puerto Rico podría recibir un mensaje radiado por un telescopio similar desde cualquier lugar de nuestra Galaxia sin que las ondas de radio fueran bloqueadas por el polvo interestelar. Se plantea, sin embargo, el problema de la sintonización. Al igual que con un equipo de radio ordinario, los astrónomos que intentan sintonizar una señal cósmica deben conocer la longitud de onda del transmisor; y como no existe una guía de programas interestelares, hay que procurar elegir una longitud de onda que fuera lógico que emplearan los extraterrestres.
Frank Drake optó por los 21 cm., la longitud de onda natural del elemento más abundante y más sencillo, el hidrógeno. En la actualidad se han examinado a esta longitud de onda, con una sensibilidad mucho mayor que la de la investigación original de Drake, unas 600 estrellas de entre las más próximas, y, además, se ha completado la investigación con barridos de lodo el cielo, con la esperanza de detectar transmisiones superintensas más distantes. Así y todo, nada se ha conseguido.
Pero ¿es apropiada la longitud de onda de 21 cm? Puesto que la Galaxia está llena de gas hidrógeno, existe siempre un fondo de radiación de 21 cm. que interfiere las observaciones. Algunos científicos piensan que una raza inteligente escogería una longitud de onda más «tranquila»; quizás entre 21 cm y 18 cm, la longitud de onda del ión hidroxilo (OH), agua a la que le falta un átomo de hidrógeno. Dado que el hidrógeno y el hidroxilo lo constituyen el agua, esta banda de longitudes de onda ha sido denominada «agujero de agua»: tal vez sea la longitud de onda más apropiada para encontrar vida basada en el agua. Sin embargo, las propias moléculas de agua emiten a una longitud de onda de 1,35 cm. ¿No sería ésta una elección más afortunada?
En la actualidad se realizan investigaciones a todas estas longitudes de onda principalmente en América y la Unión Soviética, y aunque no se ha detectado aún ninguna señal, siempre existe la duda de la sintonización. Durante los últimos veinte años se han hecho al menos tres suposiciones lógicas sobre la longitud de onda «apropiada» para el contacto por radio interestelar; es posible que una civilización un millón de años más avanzada que la nuestra tuviera de todo ello una idea completamente diferente.
Además, esos seres hipotéticos pueden tener sus razones para no emplear ondas de radio. Las longitudes de onda infrarrojas y ultravioletas son otras posibilidades, si bien no se desplazarían con tanta rapidez a través de nuestra Galaxia llena de polvo. Herbert Wischnia se valió anteriormente del gran satélite de ultravioleta Copernicus, en órbita para explorar las estrellas semejantes al Sol más próximas; pero también erró el blanco.
La luz ordinaria tiene asimismo sus desventajas en tanto que mensajero interestelar, ya que una señal inteligente sería anulada por el brillo de la estrella padre del planeta, su «Sol», al ser «vista» a través de las vastas extensiones del espacio. Sin embargo, los láseres ofrecen una solución, pues sería posible sintonizar un láser para que emitiera en una de las longitudes de onda en las que la estrella padre brillase débilmente, es decir, en una línea de absorción oscura de su espectro. Si ésta es la banda de comunicación de la Galaxia, las primeras señales extraterrestres podrían provenir no de una búsqueda basada en grandes antenas de radio, sino de un astrónomo que estudiara los espectros de las estrellas como parte de un proyecto de investigación sin relación alguna con este tema.
¿Qué ocurriría si alguien en el Universo nos estuviese «escuchando»? En buena lógica, también nosotros deberíamos transmitir señales para que otros las detectasen. De hecho, el hombre lo ha estado haciendo durante décadas, ya que las señales de radio y televisión domésticas han salido al espacio y han llegado ya a las estrellas semejantes al Sol más próximas. Quienquiera que dispusiera de un gran radiotelescopio y atinara con la frecuencia correcta, sabría que existe vida inteligente sobre la Tierra (aun cuando lo que considere inteligente puede depender de los programas que capte). En noviembre de 1974 se utilizó el gigantesco telescopio de Arecibo partí transmitir la primera señal humana intencionada a las estrellas. El mensaje se dirigió a un gran cúmulo de viejas estrellas con la esperanza de que alguna de ellas tuviera planetas con vida avanzada. Desgraciadamente, incluso a la velocidad de la luz, el mensaje tardará en llegar 24.000 años hasta obtener respuesta, que nos llegaría 48.000 años después. Esto pone de manifiesto la increíble soledad del espació interestelar. Las enormes distancias implican que los mensajes, más que conversaciones, deben ser monólogos. Y cuando recibamos una señal, ésta podrá proceder de una civilización que ha desaparecido durante el tiempo transcurrido en recibirla; o nosotros podremos haber desaparecido antes de recibirla.
§. Viaje a las estrellas
El hombre siempre ha deseado explorar. Es mucho más intrigante una expedición tripulada a la Luna que tina misión de robots que llevara a cabo los mismos cometidos a un costo inferior. Por tanto, es probable que un día se dirija hacia las estrellas una nave espacial tripulada.
Disponemos ya de la tecnología necesaria. Las naves de paso enviadas a Júpiter, los Pioneer 10 y 11, viajan al dominio de los planetas exteriores con velocidad suficiente como para no ser afectadas por la gravedad solar. Si se hubieran dirigido a la estrella más próxima, llegarían en unos 80.000 años.
En la actualidad pueden construirse naves espaciales capaces de llevar a los hombres a las estrellas en ese tiempo. Por supuesto, el problema es el del envejecimiento. La hibernación o la congelación, aun cuando discutidas, no son viables desde el punto de vista médico. Una propuesta más realista es la de Gerard O’Neill, de la Universidad de Princeton, un físico nuclear que descubrió el tipo de «anillo de almacenamiento» crucial para el descubrimiento del quark encantado. Su último proyecto atañe a la «colonización» del espacio, es decir, al establecimiento de gigantescas colonias de miles de personas que permanezcan en órbita alrededor de la Tierra. Y no hay ninguna razón que impida que algunas de estas colonias, equipadas con cohetes apropiados, realicen largos viajes interestelares. O’Neill estima que dentro de un millón de años un tiempo increíblemente corto astronómicamente hablando—, los descendientes de estos primeros pioneros podrían extenderse por toda la Galaxia.
En rigor de verdad, el problema, si deseamos ir a las estrellas más rápidamente, es la cuestión de la propulsión interestelar. Los cohetes de combustibles químicos que hoy vemos despegar desde la Tierra no son bastante eficientes como para propulsarnos a las estrellas a mayor velocidad que los exploradores Pioneer. La única solución sería una aceleración suave pero continua, mantenida durante años, y el único proceso realmente eficiente que conocemos para ello es la energía nuclear. Un reactor nuclear podría calentar gas hidrógeno en una cámara de «combustión», y este gas caliente podría impulsar al cohete tal como lo hacen los pases calientes quemados por un cohete químico. O bien podría utilizarse la energía nuclear para despojar a los átomos de sus electrones, con el fin de que repelieran eléctricamente a los restos cargados positivamente e impulsaran así la nave hacia adelante.
El único diseño «práctico» de nave publicado hasta la fecha bombardea literalmente su ruta |x>r el espacio. La sonda (no tripulada; de la Sociedad Británica Interplanetaria a la Estrella de Barnard sería propulsada por las explosiones de minúsculas bombas de hidrógeno dispara- das hacia atrás a un ritmo de 250 por segundo, cada una de ellas accionada sucesivamente por haces de láser. Las sucesivas explosiones serian recogidas por un paraguas magnético situado en la parte posterior de la nave, que de esta forma sería impulsada a velocidades cada vez mayores. Un vuelo de este tipo, realizado en dos etapas, podría atravesar los 5,9 años luz que nos separan de la estrella de Barnard en «sólo» 47 años.
Sin embargo, la limitación real al vuelo interestelar es el límite absoluto de velocidad impuesto por la Naturaleza: la velocidad de la luz. Según la teoría de la relatividad de Einstein, nada puede desplazarse con mayor rapidez que la radiación electromagnética; por consiguiente, el tiempo mínimo para llegar a la estrella de Barnard es de 5,9 años luz: y ésta es la estrella más próxima conocida con un sistema planetario. Hasta los más optimistas reconocen que el planeta habitado más próximo es improbable que esté a menos de varios cientos de años luz. De acuerdo con la teoría científica actual, jamás será posible pasar unas cortas vacaciones sobre la Tierra de otra estrella, ni viajar alrededor de la Galaxia como lo hace un avión sobre la superficie terrestre.

Dos hipotéticas colonias espaciales. Cada una es un cilindro hueco de 32 kilómetros de largo y 6 kilómetros de diámetro. El rápido giro, uno cada dos minutos, crea gravedad terrestre artificial, mientras que la luz solar es reflejada por medio de grandes espejos. Una nave espacial similar equipada con iluminación artificial, y con una unidad de propulsión, podría transportar lentamente colonias humanas hasta las estrellas.
La restricción de la velocidad parece ser fundamental en el Universo. Los escritores de ciencia ficción pueden saltar dentro y fuera del «hiperespacio», pero esta posibilidad no encaja en las actuales teorías de los físicos. No resulta exagerado afirmar que nuestra comprensión del Universo se trastrocaría si fuera posible viajar más rápido que la luz. Por supuesto, esto puede ocurrir en un futuro lejano, cuando nuestras actuales teorías nos parezcan tan ridículas como las que consideraban plana a la Tierra. No obstante, estas teorías parecen ofrecernos una imagen cada vez más unificada del funcionamiento de la Naturaleza, y el límite de la velocidad de la luz probablemente tardará aún en abandonarnos. Durante un cierto tiempo como mínimo, el logro más complejo y fascinante que nos ha proporcionado nuestra experiencia de la Naturaleza, es decir, la vida misma, permanecerá vinculada a la Tierra... a menos que a alguien se le ocurra venir a visitarnos desde otros mundos...
Capítulo 6
La frontera de lo infinitesimal
El Universo es infinitamente grande..., pero está constituido por cosas infinitamente pequeñas. La comprensión del comportamiento de las partículas fundamentales es tan singular y difícil como la de la ciencia ficción.

El microscopio pone de manifiesto bellas simetrías a una escala mucho menor que la apreciable por el ojo. Estas células forman la parte central de una raíz de caminado.
§. Ondas-partícula
§. En el interior del átomo
§. La búsqueda de lo invisible
§. La energía virtual lo une todo
§. Cola fuerte para los quarks
La exploración de lo muy pequeño es tan difícil y costosa como la exploración del Universo exterior a nuestro planeta. Aceleradores de partículas de millones de dólares se disputan los fondos con los observatorios y con las misiones de sondas espaciales. En primera línea, científicos dedicados y apoyados por los más modernos ordenadores trazan ambas fronteras del conocimiento y, como veremos, descubren que los límites de lo ultramicroscópico desafían al sentido común tanto como los descubrimientos astronómicos estimulan nuestra imaginación en el otro extremo.
Si acercamos paulatinamente esta página a nuestros ojos, los detalles se pondrán cada vez más de manifiesto. Las fotografías en color se convertirán en simples estructuras de puntos. Sin embargo, existe un límite por debajo del cual el ojo fatigado no puede enfocar más, y por ello hasta el siglo XVII nadie conoció nada que fuera más pequeño. Hacia esta época se inventó el microscopio simple, que, efectivamente, constaba sólo de un cristal de fuerte aumento (tal como al parecer sucedió con el telescopio, puede que hayan sido varios los ópticos que lo descubrieron independientemente). Un cristal de aumento nos permite ver detalles normalmente invisibles para nuestros ojos, y en el siglo XVII los ópticos holandeses hicieron importantes descubrimientos con estos microscopios simples (de una lente). Antón van Leeuwenhoek, pañero de profesión y conserje del Municipio de Delft, tallaba lentes de precisión en su tiempo libre. Con la ayuda de estas pequeñas lentes observó, a través de cristales de aumento del tamaño de una cabeza de alfiler, un mundo diminuto que nadie había visto antes, descubriendo la estructura, cuidadosamente ordenada, del tejido vivo, así como la existencia de seres unicelulares que, ahora lo sabemos, son descendientes de las formas de vida originarias de la Tierra. Las lentes de Leeuwenhoek, de casi doscientos aumentos—los suficientes para que una única letra cubra una página de este libro—, colmaron los límites de la tecnología de los cristales de aumento, y el versátil científico inglés Robert Hooke dio el siguiente paso al disponer dos lentes en un tubo, fabricando así el tipo actual de microscopio compuesto (varias lentes).
Desde entonces, el progreso tecnológico ha perfeccionado en mucho el microscopio compuesto de Hooke, pero en la actualidad aún se requiere más. Sin embargo, existe un límite natural que ni siquiera el mejor microscopio puede superar. La luz se propaga como un movimiento ondulatorio con una longitud de onda inferior a una milésima de milímetro, lo que impide que podamos ver cosas de tamaño menor. Pensemos en las olas del mar chocando con una roca. Si la roca es grande comparada con la distancia entre las crestas de las olas —la longitud de onda, éstas no pueden atravesarla en línea recta, y su movimiento se modifica. Sin embargo, cuando las olas se encuentran con un pequeño obstáculo, tal vez el mástil de un barco hundido en vez de una roca, su movimiento prácticamente no se altera. Lo mismo ocurre con las ondas luminosas. Un objeto comparativamente grande, como la cabeza de un alfiler, afecta a las ondas luminosas con que se encuentra, y la perturbación resultante es la imagen que vemos; pero-un único átomo, o una molécula, son demasiado pequeños para perturbar a estas ondas.

Los distintos métodos de iluminar muestras en el microscopio acentúan aspectos diferentes. Estas diatomeas (algas unicelulares) están observadas (de arriba abajo): con luz polarizada; con iluminación en campo oscuro, en la que solo se ve la luz difundida oblicuamente; y con luz transmitida normalmente, que atraviesa la muestra.
Por consiguiente, no podemos lubricar un microscopio superpotente para ver directamente los átomos. Los biólogos utilizan aún microscopios ópticos para observar células vivas, pues la arquitectura básica de la célula es visible, en especial cuando se tiñen químicamente sus diferentes estructuras.

Figura de difracción de rayos X del ADN los rayos X emergen de la molécula más intensamente en unas direcciones que en otras. A partir de fotografías como éste, tomada por Maurice Wilkins del King’s College de Londres, se elucidó la estructura de doble hélice del ADN.
Sin embargo, no surge ningún indicio de la compleja química de la vida desde este burdo observatorio. Es algo así como contemplar una ciudad desde el aire: veremos trazados de calles y bloques de casas, pero no podremos ver la actividad constante de los seres humanos que constituye la vida de la ciudad.
Al incrementar el microscopio en más de unos mil aumentos, alcanzamos ya los límites de la Naturaleza. Los detalles que veremos son tan pequeños como la longitud de onda de la luz, ligeramente inferior a una milésima de milímetro. Si observamos un alambre gradualmente afilado, a medida que nos aproximemos a ese tamaño comenzará a distinguirse cada vez menos, y la parte más afilada será simplemente invisible. No podemos superar el límite incrementando el aumento: las imágenes simplemente se hacen mayores pero no mejoran su definición —tal como ocurre al ampliar una fotografía desenfocada—, mientras que cualquier cosa más pequeña permanece invisible. Potencias mayores conducen a lo que los microscopistas llaman, gráficamente, «aumento vacío».
Podernos no obstante aprovechar el hecho de que la luz no es la única onda en el almacén de la Naturaleza. Existen ondas electromagnéticas de longitudes de onda más cortas, del tamaño del átomo y menores, conocidas como rayos X: son las longitudes de onda apropiadas para «ver» átomos como si fueran grandes obstáculos. Un microscopio de rayos X debe mostrarnos los átomos individuales de un trozo de materia; pero, desgraciadamente, los rayos X son notablemente difíciles de enfocar. Un microscopio ordinario, o incluso un cristal de aumento, funciona porque los rayos luminosos se desvían y se enfocan por medio de sus lentes, pero no es fácil construir una «lente» para rayos X. Como veremos más adelante, existen formas de conseguir este tipo de resolución (formación energética de imágenes) utilizando electrones. Con todo, los rayos X constituyen una herramienta vital para comprobar la disposición de los átomos en las moléculas, y los físicos han inventado un ingenioso sistema sin lentes para este propósito (en cierto modo, es similar al registro, sin lentes, de un objeto tridimensional con láser sobre la placa fotográfica plana de un holograma).
En cristalografía de rayos X se comienza a partir de un cristal puro de la sustancia, en el que están agrupadas moléculas idénticas en cuidadosa disposición. Los haces de rayos X las atraviesan y algunos son desviados por los átomos de las moléculas. La disposición de átomos, que se repite una y otra vez en el agolpamiento molecular, hace que los rayos X salgan más intensamente en unas direcciones que en otras. Si se sitúa una placa fotográfica para registrar los rayos X difractados, se revela un diagrama de puntos y líneas. La habilidad del cristalógrafo de rayos X estriba en descifrar este intrincado diagrama y descubrir la distribución de los átomos. Para moléculas sencillas basta con experiencia y sencillos cálculos, pero las moléculas de las células vivas requieren más esfuerzo. La carrera para descubrir la molécula de ADN, ganada por muy poco por Francis Crick y James Watson, fue en su mayor parte cuestión de desentrañar las enigmáticas huellas dejadas por los rayos X difractados por estas moléculas. En la actualidad, estos cálculos se efectúan en ordenadores que pueden escoger entre posibles configuraciones de átomos, comparando los resultados predichos con los experimentales en una breve fracción del tiempo que emplearía un investigador.
La cristalografía de rayos X nos muestra de forma indirecta los átomos individuales de la materia. Sin embargo, el físico germano-americano Edwin Mueller ha inventado un dispositivo completamente diferente con el que puede fotografiar átomos individuales. En su microscopio de emisión de campo, una cabeza de aguja extremadamente fina y eléctricamente cargada está centrada en una cavidad en la que se ha hecho el vacío. En una etapa anterior han sido adsorbidos en la superficie metálica átomos de helio, y a medida que la aguja se carga más positivamente, los átomos de helio pierden sus electrones y pasan a ser iones cargados positivamente. Estos iones de helio poco ligados son entonces fuertemente repelidos por la punta de la aguja cargada similarmente, y salen despedidos según trayectorias rectas.

Cuando la luz pasa a través de una doble rendija, los dos nuevos frentes de onda «interfieren», produciendo regiones de intensa perturbación (brillo) y de calma relativa (oscuridad). La materia se comporta de forma similar, pero a una escala mucho menor: las regiones de «ondas de materia» perturbadas alta energía muestran dónde existe mayor probabilidad de que se encuentre la partícula de materia.
La punta de la aguja tiene forma redondeada (aunque a muy pequeña escala), de forma que cuando el campo eléctrico obliga a salir a los iones de helio según trayectorias rectas, los iones que inciden en el extremo superior de la cámara de vacío proyectan, efectivamente, una imagen de la punta de la aguja. El aumento de este «microscopio» depende del tamaño de la cámara frente a la punta de la aguja. Es posible un aumento de un millón de veces, y a esta escala se pueden detectar las imágenes de los átomos individuales que constituyen la punta de la aguja. Fotografías de estas imágenes enormemente amplificadas son ya clásicas en la historia de la ciencia, y constituyen prueba determinante de que la materia está realmente constituida por átomos. Como para la mayoría de la gente ver es creer, una fotografía de microscopía de emisión de campo es intuitivamente más convincente que los esfuerzos de los filósofos, químicos y físicos a lo largo de siglos para probar la teoría atómica de la materia.
No obstante, tanto la cristalografía de rayos X como la microscopía de emisión de campo, pese a sus enormes aumentos, son bastante limitadas. Si deseamos una fotografía del interior de una célula como la veríamos con un microscopio ordinario superpotente, debemos recurrir a otros instrumentos. El microscopio electrónico toma fotografías utilizando un tipo sorprendente de radiación de longitud de onda corta: los propios electrones.
§. Ondas-partículas
Cuando en el siguiente capítulo nos encontremos con la naturaleza de la luz veremos que, a veces, se muestra en diminutas partículas, y otras, en una extensa sucesión de ondas. Hace algún tiempo, Max Planck y Albert Einstein señalaron el extraño comportamiento de la luz, poniendo así de manifiesto una extraña faceta más de la Naturaleza. Las partículas materiales ordinarias - electrones, átomos e incluso pelotas de golf y planetas— pueden comportarse como ondas.
Esta revolución fue anunciada por un noble francés, el príncipe Louis de Broglie. Prosiguiendo el pensamiento anterior de los físicos, que calificaban el comportamiento de la luz como corpuscular y ondulatorio, descubrió que las ecuaciones que describen el modo en que se mueven los electrones o en que vuela una pelota de golf lo hacen como si unos y otra fueran paquetes de ondas. Estas nuevas ondas no son campos eléctricos y magnéticos fluctuantes como la luz y otras radiaciones electromagnéticas, sino ondas de materia: «una fluctuación en la posición de la propia materia», sería una manera de describir la extraña predicción de De Broglie en lenguaje no matemático. La comprensión de por qué la materia se comporta en forma de ondas es esencial si apuntamos a los límites de nuestra búsqueda. Para hacernos una idea de ello, podemos investigar cómo algo tan vulgar como una pelota de golf resulta afectada por sus propiedades ondulatorias.
La forma más sencilla consiste en comenzar con la onda-partícula natural de la propia luz. Coloquemos dos dedos adyacentes casi tocándose, de manera que quede un hueco de menos de un milímetro entre ellos. Pongamos el hueco delante de un ojo y miremos a su través un fondo brillante, por ejemplo el cielo, y veremos finas líneas oscuras a lo largo de la longitud del hueco. Esto es una evidencia directa de que la luz se comporta como una onda. La luz, perturbada al atravesar el estrecho hueco, «interfiere» de forma que en unos lugares las «crestas» de las ondas coinciden y dan lugar a una línea brillante, mientras que en otros las «crestas» coinciden con los «valles» cancelándose entre sí y dando lugar a oscuridad. Las bandas alternas luminosas y oscuras son fácilmente explicables en términos de ondas.
Sin embargo, también podemos pensar que la luz se propaga como un chorro de partículas. La sensación de la visión es, simplemente, el impacto sobre la parte posterior de nuestros globos oculares de innumerables fotones luminosos individuales. Las franjas alternativamente luminosas y oscuras significan que los fotones inciden principalmente sobre aquellas franjas que vemos como brillantes y evitan las áreas negras en apariencia. Es imposible decir dónde incidirá cada fotón individual antes de que atraviese el hueco entre los dedos; pero sí podemos afirmar que es más probable que lo haga en una «banda brillante». Así es como se vinculan los aspectos de «onda» y «partícula» de la luz. Imaginemos un fotón luminoso que se propaga a través del hueco de los dedos. Si fuera una simple partícula en movimiento, por ejemplo una bala, no se desviaría, y al mirar hacia la luz veríamos simplemente una tira uniformemente iluminada; pero el fotón se comporta también como una onda. Podemos pensar en la parte que se comporta como onda propagándose a través del hueco, e interfiriendo consigo misma para dar lugar a zonas no perturbadas y a zonas de gran perturbación. Ahora bien, es simplemente más probable que el paquete de energía o fotón se mueva en una dirección en la que su onda asociada forma una zona de mayor perturbación.
No se puede decir en cuáles de las zonas brillantes acabarán los fotones individuales. Es sólo cuestión de suerte. Pero, cuando millones de fotones incidan, se distribuirán equitativamente entre las bandas brillantes «fuertemente perturbadas», mientras que evitarán las regiones «poco perturbadas» haciendo que sean negras.

Comprobación de que la materia puede comportarse como una onda. Un haz de electrones reflejados por un cristal de níquel no forma un simple punto, sino una serie de círculos concéntricos. Las «ondas de materia» de los electrones reflejados por las diferentes capas de cristal interfieren entre sí, produciendo zonas circulares en las que se concentran los electrones reflejados.
Si pensamos que esto suena a conjuro, estaremos en lo cierto. El comportamiento de la luz como onda y partícula tiene completo sentido cuando se expresa mediante sus correspondientes ecuaciones, pero resulta imposible describir en términos vulgares lo que sucede, pues estos aspectos de la luz no constituyen precisamente una experiencia cotidiana.
Sin embargo, la descripción de la luz como un fotón cuyo movimiento está controlado por ondas «guía» que deciden cuál es la dirección más probable en que se mueva- es una aproximación razonable.

El microscopio electrónico de barrido produce imágenes en profundidad con una resolución mucho mayor que la de un microscopio óptico convencional. Estos glóbulos rojos están aumentados 60.000 veces.
Volviendo ahora a las «ondas de materia», nos encontramos con que afortunadamente podemos pensar en ellas de una forma similar. Cualquier objeto que se mueve tiene una onda «guía» asociada, pero en la vida diaria las longitudes de onda son tan pequeñas que no podemos medir los efectos. Tomemos un ejemplo similar al de los fotones de luz que se propagan a través de una rendija. Si enviamos una sucesión de pelotas de golf a través de un portal abierto, teóricamente sus ondas guía interferirán consigo mismas, dando lugar a que exista una minúscula probabilidad de que cada pelota no lo atraviese en línea recta. Si suponemos que nuestra puntería es exacta, en ausencia del portal todas las pelotas se introducirían en el hoyo. Sin embargo, a causa de la «naturaleza ondulatoria de las pelotas de golf», la presencia del portal implica que cada bola alcanzará el campo en un lugar ligeramente diferente. A cada lado del banderín existirán regiones a las que llegarán pelotas de golf («brillantes», en la analogía de la luz) y regiones donde no lleguen («oscuras»). La dificultad en la práctica reside en que estas bandas «luminosas» y «oscuras» están separadas por menos de ¡una millonésima de billonésima del diámetro de un átomo!
Sin embargo, cuando descendemos a las minúsculas masas de las partículas fundamentales, las ondas guía son muy importantes. En realidad, las longitudes de onda de la materia pueden ser inconvenientemente largas. Por ejemplo, un electrón que se desplaza por el filamento de una lámpara tiene una longitud de onda mayor que el tamaño de un átomo, pero si se acelera el electrón, su longitud de onda se reduce: en esto radica el secreto del microscopio electrónico, la herramienta más versátil para observar moléculas y estructuras celulares.
Al tener un haz de electrones una longitud de onda mucho menor que la de la luz (y similar a la longitud de onda electromagnética de los rayos X), se puede enfocar fácilmente por medio de campos magnéticos. (La mayoría de nosotros cuenta con «lentes» electrónicas en nuestras propias casas; de hecho, las bobinas magnéticas de un tubo de televisión enfocan los electrones procedentes del cañón de electrones en la pantalla.) Los primeros microscopios electrónicos imitaban a los ópticos. Un haz de electrones que llega hasta la muestra es aumentado por un «objetivo», y se lo recoge sobre una pantalla o una placa fotográfica. En los más recientes microscopios electrónicos «de barrido», el haz de electrones se refleja en la superficie de la muestra para dar fotografías que se pueden observar tridimensionalmente.
Muchas de estas fotografías de los microscopios electrónicos de barrido dan una sensación de mayor «realidad» que las de los microscopios convencionales; al verlas, resulta difícil pensar que contemplamos un mundo cien mil veces más pequeño que la vida real, en el que un cabello humano tendría diez kilómetros de largo y sería más ancho que la altura de una casa de cuatro pisos. Este es el límite que, por ahora, podemos alcanzar en cuanto a fotografías con detalle; para intentar ir más lejos, dentro del átomo, son necesarias técnicas más indirectas.
§. En el interior del átomo
Ernest Rutherford, el físico neozelandés primero en transmutar un elemento en otro, fue también el primer hombre que se asomó al interior del átomo. Su método, muy simple en esencia, prefiguró muchos experimentos posteriores que procuraron investigar en lo más pequeño. Se basa en bombardear un blanco con determinado tipo de partículas, y ver qué le sucede. Sus proyectiles eran núcleos de helio de alta velocidad emitidos naturalmente por elementos radiactivos; y el blanco, una delgada lámina de oro. Predijo un resultado simple. En aquella época, los científicos creían que los átomos eran difusos, extensas burbujas (con electrones embebidos) y, por tanto, las partículas de alta velocidad debían poder atravesarlos en línea recta; y aunque la mayoría así lo hicieron, hubo unas cuantas que rebotaron. Como afirmó Rutherford, «era casi tan increíble como disparar un proyectil de 15 pulgadas contra una hoja de papel de seda y que rebotara y nos diera».
Sólo cabía una explicación. Casi toda la masa del átomo y toda su carga positiva debía estar concentrada en el centro, sitio al que Rutherford denominó núcleo. En torno a él, prácticamente todo el volumen del átomo está vacío, y únicamente contiene los electrones que giran a su alrededor. Hoy, esta imagen de los átomos nos parece muy familiar, pero en 1910 constituyó un avance revolucionario en nuestro conocimiento del Universo.
Unos sesenta años más tarde, estos experimentos de «tiro al blanco» comenzaron a revelar lo que había dentro de las supuestas partículas «fundamentales». Al lanzar un electrón sobre otro, los mismos rebotan como si se tratara de un par de bolas de billar. Si se acelera el primer electrón a una velocidad mayor que la que tenía al comienzo, disminuirá su longitud de onda de materia, y ambas partículas rebotarán como si fueran bolas más pequeñas. Incluso a las más altas velocidades que los físicos pueden comunicar a los electrones, éstos siempre rebotan como simples esferas cuyos tamaños efectivos disminuyen al aumentar la velocidad de la partícula, simplemente porque disminuye la longitud de onda. Los físicos piensan que los electrones son realmente simples partículas puntuales.
Sin embargo, cuando los electrones chocan con protones, el cuadro es totalmente diferente. Los electrones con longitudes de onda suficientemente cortas son reflejados de una forma poco habitual, lo que muestra que los protones no son simples puntos materiales. Fin vez de ello, parecería que existen tres puntos dentro de cada protón en los que está concentrada la masa. Al principio se denominaron «partones», pero ahora es obvio que poseen exactamente las mismas características que habían predicho los teóricos para los tres quarks constituyentes de un protón. Más recientemente, estos experimentos de dispersión utilizan ya electrones cuyas enormes velocidades les confieren longitudes de onda suficientemente pequeñas como para «penetrar» en los protones, mostrándonos los propios quarks. Aunque, por cierto, los físicos no han logrado aislar un quark «libre», los experimentos de dispersión de electrones (y muones) constituyen la «evidencia» más aproximada que tienen los científicos de los quarks individuales.
A esta altura, deberíamos retroceder y precisar que a escalas tan pequeñas como de las que se trata en física de partículas, la noción de tamaño es bastante ambigua. Probablemente un electrón no tiene «diámetro» real, es infinitamente pequeño y de masa y carga puntual. Sin embargo, en un experimento real, el electrón se comporta como si tuviera un tamaño prácticamente igual a su longitud de onda: al aumentar su velocidad, su tamaño efectivo disminuye.
Un protón lento se comporta asimismo como una partícula del tamaño de su longitud de onda, pero a velocidades más altas su tamaño disminuye hasta alcanzar un límite; por ello, un protón tiene un tamaño real significativo que coincide prácticamente con la distancia que separa a los quarks que lo constituyen.
Como ya hemos señalado, el mundo de lo muy pequeño hace pocas concesiones al sentido común. Los físicos de partículas no hablan generalmente en términos de «tamaños», pues los tamaños medidos dependen generalmente de cómo se realice el experimento, e incluso las masas son a veces difíciles de definir. Los quarks de un protón están fuertemente ligados, y la energía de enlace, equivalente a la masa, implica que la suma total de las masas de los tres quarks no es la misma que la del protón. El lenguaje de los físicos de partículas es rico en términos exóticos, algunos bastante familiares, como energía y carga eléctrica; y en otros, más alejados de la experiencia cotidiana, como extrañeza, encanto, spin isotópico, paridad y número bariónico y leptónico. Y se precisa aún una plétora de términos nuevos para describir las insólitas propiedades y reacciones de las partículas fundamentales que constituyen nuestro Universo; a escala muy pequeña, tiene más sentido emplear términos como éstos que conceptos habituales como el de tamaño.
A este nivel, los resultados experiméntales se entremezclan con la teoría. No podemos ver quarks individuales ni leptones, y su evidencia nos llega indirectamente de destellos luminosos o de avalanchas de corriente en los detectores de partículas, así como a partir de trazas curvadas sobre las placas fotográficas. La mayor parte de las nuevas partículas más exóticas no se muestran ni siquiera de esta forma, pero los físicos han de recurrir a ellas para explicar la producción de partículas conocidas en combinaciones, trayectorias y energías inesperadas. Todo esto puede parecer caminar a tientas, pero los resultados de distintos experimentos, interpretados por grupos de investigación diferentes de todo el mundo, son consistentes, y la gran mayoría de ellos confirma las predicciones de la teoría actual. Sólo unos cuantos ofrecen resultados inesperados, pero en vez de contradecir la teoría, la extienden al introducir, por ejemplo, nuevos tipos de partículas. Hay distintas razones para pensar que el extraño mundo de los quarks y de los leptones, con sus peculiares propiedades y sus exóticas reacciones, es tan real como el de los átomos. Recordemos que la existencia de átomos y moléculas se basó muchos años en una evidencia experimental indirecta.
§. La búsqueda de lo invisible
La década de 1960 fue testigo de la «carrera espacial» para situar a un hombre en la Luna. Tras un gran gasto y el desarrollo de la nueva tecnología de los cohetes gigantes y de los sistemas de viaje espaciales, los americanos «ganaron» cuando Neil Armstrong puso el pie sobre nuestro mundo hermano en 1969. Las de 1970 y 1980 son testigos de una nueva, aunque menos divulgada, carrera, cuyos premios son algo más que el prestigio nacional o el retorno con un saco colmado de rocas lunares. En inmensos laboratorios de los Estados Unidos y de Europa, los físicos persiguen a las últimas partículas de que está constituido el Universo. Los premios no son sólo el descubrimiento de nuevas partículas, sino que cada nuevo experimento encaja otra pieza en el complejo rompecabezas de las partículas fundamentales y de las fuerzas; v, así, llegará un día en el que el rompecabezas se habrá completado, permitiéndonos contemplar la descripción completa de la constitución básica de nuestro Universo.
Los laboratorios deben ser enormes, pues incluyen máquinas que aceleran partículas a tremendas velocidades. El principio es simple. Si se sitúa una partícula cargada en un campo eléctrico, es impulsada por la fuerza eléctrica. Los electrones de un tubo de televisión se aceleran exactamente de la misma forma: son arrastrados por la fuerza eléctrica a través del vacío del tubo hacia la pantalla cargada positivamente; al golpear contra la pantalla de fósforo, su energía de movimiento se transforma en destellos luminosos que dan lugar a la imagen.
Sin embargo, los físicos de partículas necesitan electrones de mucha mayor velocidad. En Stanford, California, los electrones son acelerados continuamente a lo largo de un tubo de vacío de tres kilómetros de longitud. El alargado montículo que cubre esta sofisticada máquina se extiende sobre el campo como si se tratara de un terraplén de la Edad del Hierro, pasando bajo las autopistas cuando se cruza con ellas. En su extremo, estos electrones salen disparados sobre una barrera de experimentos para colisionar con otras partículas y acabar ofreciendo algunas respuestas a los interrogantes que se plantean los físicos de partículas. Muchos aceleradores se construyen en forma de gran anillo, en el que las rápidas partículas se desplazan en redondo mantenidas en el centro del tubo de vacío por imanes situados a lo largo de aquél. El mayor acelerador europeo, el del CERN, laboratorio próximo a Ginebra, es un anillo completado recientemente de 7 kilómetros de circunferencia: acelera protones hasta el 99,9997% de la velocidad de la luz. El costo de estas instalaciones es un reflejo de su tamaño y complejidad: el nuevo acelerador europeo, por ejemplo, representa para las naciones participantes 1.100 millones de francos suizos (250 millones de dólares a precios de 1971.
Resulta irónico que los físicos necesiten máquinas tan enormes y tan caras para estudiar los elementos más pequeños del Universo. Sin embargo, así es, y ya hemos visto parte del porqué: la naturaleza de la onda de la materia. Para «penetrar» y observar que partículas como los protones están constituidas por quarks, se necesita sondarlos con partículas de alta velocidad de muy corta longitud de onda.
Los resultados más interesantes de los aceleradores son las nuevas partículas: en 1974, la primera partícula con quarks encantados; poco después, una partícula con probablemente un nuevo quark («fondo» o «belleza»); mientras que en este mismo período se ha hecho más evidente la existencia de un quinto miembro de la familia de los leptones. Como vimos en el capítulo 3, es imposible producir una nueva partícula de la nada, pero si se concentra energía suficiente en un lugar, puede originarse un par partícula-antipartícula. Una forma idónea de obtener esta concentración de energía es lograr que una partícula de alta velocidad colisione con otra: los residuos de la colisión están generalmente constituidos por una rica mezcla de partículas y antipartículas, y sólo en ocasiones aparece un par desconocido previamente.
El procedimiento más sencillo para provocar una colisión de este tipo es hacer que un haz de protones, electrones o lo que fuere, de alta velocidad, incida sobre un blanco fijo. El blanco, quizás un bloque de hierro o una cámara llena de hidrógeno líquido, debe tener bastante espesor como para que exista una probabilidad mayor de que las [partículas del haz colisionen con un núcleo del blanco y produzcan un «suceso». Las trazas de* los residuos de la colisión de estos sucesos informan a los físicos sobre el tipo de partículas (y antipartículas) producidas. Como la mayoría de tales sucesos tienen lugar en experimentos de «blanco fijo», los físicos pueden medir un número razonable de los comparativamente infrecuentes sucesos que producen nuevas partículas. La media de estos resultados suministra a los experimentadores valores bastante precisos de algo tan importante como las masas y las vidas medias de las nuevas partículas.
Sin embargo, los experimentos de blanco fijo no utilizan por entero las inmensas energías de las partículas incidentes. Imaginemos que éstas sean coches de carrera que ruedan en una pista circular. Nuestros «núcleos» blanco son otros coches estacionados sin freno en el arcén. Al comenzar el experimento, los coches se han salido de la carretera y han colisionado con los estacionados, originando un montón de residuos. No obstante, la mayor parte cicla energía de los coches se emplearía en el choque con los estacionados, impulsándolos hacia delante, de manera que este nuevo movimiento absorbería parte de la energía que de otra forma se hubiera empleado en los residuos.
Existe un modo bastante simple de resolver este problema. Construyamos una segunda pista prácticamente del mismo tamaño que la primera, pero de forma ligeramente diferente, de manera que ambas se intersecan en sólo dos lugares. Enviemos ahora los coches por una de las pistas en el sentido de las agujas de un reloj, y por la otra en sentido contrario. En los puntos de intersección existe la posibilidad de que un coche de una de las pistas colisione frontalmente con uno de la otra. Si ambos tienen la misma masa, pararán en seco, y toda la energía del movimiento se transformará en residuos de la colisión. El precio a pagar por estas colisiones de muy alta energía es que son comparativamente infrecuentes: la probabilidad de que un coche choque en una intersección con otro es mucho menor que la de que colisione con un coche estacionado en el experimento de blanco fijo.
No obstante, estas colisiones de alta energía son importantes cuando se buscan nuevas partículas. Según la fórmula masa-energía de Einstein, cuanto mayor es la energía presente en la colisión, más masivos son los tipos de partículas y antipartículas que puedan originarse. Los experimentadores hallaron el nuevo leptón con los anillos de almacenamiento de intersección de Stanford, simplemente porque permitían producir colisiones de alta energía. Los electrones y sus antipartículas, los positrones, procedentes del gran acelerador, estaban «almacenados» en dos anillos en intersección, y se los mantenía girando en direcciones opuestas. En las intersecciones, los electrones y positrones de alta velocidad podrían colisionar, aniquilándose unos a otros en un fogonazo de energía tan intenso que en los residuos se originarían partículas y antipartículas, siete mil veces más pesadas que el electrón, en forma de energía transformada espontáneamente en pares materia-antimateria.
En la actualidad se construyen, en Stanford y en Alemania, anillos electrón-positrón aún más potentes con el fin de intentar crear partículas todavía más masivas. También se proyectan, en Europa y en Estados Unidos, anillos de colisiones protón-protón y protón-antiprotón, pues los físicos de partículas compiten para tratar de encontrar nuevas partículas aún más pesadas. Y no es sólo una cuestión de «coleccionar» partículas como la gente colecciona sellos o monedas, sino de que cada nuevo tipo de quark o leptón nos diga algo acerca de cómo está constituido el Universo. Sin embargo, la prioridad fundamental es la búsqueda de partículas pesadas que no sean quarks ni leptones, sino las partículas «W» y «Z», manifestaciones de la propia fuerza nuclear débil.
§. La energía virtual lo une todo
Para comprender cuál es en la actualidad la última meta de los físicos de partículas, debemos sumergirnos nuevamente en las extrañas maneras en que se comporta la Naturaleza a pequeña escala. Así pues, antes hemos hablado de dos familias de partículas, los quarks y los leptones, y de las cuatro fuerzas de la Naturaleza. Pero ¿qué son estas fuerzas? ¿Cómo pueden interaccionar dos partículas separadas? Hace tiempo que los físicos recelan de la idea de «acción a distancia», y prefieren pensar en términos de alguna vinculación tangible entre ambas partículas.
Con el fin de apreciar en qué puede consistir esta vinculación, debemos volver a la familiar fuerza electromagnética. Si aproximamos dos electrones cargados negativamente, sus cargas los repelen y los separan bajo la influencia de sus campos eléctricos. Esta es la forma de ver la acción a distancia. Sin embargo, la teoría cuántica muestra que existe un vínculo tangible entre ambos electrones: un muy fugaz intercambio de fotones. Los fotones (capítulo siguiente) son los paquetes de energía en los que la luz se traslada; en efecto, son un tipo de partículas, pero no se comportan como el quark o el leptón.
En cierto sentido, no resulta sorprendente que los implicados sean los fotones, ya que son partículas de radiación electromagnética, y la repulsión electrón-electrón se debe a la fuerza electromagnética. No obstante, cuando comenzamos a preguntarnos de dónde vienen y adonde van, la teoría da una extraña respuesta: ¡no existen en realidad!
Las raíces de esta extraña situación se encuentran en la naturaleza onda-partícula de toda la materia. El físico alemán Werner Heisenberg estableció en 1927 que la dualidad onda-corpúsculo tenía consecuencias tanto filosóficas como científicas. Denominó a esto principio de incertidumbre. Existe un límite natural de lo que podemos conocer acerca del Universo que parece infranqueable.

En un microscopio electrónico, los electrones son reflejados por las capas más externas de las átomos: el microscopio de misión de campo utiliza núcleos de helio que se repelen eléctricamente para formar una imagen de los propios átomos. La estructura interna de los átomos se puso de manifiesto bombardeándolos con núcleos de helio de alta energía, observándose que algunos retrocedían sin desviarse: haces de electrones de alta energía pueden mostrar ahora los quarks que constituyen los protones y los neutrones del núcleo.
Para entender este funcionamiento, retornemos al no demasiado serio ejemplo de un campeón de golf que efectúa su chive a través de un portal, hacia un campo distante. En ausencia del portal haría exactamente un hoyo, o, dicho de otra forma, la pelota de golf no se desviaría a uno y otro lado de la trayectoria recta que conduce al hoyo.

El gran acelerador de partículas del Fermi .National Accelerator Laboratory, en Illinois, tiene 6.5 kilómetros de circunferencia. Los protones tremendamente energéticos del anillo se utilizan para comprobar la estructura de quarks de las partículas y para crear pares de nuevas partículas y antipartículas.
Sin embargo (despreciando por el momento la luz), no habría forma de conocer la posición de la pelota en su camino hacia el hoyo. Aquí reside la justificación de nuestro portal: si la pelota alcanza el campo, debe haber pasado entre las jambas y podemos conocer así su posición; pero también aquí existe un problema, pues la naturaleza ondulatoria de las pelotas de golf implica que la de nuestro ejemplo pueda resultar ligeramente desviada de su trayectoria recta. Al definir su posición por medio de la puerta, no podemos tener ya seguridad acerca de la dirección exacta en que se desplaza.
Por supuesto, estos problemas no le preocupan al golfista práctico. El puede ver la pelota en todo momento (aunque los fotones de luz que refleja hacen su trayectoria mucho más incierta que la minúscula desviación fundamental debida al principio de incertidumbre de Heisenberg). Ahora bien, si reemplazamos la pelota de golf por un electrón, el portal por una rendija estrecha, y el campo por una placa fotográfica, las consecuencias son obvias. Cuanto más intentemos definir la posición del electrón a uno y otro lado estrechando la rendija, su naturaleza ondulatoria hará tanto más incierta su dirección.
Todo esto encaja con las fuerzas de la Naturaleza por una vía lógica aunque aparentemente indirecta. El principio de incertidumbre nos muestra asimismo que no podemos medir energías con precisión, a menos que podamos efectuar la medición a lo largo de un determinado periodo. Para las energías cotidianas, el tiempo que necesitamos es muy corto y no se plantean problemas. Sin embargo, cuando nos enfrentamos con las energías mucho menores de las partículas fundamentales, los tiempos necesarios son más largos. Pensemos al respecto de una forma más práctica desde el punto de vista de las fuerzas: un paquete de energía puede aparecer espontáneamente en el vacío, así como desaparecer de nuevo en un tiempo breve, tan breve que el límite de la Naturaleza nos impide su medición. En cierta manera, ésta es la versión de la Naturaleza del refrán «ojos que no ven, corazón que no siente»; aun cuando la energía existe durante un tiempo demasiado breve como para ser medida, ello no significa que vulnere la ley de la conservación de la energía (sí significa, en cambio, que resulta imposible crear energía de la nada).
Así pues, cuando dos electrones se repelen aparentemente debido a la fuerza eléctrica, en realidad intercambian fotones cuya existencia es demasiado fugaz comer para que los podamos medir directamente.

Cilindros concéntricos de distintos tipos de detectores de partículas rodean el punto de aniquilación electrón-positrón en el Stanford Linear Accelerator Center (SLAC), mostrado por el físico Carl Friedberg. Un ordenador analiza las respuestas del detector y pone de manifiesto las tipos de pares partícula-antipartícula que se han creado a partir de cada explosión de energía. (Cortesía del Lawrence Berkeley Laboratory.
Quizá no sea ésta la mejor descripción de lo que se llama un «campo de fuerza», pero los físicos pueden efectuar cálculos basados en este intercambio de fotones «virtuales», y los resultados concuerdan extremadamente bien con diversas clases de experimentos. Esta es la teoría de la electrodinámica cuántica, una de las más exactas de la física actual; relaciona los fenómenos de las fuerzas eléctricas y magnéticas con otras propiedades de las partículas fundamentales, como el spin, y da cuenta de los aspectos ondulatorio y corpuscular de la luz y de otras radiaciones electromagnéticas.
Por tanto, los físicos ven al fotón como una partícula que interpreta dos papeles.
Un simple fotón es sólo radiación, como la luz, que se traslada de un lugar a otro; pero los fotones virtuales, que existen durante un tiempo demasiado breve como para ser medidos, son los portadores de la fuerza electromagnética. Naturalmente, los físicos han deducido que las otras tres fuerzas también deben ser transportadas por partículas virtuales. Estas no pueden
por definición ser detectadas en su papel de portadoras de fuerza, pero al igual que los fotones, deben existir en forma «real» trasladándose como un nuevo tipo de radiación.
Según la teoría de Steven Weinberg y Abdus Salam, que relaciona las fuerzas débil y electromagnética, el fotón sólo es uno de una familia de cuatro. Difiere de sus hermanos en que no posee masa, y ésta es la razón por la que las fuerzas eléctricas y magnéticas operan sobre distancias muy largas. Las otras tres partículas de la fuerza débil tina llamada «Z», y dos llamadas «W») son pesadas, probablemente unas 70 veces más pesadas que el protón, y la teoría muestra que esto las restringiría a los alcances mucho más cortos que sabemos que tiene la fuerza débil.
Así pues, los físicos compiten actualmente en la búsqueda de las partículas W y Z, que, lógicamente, deberían encontrarse en los aceleradores de muy altas energías que se proyectan ahora en Europa y en los Estados Unidos.

Demostración generada por ordenador de las partículas que brotan de una aniquilación en el MAC, que confirma la existencia de partículas «encantadas». En par quark encantado-antiquark se desintegra en dos pares quark encantado-quark arriba (muones D) y el último se desintegra en dos conjuntos de partículas designadas por 1 y 2. El neutrino (arriba izquierda) se infiere, pues escapa sin afectar a ninguno de los detectores.
No serán éstas nuevas partículas que añadir a la colección, sino que sus propiedades darán cuenta a los físicos del grado de exactitud a que se ha llegado en la unificación de las fuerzas electromagnética y débil, nuestra etapa actual en la unificación de las fuerzas de la Naturaleza.
§. Cola fuerte para los quarks
También en la fuerza fuerte median partículas hipotéticas, correcta pero inelegantemente denominadas gluones. Los gluones agrupan a los quarks de tres en tres para constituir los bariones, como el protón o el neutrón; y pueden también mantener unidos pares quark-antiquark, como los mesones. No parece probable que aparezcan gluones libres en los actuales experimentos de física de partículas, pero los físicos han conseguido aprender mucho acerca de los quarks y de sus gluones asociados a partir di* las propiedades de estos grupos de quarks fuertemente ligados, las viejas «partículas fundamentales».
La fuerza fuerte es realmente muy fuerte, al menos hasta el punto que se ha demostrado que es imposible extraer un quark de un barión oponiéndose a ella. En 1977 hubo una conmoción al creerse que los físicos habían detectado quarks «libres» en pequeñas bolas metálicas (sobre la base de que tenían cargas eléctricas menores que la del electrón), pero posteriores experimentos más sensibles no confirmaron esos resultados. Hay en verdad razones teóricas para pensar que los quarks no pueden existir aislados.
Dentro de un protón —u otro barión, los quarks parecen vivir existencias claramente independientes. Anteriormente hemos mencionado cómo electrones de alta velocidad pueden señalar con precisión tres «centros de masa» dentro del protón. La fuerza fuerte parece actuar como un trozo de goma: cuando dos quarks están muy próximos se afectan muy poco entre sí; pero al intentar separarlos, la fuerza se hace cada vez más intensa. (Las demás fuerzas de la Naturaleza actúan al contrario: cuanto más próximas están las partículas, más intensas son las fuerzas electromagnética, débil o gravitatoria.) Este infrecuente comportamiento de la fuerza fuerte encaja realmente muy bien en la teoría que establece que los quarks permanecen agrupados de tres en tres por intercambio de «gluones virtuales». La teoría, llamada «cromodinámica cuántica», predice una familia de ocho gluones diferentes implicados en la fuerza fuerte.
La comprobación de la estructura de los bariones con electrones rápidos no muestra únicamente los tres quarks, sino que revela también que los gluones constituyen aproximadamente la mitad de la masa. Por tanto, la fuerza fuerte, además de mantener unidos los quarks, contribuye realmente con algo de sí misma a la partícula resultante. Un protón es tanto «cola» como quarks.
En otros experimentos, los físicos de partículas han investigado el funcionamiento interno de los protones haciéndolos colisionar. En la explosión de energía liberada salen despedidos, en direcciones opuestas, «chorros» de nuevas partículas y antipartículas; estudiando estos chorros, los físicos pueden decir algo acerca del comportamiento de los quarks en el interior de los protones originales. Una vez más, los resultados confirman satisfactoriamente las predicciones de los teóricos relativas a las cargas eléctricas y a los spines de los quarks.
Por tanto, la teoría de los quarks está viva y bien viva. Desgraciadamente, la teoría actual no precisa cuántas clases de quarks diferentes debiera haber. En la teoría original se necesitaban tres -arriba, abajo y extraño, mientras que el cuarto —encanto— se postuló pronto. Este fue realmente «descubierto» en 1974, en dos experimentos diferentes y casi simultáneos que valieron premios Nobel a los directores de los equipos, Burton Richter y Samuel Ting. Sus hallazgos, anunciados el 11 de noviembre, son afectuosamente recordados por los físicos de partículas como la «Revolución de Noviembre», ya que constituyeron no sólo un triunfo de la teoría de los quarks, sino que indirectamente apuntalaron la teoría de la unificación de la fuerza electromagnética débil.
El «descubrimiento» del quark encantado no quiere decir que se obtuviera en el experimento un único quark aislado. La partícula se encontró realmente como combinación de un quark encantado y un antiquark encantado como un tipo de mesón. No se la pudo explicar como una combinación de los quarks conocidos, y posteriormente se, ha probado que la interpretación inicial era correcta.
En 1977 se repitió la historia cuando el físico americano León Lederman descubrió un nuevo mesón que no podía estar constituido por ninguno de los cuatro quarks conocidos; tenía que tratarse de un nuevo par quark-antiquark tal que, anteriormente, los teóricos habían denominado «fondo» o «belleza». La teoría sugiere que el número de quarks debería ser par, y ahora la búsqueda se dirige hacia el sexto tipo de «cima», o, más elegantemente, «verdad».
Así llegamos a la última de las fuerzas de la Naturaleza, la extremadamente débil y enigmática gravitación. Los físicos de partículas no pueden experimentar con la gravitación en el laboratorio, pues carece de efecto mensurable sobre las partículas. Sin embargo, teóricamente debería ser también el resultado de un intercambio de partículas virtuales en el que estaría implicada una partícula denominada «gravitón». La gravitación tiene algo de intruso entre las fuerzas en dos aspectos: siempre atrae y nunca repele; y la intensidad de la fuerza depende de la propiedad más fundamente] de un cuerpo, su masa. Independientemente de que la partícula esté eléctricamente cargada, o de que sea un quark o un leptón, la gravitación le afectará de la misma forma. Albert Einstein consideró que la gravitación era una fuerza especial, y la entendió como una distorsión del propio espacio; su teoría es aún la más útil para los astrónomos, como veremos en capítulos posteriores. Sin embargo, la gravitación también puede describirse como un intercambio de gravitones virtuales.
Lo que hace al gravitón diferente de las otras «partículas de fuerzas» el protón, las partículas W y Z y los gluones es su spin. Hemos mencionado anteriormente que la Naturaleza tiene una unidad básica de spin. Las partículas como los quarks y los leptones tienen, cada una, media unidad. Todas las partículas de fuerzas, aparte del gravitón, poseen una unidad de spin, esto es, en algún sentido tienen doble cantidad de giro alrededor de sus propios ejes. Cuando los quarks o los leptones intercambian estas «partículas de fuerzas», la teoría muestra que el spin de una unidad significa que «en tanto que» partículas (quarks y leptones) se repelerán entre sí, como sabemos que sucede en la práctica. Sin embargo, cada gravitón posee dos unidades de spin; y tales partículas generarán siempre una fuerza atractiva con una intensidad dependiente de la masa del cuerpo. La teoría de los físicos de partículas puede explicar las insólitas propiedades de la fuerza gravitatoria simplemente mediante el alto valor del spin de las partículas virtuales (gravitones: que se intercambian.
Puede llegar a creerse que otorgamos excesivo énfasis a algo tan trivial como el spin, pero esta cantidad tiene una influencia sorprendentemente importante en física fundamental. Las partículas con spin un medio (quarks y leptones) jamás pueden existir en la proximidad de otras partículas semejantes de idénticas propiedades. Por esta razón, los electrones que se hallan en órbita en torno al núcleo de los átomos no se amontonan en la órbita más interna, sino que una vez que ésta está cubierta (con dos electrones de spines opuestos), el siguiente electrón debe situarse en una órbita más externa. Así se origina la compleja estructura externa de los átomos, que da lugar a sus diferentes propiedades químicas.
No obstante, las partículas con «spin uno» o «spin dos» prefieren agruparse. Desde este punto de vista, un haz de láser es una agrupación de fotones exactamente idénticos y todos con la misma energía.
Así pues, el mundo de los físicos está poblado por partículas de spin un medio, las de las familias de los quarks y de los leptones, así como por otras de spin entero que tienen sus propias leyes. El intercambio entre los quarks y los leptones de rápidas e invisibles partículas «virtuales» origina las fuerzas de la Naturaleza. Al menos una, el fotón, existe como partícula propiamente dicha; y con aceleradores de partículas potentes, deberán comenzar a revelarse los gluones y las partículas W y Z.
Podemos ver las estrellas porque son luminosas. Pero la luz es sólo la parte visible del espectro electromagnético, que incluye entre otras a las ondas de radio y a los rayos X. No obstante, también la ciencia puede «verlas».

Los resplandecientes velos de las auroras, boreal y austral se originan en partículas cargadas eléctricamente procedentes del Sol, que chocan con la atmósfera superior de la Tierra siguiendo el campo magnético terrestre.
§. Ondas de color
§. Energía en paquetes
§. La información de la luz de las estrellas
§. Los láseres
§. Las ondas más largas
§. Relativamente próximas a la luz
§. Radiaciones exóticas
El cielo nocturno es una bóveda oscura, cuajada de miles de diminutas joyas centelleantes cuya luz proporciona al astrónomo infamación acerca de las profundidades del espacio.
Desde siempre ha fascinado al hombre la existencia de estas luces en el cielo, y no es casualidad que la astronomía sea la más antigua de las ciencias. El movimiento de algunas de las luces más brillantes los planetas, que significa «viajeros» en griego—, seguido semana tras semana, condujo al conocimiento de nuestro sistema solar; y la identificación de otras estrellas como distantes soles ayudó a los hombres a comprender la inmensidad del Universo. Descifrar el mensaje de la luz procedente de las estrellas es para los astrónomos actuales de interés primordial, ya que, a excepción de las sondas espaciales enviadas a los planetas, han sido la luz y otras radiaciones electromagnéticas que recibimos en la fierra las únicas vías de acceso al conocimiento del Universo.
La invención del telescopio sacó a la astronomía de su Edad de Piedra. Aunque no puede asegurarse quién inventó realmente el primer telescopio de dos lentes, su principio fue descubierto probablemente de forma independiente por varios ópticos, a finales del siglo XVI, cuando se fabricaron las primeras lentes suficientemente buenas como para obtener imágenes nítidas al ser dispuestas en forma de telescopio. Sin embargo, no cabe duda de que el célebre científico italiano Galileo fue el primer hombre que realizó frecuentes observaciones astronómicas con el nuevo instrumento, obteniendo resultados espectaculares, como el de los cráteres redondos de la Luna, las pequeñas lunas que se hallan en órbita en torno a Júpiter y el descubrimiento de los planetas como globos en vez de como puntos luminosos.

Sir Isaac Newton fue el primero en construir un telescopio de reflexión utilizando un espejo curvo, en vez de una lente para recoger y enfocar la luz. Este es su segundo modelo, de 1671: el espejo del extremo inferior refleja la luz al ocular por medio de un pequeño espejo inclinado.
Aun cuando el primer telescopio de Galileo tenía unos treinta aumentos, probablemente no proporcionaba más detalles que unos prismáticos modernos con lentes muy superiores, todo el mundo sabe que un telescopio aumenta el tamaño aparente de los objetos distantes, pero no es esto lo que le interesa fundamentalmente al astrónomo moderno; el problema real con que se tiene que enfrentar es el del «parpadeo». Esta constante titilación de las estrellas se debe exclusivamente a que la atmósfera de la fierra está en continuo movimiento. La luz procedente del exterior sufre constantes desviaciones y cambios, y, así, la imagen de una estrella vista con un telescopio de gran aumento está continuamente moviéndose y oscilando. Cuando se observa un planeta, la luz reflejada desde cada porción de su superficie varía, y la imagen aparece continuamente distorsionada. Es algo parecido a mirar el fondo de una piscina desde arriba cuando el agua está perturbada por la presencia de los bañistas. Ocasionalmente, existen breves momentos en los que es posible observar a través del aire en calma, y el observador entrenado tiene que memorizar todos los detalles que le sean posibles en ese raro y mágico momento de «buena visibilidad». Aun así, la visibilidad de una noche media sólo permitirá la utilización de unos cuantos cientos de aumentos.
En realidad, hoy día los astrónomos profesionales no suelen mirar por el telescopio, ya que el ojo humano no es un buen instrumento de observación. Las fotograbas presentan varias ventajas importantes, y un telescopio de un observatorio profesional se utiliza en la actualidad casi exclusivamente como cámara astronómica. Un telescopio así utilizado es idéntico, en cuanto a disposición óptica, a la lente de (ocal larga o teleobjetivo de los fotógrafos, con las únicas diferencias del tamaño y de que en los grandes telescopios modernos se usa un espejo, en lugar de una lente, para concentrar la luz.
Las placas fotográficas almacenan toda la luz que incide sobre ellas, y así, a diferencia del ojo, registran objetos más débiles mediante exposiciones de larga duración, constituyendo un registro permanente que los astrónomos pueden estudiar en cualquier instante. Uno de los inconvenientes más serios del ojo es la distorsión subjetiva que se produce de modo insensible cuando forzamos el límite de visibilidad; los «canales» de Marte son quizás uno de los primeros ejemplos del ojo engañando al cerebro.
Si el aumento no es particularmente importante, ¿por qué construyen los astrónomos enormes telescopios como el de 5 metros de diámetro de Monte Palomar, o el soviético de 6 metros del Observatorio de Astrofísica Zelenchukskaya? La respuesta, simplemente, dice que un telescopio grande concentra más luz que uno pequeño. La mayor parte de los objetos de especial interés en astronomía moderna, que aparecen muy débiles dada la gran distancia a que se encuentran, deben estudiarse usando grandes telescopios que recojan mucha más luz.

El telescopio refractor de 71 centímetros del Real Observatorio de Greenwich es el más grande de Gran Bretaña y el séptimo del mundo. Los refractores han de limitarse a lentes menores de aproximadamente 1 metro, pues otras mayores se combarían bajo su propio peso.
Una fotografía tomada con un gran telescopio muestra realmente menos detalles de los objetos brillantes que los que puede ver el ojo con el mismo telescopio, debido a que durante los minutos de exposición los momentos de buena visibilidad quedan cubiertos por la normal oscilación de las imágenes que emborrona los detalles más finos. Las perspectivas futuras tienden a mejorar esta situación; ya se ha probado un espejo pequeño y flexible, cuya distorsión contrarresta la de la atmósfera y ofrece imágenes más nítidas. Más curiosa incluso es la técnica denominada de «interferometría de espectro», en la que se fotografía con exposición muy corta, gracias a un intensificado electrónico, la distorsión atmosférica real de una estrella. Al procesar una serie de estas fotografías en un ordenador, se eliminan las distorsiones. De esta forma se pueden «resolver» estrellas dobles muy próximas y conseguir que algunas estrellas gigantes más cercanas no aparezcan como puntos de luz, sino como discos.
Sin embargo, el mayor avance llegará con el telescopio espacial que se pondrá en órbita en la década de 1980. Al estar por encima de la atmósfera, será capaz de fotografiar detalles diez veces más pequeños que los observables con telescopios terrestres, y, asimismo, permitirá estudiar objetos más débiles, libres del contenido del fondo de luz de la atmósfera, que enturbia las fotografías astronómicas terrestres durante las largas exposiciones.
§. Ondas de color
El filósofo francés positivista Augusto Comte declaró, en 1835, que existen ciertos hechos que la ciencia es incapaz de esclarecer, y eligió como ejemplo de ello la constitución de las estrellas. Desde luego, no es evidente que incluso con grandes telescopios y sensibles detectores podamos aprender mucho acerca de la composición de las estrellas. Sin embargo, el ejemplo de Comte no es aceptable en la actualidad, ya que desde entonces los científicos han ahondado más profundamente en los milagros de la propia luz. Comte ignoraba que la luz de una estrella nos dice no sólo donde está, sino también su composición, su temperatura, la intensidad de su gravitación, el rápido movimiento de gases en su superficie y a qué velocidad se acerca o se aleja de nosotros. Para comprender esto debemos examinar la naturaleza de este sutil «mensajero celeste» citando el título del trabajo más célebre de Galileo).
La luz se desplaza como onda en movimiento. El científico inglés Thomas Young, alias «El Fenómeno», entre cuyas habilidades se incluían las de ser funambulista y el primer traductor de algunos símbolos jeroglíficos de la Piedra de Rosetta, demostró en 1801 que los rayos luminosos pueden a veces cancelarse entre sí, generando oscuridad. La única forma de explicar este problema era suponer a la luz como una especie de onda viajera, de forma que a veces las «crestas» de un rayo de luz pueden coincidir con los «valles» de otro. El efecto resultante es una cancelación del movimiento de la onda, tal como ocurre con las olas del océano, que, al aproximarse desde distintas direcciones a un promontorio, pueden dejar pequeñas zonas de agua no perturbadas en el lugar donde coinciden.
La teoría ondulatoria fue confirmada por el físico escocés James Clerk Maxwell, quien demostró que la naturaleza «ondulatoria» de la luz se debía simplemente a la variación de campos eléctricos y magnéticos. Al englobar todas las observaciones de los fenómenos eléctricos y magnéticos en una única teoría electromagnética, verificó que las ecuaciones predecían un tipo de radiación consistente en campos eléctricos y magnéticos en movimiento. La velocidad que calculó para está radiación era exactamente la misma que la velocidad de la luz medida anteriormente. Cálculos posteriores no dejaron lugar a dudas: la luz es radiación electromagnética. Por ejemplo, lodos sabemos que los rayos de luz se «desvían», es decir se refractan, cuando pasan de una sustancia transparente a otra, como del aire a una lente, o del vidrio al agua.

El haz de luz procedente de la rendija de la pantalla (línea negra del centro) se descompone en los calores del arco iris, ya que sus longitudes de onda se separan al reflejarse en los finos surcos de la red de difracción (derecha).
A partir de la teoría de Maxwell, este resultado se explica por entero: los electrones del sólido interaccionan con e] campo eléctrico ondulatorio del rayo luminoso y cambian de dirección.
Si la luz es una onda, debe de poseer longitud de onda. La longitud de onda de una ola del océano es la distancia entre una cresta y la siguiente; para la luz, es la distancia entre una cresta del campo eléctrico y la siguiente; aunque no resulte de sencilla visualización, es así. La radiación que llamamos luz consta, en realidad, de diversas longitudes de onda; de hecho, verificamos esto cotidianamente, ya que la sensación de color proviene de las diferentes longitudes de onda. La luz roja es la de mayor longitud de onda que nos es dado ver. Su distancia entre dos crestas sucesivas es de 700 millonésimas de milímetro (700 nanómetros). Las longitudes de onda ligeramente más cortas, de aproximadamente 560 nanómetros, se perciben amarillas. Las del orden de 500, verdes; mientras que las más cortas que podemos ver son azules y violetas alrededor de 420 y 400 nanómetros respectivamente). Las de longitud de onda intermedia se ven como colores intermedios, tales como naranja o verde azul.
Esta secuencia de colores —rojo-anaranjado-amarillo- verde-azul y violeta nos resulta familiar: es el orden de los del arco iris. Las gotas de agua del aire pueden separar los colores de la luz «blanca» (mezcla de todas las longitudes de onda visibles) y desplegarlos cual un espectacular arco en el cielo. En cualquier caso, cuando la luz se refracta al propagarse por sustancias transparentes distintas, las longitudes de onda son desviadas bajo ángulos ligeramente diferentes y se despliegan como un abanico de colores.
De esta forma, podemos estudiar la luz procedente de cualquier objeto —sea la de una lámpara o la de una estrella-— haciendo que pase a través de un bloque transparente apropiado. El más simple es un prisma triangular de vidrio, y a la distribución de colores que se obtiene en el lado opuesto se le denomina espectro de la fuente luminosa.

Por técnicas de espectroscopía se puede intensificar enormemente la ligera desviación de un haz luminoso que pasa a través de irregularidades en el aire. Con el empleo de filtros adecuados las irregularidades aparecen coloreadas, como en esta perturbación originada por una bala que pasa sobre la llama de una bujía.
Aun cuando un prisma es el dispositivo más sencillo para obtener un espectro, parte de la luz es absorbida por el vidrio. Puesto que los astrónomos trabajan normalmente con objetos débiles, prefieren despilfarrar menos luz descomponiéndola con una red de difracción. Sobre la superficie de una red se han grabado trazos paralelos extremadamente finos, del orden de 500 por milímetro, que actúan como diminutos reflectores. Los rayos de luz reflejados se cancelan unos con otros crestas con valles en todas direcciones, excepto en una que depende de la longitud de onda, por lo que a la salida de la red aparece la luz blanca descompuesta en su espectro de colores, incidentalmente, algunas piezas de «joyería», o colgantes decorativos, se fabrican actualmente con su superficie similar a la de una red; así, aun cuando aparentemente parezcan una superficie plana metálica, al moverse reflejan los distintos colores.)
Prestemos ahora atención al espectro de una estrella típica, el Sol. Para comprender su mensaje, hemos de admitir el hecho de que nuestro ojo es sensible en mayor grado a la luz amarilla, y que esta sensibilidad disminuye para las longitudes de onda más largas, las rojas, así corno para las más cortas, las azules. Aun así, mediciones precisas muestran que el espectro del Sol es más brillante alrededor de-la región del amarillo-verde, en los aproximadamente 520 nanómetros. No obstante, no todas las estrellas siguen este modelo. Así, la estrella roja Betelgeuse, en la constelación de Orion, es más brillante para las longitudes de onda situadas más allá del extremo rojo del espectro, o sea la zona de longitudes de onda muy largas denominada infrarrojo. Su luz visible se concentra hacia el extremo rojo y, por tanto, éste es el color en el que parece brillar. La otra estrella brillante de Orion, Rigel, tiene su pico espectral en las longitudes de onda muy cortas, o sea en la región ultravioleta -radiación invisible más allá del violeta en el espectro, y por ello su luz visible es predominantemente azul-violeta, un color poco sensible para nuestros ojos. Aunque todas las estrellas emiten en todas las longitudes de onda de la luz visible, la apariencia coloreada, —rojiza para Betelgeuse y azul para Rigel depende de cómo esté distribuida la energía radiante en el espectro.
Podemos entender fácilmente los colores de las estrellas como una consecuencia de su temperatura, según vimos en el capítulo 2; de la misma forma en que, debido a su temperatura, un atizador en el fuego se ve rojo, la forja del herrero aparece amarilla, y el bulbo de una lámpara, amarillo-blanquecino. Aun cuando creamos que tanto los bulbos de las lámparas como el Sol tienen un brillo blanco-amarillento, los primeros se hallan a mucha menor temperatura y, en consecuencia, tienden a ser más anaranjados. Si se comparan los colores de una lámpara y del Sol, bien directamente, bien mirando una fotografía en color bajo luz artificial, la diferencia es sorprendente.
Los físicos han estudiado con suma atención objetos cuya emisión proviene simplemente del hecho de hallarse calientes; los designan con el perverso nombre de «cuerpos negros». En rigor de verdad, el cuerpo negro de los físicos es ideal. Es un cuerpo que absorbe toda la radiación que incide sobre él sin reflejar ninguna. Una chimenea ennegrecida de hollín es lo más parecido a un cuerpo negro, pero incluso ella no absorbe perfectamente la luz.

Pueden registrarse simultáneamente los espectros de muchas estrellas colocando un delgado prisma sobre el objetivo de un telescopio. Todos estos espectros tienen finas líneas oscuras de absorción, pero un examen cuidadoso muestra ligeras diferencias debidas a las distintas temperaturas de las estrellas.
Los físicos piensan más bien en el interior de una gran caja con un diminuto agujero: cualquier radiación que pase a través del agujero será probablemente absorbida por las paredes interiores antes de reflejarse las veces suficientes como para encontrar otra vez la salida por el agujero. Si la caja se calienta, el interior se pondrá incandescente, y, entonces, la radiación emitida a través del agujero puede depender sólo de su temperatura, y no de la radiación incidente.
Al medir la radiación luminosa emitida por dichas cajas negras, los físicos encuentran que estas fuentes incandescentes de luz emiten todas las longitudes de onda de la luz, pero radian más intensamente en algunas zonas del espectro, tal como los astrónomos comprueban que sucede en las estrellas. La longitud de onda de este «pico» de emisión es más corta para cuerpos cada vez más calientes.
Así pues, estos estudios en el laboratorio relacionan la longitud de onda del máximo de luz con las temperaturas medidas, y los astrónomos «toman» en la actualidad la temperatura a las estrellas comparando su intensidad espectral para dos longitudes de onda, generalmente la del amarillo-verde y la más corta del azul, e interpretan los resultados en términos de la radiación del cuerpo negro de los físicos.
§. Energía en paquetes
A la vuelta del siglo, los astrónomos podían establecer por qué algunas estrellas son rojas, otras amarillas y algunas azules, en función de sus diferentes temperaturas. No obstante, los físicos teóricos estaban desorientados acerca de los resultados obtenidos con los experimentos del cuerpo negro. La aparentemente sencilla observación de que un cuerpo «caliente» emite en el rojo, y otro más caliente en el amarillo, fue el inicio de una revolución que hizo tambalear algunos de los fundamentos de la física establecida. Esta nueva teoría cuántica fue tan importante como la famosa teoría de la relatividad al establecer una perspectiva científica moderna del Universo.
El primer físico que investigó en la teoría de la emisión del cuerpo negro fue el eminente científico Victoriano lord Rayleigh. Inspirándose en todos los axiomas básicos de la física de su época llegó, mediante cálculos rigurosos, a una conclusión que discordaba de modo casi total con los resultarlos experimentales y con la experiencia cotidiana.
Rayleigh utilizó sus cálculos para «probar» que un cuerpo, independientemente de que esté frío o caliente, emite la mayor parte de su luz en la región de las longitudes de onda muy cortas, mucho más cortas que las de la luz visible; lo que, en apariencia, era completamente imposible, puesto que los espectros mostraban un pico de intensidad en la zona de las longitudes de onda visibles. Claramente, la teoría era errónea, a pesar de que Rayleigh había basado sus cálculos en los firmes fundamentos de las leyes científicas establecidas.
El físico alemán Max Planck se empeñó en resolver este problema, bautizado como «la catástrofe ultravioleta», reduciéndolo al hecho sencillo de que, en «física clásica», cada longitud de onda larga puede producirse por asociación de un número infinito de longitudes de onda más corlas. Los estudiantes de música saben que una nota baja en el piano da lugar a series completas de armónicos de tono más alto (longitud de onda más corta); y el caso de la luz supondría algo similar. Planck tuvo que encontrar el modo en que la Naturaleza limita el número de longitudes de onda cortas que realmente produce un cuerpo negro, y propuso una audaz sugerencia que no chocara de manera excesivamente violenta con las bien establecidas leyes de la física. Supuso que allí donde se emite una onda de luz, la energía calorífica tiene que exceder de un cierto umbral particular, y que cada longitud de onda tiene distinto umbral, de forma que las longitudes de onda más cortas necesitan una mayor energía para poder emitirse. Así, la superficie del cuerpo negro emite con bastante facilidad longitudes de onda largas, para lo que sólo serían necesarias bajas energías. Para otras longitudes de onda ligeramente más cortas, la intensidad de la radiación empezaría a aumentar según la ley de lord Rayleigh. Pero como vemos según el nuevo principio de Planck, para longitudes de onda aún más cortas advertimos que su emisión necesita una concentración de energía muy alta. El cuerpo negro encuentra dificultades para emitir estas longitudes de onda cortas, y, por tanto, la intensidad empieza a disminuir de nuevo para las longitudes de onda cortas del extremo del espectro. Debe existir en alguna parte del espectro un pico cuya longitud de onda dependa de la temperatura del cuerpo negro. La teoría de Planck concordaba con los experimentos, y la física pareció salvada sin tener que sacrificar ninguno de sus principios básicos.
Pero incluso el mismo Planck no advirtió la magnitud de la revolución que había generado al asociar una energía a la radiación de una cierta longitud de onda. Pensó que era algo peculiar la forma en que un cuerpo caliente emite una onda de luz. Fue Albert Einstein quien intuyó la comprobación de que ciertas experiencias, en las que la luz arrancaba electrones de superficies metálicas, ampliaban la teoría de Planck hasta convertirla en una auténtica revolución. Einstein señaló que, debido a una cierta concentración umbral de energía en el cuerpo negro, la longitud de onda que se emite transporta consigo una determinada cantidad de energía.

Los láseres proporcionan el método mas preciso de medir la distancia a la Luna. El estrecho haz de láser (azul) se refleja en los reflectores depositados sobre la superficie lunar por naves espaciales tripuladas o no tripuladas—, y la luz que retorna se detecta por medio del telescopio (a continuación del láser) tras su viaje de ida y vuelta de unos 750.000 kilómetros.
Al iluminar una superficie metálica, la onda luminosa suministra precisamente esta energía; y, si las condiciones son favorables, puede arrancar un electrón. La luz, entonces, no es únicamente una onda. La luz se desplaza en forma de paquetes de energía individuales.

El espectro electromagnético completo, del cual la luz es apenas una pequeña parte. Los tipos de radiación difieren fundamentalmente sólo en su longitud de onda, que se muestra en la escala inferior (1 nm = una millonésima de milímetro). Las definiciones se solapan ligeramente, y las ondas de radio (derecha) se han dividido aquí en las bandas convencionales de radiodifusión. En la figura intercalada, las líneas negras muestran cómo se distribuyen en el espectro las radiaciones de un cuerpo caliente. Un cuerpo a 6.000 ℃ (como el Sol) emite fundamentalmente luz visible, mientras que un objeto a 2.000 ℃ emite principalmente radiación infrarroja.
Se acuñó el término quantum (del latín «¿cuánto?») para designar estos paquetes de energía; y la revolución de Planck-Einstein surgió en forma de la denominada teoría cuántica.
Un paquete de energía que permanece compacto cuando se desplaza a través del espacio es, en esencia, una nueva clase de partícula; y el cuanto de luz se llamó fotón. La teoría cuántica es una forma más completa de contemplar el mundo, ya que exige que la luz sea partícula y onda. A veces la energía está concentrada en un punto, lo que sólo es característico de una pequeña partícula; otras, la luz puede cancelarse con luz dando franjas oscuras, efecto indudablemente ondulatorio. Pero esta perplejidad sobre la dualidad «onda-partícula» se halla en verdad en nuestra propia mente: esto sucede sólo cuando pretendemos pensar acerca de algo tan extraño como la luz en términos cotidianos de lo tangible, proyectiles u olas. Los físicos pueden escribir ecuaciones que describan cómo se comporta la luz cuando incide sobre un metal susceptible de perder electrones, o sobre una red de difracción. En el primer caso, la solución de las ecuaciones muestra que la luz se comporta como si fuera una partícula; y en el segundo, como si fuese una onda. No existe de esta forma ninguna contradicción a nivel de las ecuaciones básicas, pero es imposible entenderlo en términos coloquiales.
§. La información de la luz de las estrellas
Al mirar los detalles más finos del espectro del Sol, o de otras estrellas, pueden observarse líneas oscuras muy estrechas en su despliegue de colores. Corresponden ellas a longitudes de onda específicas, en las que la superficie de la estrella no emite luz, contradiciendo la idea de Comte de que nada podemos conocer acerca de la estructura de las estrellas. Por cierto, los científicos llegaron a la conclusión de que, algunos años después de su muerte, cada elemento químico emite un único conjunto de longitudes de onda, que constituyen su huella digital espectral. Igualmente, los astrónomos han descubierto que las longitudes de onda oscuras de los espectros de las estrellas corresponden a longitudes de onda de luz emitidas por determinados elementos, tales como el hidrógeno y el sodio cuando se estudian en el laboratorio. El elemento helio fue el primero en detectarse a partir de un conjunto de líneas no identificadas del espectro solar, cuarenta años antes de ser aislado en la Tierra.
Cuando se descubrió la estructura del átomo, a principios del siglo XX, pudo explicarse fácilmente la huella digital que distinguía a cada elemento.

En holografía, el haz procedente de un láser (derecha) se divide en dos, uno de ellos, reflejándose en el espejo, se incide en la placa fotográfica (próxima a la izquierda); el otro ilumina el objeto que se pretende registrar, y la luz reflejada por él incide también sobre la placa. Si se ilumina la placa procesada (un holograma) con un haz de láser, se produce una imagen tridimensional del objeto original.
Cada elemento muestra una disposición de electrones diferente a su alrededor que origina sus propiedades químicas únicas. Pero los electrones sólo pueden moverse en determinadas órbitas, debido a las restricciones actuales de la teoría cuántica. Si un electrón que se mueve en una órbita alejada del núcleo quiere «descender» a un nivel de menor energía, o sea a una órbita menor, ha de ejecutar un «salto». Los movimientos de los electrones de órbita en órbita dan lugar a saltos, cada uno de los cuales conlleva una cantidad exacta de energía. Si un electrón salta hacia el núcleo, la energía se emite como un fotón de luz de esa misma energía, y en el espectro aparece como luz de la correspondiente longitud de onda. De la misma forma, Cuando el átomo se ilumina con luz de todas las longitudes de onda, un electrón en esta órbita más baja puede absorber esta longitud de onda particular y emplear esta cantidad de energía para saltar precisamente hasta la órbita «superior».
Un gas caliente bien sea en el laboratorio, en una lámpara callejera o en forma de nube en el espacio está constituido por átomos que colisionan de continuo a altas velocidades. Estas colisiones llevan a sus electrones a órbitas superiores; cuando éstos descienden, mediante un salto, emiten ondas de luz cuyas «huellas digitales» constituyen el espectro de emisión consistente sólo en líneas brillantes sobre un fondo oscuro. Sin embargo, la superficie de una estrella es diferente. La radiación del cuerpo negro, procedente de su superficie, atraviesa las capas más altas y más frías de su atmósfera, y allí los electrones de los átomos seleccionan los fotones de luz que pueden llevarles hasta órbitas mayores. Así pues, el espectro original del cuerpo negro de la estrella, que contiene todos los colores, queda desprovisto de algunas longitudes de onda específicas que aparecen como líneas oscuras de absorción en el fondo continuo brillante del espectro.
Al identificar las longitudes de onda de estas líneas oscuras, los astrónomos pueden descubrir los distintos elementos que componen la estructura de las capas más externas de la estrella. Además, los tipos de líneas nos informan acerca de su temperatura. A altas temperaturas, los átomos colisionan con mayor fuerza, alterando su distribución electrónica y, a veces, hasta expulsando electrones fuera del átomo. En cualquier caso, las líneas espectrales emitidas cambian, en intensidad o longitud de onda, y los astrónomos pueden medir la temperatura, bien a partir de las líneas espectrales, bien a partir del color total de la estrella, satisfaciendo sus expectativas cuando ambos métodos concuerdan.
La forma detallada en que las líneas oscuras de una estrella se intensifican hacia sus longitudes de onda centrales, suministra a los astrónomos información acerca de la gravitación superficial de la estrella, así como de la turbulencia existente en las capas más externas. Pero cuando se mide con precisión la longitud de onda central de una línea, la misma nunca coincide exactamente con la longitud de onda que los físicos encuentran para igual línea en el laboratorio. Para una estrella cualquiera, todas las líneas espectrales están desviadas muy ligeramente, bien hacia las longitudes de onda más largas (rojas), bien hacia las más cortas (azules). El corrimiento de longitud de onda es fácilmente comprensible cuando se analiza la luz como una onda; el efecto fue investigado por vez primera por el físico austríaco Christian Doppler, hacia 1840, como una propiedad de las ondas sonoras.
A Doppler le intrigaba el hecho de que un sonido pareciese más agudo al moverse su fuente hacia nosotros, y más grave al alejarse. En nuestra vida cotidiana notamos el descenso del tono de las sirenas de un coche de la policía, o de una ambulancia, cuando pasan ante nosotros. Una vez que elaboró la teoría, Doppler pasó a comprobarla. Para ello dispuso una orquesta de trompetistas tocando notas diferentes en un vagón abierto de un tren que debía ser arrastrado, a diferentes velocidades, por delante de un grupo de músicos que interpretasen con el tono correcto. La teoría predecía una relación sencilla entre el tono interpretado, el escuchado y la velocidad del tren; pues bien, este exótico experimento demostró que su teoría era correcta. Cuando los trompetistas vienen hacia nosotros, las ondas sonoras, al no poder desplazarse a velocidad mayor que la normal del sonido en el aire, se «agrupan», y escuchamos el sonido como una longitud de onda más corta (tono más alto); mientras que cuando se alejan, dado que el sonido no puede viajar más lento, la nota «se alarga» hasta una longitud de onda mayor (tono más bajo). Así sucede con la luz: si una estrella se aleja de nosotros, las ondas de luz se alargan, y todas las líneas espectrales se desplazan hacia el rojo; mientras que si la estrella se acerca, hay un corrimiento hacia el azul. La extensión de la teoría original demostrada por los trompetistas del tren permite, en la actualidad, que los astrónomos midan la velocidad real con que una estrella se acerca o aleja de nosotros.

El radiotelescopio de 64 metros de diámetro de Parkes, en Nuevo Gales del Sur, detecta débiles señales de radio procedentes del espacio. Las radioondas se reflejan desde la gran parábola hasta la sensible antena del cajón superior. Las ondas de radio, procedentes de cuerpos astronómicos, suministran a menudo más información que la luz que emiten.
§. Los láseres
Hay un efecto interesante de la naturaleza ondulatoria de la luz que ha revolucionado el mundo en los últimos años: el láser. Un haz de láser es bastante potente como para atravesar láminas de acero y ladrillos. Es suficientemente estrecho como para incidir sobre los reflectores instalados por los astronautas en la Luna, y tiene potencia capaz de lograr que la reflexión sea visible después de 750.000 kilómetros entre ida y vuelta. Por otra parte, la luz láser tiene la extraña propiedad de la «coherencia», que nos permite registrar fotografías en tres dimensiones. Aun a pesar de sus connotaciones espacio-temporales, la teoría subyacente fue elaborada hace sesenta años por el genio mundial, Albert Einstein.
Einstein estaba interesado por entonces en relacionar la fórmula de la radiación de Planck con la nueva teoría de las órbitas electrónicas de los átomos; y demostró que los electrones deben efectuar tres tipos de saltos. Los físicos sabían ya que los electrones pueden absorber fotones de luz para saltar a niveles más altos, y que podían emitir radiación espontáneamente al descender. Einstein descubrió otro tipo de salto hacia abajo, que tiene lugar cuando llega al átomo un fotón con la energía exacta de ese posible salto. El electrón que se encuentra en la órbita de alta energía experimenta la «estimulación» del fotón incidente, y de inmediato salta hacia abajo emitiendo un fotón exactamente igual al que ocasionó la estimulación. Este fenómeno fue prácticamente ignorado durante cuarenta años. Pero cuando Charles Townes, físico americano, perfeccionó un dispositivo para producir ondas de radio intensas por un proceso similar (el máser), los científicos se apresuraron a perfeccionar la contrapartida óptica: una fuente de luz intensa. Adelantándose ligeramente a todos, el científico americano T. H. Maiman elaboró con éxito el primero de tales dispositivos en 1960, y desde entonces se han construido y comercializado muchas versiones del mismo.
En principio, la teoría es bastante simple. Primeramente, los electrones de los átomos que constituyen el cuerpo del dispositivo (un cilindro de rubí artificial en el caso de Maiman) deben llevarse a las órbitas de alta energía. La energía necesaria se puede proporcionar iluminándolo con luces muy intensas o con corrientes eléctricas adecuadas. Una vez que la mayor parte de los electrones se hallen en estas órbitas, permanecerán allí un tiempo del orden de una diezmillonésima de segundo antes de que algunos caigan otra vez espontáneamente. Y, aquí, la aportación de Einstein se vuelve crucial, pues el fotón emitido en el brinco del electrón, al desplazarse a través de los átomos, estimulará a todos los electrones de alta energía a descender y a emitir fotones similares. Esta acumulación de luz puede amplificarse fácilmente, situando dos espejos en los extremos que obliguen a los fotones a moverse entre ellos a través del cristal, estimulando así a emitir cada vez a más electrones. La legión de fotones idénticos crece cada vez más; y se forma dentro del dispositivo un flujo de luz de una longitud de onda muy precisa. Esta luz puede liberarse, bien con un «obturador» electroóptico situado en un extremo, bien, simplemente, haciendo que uno de los espejos tenga reflectividad menor que el 100%. El flujo de fotones que emerge es un haz luminoso estrecho, muy intenso, y de una longitud de onda muy precisa.
El primero de estos dispositivos (llamados «láseres», siglas de Light Amplification by the Stimulated Emission of Radiation; proporcionaba un impulso de luz antes que los electrones hubieran vuelto a adquirir energía. Los modelos posteriores pueden producir un haz continuo de luz en vez de una serie de impulsos. Otro avance conseguido es el láser que puede «sintonizar» la longitud cié onda deseada, sin la limitación de los que la producen a partir de la emisión natural de los saltos electrónicos de determinados átomos. La tecnología sobre el láser continúa desarrollándose sin que se advierta su límite.
La intensidad de un haz de láser se debe, fundamentalmente, a que todas las ondas luminosas emitidas por los distintos átomos se hallan «en una relación fija de fase». El proceso de emisión estimulada garantiza que cada nuevo fotón coincida con el original, y aquí tenemos un excelente ejemplo del modo en que los físicos deben describir la luz en términos de onda-partícula para explicar los hechos naturales. A medida que el proceso láser continúa, todos los fotones terminan teniendo una relación fija de fase, al contrario que en una lámpara de luz ordinaria, en la que los fotones producidos son todos independientes, de forma que muchos de ellos cancelan sus crestas con los valles de otros fotones.
Ya que la luz láser tiene esta propiedad de «coherencia», podemos emplearla para tomar fotografías tridimensionales. En esta técnica, denominada holografía, se divide un haz de luz de láser en dos y se hace que uno de ellos incida sobre el objeto que se pretende fotografiar. Se coloca una placa fotográfica de forma que quede iluminada por el segundo haz del láser, y que recoja asimismo la luz reflejada procedente del objeto (sin ningún enfoque). Dado que el objeto ha modificado de una forma muy complicada las crestas y los valles de la radiación que se ha reflejado en él, encontramos en la placa fotográfica una intrincada figura de manchas claras y oscuras donde las luces reflejada y directa se han reforzado o cancelado entre sí.
Se quita la placa, se la revela, y si a continuación se ilumina con un haz del láser, aparece una imagen del objeto original en forma de un sólido tridimensional. Se lo puede mirar desde distintas direcciones y apreciar aspectos diferentes, como si fuera real. Los primeros hologramas se realizaron en un solo color, de forma que todo aparecía en un solo tono —a menudo en verde pálido—, pero ahora pueden lograrse hologramas de luz blanca que muestran colores muy parecidos a los reales. Muchos museos han considerado seriamente la sustitución de obras inapreciables por hologramas, que desde el punto de vista de la exhibición, aparecerían idénticos al original.
Los láseres tienen además importantes perspectivas comerciales y de investigación. Si se limitan pulsos de láser a un tiempo muy breve una billonésima de segundo, se pueden producir pulsos de enorme energía luminosa, mil billones de veces más intensos que la luz del Sol. Pulsos tan cortos y energéticos podrían finalmente ser la clave de la fusión de los núcleos de hidrógeno en helio, abriéndose así el camino para el aprovechamiento del hidrógeno de los océanos con- el fin de producir energía casi ilimitada.
A una escala menor, los hospitales comienzan ahora a utilizar láseres, en particular en cirugía ocular: un desprendimiento de retina, por ejemplo, se puede «soldar» in situ iluminando el globo ocular con pulsos de láser. También los astrónomos pueden medir el tiempo empleado por un pulso de láser en retornar a la Tierra después de haberse reflejado en los reflectores colocados en la Tuna, determinándose así, de forma precisa, la forma de la órbita lunar. De este modo, los láseres han acabado con algunos de los detractores de la teoría de la gravitación de Einstein tal como se verá en el capítulo 9).
§. Las ondas más largas
La luz está lejos de ser la única forma de radiación electromagnética. Hemos mencionado ya, dentro de las longitudes de onda más largas, al infrarrojo; y, en las longitudes de onda más cortas, al ultravioleta. La familia de las radiaciones «invisibles» se completa con las extremadamente largas ondas de radio y las longitudes de onda ultracortas denominadas rayos X y rayos gamma. Podas estas radiaciones son, en esencia, lo mismo. Podas se comportan simultáneamente como partículas y como ondas de campos magnéticos y eléctricos oscilantes, con la energía de un fotón dependiendo inversamente de la longitud de onda.
La razón de que las cataloguemos bajo denominaciones diferentes se debe, en realidad, a que las generamos y detectamos de distintas maneras. La radiación puede tener cualquier longitud de onda (y energía asociada, pero las unidades de materia, como los átomos, tienen tamaños y energías definidas; así pues, las distintas longitudes de onda interaccionan con la materia de formas diferentes. Por ejemplo, una onda luminosa es unas mil veces mayor que un átomo, pero tiene la energía conveniente como para trasladar un electrón de una órbita a otra; mientras que la longitud de onda de los rayos X es del tamaño del átomo, pero su mayor energía implica que puede extraer los electrones. A causa de estas formas de interacción diferentes, la historia de los descubrimientos de las distintas radiaciones difiere ampliamente. Las radiaciones invisibles situadas más allá de los extremos del espectro solar se descubrieron accidentalmente: con termómetros en el caso del infrarrojo, y con sales fotográficas que se oscurecían bajo la exposición en el del ultravioleta.

Una fotografía tomada con radiación infrarroja. Para el ojo, esta escena seria completamente negra, pero la radiación infrarroja («calor») procedente de las planchas puede detectarse con una película apropiada e «iluminar» el busto. Los astrónomos observan normalmente objetos distantes por la radiación no visible que emiten.
El físico alemán Heinrich Hertz descubrió las ondas de radio después de que se publicase la teoría de Maxwell, mientras que los rayos X y gamma fueron descubrimientos accidentales que tuvieron lugar, respectivamente, durante la investigación acerca de la conducción de los gases y acerca de la radiactividad.
Las más largas son las ondas de radio. Cualquier radiación electromagnética con una longitud de onda mayor que 1 milímetro es una onda de radio como las empleadas en telecomunicaciones. Los circuitos eléctricos en un transmisor ele radio obligan a los electrones a oscilar por un hilo transmisor o antena, y la continua aceleración y desaceleración de estas cargas eléctricas en movimiento produce un flujo continuo de ondas electromagnéticas desde la antena. La longitud de onda transmitida depende de la frecuencia a que están obligados a oscilar los electrones. Por poner otro ejemplo, un circuito eléctrico ordinario es una señal alterna que hace oscilar los electrones 50 veces por segundo, una frecuencia de 50 Hz. (el nombre completo de la unidad es «Hertz») en la jerga física. Cualquier instrumento eléctrico radia ondas electromagnéticas con la longitud de onda correspondiente de 6.000 kilómetros (hay una relación muy sencilla: longitud de onda × frecuencia = velocidad de la luz;, que pueden ser captadas por otros hilos próximos y que cualquier entusiasta de la hi-fi reconoce como un zumbido en su amplificador. (La corriente alterna típica es de 50 Hz en el Reino Unido, pero en Norteamérica es de 60 Hz. La radiodifusión ordinaria emplea frecuencias mucho más altas y longitudes de onda correspondientemente más cortas: son valores típicos los 900 kHz (900.000 Hz), los 330 metros en la banda de onda media; y los 90 MHz (90.000.000 Hz, 3,3 metros, en la banda de VHF. Las longitudes de onda más largas pueden desplazarse por grandes distancias alrededor del mundo lo que puede comprobarse fácilmente sintonizando la onda media por la noche—, ya que las ondas procedentes del transmisor que se desplazan hacia arriba se reflejan en la capa de electrones de la atmósfera superior de la Tierra.

Los objetos astronómicos pueden emitir la gama completa de radiaciones electromagnéticas, pero sólo la luz y las ondas de radio más cortas penetran en la atmósfera terrestre hasta el nivel del mar. Los astrónomos de infrarrojo trabajan en altas montanas, o desde globos o aviones; para las demás longitudes de onda se requiere un observatorio en órbita por encima de la atmósfera.
Esta ionosfera, de aproximadamente 300 kilómetros de altura, actúa como un espejo para las ondas de radio largas, que pueden reflejarse entre la ionosfera y la superficie de la Tierra cubriendo distancias sorprendentes (la mejora de la recepción por la noche tiene su origen en los cambios atmosféricos). Por el contrario, las ondas de VHF, muy cortas, pueden ser captadas únicamente por receptores más o menos alineados con el transmisor, ya que pasan, a través de la ionosfera, al espacio. A esta razón se debe que las estaciones de radio locales empleen más ondas VHF; cualquier programa VHF queda mucho más libre de interferencias indeseables con las estaciones de radio distantes.
Dado que la ionosfera es transparente para radiaciones más corlas que aproximadamente 30 metros, las ondas de radio de las fuentes naturales del espacio pueden penetrar hasta la fierra. Los radioastrónomos estudian esta radiación, del mismo modo que los astrónomos «ópticos» estudian la luz procedente del espacio, para ayudarnos a comprender lo que ocurre en las profundidades del Universo. Aquellos objetos celestes que son emisores naturales de radio son a menudo, en verdad, muy débiles en cuanto a la luz que sale de ellos; así pues, la radioastronomía ha descubierto, o llamado la atención, sobre potentes objetos que los astrónomos ópticos habían pasado por alto: los púlsares y los quásares son los mejor conocidos de ellos, lo que no significa que sean los únicos ejemplos en el medio siglo de historia de la radioastronomía.
Esta ciencia surgió accidentalmente cuando el ingeniero de comunicaciones Karl Jansky, de los laboratorios de la Bell Telephone, investigaba radio «estática» a principios de la década de 1930. Además del silbido de los truenos encontró «ruido» de radio que provenía del cielo. A partir de entonces, la radioastronomía avanza cada vez más. Se han construido radiotelescopios mayores y se han utilizado receptores más sensibles y ordenadores que analizan los resultados mucho más rápidamente que cualquier investigador humano. Un radiotelescopio trabaja igual que cualquier otro equipo de radio: básicamente, consta de una antena conectada a un receptor y a un amplificador. Pero la sensibilidad es el caballo de batalla del radioastrónomo. La cantidad total de energía recogida por todos los radiotelescopios del mundo durante la historia entera de la radioastronomía es menor que la que emplearíamos en volver esta página.
La palabra «radiotelescopio» lleva a pensar en un gran tazón soportado y movido por un armazón metálico inferior. Este tipo de radiotelescopio «de gran plato» concentra las ondas de radio reflejándolas sobre la antena situada sobre su centro, tal como un espejo de telescopio óptico concentra la luz. El receptor propiamente dicho es especialmente sensible y costoso. Algunos están refrigerados por aire líquido, para obtener mayor sensibilidad, mientras que otros incorporan un máser (el equivalente en microondas al láser para amplificar la diminuta señal de radio procedente del cielo. Los receptores se diseñan de acuerdo con las peculiaridades de la fuente de radio cósmica en estudio. Algunas fuentes emiten en una sola longitud de onda —como un transmisor hecho por el hombre y se corresponden exactamente con las líneas espectrales de luz visible. Los astrónomos estudian estas «líneas de radio» al detalle para comprender cómo se mueve el gas invisible en nuestra Galaxia, así como en otras. La mayor parte de las fuentes de radio, sin embargo, producen todas las longitudes de onda de las ondas de radio, y no es demasiado importante dónde «sintonice» el radioastrónomo.
El radioastrónomo enfrenta asimismo problemas para percibir los detalles finos de una fuente de radio. Cualquier telescopio está limitado en teoría por los detalles que puede apreciar; y, naturalmente, un gran telescopio puede captar detalles más finos que otro más pequeño. A los astrónomos ópticos esto no les aféela en sumo grado, ya que su límite, determinado por las fluctuaciones de la atmósfera, es mucho más vasto. Pero los radioastrónomos se enfrentan con un hándicap real en el límite natural originado por la naturaleza ondulatoria de la radiación. Sus longitudes de onda son aproximadamente un millón de veces más largas que las de la luz, v los telescopios han de ser mucho mayores para apreciar la misma dimensión de detalle.
El astrónomo real británico sir Martin Ryle ha propuesto una ingeniosa solución: conectar electrónicamente varios platos pequeños dispuestos según una línea recta para aprovechar la rotación de la Tierra. Con la ayuda de un ordenador para analizar los resultados, es posible lograr que la resolución de un telescopio sea tan grande como larga es la disposición de las antenas. Su telescopio «de cinco kilómetros», en Cambridge, construido paralelamente a la línea de ferrocarril Oxford-Cambridge, puede «ver» los mismos detalles que un telescopio óptico a pesar de la mucha mayor longitud de onda de las ondas de radio.
Una tentativa, más extraña incluso, consiste en registrar señales desde radiotelescopios individuales situados en lugares opuestos del mundo, ambos dirigidos simultáneamente hacia la misma fuente. Combinando los resultados posteriormente, los radioastrónomos han vislumbrado algunos de los detalles que suministraría un radiotelescopio tan grande como la Tierra: un detalle equivalente al grosor de un cabello humano a 10 kilómetros de distancia.
§. Relativamente próximas a la luz
Más cortas que las radioondas son las longitudes de onda del infrarrojo, familiarmente conocidas como radiación «calorífica». Llenan el hueco entre las radioondas y el extremo rojo del espectro luminoso: son la radiación procedente de las puntas de los objetos templados y moderadamente calientes. Un calentador eléctrico genera una gran cantidad de infrarrojo y escasas ondas luminosas o de radio; esta radiación produce vibración en las moléculas de nuestra piel, haciéndonos sentir calor. En un horno, o parrilla, la radiación es suficientemente intensa como para romper las moléculas y, así, cocinar nuestras comidas.
Esto supone un evidente despilfarro de energía, ya que, como el calor debe penetrar dentro, emplea tiempo para ello y, posiblemente, quema la superficie. Los hornos de microondas funcionan de forma totalmente diferente y cocinan los alimentos desde dentro. Estas ondas se sitúan entre las de radio y las infrarrojas. Un haz de microondas muy potente puede generarse electrónicamente. Se escoge la longitud de onda que iguala el valor natural a que vibran las moléculas de agua, y como la comida está constituida en gran parte por agua, estas moléculas absorben las microondas que pasan a su través y calientan la comida adecuadamente. El resultado es que cocinan rápida y completamente, y el plato, que no contiene moléculas de agua, permanece frío.
Los astrónomos de infrarrojo recogen la radiación de estrellas relativamente frías y de nubes de polvo templadas del espacio. Pero nuestra atmósfera bloquea la mayoría de las longitudes de onda infrarrojas, que son absorbidas por las moléculas de agua y de dióxido de carbono del aire; por consiguiente, los astrónomos que estudian el infrarrojo deben trabajar en observatorios muy altos o desde globos y aeroplanos que vuelen a gran altura. Su tarea es una de las más duras de las de todos los astrónomos, ya que el aire que les rodea y el telescopio mismo se hallan a temperatura idónea para emitir su pico de radiación en las longitudes de onda a que ellos observan. ¡Es como si un astrónomo óptico tuviera que entendérselas con un telescopio pintado por dentro y por fuera con pintura fosforescente! Los avances electrónicos pueden resolver en parte este problema.
La astronomía óptica moderna se está convirtiendo en un paraíso de brujas electrónico. Aun cuando la fotografía es todavía extremadamente importante, los métodos electrónicos de detección de fotones individuales de luz facilitan la medición exacta de la intensidad y proporcionan espectros realmente precisos. Por regla general, los ordenadores se emplean para guiar telescopios o analizar resultados, y como ayuda para medir las posiciones en las placas fotográficas. El que los astrónomos hayan aumentado enormemente su conocimiento del Universo en las dos últimas décadas se ha debido tanto al ordenador como a otros factores.
Para longitudes de onda más cortas que las de la luz, la atmósfera terrestre bloquea todas las señales procedentes del espacio. Los astrónomos se refieren a dos «ventanas» en la atmósfera, una de las cuales deja pasar la luz, y la otra, las ondas de radio. Para el resto de longitudes de onda, el cielo es un velo opaco.
Por debajo del extremo corto del espectro (violeta) se encuentran los rayos ultravioletas. Los fotones individuales de estas radiaciones son suficientemente energéticos como para disociar las moléculas, y las desagradables quemaduras de Sol nos recuerdan que, sin el escudo ultravioleta de nuestra atmósfera, no existiría vida sobre la Tierra. Los rayos ultravioletas de) Sol son bloqueados por una capa de ozono moléculas de oxígeno que contienen tres átomos en lugar de dos a una altitud de unos 50 kilómetros. Recientemente, los ecologistas han señalado que el gas de los aerosoles o los escapes de los aviones pueden romper las moléculas de ozono. Si esto es una auténtica posibilidad, la vida sobre la superficie de la Tierra está amenazada de muerte .por inundación de los rayos ultravioletas del Sol.
La astronomía de ultravioleta debe realizarse desde satélites de control remoto que se sitúen en órbita por encima de la capa de ozono y capten estrellas muy calientes, cuyos picos de radiación se hallen en esta zona del espectro; un análisis detallado del espectro ultravioleta de la estrella da cuenta de una absorción por parte de las moléculas que existen en el espacio. La más importante de éstas es la molécula de hidrógeno. La que se encuentra normalmente en la Tierra está constituida por dos átomos de hidrógeno, pero aun cuando los radioastrónomos descubrieron átomos de hidrógeno en el espacio, las moléculas de hidrógeno eran inesperadas; los astrónomos piensan ahora que la mitad del gas de nuestra Galaxia corresponde a esta forma.
§. Radiaciones exóticas
Si bajamos un tanto, encontramos los aún más cortos rayos X, cuyas longitudes de onda son prácticamente iguales al tamaño de un átomo. Los fotones son incluso más energéticos, más disruptivos y más penetrantes. En medicina, los penetrantes rayos X son de inapreciable valor para mostrar los desórdenes internos en el cuerpo humano, y la última de las técnicas, la tomografía, barrido con una fuente de rayos X, proporciona una visión tridimensional de los tumores cerebrales. Sin embargo, existe un ligero riesgo de dañar el tejido del cuerpo (las dosis de rayos X largas se emplean en realidad para destruir tumores cancerosos), y los médicos vuelven ahora a emplear técnicas de ultrasonidos o de sondeo magnético completamente inocuas.
Los rayos X del espacio proceden generalmente de nubes de gas extremadamente calientes, a temperaturas de miles de millones de grados. Los observatorios de satélites han localizado las posiciones de unas trescientas fuentes de rayos X, y estos objetos a alta temperatura (normalmente invisibles para los telescopios ópticos ordinarios; nos dan cuenta de algunos olios que son de lo más extraño del Universo, como los agujeros negros, con los que nos encontraremos en un capítulo posterior.
Por último, la radiación más corta de todas es la de los rayos gamma. No existe una línea divisoria suficientemente precisa entre los rayos ultravioletas y los X. o entre los rayos X y los gamma. En la Tierra, la distinción depende generalmente de cómo los producimos, pero cuando se los recibe como señales desde el espacio, la diferenciación entre las longitudes de onda es bastante arbitraria.
La astronomía de rayos gamma es aún una ciencia muy joven, y se conocen muy pocas fuentes celestes. Los primeros satélites de rayos gamma fueron los de la serie American Vela, en realidad un programa militar destinado a detectar explosiones nucleares sobre la Tierra. En 1967 comenzaron a detectar de improviso impactos de rayos gamma, que pronto resultó obvio que procedían del espacio y no de nuestro planeta. Las primeras explicaciones se refirieron a choques de cometas contra estrellas de neutrones ultra-compactas relativamente próximas, e incluso a la explosión de estrellas en galaxias distantes; pero ahora parece probable que se hallen en relación con fuentes celestes ordinarias de rayos X, como veremos en el capítulo 9.
Los astrónomos actuales recogen la radiación electromagnética del Universo desde las ondas de radio hasta los rayos gamma, abarcando un intervalo de longitud de onda de un trillón. Los complejos equipos de radio del radioastrónomo, los gigantes telescopios terrestres de los astrónomos ópticos, así como los satélites en órbita que los astrónomos deben emplear para estudiar las demás longitudes de onda, nos dan una idea de lo que se progresa.
Podemos recoger otras señales del espacio, no electromagnéticas, pero son muy escasas. Partículas cargadas que se mueven muy' rápidamente —electrones, protones y varios núcleos atómicos se rompen en la parte superior de nuestra atmósfera en forma de «rayos cósmicos» después de un largo camino desde las estrellas en explosión. Los esquivos neutrinos son otro tipo de partículas procedentes del espacio, pero sólo se los puede atrapar con dificultad. Los astrónomos han detectado sólo neutrinos procedentes de nuestra estrella más próxima, el Sol.
Más emparentadas con las ondas electromagnéticas están las ondas gravitacionales, diminutas fluctuaciones en la gravitación de objetos distantes que se originan cuando éstos giran de modo frenético o se colapsan catastróficamente. El físico americano Joseph Weber fue el primero en investigar las ondas gravitacionales empleando dos grandes cilindros de aluminio suspendidos, que pesaban una tonelada cada uno. Observó repentinas vibraciones de los cilindros causadas por un «martillazo» exterior de alguna especie. Obviamente, los terremotos podían ser una causa, por lo cual instaló los cilindros en lugares muy alejados entre sí, próximos a Washington y a Chicago. El único «soplo» que pudiese afectar a ambos cilindros simultáneamente debería ser el de un impacto de ondas gravitacionales procedentes del espacio, y sus primeros resultados parecieron mostrar muchas de estas vibraciones repentinas y simultáneas. Desgraciadamente, otros investigadores no han tenido éxito en encontrar esta plétora de impactos gravitacionales; pero Weber les ha animado a construir equipos más sensibles, y posiblemente las ondas gravitacionales se descubran algún día. Una gigantesca erupción en el Sol, nuestra estrella local, fotografiada en rayos X por los astronautas del Skylab. El falso color muestra las variaciones de temperatura, mientras que imágenes más débiles en hilera, que se solapan, originan las manchas y trazas brillantes a izquierda y derecha.
Capítulo 8
En el interior de las estrellas
Constantemente nacen y mueren estrellas; sus vidas dependen de su tamaño. Si nuestro Sol es una estrella «ordinaria», ¿cómo son las extraordinarias? ¿Y cuál es el futuro de nuestro Sol?

Una gigantesca erupción en el Sol, nuestra estrella local, fotografiada en rayos X por los astronautas del Skylab. El falso color muestra las variaciones de temperatura, mientras que imágenes más débiles en hilera, que se solapan, originan las manchas y trazas brillantes a izquierda y derecha.
§. Los constructores de estrellas
§. El nacimiento de una estrella
§. Las centrales generadoras de las estrellas
§. Las estrellas de la secuencia principal
§. El Sol
§. Clima magnético
§. El «clima» del Sol nos afecta
§. Los neutrinos perdidos
§. Enanas blancas
§. La muerte de un peso pesado
§. Los púlsares
A dos mil metros bajo tierra, en un lugar próximo a la ciudad de Lead, en Dakota del Sur, un astrónomo observa el corazón del Sol con un tanque de 400.000 litros de líquido quitamanchas. Raymond Davis procura capturar algunos de los fantasmagóricos neutrinos que salen a raudales del infernal núcleo del Sol cuando los núcleos de hidrógeno se fusionan en helio.
El flujo (cantidad de energía transferida; de neutrinos solares es inmenso. Transportan un quincuagésimo de la energía al abandonar el Sol, del cual son emitidos a razón de ciemos de billones por segundo. Son extraordinariamente esquivos, por ser prácticamente imparables. No tienen carga eléctrica y pasan a través de los electrones y de los núcleos de los átomos sin que éstos les afecten. Su velocidad es aproximadamente igual a la de la luz, por lo que sólo son ligerísimamente desviados por la gravedad. Son inmunes a la fuerza nuclear fuerte, y únicamente dan cuenta de su presencia por medio de la llamada interacción débil; un neutrino típico se desplazaría una distancia de años luz a través de un blindaje de plomo antes de detenerse.
El tanque de Davis está lleno de tetracloroetileno, un líquido rico en átomos de cloro de los que uno de cada cuatro pertenece a la variedad pesada cloro-37. Ocasionalmente, un neutrino que pasa es detenido por un núcleo de cloro-37; el impacto escinde uno de los neutrones del núcleo en un protón y un electrón que escapa. El cloro-37 se transmuta entonces en un átomo del gas inerte argón-37.

Un enorme tanque, a dos kilómetros de profundidad, en una mina de oro en Dakota del Sur, detecta algunos de los neutrinos que surgen del corazón del Sol. Estas esquivas partículas reaccionan con los átomos de cloro del líquido quitamanchas que llena el tanque de 400.000 litros.
Cada pocos meses se limpia el inmenso tanque con un chorro de gas helio, y en este gas se rastrean los posibles indicios de argón. El insólito lugar elegido para la instalación del tanque, bajo la mina de oro de Homestake, se debe a la necesidad de proteger a los núcleos de cloro de otras radiaciones y partículas.

El científico alemán del siglo XIX Hermann van Helmholtz estudió temas tan diversos como el ojo humano, las ondas sonoras y la energía. Calculó que la energía gravitatoria del Sol únicamente podría mantenerlo brillando durante 30 millones de años.
Los 2.000 metros de techo de roca aíslan el tanque de la lluvia continua de rayos cósmicos núcleos y electrones muy rápidos procedentes de las profundidades del espacio—, mientras que son prácticamente transparentes para los insustanciales neutrinos.

Los ordenadores ayudan a los astrónomos modernos a calcular el modo en que varían las estrellas con la edad. Los resultados se representan en un gráfico: este ejemplo pone de manifiesto (para un ojo entrenado) cómo se altera un sistema doble de estrellas cuando una de ellas se expande al envejecer.
Esta experiencia, que puede parecer esotérica a primera vista y que se efectúa desde hace diez años, constituye una comprobación vital de las teorías acerca de los ciclos de vida de las estrellas. En los últimos cuarenta años, los astrofísicos han afinado de forma notable sus teorías sobre la evolución estelar, y ya resulta posible dar cuenta casi con exactitud de la temperatura y de las combinaciones de elementos en el centro de diversos tipos de estrellas, calcular cuánto tiempo permanecen en cada etapa de su evolución y predecir cuándo morirá finalmente la estrella. De estos resultados teóricos existen pocas comprobaciones directas. La gama completa de radiaciones electromagnéticas que recibimos de una estrella, desde los rayos X hasta las ondas de radio pasando por la luz, proviene de sus capas superficiales y de su atmósfera. Los neutrinos, por su parte, son emitidos directamente hacia el espacio desde las propias reacciones nucleares del centro. Los modelos teóricos de estrellas predicen cuántos neutrinos deberían producirse, y el dispositivo de Davis comprueba estos cálculos cuando se aplican a nuestra estrella local, el Sol.
§. Los constructores de estrellas
En principio, puede resultar misterioso el que los astrónomos pretendan conocer algo acerca del interior de estrellas remotas; después de todo, se las ve como meros puntos de luz incluso en los mayores telescopios fa menos que se utilicen técnicas especiales. Sin embargo, como vimos en el capítulo 7, el espectroscopio revela los elementos que Componen las capas más externas de las estrellas, y su espectro, o bien su color, nos dan a conocer su temperatura superficial. Puede calcularse la luminosidad total si se conoce la distancia a que está la estrella, y la masa sólo si es uno de los pares ligados gravitacionalmente (véase capítulo 2).
Con la ayuda de un gran ordenador, un astrofísico moderno puede construir un enorme rango de estrellas «patrón» teóricas. Para ello simula una cantidad de gas de masa determinada y una específica mezcla de elementos, que se mantienen unidos por la atracción gravitatoria, e investiga los cambios en la temperatura, en la presión y en la composición de la estrella cuando se producen reacciones nucleares u otros procesos. Una formidable labor, ciertamente; pero, en principio, no consiste más que en aplicar las conocidas leyes de la física, de la misma forma que cuando se calcula la trayectoria de una pelota lanzada al aire.
El Universo debe ser, no obstante, la última piedra de toque. Un modelo teórico de estrella puede no corresponder exactamente al deseado para la estrella real, bien porque nuestras leyes físicas de laboratorio no tengan validez para el tremendo calor del corazón de la estrella, bien, simplemente, porque algunos de los cálculos se hayan simplificado en exceso con el fin de obtener más sencillez y velocidad de cálculo, en detrimento de una respuesta exacta. La primera de estas posibilidades condujo a una gran crisis cuando los físicos calcularon, a mediados del siglo XIX, la energía de salida del Sol antes de conocerse la energía encerrada en los núcleos atómicos. El gran científico alemán Hermann von Helmholtz supuso que la gravitación era la única fuerza entonces conocida capaz de mantener caliente al Sol durante largo tiempo. Al contraerse por su propia atracción gravitatoria, una nube de gas se calienta; pero un simple cálculo mostró que la energía producida únicamente hubiera permitido brillar al Sol, a su ritmo actual, durante 30 millones de años. Los geólogos indicaron que este resultado era imposible. La Tierra y, algo más importante, los fósiles indicadores de la vida en la Tierra, eran bastante más antiguos. Hasta la década de 1930 no se resolvió finalmente el problema, cuando otro alemán, Hans Bethe, dedujo las reacciones nucleares que pueden ocurrir en el ardiente núcleo del Sol, reacciones no contempladas por las leyes físicas conocidas en tiempos de Helmholtz. Los avances en la física de laboratorio han permitido que los astrónomos expliquen la luminosidad de las estrellas; y los astrofísicos modernos pueden pagar la deuda al tratar al Universo como un inmenso laboratorio, en el que el hombre puede apreciar los resultados de los experimentos propios de la Naturaleza a una escala imposible de alcanzar en la Tierra.
Los resultados sobre los «experimentos» de la Naturaleza en la construcción de estrellas pueden resumirse convenientemente en las relaciones masa-luminosidad y temperatura-luminosidad Hertzsprung-Russell), que tratamos en el capítulo 2. Ambas son la Piedra Rosetta de los «constructores de estrellas» humanos. El «modelo» teórico debe acatar estas relaciones, y también ha llegado a ser evidente por qué la mayor parte de las estrellas se encuentran en la «secuencia principal», mientras que otras son gigantes rojas o enanas blancas. De hecho, los cálculos concuerdan con las relaciones demostradas para estrellas reales, y los astrónomos confían en que, si pudieran realmente penetrar dentro de una estrella, sus condiciones interiores coincidirían con los modelos teóricos.
Quizá sorprenda aún más, asimismo, la adecuada comprensión de los cambios experimentados por una estrella durante su vida. Habida cuenta de que el rango de vida media de las estrellas puede oscilar entre un millón y 100.000 millones de años, tales cambios tienen lugar muy lentamente.

La gran Nebulosa de Orion, fotografiada por el telescopio de 5 metros de los Observatorios Hale, es una nube de gas iluminada por jóvenes estrenas que se han formado recientemente en ella. (Copyright del instituto de Tecnología de California y la Institución Carnegie de Washington. Reproducido con permiso de los Observatorios Hale.)
De vez en cuando, los astrónomos han visto «encenderse» una estrella y empezar a brillar; o bien han contemplado la muerte súbita de otra, advertible por la explosión de una lejana supernova; pero, en general, las estrellas parecen invariables. Nuestra situación es semejante a la de un extraterrestre que paseara una hora por una de las bulliciosas calles de la Tierra; aun cuando no apreciase el modo en que transcurre la edad de las personas, podría comparar a los individuos, deducir qué caracteriza a la edad y, en consecuencia, determinaría cómo evolucionan los humanos desde la infancia hasta la vejez.
Similarmente, las teorías de la estructura estelar indican los cambios que podríamos esperar en una estrella cuando sus reacciones nucleares centrales convierten un elemento en otro; e, igualmente, permiten adivinar las edades y las historias de la multitud de estrellas que nos rodean, incluyendo el pasado y el futuro de nuestro propio Sol.
Sin embargo, antes de describir las etapas fundamentales de la vida de una estrella, mucho mejor conocidas, es ocasión de retornar a su nacimiento, proceso hasta hace muy poco sumido en la oscuridad.
§. El nacimiento de una estrella
La «infancia» de las estrellas ha permanecido oculta a los ojos de los astrónomos, sumida en las profundidades de grandes nubes de gas y oscuro polvo. Las nubes de gas, como la famosa Nebulosa de Orion, ocupan la mayor parte del plano de nuestra Galaxia en rotación. Una nube interestelar es generalmente bastante estable, ya que la presión del gas que la intenta expandir dentro del gas más tenue que la rodea resulta equilibrada por la fuerza de su propia gravitación. Pero el equilibrio se quiebra si la nube se comprime repentinamente, quizás al estrellarse contra una de las nubes de gas de los brazos espirales cuando flota alrededor del centro de la Galaxia, o, tal vez, al ser alcanzada por los restos en expansión de la explosión de una supernova cercana. En cualquier caso, la nube queda aplanada cual una torta cósmica, y la gravitación se encarga de atraer al gas al interior de los trozos contraídos. Cuando estos últimos se contraen, giran más rápidamente, obedeciendo la ley de conservación del momento angular que vimos en el capítulo 3 (al igual que un patinador sobre hielo gira más rápidamente cuando encoge sus brazos), hasta que finalmente las partes se escinden y acaban formando condensaciones independientes. Así pues, se establece un cúmulo completo de «protoestrellas» contraídas, oculto dentro de los restos de la nube original.
En los últimos años, los astrónomos escudriñan ya a través de las «cortinas de los criaderos de estrellas». Los rayos infrarrojos y las ondas de radio pueden penetrar las nubes de polvo, y los astrónomos captan ahora estas radiaciones y «ven» las protoestrellas y sus alrededores. Las protoestrellas contraídas se calientan a medida que su energía gravitatoria se convierte en calor, tal como Helmholtz calculó para la «contracción solar» el siglo pasado; y cuando la «superficie» en realidad, un capullo de polvo más espeso en torno a la estrella alcanza una temperatura de unos cuantos cientos de grados, empiezan a brillar débilmente. Tal como en un calentador eléctrico a temperatura similar, la mayor parte de la energía se emite como radiación infrarroja (calor. Los astrónomos han encontrado decenas de capullos de estrellas infrarrojas acumuladas en el centro de nubes como la Nebulosa de Orion.
En los últimos años sesenta, Eric Becklin y Gerry Neugebauer descubrieron una estrella de infrarrojo particularmente brillante en esta nebulosa, detrás del resplandeciente gas y de las estrellas que muestran las fotografías ordinarias. El objeto de Becklin-Neugebauer es, con toda probabilidad, una protoestrella aproximadamente unas diez veces más pesada que el Sol, y diez mil veces más brillante, y, si no estuviera en la etapa de capullo y oscurecida por el polvo, la veríamos como una de las estrellas más brillantes del cielo. Por el contrario, el objeto de Becklin-Neugebauer es invisible, incluso para los mayo- íes telescopios ópticos, y las propiedades del infrarrojo sugieren que sólo una parte de un trillón de su luz visible puede escapar del capullo y de la nebulosa que le rodea.
Los radioastrónomos no se muestran menos excitados por estas noticias. Durante largo tiempo detectaron gas hidrógeno caliente próximo a las estrellas jóvenes, pero un examen detallado del espectro de radioondas de las densas nubes de gas reveló, recientemente, «líneas» de muchas moléculas. Con anterioridad, sólo se habían encontrado en el espacio átomos sencillos (y átomos cargados eléctricamente llamados iones), pero hace poco se detectaron cincuenta compuestos químicos diferentes en las nubes interestelares, y la lista aumenta cada año. Estas moléculas se forman a partir de átomos de gas sobre la superficie de los minúsculos granos de polvo, y éste las protege de la radiación ultravioleta que normalmente disocia las moléculas del espacio. Algunas de las moléculas más grandes son sorprendentemente similares a las que se encuentran en las células vivas, y algunos científicos sugieren que estas reacciones químicas interestelares pueden jugar un importante papel en el origen de la vida de los planetas que se hallan en órbita en torno a la protoestrella.
Aún más inesperado resulta el que algunas de estas moléculas se hallen en pequeñas nubes que brillan intensamente a las longitudes de onda de radio en forma de máseres naturales (el equivalente en radio a los láseres). Cada una tiene aproximadamente el tamaño de la órbita de la Tierra en torno al Sol, y es alimentada por la radiación infrarroja de las protoestrellas próximas, convertida por medio de las moléculas de agua H2O e iones hidroxilo (OH) en intensos haces de microondas. Asisten al nacimiento de la estrella actuando como si fuesen refrigeradores cósmicos, es decir, realizan una función que consiste fundamentalmente en extraer el calor que de otra forma se opondría a la contracción gravitatoria de las protoestrellas.
§. Las centrales generadoras de las estrellas
La temperatura central de la protoestrella aumenta continuamente durante su colapso; y cuando alcanza la colosal temperatura de diez millones de grados, empiezan las reacciones nucleares. Los núcleos de hidrógeno (protones) se fusionan de cuatro en cuatro para dar núcleos de helio. Con el fin de iniciar la reacción, los núcleos deben chocar con fuerza suficiente como para vencer la repulsión debida a sus cargas eléctricas positivas —«cargas iguales se repelen» -, y, como la temperatura es una medida de la velocidad de las partículas de gas, una temperatura suficientemente alta asegurará que comienza la fusión.
Esta alta temperatura es el problema más serio en el diseño de un reactor de fusión en la Tierra.)
Dado que la fuerza nuclear fuerte mantiene unidas a las partículas, la energía es extraída por la alta velocidad de los productos y por los rayos gamma. La razón de la pérdida de energía puede apreciarse fácilmente si se considera la reacción inversa: se necesitaría una gran cantidad de energía para descomponer un núcleo de helio en dos protones y dos neutrones libres; y una cantidad exactamente igual de energía se libera, por tanto, cuando los componentes de un núcleo de helio se unen. Esta pérdida de energía de enlace, que tiene lugar cuando se combinan los núcleos, alimenta a las estrellas. Toda forma de energía posee una cantidad de masa asociada a ella, según la famosa ecuación de Einstein, E = mc2 (energía- = masa × velocidad de la luz al cuadrado), y la pérdida de energía significa que cada núcleo de helio es únicamente el 99,3% tan pesado como los cuatro núcleos de hidrógeno que lo han formado. Una estrella típica como nuestro Sol convierte masa en radiación al sorprendente ritmo de 4 millones de toneladas ¡por segundo!
La estrella se calienta en el centro debido a la energía perdida por los núcleos que se funden en él (aparte de la pequeña cantidad de energía transportada al espacio por los esquivos neutrinos). Los principales productos de la reacción núcleos y partículas rápidas, y rayos gamma no pueden desplazarse lejos sin encontrarse con partículas del gas de los alrededores; y aquí, la fuerza electromagnética entre ellas juega su papel moderando los residuos de la reacción e impulsando las partículas de gas a altas velocidades. Por tanto, la velocidad media de las partículas se incrementa aumentando aún más la temperatura del ya sobrecalentado núcleo de la estrella. Pero, al calentarse, un gas aumenta la presión que ejerce sobre sus alrededores tal como lo sabe cualquiera que haya abierto una botella de champán caliente, y este exceso de presión en el centro de la estrella se opone a la omnipotente atracción gravitatoria. La estrella deja de contraerse, y el perfecto equilibrio de las fuerzas la mantiene brillando constantemente durante millones de años.
¿Y qué sucede con la cuarta fuerza, la fuerza nuclear débil? También juega un papel fundamental. Cuando los cuatro núcleos de hidrógeno se combinan para formar un núcleo de helio, dos de ellos deben cambiar de protones a neutrones. Esto va acompañado de la emisión de un positrón antielectrón y de un neutrino, una reacción nuclear débil. Como vimos en el capítulo 3, las reacciones débiles son aproximadamente cien billones de veces más lentas que las reacciones nucleares fuertes; y son necesarias en la cadena de reacciones de formación del helio para moderar la rápida reunión de los núcleos de helio.

Las Pléyades, o Siete Hermanas, son jóvenes según los patrones astronómicos. Solamente tienen 60 millones de años y están rodeadas por jirones de la nebulosa en la que nacieron. Estas estrellas, brillantes y pesadas, se apagaran antes de que el Sol deje de brillar. (Copyright del Instituto de Tecnología de California y la Institución Carnegie de Washington. Reproducido con permiso de los Observatorios líale.)
En la llamada bomba «de hidrógeno», el explosivo no es hidrógeno ordinario, sino variedades más pesadas cuyos núcleos contienen uno o dos neutrones además del protón; así pues, como no hay necesidad de esperar el proceso débil para generar neutrones, la fuerza fuerte lo arrolla todo: los núcleos se fusionan en un cataclismo casi instantáneo. Si los protones pudieran convertirse en neutrones a un ritmo correspondiente al de la interacción fuerte, el Sol habría estallado por sí mismo tan pronto como se formó, al igual que una bomba de hidrógeno a escala cósmica.

La Nebulosa Eta Carina, una resplandeciente nube de gas surcada por oscuras sendas de polvo. Esta fotografía, procedente del Observatorio Interamericano de Cerro Tololo, en Chile, está salpicada por cientos de estrellas, y cada una de ellas es una central nuclear como nuestro Sol.
De esta manera, una estrella como nuestro Sol, que brilla regularmente, es un gigantesco campo de batalla entre las fuerzas naturales. Por una parte, la gravitación intenta contraería continuamente al tamaño más pequeño posible, y por sí sola lo lograría en unos 30 millones de años, según la escala de Helmholtz. Pero la reacción fuerte une los núcleos en el centro de la estrella y libera energía por intermedio de la fuerza nuclear débil. Las fuerzas electromagnéticas aseguran que esta energía caliente el interior de la estrella, con el fin de producir una presión hacia afuera que sirva para equilibrar exactamente la gravitación.
§. Las estrellas de la secuencia principal
No resulta sorprendente que esta condición de equilibrio asegure el que todas las estrellas de fusión de hidrógeno, de igual masa, sean como gemelos idénticos con propiedades notablemente similares. Supongamos, por ejemplo, una estrella que produjese menos energía que la apropiada para su masa. El centro se volvería demasiado frío, y la menor presión del gas permitiría entonces que las fuerzas gravitatorias comenzasen a contraer la estrella; esta contracción calentaría el núcleo, y esta mayor temperatura aumentaría el ritmo de fusión nuclear con el correspondiente retomo a la producción normal de energía. Este magnífico sistema de realimentación asegura que las estrellas brillen, más o menos constantemente, durante el tiempo en que fusionan el hidrógeno en helio.
El Sol se halla a aproximadamente la mitad de su periodo de fusión de hidrógeno de 10.000 millones de años, pero, bastante paradójicamente, le sobrevivirán estrellas menos masivas. Aun cuando estas estrellas tienen menos reservas de combustible, su menor gravitación les proporciona una temperatura central menor, y el ritmo de fusión es tan lento que su provisión de hidrógeno les durará de hecho más que al Sol. En una nube de gas en colapso habrá protoestrellas de todas las masas, y los cálculos muestran que sólo aquellas más pesadas que un veinteavo de la masa del Sol (cincuenta veces la masa de Júpiter) alcanzarán una temperatura central bastante alta como para fusionar los núcleos de hidrógeno. Una bola de gas menos masiva se calentará por contracción, pero nunca brillará por sí misma y terminará como un gran planeta, como un Júpiter más masivo. La predicción teórica queda verificada por la estrella más ligera conocida, Ross 614B, unas setenta veces más pesada que Júpiter, justo por encima del límite.
Las estrellas más masivas son, correspondientemente, pródigas en su uso del hidrógeno. Una estrella diez veces más pesada que el Sol vive sólo la milésima parte (diez millones de años), mientras que las reacciones nucleares en su sobrecalentado núcleo agotan el combustible de hidrógeno. Las estrellas más masivas son, como era de esperar, más luminosas que el Sol, y la relación calculada es muy similar a la relación masa-luminosidad para estrellas reales. La alta luminosidad convierte en inestables a las estrellas más masivas; el inmenso flujo hacia el exterior de fotones, que transporta energía desde el centro, arranca sus capas más externas incluso en contra de la enorme atracción gravitatoria. Las estrellas más pesadas conocidas, como el superpesado par llamado estrella de Plaskett, es alrededor de sesenta veces más pesado que el Sol y se acerca a este límite superior.
La teoría relaciona asimismo la luminosidad de una estrella con su temperatura superficial, y la predicción se corresponde adecuadamente con la secuencia principal del diagrama Hertzsprung-Russell.

La parte superior de una gran protuberancia puede alcanzar casi un millón de kilómetros por encima de la superficie del Sol. Las capas más inferiores de la atmósfera del Sol (fotografiadas aquí con luz de átomos de hidrógeno) se distorsionan a causa de los campos magnéticos. Los campos mu) fuertes enfrían los gases del Sol y originan las manchas solares oscuras.
Por consiguiente, las estrellas de la secuencia principal son estrellas de fusión de hidrógeno, y la posición que una estrella ocupa en la secuencia depende en esencia de su masa. Como veremos más adelante, los otros tipos más raros que incluyen las gigantes rojas y las enanas blancas son simplemente estrellas más viejas que han pasado ya por la fase de la secuencia principal.
La mayor parte de la vida de una estrella es empleada en fusionar hidrógeno, y, así, la mayoría de las estrellas que vemos en el cielo son del tipo de las ele la secuencia principal; al igual que la mayor parte de la gente que vemos por-las calles se halla por debajo de los 60 años, simplemente porque un ser humano vive más tiempo por debajo de los 60 que por encima.
La concordancia entre los cálculos y las relaciones observadas de masa-luminosidad y temperatura-luminosidad (Hertzsprung-Russell) muestra que la teoría de la fusión de hidrógeno es bastante precisa. Antes de seguir las últimas etapas de la vida de una estrella, después de que alcanza el punto crítico en el que ya ha convertido lodo su hidrógeno central en helio, retornaremos a la única estrella de fusión de hidrógeno que podemos estudiar al detalle.
§. El Sol
El suave y sonriente rostro del Sol pintado por los artistas desde la antigüedad es una buena representación del modo en que éste oculta la mayor parte de sus secretos a las interrogantes de los astrónomos. Hasta que Raymond Davis comenzó a investigar los neutrinos en 1968, no había forma directa alguna de explorar su oculto interior, y nuestro conocimiento de su estructura se basaba en su mayor parte en la teoría que tan correctamente describe las estrellas de fusión de hidrógeno.
La energía del núcleo del Sol se filtra hacia el exterior muy lentamente. Cada fotón individual se desplaza sólo una fracción de milímetro antes de encontrarse con una partícula de gas y ser absorbido o esparcido, y, cada vez que esto sucede, varían su energía y dirección. En el capítulo 7 vimos cómo el carácter de la radiación electromagnética (fotones) depende de la temperatura de la materia que la rodea. Cuando la energía se difunde hacia afuera desde el extremadamente caliente núcleo, el tipo principal de fotones cambia desde los rayos X hasta el ultravioleta, y hasta la luz visible, antes de que la energía emerja de la brillante superficie solar. Esta lenta «rata» de difusión significa que la energía producida tardará millones de años en atravesar los 700.1)00 kilómetros hasta la superficie del Sol, mientras que en el espacio vacío esta distancia sería recorrida en algo más de ¡dos segundos!
Exactamente debajo de la superficie visible del Sol existe una zona en la que el flujo saliente de energía es transportado por inmensas columnas verticales de gas. Una cacerola caliente es un excelente ejemplo para ilustrar este proceso de convección. Antes de que el agua de la cacerola hierva, hay una etapa en la cual las columnas de agua caliente ascienden hacia la superficie, mientras que el agua fría adyacente, más densa, desciende, otorgando a la superficie el aspecto de un panel de celdas de convección. La superficie solar está recubierta de este tipo de celdas, cual un tazón de arroz en el que cada «grano» mostrase un centro caliente y brillante de gas ascendente, así como bordes oscuros y fríos, por los que el gas desciende al interior del Sol después de emitir parte de su calor. Estos gránulos de 700 kilómetros de diámetro están dispuestos en celdas más grandes de super-gránulos (30.000 kilómetros), observados en la parte más baja de la atmósfera del Sol con instrumentos especializados. Veremos más adelante que estos super-gránulos se relacionan íntimamente con el clima del Sol.

El gas resplandeciente de esta prominencia visible en el borde del Sol muestra lazos en el campo magnético solar, tal como el campo de un imán puede distribuir las limaduras de hierro que se coloquen a su alrededor en forma similar.
Puede parecer contradictorio que hablemos de «superficie» y «atmósfera» del Sol, ya que todo el Sol es gas que se vuelve menos denso desde el centro hacia afuera. En las partes más externas de la tenue atmósfera solar fluye gas llamado viento solar que se extiende más allá de la órbita de Júpiter; por lo que podríamos afirmar, hasta cierto punto, que la mayor parte de los planetas se hallan en órbita dentro del Sol. Sin embargo, estas capas más externas son extremadamente tenues y están más enrarecidas que el mejor «vacío» que podernos producir en la fierra. La idea de una superficie definida es, de hecho, bastante razonable, pues las fotografías vistas con luz ordinaria muestran que el Sol posee un borde muy afilado. (Nunca se debe mirar al Sol directamente a través de un telescopio o de unos prismáticos, pues la concentración de calor puede dañar los ojos de modo permanente.) En la región de la superficie del Sol (fotosfera), la densidad del gas disminuye miles de veces en sólo unos pocos cientos de kilómetros, y desde la Tierra se lo ve como una delgada película. Por debajo de la fotosfera, el gas del Sol es tan denso que se vuelve opaco, mientras que por encima en la «atmósfera» es transparente a la luz.

La atmósfera más externa del Sol, la corona, sólo puede observarse cuando la Luna oculta el disco bullente del Sol durante un eclipse total. Este fue fotografiado desde Miahuatlán, México, el 7 de marzo de 1970.
§. Clima magnético
A primera vista, el Sol parece ser el simple balón de gas caliente que predice la teoría. Sin embargo, esto se debe al inmenso flujo de energía en la zona de la luz visible del espectro, que emerge desde el núcleo y que oculta completamente en las fotografías ordinarias los fenómenos de la atmósfera solar. Si consideramos al Sol en términos de ondas de radio o de rayos X, o de las estrechas «líneas» del espectro visible procedentes de iones y átomos particulares, su clima se revela como un auténtico remolino de actividad. Esparcidas sobre la superficie hay enormes regiones activas, algunas de 150.000 kilómetros de extensión, resaltadas por nubes calientes, en la parte inferior de la atmósfera, que brillan intensamente con luz emitida por gases de hidrógeno y calcio. De la superficie sobresalen ligeras prominencias, mientras que la explosión repentina de una erupción ocasional arroja rociadas de gas al espacio. Por encima de todo flotan enormes concentraciones de gas en la atmósfera superior, que aparecen como trazas brillantes en las fotografías de emisiones de rayos X.

Las auroras son más frecuentes cuando el Sol se encuentra en una época activa de su ciclo de once años. Los registros de auroras brillantes a lo largo de la historia permiten que los astrónomos determinen la pasada actividad solar.
Todas estas «representaciones climáticas» de la región activa proceden por entero de la actividad del campo magnético del Sol. El campo general se produce probablemente por corrientes eléctricas internas, de forma parecida a lo que ocurre con el campo magnético terrestre, y que, a pesar del enorme tamaño del Sol, no es más intenso que el de la fierra. No obstante, el gaseoso Sol no gira de forma sencilla, como ocurre con el rocoso globo terrestre; sus regiones ecuatoriales rotan más rápidamente que el resto, y esto «agita» el campo magnético arrollándolo en torno al Sol cual una fibra elástica.
La capa burbujeante de convección, bajo la superficie, retuerce el campo en «sogas» algunos cientos de veces más intensas que el campo general norte-sur. Estas sogas ascienden hasta los bordes de los grandes supergránulos, y muestran la atmósfera del Sol como un campo espigado cuando se lo fotografía con luz de hidrógeno.
Las concentraciones magnéticas mayores producen las regiones activas, atrapando nubes calientes de gas en la atmósfera inferior y concentrando la tenue atmósfera superior dentro de las zonas de emisión de rayos X que se hallan encima. Incluso estos gases más calientes pueden enfriarse gradualmente y fluir bajo el campo magnético, descubriendo mientras tanto el pasadizo llameante de una prominencia. Cuando campos magnéticos dirigidos en sentido opuesto se encuentran, se aniquilan unos a otros en la furiosa explosión de una erupción.
En el centro de una región activa, la parte más intensa del campo magnético da lugar al único fenómeno que muestran las fotografías ordinarias del Sol: las manchas solares. Las más grandes son reconocibles a simple vista a la salida del Sol, o cuando está algo nublado (insistimos en que nunca se debe mirar al Sol directamente), .y eran conocidas por los chinos desde el año 43 aC. Galileo comenzó el estudio científico de las mismas en 1610, y su insistencia, en cuanto a que un Sol supuestamente perfecto era insostenible debido a las oscuras manchas, constituyó uno de los motivos que le acarrearon conflictos con las autoridades de la Iglesia.
Una mancha solar es oscura únicamente por contraste, ya que está «más fría» que el resto de la fotosfera; y «más fría» significa una temperatura de unos 4.000 ℃. Si pudiéramos aislarlas de la cegadora luz de la cercana fotosfera a 6.000 ℃, las manchas brillarían en un tono rojo anaranjado. Las teorías modernas demuestran que el intenso campo magnético en las manchas —algunos miles de veces el campo de la Tierra— enfriará de forma natural la superficie cuando pase a su través.
Siglos de observación de las manchas solares han revelado que su número visible oscila de forma regular en ciclos de once años. Cada once años, cuando el número de manchas es mínimo, el campo magnético general del Sol cambia: el polo magnético N pasa a ser S por espacio de otros once años. Después de cada inversión, el nuevo campo general «gira» gradualmente, y, como consecuencia de ello, empiezan a aparecer nuevas regiones activas- (con sus correspondientes manchas solares). Tras cuatro o cinco años se alcanza un máximo de actividad, pues los intensos campos magnéticos de las regiones activas en declive se han extendido sobre la superficie solar y empiezan a neutralizar el campo general. Después de once años han logrado invertirlo, y el ciclo comienza otra vez.
§. El «clima» del Sol nos afecta
Dado que nuestra Tierra se halla en órbita dentro de la atmósfera más externa del Sol, no resulta sorprendente que podamos detectar desde aquí señales del ciclo de once años.

Durante el siglo XVII, Europa sufrió inviernos tan rigurosos que el Támesis se heló a su paso por Londres, y los ciudadanos celebraron ferias sobre el hielo. Esta «pequeña glaciación» se originó probablemente en la inactividad temporal del clima magnético del Sol.

La cosecha de uva en zonas de viñedos, como la de Le Lavaridou en el sur de Francia, depende de las buenas condiciones climatológicas. Es posible que la calidad de las cosechas coincida con el ciclo de once años del magnetismo solar, mediante su influencia sobre el clima terrestre.
Las capas radio-reflectantes de la ionosfera terrestre se ven afectadas por el chorro de partículas procedente de las regiones activas del Sol; y, de este modo, la recepción de ondas de radio varía significativamente con el ciclo solar. Los hermosos y resplandecientes velos de luz de las auroras boreales y australes son átomos de nuestra atmósfera cuyos electrones han sido arrancados por partículas solares canalizadas por el campo magnético de la Tierra. El número de auroras, así como su brillo, depende asimismo del ciclo solar. Los registros de auroras se empleaban en el Medievo para representar la actividad del Sol, siglos antes de que las observaciones de las manchas solares se efectuaran con regularidad.
No obstante, el ciclo de once años se manifiesta también en otras circunstancias más sorprendentes: la calidad de las cosechas de vino, así como el número de centuries marcados en criquet de primera división, son consecuencia del ciclo del Sol. El vínculo es el clima de la fierra. Durante el periodo de máxima actividad de manchas solares, el tiempo es generalmente mejor: de aquí que, con menos lluvias, las cosechas sean mejores y peores los partidos de criquet. La analogía deportiva familiar es inglesa, ya que en Inglaterra, normalmente, ¡llueve mucho!; Aunque la correlación entre el «clima» solar y el terrestre parece ciertamente real, ha resultado arduo para los meteorólogos el lograr explicarla. Es fácil entender el modo en que las partículas muy energéticas de las regiones activas pueden afectar la tenue y eléctricamente cargada ionosfera de la Tierra, pero el efecto total sobre la atmósfera inferior debería ser muy pequeño en comparación con la energía adquirida directamente del calor del Sol; y esta energía total que sale del Sol varía muy poco durante el ciclo.
El clima solar afecta en sumo grado a nuestro clima. Durante el pasado siglo XVII, toda la actividad de la superficie del Sol se detuvo durante sesenta años, y la temperatura de la Tierra descendió. Sólo en 0,6 ℃ sobre la media, es cierto, pero fue sin embargo suficiente como para dar lugar a una «mini» glaciación: el Támesis en Londres, por ejemplo, se heló unas diez veces en estos rigurosos inviernos.
John Eddy, del High Altitude Observatory, Colorado, ha investigado incluso más atrás, en la historia del Sol. Comparando los registros medievales de los fenómenos relativos a la actividad solar con la cantidad de carbono radiactivo (carbono-14; en árboles plantados en la época, estableció que el carbono-14 lúe más abundante durante los largos periodos de «tranquilidad solar», como en el pasado siglo XVII. Este resultado no causó gran sensación, ya que el carbono-14 se produce por el impacto de los rayos cósmicos procedentes de las profundidades del espacio sobre los átomos de la atmósfera de la Tierra; y, cuando la actividad solar es débil, la mayor parte de estas partículas rápidas pueden penetrar en el sistema solar.
Sin embargo, en 1977 Eddy sorprendió al mundo científico anunciando que un estudio del carbono-14 en la madera de hace 3.000 años había revelado que la mayor parte de ese tiempo la superficie solar había permanecido muy tranquila. Los periodos de actividad regular del Sol- semejantes al actual que se mantiene desde 1715 dC sólo se presentan esporádica y raramente. Durante el 90% de los últimos 3.000 años, la cara del Sol se ha mantenido imperturbable, mucho más que la sencilla bola de gas de los teóricos de las estrellas. Es una suerte que vivamos una época en la que los campos magnéticos próximos a la superficie solar dejen escapar sus exhibiciones de fuegos artificiales.
§. Los neutrinos perdidos
Si se vuelve aún más atrás, la presencia de las grandes glaciaciones cuando planchas de hielo bajaban desde los polos hasta las zonas templadas de la fierra- pudo haber sido el resultado de profundos acontecimientos sucedidos en el núcleo del Sol. Se han propuesto muchas explicaciones para estas glaciaciones, y la teoría astronómica actual más aceptada supone lentos cambios en la dirección de los polos magnéticos terrestres, así como en la forma de su órbita. Una hipótesis contraria relaciona las intermitentes heladas de la superficie de la Tierra con el horno nuclear del corazón solar; esto se ha comprobado recientemente como consecuencia del experimento de neutrinos descrito al principio de este capítulo. Los primeros resultados de Davis, anunciados en 1968, causaron consternación entre los astrónomos: el número de neutrinos procedentes del Sol era mucho menor que el esperado. En consecuencia, la temperatura del núcleo del Sol debe de ser bastante inferior a la predicha por la bien establecida teoría de la fusión de hidrógeno de las estrellas. El pánico inicial causado por esta noticia disminuye en la actualidad, después de que los astrónomos investigaran esta nueva pista del funcionamiento del Sol. Los resultados del gran tanque subterráneo, recopilados durante años, suministraron ahora un valor bastante exacto del flujo de neutrinos, algo mayor que el increíblemente bajo valor inicial; y los teóricos reelaboraron sus modelos del interior del Sol y. actualmente, predicen un número bastante menor de neutrinos. No obstante, existe todavía una discrepancia real: el corazón solar está más frío que lo esperado.
Sin embargo, los astrónomos jamás carecen de una explicación; y en este caso hay al menos dos hipótesis que pueden explicar la diferencia entre el modelo teórico del Sol y el real, en términos de simplificación del modelo, sin que ello conlleve una revolución de las leyes físicas conocidas. La primera desafía la hipótesis largamente mantenida por los teóricos acerca de que la composición elemental original del Sol, incluyendo su núcleo, era la misma que la de su superficie en la actualidad. Si su superficie actual está realmente compuesta de gas recogido de las nubes interestelares, desde el nacimiento del Sol, esto no constituye necesariamente una buena referencia para conocer el material original del centro, ya que es bastante posible que el núcleo se halle más frío de acuerdo con los resultados obtenidos con los neutrinos. La segunda consiste en que no debemos olvidar que los neutrinos de Davis han abandonado el corazón del Sol tan sólo hace ocho minutos, ya que viajan a través del Sol y del espacio interplanetario a la velocidad de la luz, mientras que la luz y el calor procedentes de la superficie solar han empleado millones de años en desplazarse desde su núcleo; por consiguiente, la luminosidad actual del Sol revela cuánta energía se produjo en el núcleo hace algunos millones de años. El reactor nuclear del Sol podría variar periódicamente su temperatura debido a eventuales combinaciones del gas que le rodea. Así pues, si se hubiera enfriado ligeramente hace unos cuantos millones de años, la temperatura deducida del experimento de neutrinos debería ser realmente menor que la predicha a partir de la luminosidad del Sol. Por otra parte, la temperatura actual más baja del núcleo causará un ligero enfriamiento de su superficie, y, dentro de unos cuantos millones de años, un enfriamiento de la fierra. Si esta hipótesis es correcta, debemos esperar una glaciación mayor en el futuro.
El Sol ha sido, durante casi 5.000 millones de años, un magnífico proveedor de calor y luz para la Tierra. El equilibrio entre las reacciones nucleares y la gravedad en el centro del Sol ha mantenido esta producción prácticamente constante durante mucho tiempo, y si bien algunas pequeñas variaciones han causado nuestras glaciaciones, el calor del Sol nunca varió tanto como para congelar completamente la fierra o hacer hervir sus océanos. Hasta cierto punto, se ha tratado de una feliz coincidencia. Las teorías de la evolución estelar muestran que el Sol se abrillanta poco a poco, y que en la actualidad es aproximadamente una mitad más brillante aún que al principio de la historia del sistema solar; pero, al mismo tiempo, se ha reducido el dióxido de carbono de la atmósfera terrestre gracias a las plantas verdes, y. como resulta de ello, ha disminuido el llamado «efecto invernadero» (por el que una atmósfera de dióxido de carbono mantiene un planeta más caliente que lo espetado:. La combinación de estos dos factores implica que la temperatura de la superficie terrestre se ha mantenido entre las del punto de ebullición y el punto de congelación del agua. En verdad, debemos estar agradecidos, pues sólo un mundo húmedo habría de permitir que evolucione nuestra forma de vida.
Pero, ¿cuál es el futuro lejano del Sol? Evidentemente, nuestra estrella no puede brillar siempre, ya que su almacén de «combustible» de hidrógeno disminuye de continuo y comienza a saturarse con el «residuo» de helio. Las reacciones de fusión nuclear que mantienen al Sol pueden ocurrir únicamente en su propio centro, donde la temperatura y la presión son suficientemente altas y donde, según los cálculos, se encuentra una décima parte de la materia solar. Así pues, una vez que la décima parte del hidrógeno del centro del Sol se haya «transmutado» mediante reacciones de fusión dentro del núcleo de helio inerte, nuestra estrella se encontrará en apuros. Sin hidrógeno en las condiciones deseadas para la reacción, la energía proporcionada disminuirá, y el Sol no contará con ninguna resistencia frente a la omnipotente atracción gravitatoria de su propia masa.
En cualquier caso, no viviremos para presenciar la crisis energética del Sol. Los teóricos estiman que el Sol se encuentra aproximadamente a mitad de camino de su vida de fusión de hidrógeno, v la crisis sobrevendrá en unos 5.000 millones de años. No obstante, como los cuidadosos modelos matemáticos calculados para las estrellas, «construidos» por los teóricos en ordenadores, pueden evolucionar tan rápido como queramos, podemos simular un modelo para el Sol y seguir su evolución después de que el hidrógeno de su centro se haya extinguido.
Durante la fase actual de la fusión del hidrógeno, los residuos de helio se acumulan en el mismo centro formando un corazón muerto en medio de la región de fusión. Resultado de esta producción de «escoria» es el aumento progresivo del brillo del Sol. Pero hasta que el núcleo de helio no sea la décima parte de la masa solar, los efectos no serán evidentes. El modelo de ordenador demuestra que cuando el reactor de fusión nuclear del Sol empiece a agonizar, la gravedad comenzará a contraer el núcleo; pero, aunque parezca extraño, las capas más externas se expandirán. Resulta difícil explicar esta paradoja de forma simple, pero los cálculos no dejan lugar a dudas en cuanto a que, cuando la mayor parte de la masa del Sol se acerque paulatinamente más al centro, se producirá una expansión recíproca de su tenue envoltura más externa.
Las observaciones de los astrónomos apoyan los cálculos de sus colegas, pues el cielo está colmado de estrellas gigantes cuyas propiedades demuestran que se encuentran allende la etapa de fusión del hidrógeno. A diferencia de estas estrellas, que muestran una secuencia clara cuando sus propiedades se representan en un diagrama Hertzsprung-Russell, las gigantes forman una abigarrada multitud. Una estrella de fusión de hidrógeno que, por ejemplo, tenga la misma temperatura superficial que el Sol, debe mostrar aproximadamente el mismo brillo, la misma masa y el mismo tamaño, idénticos en todos los aspectos. Ahora bien, si atendemos a estrellas gigantes con temperatura igual a la de la superficie solar, no podemos establecer ningún modelo: unas son diez veces más grandes y cien veces más brillantes; otras son más grandes aún, y, en consecuencia, más luminosas, sin hablar ya de las enormes estrellas supergigantes diez mil veces más brillantes. La mayoría de las estrellas gigantes tienen superficies más frías que la del Sol, y habitualmente se las denomina gigantes rojas. Por tanto, en la superficie de tales estrellas la gravedad es comparativamente débil y el gas puede contraerse y expandirse cambiando el brillo de la estrella cuando varía su tamaño. Las «pulsantes» más regulares son las estrellas variables Cefeidas, supergigantes amarillas tan brillantes que pueden verse en otras galaxias, y especialmente importantes porque su periodo de pulsación se relaciona precisamente con su brillo medio. Una vez que se identifica una Cefeida por su ciclo regular —aproximadamente semanal -, se sabe cual es su luminosidad intrínseca; comparándosela con la luminosidad aparente, se puede calcular la distancia a que se encuentra. Muchas de las estrellas gigantes y supergigantes son pulsantes; sin embargo, la mayor parte se manifiesta bastante más irregularmente. Incluso la gigante roja más familiar de todas, Betelgeuse (en el hombro de la constelación de Orion}, cambia su luminosidad: durante un año se abrillanta, y luego se oscurece hasta sólo la mitad o un tercio de su brillo máximo.
La diversidad entre las estrellas gigantes proviene del hecho de que, bajo su apariencia similar de superficies pulsantes, tienen núcleos muy diferentes. Todas han dejado atrás la etapa de fusión del hidrógeno, y dentro de sus extensas y tenues capas más externas cuentan con diminutos y muy densos núcleos estrechamente contraídos por la gravedad. Las reacciones y la composición elemental del núcleo dependen de la masa de la estrella y de su edad, y éstos son los factores que deciden su tamaño, su temperatura de superficie y su brillo. De este modo, una gigante con una superficie caliente al rojo a 4.000 ℃, que brillase 30 veces más que el Sol, sería, bien una estrella un 25% más pesada que éste y con una antigüedad de 1.000 millones de años desde que su provisión de hidrógeno central se agotó, bien una estrella del doble de esta masa v cuya «crisis de energía» tuvo lugar hace sólo 30 millones de años.
Así pues, las gigantes rojas permanecen inescrutables con sus enormes envolturas, que ocultan el estado de sus núcleos. A diferencia de las estrellas de fusión de hidrógeno, resulta difícil poder afirmar algo sobre la edad, la masa o el interior de una gigante roja o una supergigante estudiando la luz procedente de ella. Entonces, para tener una referencia debemos contar con los cálculos teóricos del ordenador. Se espera que estas predicciones —sobre los tipos de estrellas gigantes y sus cifras respectivas- coincidan satisfactoriamente con las observaciones de estrellas reales. Así, podremos retornar al futuro del Sol seguros de que nuestro modelo de ordenador constituye una guía razonablemente fiable.
Cuando su núcleo empiece a ser una escoria de helio que se contrae, y su envoltura más externa comience a crecer, aún quedará una estrecha zona en torno al núcleo donde puede continuar la fusión de hidrógeno. De esta manera, el Sol puede todavía radiar energía; y la contracción del núcleo bajo la influencia de la gravitación también creará calor. De hecho, cuando el Sol alcance su «crisis de energía», de acuerdo con los cálculos aumentará su energía total radiada.
El aumento de brillo del Sol en expansión será entonces mala señal para los planetas interiores. Finalmente, dentro de 6.000 millones de años a partir de ahora, el calor del Sol abrasará la superficie terrestre hasta temperaturas insoportables y hará hervir el agua de los océanos. Cualquier superviviente de la especie humana, fuertemente protegido, por cierto, vería salir el Sol sobre la seca superficie de la fierra cual una enorme bola roja, ocupando una décima parte del cielo. Su superficie se dilataría gradualmente rodeando la órbita de Mercurio, y el diminuto planeta herviría dentro de las capas más externas del gigante Sol.
Pero, en este estadio, el núcleo de helio se habrá contraído tanto que la atracción gravitatoria calentará su centro hasta 1,000.000.000 ℃. Entonces, los núcleos de helio colisionarán a velocidades tan altas que podrán combinarse de tres en tres para formar núcleos de carbono, y esta fusión del helio proporcionará súbitamente una nueva fuente de energía al corazón solar. El núcleo se expandirá ahora ligeramente; y esto será contrarrestado por una repentina contracción de las capas más externas del Sol: nuestros hipotéticos observadores de la Tierra verían que el Sol, probablemente en un día, se colapsa hasta ser un globo diez veces menor. Pero la gradual conversión del helio en carbono en el centro reanudaría la expansión de las capas más externas, y, convertido en una gigante roja, el Sol comenzaría otra vez a amenazar a los planetas.
El interior solar tendrá entonces una estructura parecida a una cebolla. Las capas exteriores no se habrán modificado desde la formación del Sol, y consistirán fundamentalmente en hidrógeno.
Más adentro habrá una delgada concha, en donde el hidrógeno esté suficientemente caliente como para fusionarse en helio; y, dentro de ella, otra de helio inerte.

Las glaciaciones terrestres, en las que bloques de hielo descienden desde los polos hasta zonas normalmente templadas, pueden ser consecuencia de cambios periódicos en las reacciones nucleares del núcleo del Sol.
Exactamente en el centro estará la nueva región de reacción, en la que el helio se hallará bastante caliente como para su fusión en carbono; y desde aquí se filtrará la energía hacia afuera para mantener al Sol ante su atracción gravitatoria.
En esta última etapa, los cálculos comienzan a ser inciertos. Las líneas maestras están claras, pero resulta difícil predecir cantidades exactas. El Sol aumentará probablemente hasta su tamaño máximo en menos de cincuenta millones de años desde el comienzo de la fusión del helio, y los últimos cálculos muestran que no será mucho más grande que en su anterior etapa de gigante. La superficie del Sol, mucho mayor que la órbita del entonces sumergido y ya no existente Mercurio, puede amenazar a Venus; pero la Tierra, con mayor órbita, se mantendría fuera de peligro. Nuestro planeta volvería a secarse, y cualquier superviviente de la especie humana se enfrentaría entonces a otra amenaza: las capas más externas del Sol se volverían inestables y serían despedidas al espacio en forma de grandes conchas de gas, portando cada una de ellas un pequeño porcentaje de la materia del Sol. Después de decenas de miles de años, la mitad del gas solar se perdería de esta manera, dejando al diminuto y caliente núcleo solitario en su viaje por el espacio.
Los astrónomos conocen bien estas conchas de gas en expansión que rodean a algunas pequeñas y calientes estrellas, y que aparecen como diminutos discos luminosos en un telescopio pequeño, cual débiles luces o distantes planetas: por ello, el gran astrónomo de inicios del siglo XIX, sir William Herschel, las denominó, erróneamente, «nebulosas planetarias». En un principio músico, Herschel era aficionado a la astronomía, lo que le llevó a descubrir accidentalmente el planeta Urano; esto le valió una pensión del rey Jorge III. Junto con su hermana Carolina observó el cielo cada noche clara durante cuarenta años; uno de sus grandes proyectos fue la clasificación y medida de las posiciones de variados objetos «difuminados» —nebulosas— en el cielo. En la actualidad se conocen cerca de un millar de las nebulosas «planetarias» de Herschel, y los astrónomos modernos las interpretan como una evidencia del final agónico de las estrellas parecidas a nuestro Sol, que terminan sus vidas no con una gran explosión, sino con un vago quejido.
§. Enanas blancas
El núcleo central del Sol estará entonces efectivamente muerto. La provisión de helio se habrá transformado en carbono, y la temperatura nunca será suficientemente alta como para que éste se fusione en otros elementos. El esqueleto central del Sol, despojado de su cubierta más externa, se enfriará durante miles de millones de años, liberando su calor almacenado al frío del espacio. Primero blanca, luego amarilla, enfriándose hasta el rojo y finalmente apagándose, nuestra estrella terminará como una invisible pequeña reliquia en una vasta galaxia, rodeada aún de un séquito de planetas que incluirá a nuestra congelada Tierra.
Los esqueletos de estrellas blancas, amarillas o rojas pueden verse con un telescopio potente. Son pequeñas no mayores que la Tierra— y brillan sólo débilmente. Los astrónomos las han llamado, acertadamente, «enanas blancas». La estrella más brillante del cielo, Sirio, tiene una enana blanca por compañera, sospechada mucho antes de su descubrimiento, cuando se determinó que Sirio se movía en una órbita de 50 años. Dado que Sirio también es conocida como la Estrella del Perro, a su diminuta acompañante se la suele denominar «el Cachorro».
Pero, ¿qué sucede con la inexorable atracción gravitatoria? Cualquier cuerpo del espacio debe de estar sometido a una fuerza que se oponga a su tendencia a colapsarse. Un planeta se mantiene por las interacciones entre los electrones de los átomos próximos. En una estrella que brille activamente, las altas temperaturas escinden los átomos en núcleos y electrones; pero ella mantiene sus capas más externas por el rápido movimiento de estas partículas, calentadas por las reacciones nucleares de su activo centro. Cuando el núcleo del Sol esté totalmente compuesto de núcleos de carbono inerte, habrá otro tipo de presión importante: la de los propios electrones.
En el capítulo 6 hemos visto que, aun cuando los electrones son infinitesimalmente pequeños, la extraña característica dual onda-corpúsculo de la materia implica que dos electrones no pueden hallarse más cercanos que aproximadamente una longitud de onda,, y que la longitud de onda disminuye cuando la velocidad relativa aumenta. En el contraído núcleo del Sol, los electrones y los núcleos se mueven independientemente dentro del plasma a alta temperatura. Pero cuando el núcleo se vuelve más pequeño, los electrones acaban encontrándose con que el espacio entre ellos disminuye hasta una longitud de onda, y empiezan a empujarse buscando sitio. La única solución que tienen es moverse más rápidamente, disminuyendo así sus longitudes de onda con el fin de ocupar menos espacio. En efecto, la fuerza gravitatoria que contrae la estrella comprime sus electrones hasta que se mueven más rápidamente, y los empellones y el rápido movimiento de los mismos suministra la presión para mantener la estrella. La gravitación queda, así, equilibrada.

Una fotografía de gran aumento de la estrella gigante Arturo, tomada por Richard Scaddan con el telescopio Isaac Newton. Las distorsiones se deben por entero a la atmosfera terrestre; pero con una mina técnica, llamada interferometría de speckle, un ordenador puede eliminar estas distorsiones y mostrar algunas estrellas gigantes próximas como discos con regiones luminosas y oscuras, o sea como estrellas puntuales.
Los núcleos en la estrella no resultan afectados por esta gran compresión, ya que la longitud de onda de una porción de materia es inversamente proporcional a su masa, y los núcleos son miles de veces más pesados que los electrones: tienen espacio suficiente y se mueven sin impedimentos. Teóricamente, es posible que haya enanas blancas de carbono, de hierro o de helio: en cada caso los núcleos, tan importantes en planetas y estrellas, no proporcionan sino cargas positivas que contrarrestan toda la carga eléctrica de los electrones, encargándose del «trabajo del burro». Este estado se conoce con la denominación de materia degenerada (y de ello deriva el que algunas publicaciones técnicas tengan títulos que pueden parecer extraños a los no astrónomos: el astrofísico americano Jeremiah Ostriker, por ejemplo, ha escrito un trabajo sobre «las recientes investigaciones en la teoría de las enanas degeneradas»}.
El apretado paquete de una enana blanca se sitúa más allá de nuestra comprensión: una enana blanca típica contiene aproximadamente dos tercios de la materia del Sol, pero comprimida en una esfera tan pequeña como la Tierra; o sea materia un millón de veces más densa que el agua: de este modo, un dedal de enana blanca debería pesar una tonelada. Además, debido a la naturaleza peculiar de la fuerza que mantiene a las enanas blancas, las de mayor masa son más pequeñas que las más ligeras. Mayor masa significa mayor atracción gravitatoria, así como más electrones obligados a moverse con mayor rapidez a efectos de acortar su longitud de onda. Estos pueden agruparse más, y, así, la estrella alcanza un tamaño menor.
Pero hay un límite al que pueden llegar los electrones. Cuando los más rápidos se mueven a velocidades próximas a la de la luz, les resulta cada vez más complicado mantener a la estrella: cálculos precisos muestran que una enana blanca, un 45% más pesada que el Sol, no puede mantenerse por sí misma. Si el núcleo de una agonizante estrella se sitúa por encima de este natural peso límite, sus electrones no pueden detener la contracción indefinida bajo la acción de su propia gravitación. Pasada la etapa de inexorable contracción de la enana blanca, alcanzarán uno de los estados más extraños conocidos por los astrofísicos modernos. Sigamos ahora la historia de una estrella superpesada que habrá de experimentar este destino.
§. La muerte de un peso pesado
Una estrella diez veces más pesada que el Sol debe ser considerada como pródiga. Hemos visto ya que pasará sólo la milésima parte de su vida en su etapa de fusión de hidrógeno, y recorrerá a la misma velocidad los estadios de gigante.
Ni siquiera su núcleo se detendrá en el carbono. La mayor atracción gravitatoria calentará el centro hasta que los núcleos de carbono se fusionen en núcleos más pesados, como los de silicio. Más larde, este «inerte» núcleo de silicio, contraído bajo la gravitación, se calentará y producirá núcleos de hierro. En este estadio de supergigante, la estructura de la estrella es aún más «parecida a una cebolla» que la del Sol en el estadio de gigante. Pueden distinguirse cinco capas diferentes: un núcleo de hierro; conchas sucesivas de silicio, carbono y helio y sus elementos afines; y una envoltura exterior consistente fundamentalmente en hidrógeno. Entre las capas hay «conchas» de fusión en donde los núcleos de cada capa superior se fusionan y caen a la inferior. La energía total emitida por la estrella proviene de las distintas reacciones que tienen lugar a profundidades diferentes.
Ahora bien, el paso de «combustible» a «residuo», para ser empleado nuevamente como combustible a mayor temperatura, no puede durar siempre. Muchos de los grandes núcleos son inestables debido a la repulsión eléctrica entre sus protones; de este modo, la fusión de núcleos de hierro para dar lugar a otros elementos más pesados resulta tarea difícil, pues no sólo no produce ninguna energía, sino que necesita tomarla. El núcleo de hierro se enfrenta así a una crisis bastante diferente a la experimentada con anterioridad por la estrella: ahora no hay forma de producir un flujo saliente de energía, y la inexorable gravitación comprimirá la estrella en una secuencia irreversible haciéndola cada vez más pequeña, cada vez más caliente.
Alguien debe ceder, y, finalmente, el núcleo de hierro renuncia a esta desigual lucha.

Finalmente, el Sol se expandirá hasta convertirse en una estrella gigante roja, con un centenar de veces su tamaño actual. Mercurio, el planeta más interno, se evaporará cuando esté inmerso en las capas más externas del Sol, y la superficie terrestre se cocerá en seco.
El aumento de temperatura implica que los núcleos individuales se muevan más rápidamente, por lo que sus colisiones se hacen más violentas, hasta que literalmente se escinden en diversas partes. Los fragmentos son núcleos de helio; pero hay un precio que pagar. Durante la vida de la estrella supergigante, ésta había fusionado laboriosamente los núcleos de helio en otros sucesivamente mayores, radiando hacia todas partes el exceso de energía producido en estas reacciones. Cuando los núcleos de hierro se escinden, tienen que restaurar la pérdida de energía, y ésta sólo puede provenir del movimiento de aquéllos. Así pues, los núcleos de helio resultantes tienen menos energía de movimiento que los de hierro, y tampoco pueden mantener al núcleo. La gravitación lo comprime cada vez más drásticamente, la temperatura sube más rápidamente, se desintegran más núcleos de hierro y, como resultado, el corazón de la estrella pierde protección y se colapsa con mayor rapidez. El fin ha llegado: el núcleo se precipita al colapso.
La agonía mortal de la estrella se ha mantenido oculta al Universo exterior debido a su inmensa envoltura gaseosa. Pero el secreto no es tal durante largo tiempo. La desintegración suicida de los núcleos produce un vasto flujo de neutrinos desde el centro de la estrella, y un astrónomo en un planeta próximo a la supergigante diagnosticaría, estudiando dicho flujo, el final de la misma.

Salida del Sol en el año 6.000.000.000 dC. El Sol sale como gigante roja sobre una Tierra chamuscada y desolada.
Pero la mayor parte de la inundación final de neutrinos es absorbida por las capas intermedias de la propia estrella; y la energía que ellos transportaban eleva y hace volar las capas más exteriores con una tremenda explosión conocida por los astrónomos como de tipo supernova II.
Tenemos aquí un primer ejemplo de la interacción entre la física de partículas y la astrofísica, en los límites del conocimiento actual. Los primeros cálculos efectuados indicaban que la mayor parte de los neutrinos fluiría a través de la estrella sin afectar las capas exteriores, y que la envoltura de la estrella sería atraída por la gravitación. Por su parte, los astrónomos sabían que las estrellas supergigantes explotan, y la única causa posible parecían ser los neutrinos del centro. La contradicción podría resolverse ahora, pues las reacciones de «corriente neutra» previstas por la teoría unificada de las fuerzas electromagnética-débil de Weinberg y Salam, producirían fuerza suficiente como para detener a los neutrinos dentro de la estrella.
Los teóricos trabajan todavía en los cálculos específicos, y es probable que el desconcierto de los astrónomos para explicar la violencia cósmica de las explosiones del tipo supernova II pueda remediarse con las últimas teorías y descubrimientos en el dominio de las partículas fundamentales.
La enorme concha de gas que explota en el espacio contiene tanta materia como varios soles, su expansión es de unos 5.000 kilómetros por segundo y continuará expandiéndose durante quizá medio millón de años, barriendo mientras tanto el tenue gas interestelar. Este aumento gradual de su volumen retardará la concha en expansión (los restos de supernova) hasta, finalmente, confundirse con el gas interestelar cual un anillo de nubes más densas.
Sólo recientemente han comenzado los astrónomos a estudiar los restos de supernova al detalle, ya que únicamente unas pocas emiten luz visible. Sin embargo, los radioastrónomos pueden captar con facilidad sus señales, y en los últimos catálogos aparecen como un centenar de estos andrajosos fantasmas de estrellas muertas. La joven ciencia de la astronomía de rayos X promete obtener más revelaciones, ya que el gas de las conchas brilla con mayor intensidad a estas longitudes de onda debido a su muy alta temperatura de millones de grados. La inmensa velocidad de las conchas en expansión calienta el gas que ellas barren, de la misma forma que el aire que coge la cabeza de un avión supersónico se calienta por la velocidad de este. Los restos de supernova son de vital importancia en nuestra Galaxia, ya que una estrella masiva es como un ave fénix celeste: de sus «cenizas» en expansión nacen nuevas generaciones de estrellas.
Sigamos ahora el ciclo completo. Al examinar el nacimiento de una estrella —y el de un planeta—, descubrimos que una nube de gas en el espacio podría ser comprimida por los restos de una supernova en expansión. Algunas de las estrellas que nacen en este cúmulo serán estrellas pesadas que explotarán dentro de 10 millones de años; sus restos en expansión volverán a comprimir las nubes de gas que hubiere más allá, y comenzará una nueva generación de estrellas. Al devolver sus gases a la «comunidad» interestelar, las supernovas pagan su deuda con intereses, ya que enriquecen la Galaxia con elementos «pesados». Las conchas que han explotado transportan elementos como el carbono y el silicio que se habían formado en el ardiente interior de la estrella, y los esparcen a través del espacio.
En el principio, según creemos ahora, nuestra Galaxia sólo consistía en hidrógeno y helio. Los demás elementos se fabricaron en el profundo interior de las estrellas y, más tarde, fueron expulsados especialmente por explosiones de supernova. De esta forma, las últimas generaciones de estrellas, como nuestro Sol, contienen un 2% de elementos pesados; y, lo más importante para nosotros, el Sol en formación estuvo rodeado de polvo compuesto por estos elementos que se convirtió en su séquito de planetas. A excepción del hidrógeno y del helio, todos los núcleos de los átomos que componen las rocas de la Tierra, el aire que nos rodea y nuestros propios cuerpos fueron sintetizados en los hornos nucleares, de multimillones de grados, dentro de las estrellas superpesadas.
Una vez más, las fuerzas de la Naturaleza operaron adecuadamente. La gravitación actuó sobre la estrella, superada su etapa de fusión del hidrógeno, llevando su núcleo a temperaturas sucesivamente superiores. Al alcanzarse velocidades mayores, los núcleos cada vez más pesados, y más positivamente cargados, son capaces de aproximarse más de lo que les permitiría la repulsión eléctrica; y la fuerza fuerte de corto alcance interviene entonces para fusionarlos en núcleos aún mayores. Finalmente, en la etapa de núcleo de hierro, el equilibrio entre la fuerza fuerte y la electromagnética dentro de cada núcleo determina que los núcleos mayores sean inestables, y la gravedad se enseñorea otra vez con el propósito de comprimirlo. La escisión de los núcleos resulta de una reacción de la fuerza débil que origina un flujo de neutrinos; y, nuevamente, una reacción de «corriente neutra» de fuerza débil arranca las capas más externas de la estrella y distribuye los grandes núcleos por el espacio. Resulta irónico que el tipo de explosión de supernova II un cataclismo por el cual una estrella es temporalmente cien millones de veces más brillante que el Sol sea resultado de la llamada ¡fuerza nuclear «débil!»
§. Los púlsares
¿Qué sucede con el núcleo de la estrella supergigante, al que dejamos colapsándose cada vez más rápidamente después de que hubo abandonado la desigual batalla frente a la gravedad? Los teóricos más audaces habían sugerido posibles respuestas allá por 1930, cuando la teoría Sobre la evolución de las estrellas estaba en su infancia; pero la confirmación experimental de sus al parecer fantásticas ideas tuvo que esperar a la nueva astronomía de los años 1960 y 1970.
En el otoño de 1967, en un lugar cercano a Cambridge, Inglaterra, Antony Hewish y su equipo construyeron un nuevo tipo de radiotelescopio con el propósito de investigar detalladamente las pequeñas fuentes de radio situadas más allá de nuestra propia Galaxia.

La Nebulosa Hélix, en Aquarius, es una concha de gas expulsada desde la estrella del centro. (El resto de las estrellas se halla m primer termino, o bien en el fondo.) Tales nebulosas parecen discos de planetas cuando se observan en pequeños telescopios, y han recibido el erróneo nomine de «nebulosas planetarias». Fotografía de es observatorios Monte Wilson y Palomar.
Este revolucionario telescopio no es un ejemplar de plato corriente: demasiado grande para ser seguidor, recuerda un campo lleno de alambres de tender la ropa. Utiliza, como componente vital, el chorro de partículas eléctricamente cargadas procedentes del Sol: el «viento solar». Cuando éste silba al pasar por los planetas, sus diminutas irregularidades afectan a las ondas de radio procedentes de las profundidades del espacio, y al radioastrónomo le parece que la fuente «parpadea».

Una estrella supergigante es la etapa final de la luda de una estrella masiva; las reacciones nucleares han creado conchas concéntricas de diferentes elementos. Finalmente, el núcleo de hierro se colapsará, liberando un flujo de neutrinos que arrancará las capas más externas en una explosión de supernova.
Esta es realmente una acertada definición, pues el efecto es muy similar al de las pequeñas irregularidades de la atmósfera terrestre que hacen «parpadear» la luz de las estrellas. Hewish, por cierto, se jacta de que los astrónomos ópticos no entendiesen por completo el parpadeo de las estrellas hasta que los radioastrónomos no efectuaron los cálculos para las ondas de radio en el viento solar.
La cantidad de parpadeo que vemos depende del tamaño aparente de la fuente lejana (a esto se debe el píalos planetas parpadeen menos que las estrellas), y el telescopio de Hewish fue diseñado para detectar los detalles del parpadeo. Pero, simplemente por ser el primer radiotelescopio sensible a los cambios rápidos de brillo chuna fuente de radio, el instrumento de Cambridge se encontró con resultados totalmente inesperados.

Los gases arrojados por una supernova arrastrarán el gas interestelar y lo calentarán liada unos 10.000.000 ℃. Este gas emite copiosamente rayos X, y esta fotografía en seudocolor representa la emisión de rayos X desde Cassiopeia A, los restos de una supernova de 300 años. (Otras fotografías, en pp. 186-7.) Basada en datos obtenidos del satélite Copernicus por Charles. Culliane y Borken.
Entre el cúmulo de registros de las fuentes «parpadeantes», una de las estudiantes de Hewish, Jocelyn Bell (ahora doctora Jocelyn Burnell), advirtió uno que no encuadraba. Una ojeada más profunda reveló el por qué. En vez de parpadear erráticamente, esta fuente lo hacía de forma regular, una vez cada 1,337 segundos. Fácilmente podría haberse tratado de tina interferencia humana, pero observaciones más continuadas mostraron que aparecía en el registro con un adelanto de cuatro minutos cada día. Esto resultaría extraño para una fuente terrestre, pero concordaría con el hecho ele que una fuente celeste incidiera en el haz fijo del telescopio con un adelanto de cuatro minutos diarios como resultado del movimiento de la Tierra alrededor del Sol. La única interferencia posible sería la de un equipo que operase a este rápido ritmo «sidéreo» en otro observatorio astronómico, y se interrumpiese a intervalos de 1,337 segundos. Sin embargo, las indagaciones efectuadas en otros observatorios condujeron a desechar tal posibilidad. Una potente fuente de radio «pulsaba» en el cielo, y se la denominó púlsar.
Algunas mentes especulativas concluyeron de inmediato que el «telescopio de cuatro acres» captaba señales de un (aro cósmico, una comunicación de una civilización extra- terrestre. Era importante investigar si tales señales provenían de una fuente natural antes de que los periódicos sensacionalistas anunciasen el descubrimiento de vida extraterrestre, por lo que el equipo de Hewish llevó a cabo otras investigaciones antes de publicar estas noticias.

Dos vistas del centro de la Nebulosa del Cangrejo que muestran el púlsar. Por medio de una técnica estroboscópica, las dos imágenes están separadas por 1/60 de segundo. En ambas se puede identificar el mismo fondo de estrellas, pero el púlsar del Cangrejo se halla únicamente «en» la fotografía de la derecha: es un faro cósmico cuyo haz gira cada 1/30 de segundo. Fotografías del Observatorio Lick.
La señal del púlsar era tan precisa que se podría medir el ligerísimo cambio de su periodo cuando la Tierra completase su órbita en torno al Sol, y, como esta variación coincidió exactamente con lo esperado, la fuente de radio no podía estar moviéndose en órbita alrededor de otra estrella: no era un faro establecido en un planeta.
Esto pareció excluir un mensaje interestelar, y Jocelyn Bell confirmó que el caso tenía un origen natural cuando investigó los registros y descubrió otros tres púlsares más débiles. Era excesivo suponer que cuatro civilizaciones diferentes procurasen vincularse con la Tierra simultáneamente.
Cuando las observaciones mejoraron, llegó a ser obvio que la gran regularidad de los púlsares únicamente podría ser causada por el giro de una estrella muy pequeña y densa, incluso más pequeña que una enana blanca. Sólo había un candidato posible: la estrella de neutrones. En 1932, menos de un año después del descubrimiento del neutrón, el brillante físico soviético Lev Landau predijo que la Galaxia puede contener estrellas constituidas totalmente por neutrones. Tal como las enanas blancas se mantienen por la presión de los apretujados electrones, una estrella de neutrones se mantiene por los empujones de neutrones empaquetados tan apretadamente que su separación es aproximadamente la longitud de onda del neutrón. Puesto que los neutrones son casi dos mil veces más pesados que los electrones, sus longitudes de onda son menores y pueden empaquetarse mucho más próximos entre sí que aquéllos. Aun cuando una estrella de neutrones tiene sólo unos cuantos kilómetros de extensión, contiene tanta materia como el Sol: una cabeza de alfiler de materia de una estrella de neutrones pesaría un millón de toneladas.
En 1933, dos astrónomos americanos, Walter Baade y Fritz Zwicky, señalaron que las estrellas de neutrones podrían formarse a partir de los núcleos sin explotar de supernovas. Cuando el núcleo se colapsa en la etapa pesada de enana blanca, los electrones están obligados a acercarse más de lo «permitido», y su único remedio es combinarse con protones para formar neutrones. En este caso extremo, los neutrones son las partículas más estables, pues no resulta posible una desintegración en protón y electrón debido a que no hay espacio que el electrón pueda ocupar.
Durante cuarenta años, las estrellas de neutrones quedaron relegadas al remanso de los astrofísicos. Incluso si existiesen, pensaban los astrónomos, serían demasiado débiles como para ser detectadas. Sin embargo, con el descubrimiento de los púlsares se recuperaron y desempolvaron las viejas teorías; y una estrella de neutrones en rotación había de ser la respuesta al misterio del púlsar. Estas estrellas tienen intensos campos magnéticos comprimidos, por estar atrapados en el núcleo colapsado; en alguna parte, de este campo (los detalles exactos aún se discuten) se produce un haz de ondas de radio. Este haz, debido al giro de la estrella, barre el cielo al igual que la lente giratoria de un faro, y el radioastrónomo terrestre ve los «destellos» o «pulsos» de esta señal de radio tal como el marinero ve la secuencia regular de los destellos de la luz del faro.
La vindicación final llegó en 1968, cuando los radioastrónomos descubrieron un púlsar en la famosa Nebulosa del Cangrejo.

La Nebulosa del Cangrejo esta constituida por los restos de una estrella que vieron explotar los chinas en el ario 1054 dC. Las capas más externas tienen forma de filamentos retorcidos, lo que ha dado el nombre a la nebulosa, y el núcleo de la estrella original se ha colapsado hasta llegar a ser una estrella de neutrones o un púlsar (véase las fotografías anteriores).
Esta extraña nebulosidad fue bautizada así en el siglo XIX por el tercer Conde de la Rosa, quien descubrió unas pinzas en forma de filamentos que se extendían desde la nebulosa oval. Observaba en su ancestral casa en el corazón de Irlanda con un inmenso e inmanejable telescopio, que, sorprendentemente, fue el mayor del mundo durante 72 años, hasta que se instaló el Hooker de «100 pulgadas» en 1917 en Monte Wilson, bajo los claros cielos californianos. Las fotografías modernas muestran la retorcida nebulosa mejor de lo que puede apreciar el ojo con cualquier telescopio; y, hasta cierto punto, se explicó el misterio de su extraña apariencia cuando se descubrió que coincidía con la posición de una supernova vista y registrada por los chinos en el 1054 dC., una explosión tan brillante que fue visible a pleno día durante 23 días. Por consiguiente, la Nebulosa del Cangrejo es los restos de una supernova infrecuentemente potente, tanto como fuente de luz como de radio.
El descubrimiento del púlsar del Cangrejo resolvió varios misterios a la vez. Su posición en el centro de la nebulosa mostró que los núcleos de supernova pueden realmente convertirse en estrellas ele neutrones, y señaló la posición de una débil estrella visible a la que durante largo tiempo se había sospechado como núcleo muerto de una estrella.
El púlsar del Cangrejo es el más rápido de los conocidos; pulsa 30 veces por segundo (visto de cerca, desafía la imaginación: una bola de 25 kilómetros de extensión, tan pesada como el Sol, girando 30 veces por segundo).

Las ondas de radio procedentes de púlsares y la luz procedente de los púlsares del Cangrejo y de Vela deben estar originadas por electrones rápidos que se mueven en el campo magnético del púlsar, y que son emitidos como un estrecho «haz de faro». Aquí se muestran dos situaciones posibles para la radioemisión, pero sólo investigaciones posteriores pueden decidir cuál es la alternativa correcta.
Los astrónomos ópticos se abocaron de inmediato a la estrella visible usando técnicas especiales, y también descubrieron que parpadeaba a este ritmo demasiado rápido como para ser observado con el ojo, y con un periodo tan breve que su luz debería promediarse sobre una fotografía.
Investigaciones posteriores mostraron que todos los púlsares se hacen gradualmente más lentos cuando pierden energía de rotación. El púlsar del Cangrejo no constituye una excepción, y su pérdida de energía es transportada a los alrededores de la Nebulosa del Cangrejo: éste es el secreto del brillo poco corriente de la misma.
Estas observaciones de los púlsares concuerdan totalmente con la teoría de los interiores de la estrella de neutrones. El grueso de la estrella está compuesto por neutrones degenerados, que se mueven en completa libertad (como un superfluido), y las corrientes debidas al movimiento de los neutrones pueden generar el intenso campo magnético del púlsar. Precisamente en el centro, los neutrones están tan apiñados que pueden reaccionar y producir una pequeña proporción de agrupaciones más pesadas de quarks: las «antiguas partículas fundamentales» conocidas con las letras griegas sigma, lambda y delta. Por este motivo, el núcleo de una estrella de neutrones ha sido adecuadamente denominado «la rica sopa del alfabeto griego».
La capa más externa de la estrella de neutrones es, efectivamente, una sólida corteza, construida al igual que una enana blanca, con núcleos de hierro esparcidos en un «mar» de neutrones degenerados. Puede haber montañas en su superficie, pero la intensa gravitación de las estrellas de neutrones les impedirá superar la altura de unos pocos milímetros. No obstante, la intensa atracción implica asimismo que será necesaria más energía para salvar este promontorio de un milímetro en una estrella de neutrones que para ascender al monte Everest en la Tierra. Además, la sólida corteza puede sufrir «temblores» cuando el púlsar se desacelera y su bulto ecuatorial —causado por su alta velocidad de giro empieza a disminuir. Los radioastrónomos consideran este fenómeno como un repentino aumento en la velocidad de rotación, y han observado una súbita aceleración del púlsar del Cangrejo debida a la contracción repentina del radio ecuatorial en una simple centésima de milímetro.

Una estrella es un ave fénix, sus cenizas dan lugar a nuevas estrellas. Esta es la región central de la .Nebulosa de Orion, en la que se han formado recientemente las cuatro estrellas más internas (el Trapecio). Muchas nebulosas sólo comienzan a colapsarse para formar estrellas cuando se comprimen por explosión de una supernova próxima: y, por cierto, las jóvenes estrellas del Trapecio contienen elementos originados en generaciones previas de estrellas ahora destruidas, fotografía del observatorio Lick.
Ahora, los púlsares han dejado de ser extraños para los radioastrónomos. En los últimos diez años se han encontrado unos 300, con periodos de rotación que van desde el de 1/30 de segundo del púlsar del Cangrejo hasta 4 segundos. Por el contrario, sólo se ha descubierto una fuente ópticamente pulsante. Situada en la constelación austral de Vela, este púlsar «visible» fue detectado por los astrónomos que manipulaban el gran telescopio anglo-australiano de Siding Spring en Nueva Gales del Sur.
Utilizando detectores electrónicos diseñados sólo para registrar luz pulsante de la misma frecuencia que el radio púlsar, hallaron una fuente pulsante excesivamente débil como para ser medida por cualquier otro método: la prensa declaró que los astrónomos británicos habían descubierto la estrella más débil jamás detectada.
Los astrónomos que investigan la estadística de los periodos de los púlsares, así como los retardos, han calculado que un púlsar medio emite sus ondas de radio sólo durante unos cuantos millones de años. Luego, sus pulsos se harán más esporádicos y, finalmente, desaparecerán. Aún más sorprendentemente, la estadística muestra que los púlsares deben nacer cada cinco años, más o menos, en nuestra Galaxia, ya que se mantiene el número de los observados aun cuando las supernovas tengan lugar mucho menos frecuentemente. Si esta conclusión es correcta, quizá sólo unos cuantos púlsares sean núcleos colapsados de supernovas; y los astrónomos tendrán que atender a otros tipos de estrellas como progenitores de la mayor parte de los púlsares, por lo que aún pueden deparar supresas.
Los agujeros negros suenan a ciencia ficción; no obstante, se los predijo por vez primera en 1795. Su existencia es cada vez más evidente, pese a que no los podamos «ver».

La Nebulosa del Velo en Cygnus son los restos, hechos jirones, de la explosión de una supernova hace 20.000 años. El pequeño núcleo de la estrella original puede haberse colapsado tanto como para haberse transformado en un agujero negro, una región del espacio con gravitación tan intensa que está separada del resto del Universo.
§. El célebre oficinista de patentes
§. Einstein frente a Newton
§. La compañera invisible
§. La explotación de los agujeros negros
§. La explosión de los agujeros negros
«Agujero negro = traviesa expresión.» Tal era el mensaje escrito en la pizarra en una de las sesiones de la Unión Astronómica Internacional, en 1970. Y en realidad, no eran los astrónomos experimentales los únicos en rechazar este improbable fruto de la imaginación de los teóricos, pues un agujero negro suena a ciencia ficción: una pequeña región del espacio donde la materia desaparece para siempre de nuestro Universo, una especie de «agujero en el espacio»; y, además, un agujero que no puede verse, pues absorbe toda la luz. Ni los más prestigiosos científicos estaban preparados para admitir la idea de agujeros negros en nuestro Universo.
Esta opinión ya se ha modificado. Los astrónomos, mediante un proceso de eliminación, se han visto obligados a aceptar los agujeros negros como el único camino para explicar ciertos objetos astronómicos. Como Sherlock Holmes, han tenido que admitir que cuando el imposible ha sido eliminado, todo lo que queda, aunque sea improbable, debe ser lo cierto. Así, los agujeros negros han empezado a ser aceptados por los astrónomos. Su extraña naturaleza ha dado lugar a divulgaciones sensacionalistas: viajes a otros universos, «miniagujeros» negros que colisionan con la Tierra, agujeros «blancos». ¿Qué hay de cierto en torno a los agujeros negros?
Aunque parezca sorprendente, la idea data de 1795 y se encuentra en el gran tratado sobre la gravitación y el sistema solar intitulado Exposition du système du Munde, de Pierre-Simon Laplace. Según la teoría de la gravitación de Newton, la intensidad de la atracción gravitatoria en la superficie de un objeto esférico depende de su masa y de su radio. Si la Tierra tuviese dos veces más materia, pero el mismo radio, su gravedad sería el doble de intensa. De la misma forma, si la Tierra estuviera concentrada en un radio menor pero con la misma cantidad de materia que contiene, la gravedad en la superficie aumentaría. Podemos también pensar esto en términos de velocidad de escape. Despreciando la resistencia del aire, cualquier cosa que se lance hacia fuera con velocidad mayor a 11 kilómetros por segundo puede escapar totalmente de la Tierra, pues aunque está continuamente frenada por la gravedad terrestre, este efecto disminuye a medida que se aleja, de modo que nunca se detendrá. La velocidad de escape también depende de la masa y del radio del cuerpo en cuestión: Laplace verificó que un cuerpo de la misma densidad que la Tierra, pero 27.000 veces mayor, contendría 20 billones de veces la materia de ésta; en tales condiciones, la velocidad de escape sería igual a la velocidad de la luz (300.000 kilómetros por segundo). Imaginó a la luz viajando como una sucesión de pequeños proyectiles, y dedujo, bastante correctamente, que ésta no podría escapar de un cuerpo semejante; en otras palabras, las estrellas más grandes y masivas del Universo serían invisibles.
Aun cuando sabemos que las hipotéticas estrellas de Laplace no pueden existir, su idea básica tuvo gran resonancia. Si se combina una gran masa y un radio pequeño es posible obtener un cuerpo del cual la luz no pueda escapar. No obstante, los teóricos modernos piensan en los agujeros negros en términos diferentes, pues la teoría de la gravitación de Newton ha sido reemplazada por la de Einstein, y la idea de la luz desplazándose en forma de pequeños proyectiles ha sido sustituida por la teoría cuántica de la dualidad onda-corpúsculo.
§. El célebre oficinista de patentes
Las grandes contribuciones a la ciencia de Albert Einstein empezaron en 1905, cuando tenía 26 años y trabajaba en una oficina de patentes en Berna. Ese año escribió tres importantes trabajos científicos, uno de los cuales estaba destinado a alterar nuestra forma de pensar acerca de los conceptos de espacio y tiempo. Titulado modestamente Sobre la electrodinámica de los cuerpos en movimiento, constituyó el primer paso para la comprensión de la teoría unificada de los campos eléctrico y magnético, establecida por Maxwell unos cuarenta años antes. En lo que nadie hasta Einstein había reparado era en que esta teoría predecía que la velocidad de la luz es siempre la misma para cualquier observador. Si medimos la velocidad de la luz procedente del Sol, ésta sería de 300.000 kilómetros por segundo. Supongamos ahora que pudiésemos lanzarnos en un cohete hacia el Sol a 200.000 kilómetros por segundo. En los pocos minutos anteriores al devastador encuentro con la superficie solar, ¿podría ser que la velocidad de la luz solar nos pareciese de 200.000 + 300.000 = 500.000 kilómetros por segundo? Las ecuaciones de Maxwell dicen que no, que la medida sería aún de 300.000 kilómetros por segundo. Y no cabe duda de que las ecuaciones de Maxwell son básicamente correctas, pues han explicado las propiedades de la luz como fuerzas eléctrica y magnética, y han predicho las ondas de radio antes de su descubrimiento.
Einstein siguió las implicaciones de este inesperado resultado y descubrió que no coincidían con la idea intuitiva de que el espacio y el tiempo son invariables para cualquier observador independientemente de cómo se mueva. Si dos naves espaciales idénticas se cruzasen a muy alta velocidad por ejemplo, a 270.000 kilómetros por segundo, el 90% de la velocidad de la luz, la tripulación de cada una de ellas se sorprendería de la apariencia de la otra nave. Esta sería sólo la mitad de larga de lo esperado, y, si su masa pudiera medirse a toda velocidad, parecería ser doblemente masiva. Además, comparando los relojes, los de la otra nave parecerían moverse sólo a la mitad de rapidez que los de nuestra propia nave. Estos efectos son complementarios: cada una de las tripulaciones advierte que la otra experimenta estos extraños efectos, y como lo importante es el movimiento relativo de las naves, cada tripulación cree que su nave está en reposo y es la otra la que se mueve; por esto, la teoría recibió la denominación de relatividad.
Las .nociones del cambio de longitud y masa de un objeto, sólo porque se mueve respecto a nosotros, pueden parecemos absurdas en nuestra vida cotidiana, pero esto se debe simplemente a que todas nuestras velocidades son incomparablemente menores que la velocidad de la luz. Un coche lanzado a 100 kilómetros por hora se contrae aproximadamente el diámetro de un núcleo atómico, algo excesivamente pequeño como para ser medido. Sin embargo, en los aceleradores de partículas, donde las partículas subatómicas se aceleran hasta velocidades próximas a la de la luz, estos efectos son muy notables.

Sir Isaac .Newton fue el primero en formular una temía de la gravitación universal, tras haberse inspirado al ver caer una manzana. Esta teoría de siglos ha sido reemplazada ahora por la de Einstein, que predice la existencia de agujeros negros, considerados normalmente como una idea muy moderna.
Aun cuando los físicos de partículas no puedan medir la contracción experimentada por partículas casi puntuales, pueden detectar fácilmente el aumento de su masa y el retardo temporal, observando que las partículas inestables viven más cuando están en movimiento.
Al aumentar la velocidad, todos los efectos se intensifican. A velocidades próximas a la de la luz, los relojes naturales se retrasan hasta que efectivamente se detienen, las longitudes se contraen hasta cero y las masas aumentan indefinidamente hasta infinito. Por esta razón resulta imposible alcanzar la velocidad de la luz, y, más aún, sobrepasarla. Tendríamos que suministrar cada vez más energía a cuerpos paulatinamente más masivos con rendimientos decrecientes en velocidad. La velocidad de la luz es la velocidad límite del Universo (los propios fotones de luz se desplazan a este límite de velocidad porque tienen, en efecto, masa cero: tampoco puede lograrse que un fotón se desplace con mayor lentitud que la velocidad de la luz).
Dos años después, Einstein verificó que ya que la energía del movimiento incrementa la masa de un cuerpo, debería existir una equivalencia entre masa y energía, por la cual la materia - en reposo podría transformarse en energía pura bajo circunstancias adecuadas. Esta relación puede resumirse en la famosa ecuación E = mc2, hoy día ya comprobada en los reactores nucleares y en las terribles bombas nucleares.
§. Einstein frente a Newton
Sin embargo, esta primera teoría, la teoría especial de la relatividad, no incluye ni la gravitación ni los efectos de la aceleración. Era sencillamente imposible introducir la teoría de Newton en la de la relatividad especial, y obtener así una teoría gravitacional aceptable. Diez años le llevó a Einstein ampliar la teoría especial, y su teoría general de 1915 es, en la actualidad, la teoría de gravitación aceptada.
Partió de un extraño fenómeno de la Naturaleza. Cuando conducimos, si pisamos bruscamente el acelerador nos sentimos impelidos en nuestro asiento hacia atrás por la inercia. Si seguimos acelerando suavemente, la fuerza que nos empuja hacia atrás se experimenta de igual forma que la fuerza de la gravedad que nos impele hacia abajo. Einstein supuso que existía algún tipo de equivalencia básica entre la fuerza gravitatoria y la de inercia, y en esto fundamentó su teoría. En esencia, según la teoría de Newton, lo mismo podríamos decir que el coche acelera hacia adelante o que la Tierra y la carretera lo hacen hacia atrás, debido a la fuerza de inercia que nos empuja contra el asiento. Einstein necesitaba una teoría que preservase la idea de relatividad, es decir en la que no fuera posible determinar si el que acelera es el coche o la carretera (observemos que si la velocidad es constante, no podemos afirmar quién se mueve, y éste es el caso de la relatividad especial.
Supongamos que pensamos en el coche como algo estacionario, y que el resto del Universo acelera hacia atrás. Para explicar cuál es la fuerza que sentimos que nos impele hacia atrás, podemos sostener que cuando todo el Universo (a excepción del coche) acelera, produce una fuerza gravitatoria extra que nos empuja hacia atrás. Aun cuando estos «experimentos mentales» puedan parecer desesperadamente filosóficos, a partir de ellos, y con la ayuda de complicadas matemáticas, Einstein fue capaz de formular una nueva teoría del movimiento y de la gravitación, que predecía los mismos resultados que la de Newton cuando la gravitación es débil caso de la órbita de la Luna en torno a la Tierra, por ejemplo—, pero que representaba notables diferencias para campos gravitatorios fuertes.
Obtuvo su primer logro con la órbita de Mercurio. Este pequeño planeta se mueve por un extenso camino cercano al Sol, y el eje mayor de la órbita se mueve gradualmente en torno a él. La mayor parte de este movimiento se debe a la atracción gravitatoria de los demás planetas, y podría explicarse por la teoría de la gravitación de Newton; sin embargo, no habría concordancia suficiente entre las cantidades medidas y las predichas. Los astrónomos buscaban en vano otro pequeño planeta que se hallase en órbita más próximo al Sol que Mercurio, y que pudiera perturbar su movimiento. Mercurio, cercano a un lugar en el que la atracción gravitatoria del Sol es relativamente intensa, fue el único planeta para el cual las ecuaciones de Einstein daban diferente respuesta que las de Newton; para más, las de Einstein concordaban con las observaciones. Así pues, el movimiento «anómalo» de Mercurio se debía, simplemente, a que los astrónomos empleaban la teoría gravitacional incorrecta.
Un efecto más convincente aún, y que Einstein predijo antes de que se realizaran las mediciones, es el relativo a la desviación de la luz de las estrellas debido a la gravedad. Cuando una estrella se encuentra casi detrás del Sol en el cielo, su luz tiene que atravesar el intenso campo gravitatorio de éste; Einstein mostró que se tendría que desviar ligeramente, de forma que la estrella parecería estar en una posición ligeramente diferente. Las estrellas sólo pueden verse cerca del Sol cuando la luz de este último queda bloqueada por la Luna durante un eclipse total, y la primera oportunidad de comprobar la predicción de Einstein tuvo lugar al final de la primera guerra mundial: una expedición británica en la pequeña Isla de Príncipe, en la costa africana, observó el eclipse del 29 de mayo de 1919, y las fotografías obtenidas mostraron que las imágenes de las estrellas estaban desplazadas en la cantidad predicha por Einstein. El mundo, agotado por la guerra, advirtió con este oportuno ejemplo la auténtica internacionalidad de la ciencia; e incluso sin llegar a comprender realmente lo que representaba el haber refundido la estructura del espacio-tiempo, la prensa popular hizo que el nombre de Einstein fuera familiar en todo el mundo.
La llamada tercera «comprobación» de la relatividad general se relaciona directamente con el tema de los agujeros negros. Einstein demostró que la luz pierde energía cuando atraviesa un campo gravitatorio; puesto que un fotón individual de luz siempre se desplaza a la misma velocidad (velocidad de la luz), las pérdidas de energía deben provenir de la energía interna del fotón. Y según la fórmula de Planck, que relaciona energía y longitud de onda, la disminución de energía interna del fotón significa que aparece como radiación de mayor longitud de onda. Por consiguiente, en teoría, un fotón emitido desde la superficie del Sol llegará como un fotón de longitud de onda ligeramente mayor (ligero corrimiento hacia el extremo rojo del espectro) cuando se lo reciba en la Tierra. Este corrimiento hacia el rojo puede medirse, ya que los átomos de la atmósfera solar emiten luz a determinadas longitudes de onda, las líneas espectrales. Comparando las longitudes de onda de las líneas del Sol con las del mismo tipo de átomos en el laboratorio, los astrónomos comprobaron que la gravitación del Sol desplazaba realmente sus líneas en la cantidad predicha por Einstein. (Experimentos más precisos de laboratorio —que utilizan rayos gamma, que viajan hacia arriba en el campo gravitatorio terrestre— han verificado con mayor precisión, para estos fotones de longitud de onda más corta-, el corrimiento de Einstein.)
Astronómicamente hablando, la gravitación del Sol es bastante débil: las desviaciones hacia el rojo de las líneas espectrales son de sólo dos partes por millón. El efecto de Einstein sobre la radiación se relaciona con la velocidad de escape de cuerpos masivos, ya que en ambos casos la «partícula en estudio», al viajar hacia arriba, pierde energía en su lucha contra la atracción gravitatoria. Una estrella enana blanca, cuya masa sea aproximadamente la del Sol, pero cuyo radio fuera tan pequeño como el de la Tierra, tendría un corrimiento de Einstein unas cien veces mayor. Aun así, no resulta fácil medir con precisión las longitudes de onda de las líneas del espectro de estas
débiles estrellas; y aún se presenta otro problema: una línea espectral de una enana blanca puede desviarse ligeramente por efecto Doppler, según que se mueva acercándose o alejándose de nosotros. Seleccionando enanas blancas en sistemas binarios, los astrónomos pueden soslayar en parte este problema, ya que la desviación media de la longitud de onda de la otra estrella (debida exclusivamente a efecto Doppler), tomada sobre una órbita completa, nos informa de la velocidad del sistema binario a través del espacio. Se observa entonces que la enana blanca tiene una desviación media de longitud de onda ligeramente más roja que la de su compañera, y, de este modo, dentro de los límites de esta dificultosa e imprecisa medición, se obtienen resultados acordes con la desviación predicha por Einstein.
En un paso a objetos todavía más pequeños y más densos, reclaman nuestra atención las estrellas de neutrones. La teoría de Einstein predice que la desviación hacia el rojo de una de estas estrellas, tan masiva como el Sol y de sólo 25 kilómetros de extensión, es casi del 15%. Un fotón que pretenda escapar de la gravitación desde la superficie de una de estas estrellas tiene que entregar una séptima parte de su energía. Desgraciadamente, las superficies de las estrellas de neutrones no emiten líneas espectrales, por lo que esta predicción no puede comprobarse de modo directo, pero sí muestra que, incluso entre los recientemente aceptados miembros de nuestra Galaxia, la fuerte gravedad afecta la forma en que vemos las cosas.
Ingresamos aquí en el dominio de los agujeros negros. Existe un límite para la masa máxima que puede tener una enana blanca antes de que los electrones deban ceder a la atracción gravitatoria; también las estrellas de neutrones tienen una masa límite. Cuando la compresión gravitatoria es demasiado alta, los neutrones reaccionan para formar partículas más pesadas las de la «sopa del alfabeto griego» mencionadas anteriormente, cuyas longitudes de onda más cortas permiten que la estrella de neutrones se contraiga más. La masa límite depende exactamente de cuáles son las reacciones nucleares que tienen lugar a las altas energías implicadas: una vez más, los astrofísicos necesitan los resultados de los físicos de partículas de altas energías con el fin de que les ayuden a comprender la causa de su punto de ruptura. Sin embargo, las estrellas de neutrones tres veces más pesadas que el Sol no pueden soportar la gravedad (y el límite puede ser menor que ésta).
Sigamos nuevamente el destino de las estrellas masivas; esta vez, el de una estrella treinta veces más pesada que el Sol. Una estrella semejante pierde gran cantidad de materia de su superficie en forma de «viento estelar» cuando llega a ser supergigante, y puede desprenderse>de la mayor parte de sus capas más externas en una explosión de supernova. Aun así, su núcleo colapsado será todavía unas cinco veces más pesado que el Sol. Al colapsarse pasa al estadio de enana blanca, pero sobrepasa el límite de peso para estas estrellas y se contrae a las densidades de estrella de neutrones. Sin embargo, nuevamente se sitúa por encima del límite que soportan los neutrones, y el colapso continúa. Con el radio del núcleo contraído, la velocidad de escape de su superficie aumenta cada vez más rápidamente, y los fotones de luz encuentran mayor dificultad para escapar del campo gravitatorio.

La estructura interior de una estrella de neutrones a escala ordinaria. Pese a su pequeño tamaño, las estrellas de neutrones pueden detectarse, bien como púlsares de radio (capítulo anterior), bien como fuentes de rayos X originadas cuando el gas caliente, procedente de una compañera próxima, describe una espiral sobre ellas.
Finalmente y todo esto ocurre en un segundo—, la atracción gravitatoria en la superficie de la estrella es tan intensa que los fotones de luz no pueden escapar, perdiendo toda su energía en el empeño.
Desde un lugar seguro fuera de la estrella podríamos observar si tuviéramos un telescopio suficientemente potente cómo el núcleo se contrae rápidamente hasta alcanzar su tamaño crítico y, a continuación, se desvanece en una milésima de segundo. El diminuto núcleo, intensamente brillante, desaparecería de nuestra vista debido a su propia gravedad. De hecho, una vez contraído por encima de su tamaño crítico, ya no podemos verle, y nada podemos conocer acerca del núcleo muerto. La luz y otras radiaciones no pueden escapar de su intenso campo gravitatorio. El tamaño crítico es aquél para el que la velocidad de escape ha aumentado hasta la velocidad de la luz; y dado que ningún cuerpo material puede moverse con mayor rapidez que la luz, ninguna partícula material puede escapar desde el campo gravitatorio del núcleo colapsado. Puesto que el núcleo se hace cada vez más pequeño, nunca podremos saber lo que sucede dentro de una esfera imaginaria, igual al núcleo en su tamaño crítico. Esta superficie imaginaria, que encierra una pequeña región del Universo de la cual no podemos conocer nada, se denomina horizonte de sucesos, o, más gráficamente, agujero negro.
Un agujero negro es «negro» supuesto que ni la luz ni cualquier otra radiación puede escapar de él. Es un «agujero» porque los objetos pueden caer en él, pero nunca volver a escapar. Incluso un haz de luz que iluminara un agujero negro sería capturado por él y no reflejaría luz alguna. La ciencia ficción llegó a su apogeo gracias a estos invisibles agujeros negros del espacio, que aguardan al imprudente viajero espacial que desconoce su sino hasta que siente, demasiado tarde, que su nave es atraída cada vez más rápidamente por la gravitación de algo invisible. Una vez que atraviesa el horizonte de sucesos, sus compañeros del exterior pierden contacto con él para siempre. El viajero espacial puede ver todavía el Universo exterior, ya que la luz procedente de fuera puede entrar fácilmente en el agujero, pero su visión del interior del mismo, mientras se precipita hacia su centro, será efímera.
En esbozo, este escenario es cierto, pero los agujeros negros han adquirido una falsa reputación de codiciosos basureros que «aspiran» cualquier cosa que atraviese las orillas de sus campos gravitatorios. De hecho, la atracción gravitatoria de un agujero negro fuera de su horizonte de sucesos no difiere de la de cualquier cuerpo celeste. El Sol atrae a la Tierra continuamente, y sin embargo la Tierra no es «absorbida» por nuestra estrella, ya que su movimiento orbital equilibra con exactitud la atracción solar. Si el Sol se contrajera de súbito hasta convertirse en agujero negro, la atracción gravitatoria experimentada por la Tierra no se alteraría en lo más mínimo: nuestro planeta continuaría girando en torno a su nuevo y oscuro dueño, tan fielmente como gira en torno al Sol.

El gas procedente de la estrella mayor de un sistema doble puede fluir sobre su compacta compañera, formando un «disco de captura» espiral en torno a ella. Cuando la estrella pequeña es una estrella de neutrones o un agujero negro, este disco de captura está suficientemente caliente como para emitir copiosas cantidades de rayos X, detectables desde satélites en órbita terrestre.
Si se sigue considerando el sistema solar, un cometa, atraído desde las profundidades del espacio por la gravitación del Sol, tiene habitualmente un movimiento bastante «sesgado» con objeto de esquivar al disco solar, y se balancea simplemente como consecuencia de su proximidad, antes de retornar a las zonas más exteriores del sistema solar. De igual modo, una nave espacial que se aproxime a un invisible agujero negro en el espacio, es muy improbable que se dirija en línea recta hacia él (el Sol como agujero negro tendría sólo 6 kilómetros de extensión), y el viajero espacial simplemente experimentaría que su nave se acelera, oscila en torno a la invisible estrella colapsada y .egresa al espacio por un nuevo camino, quedando perplejo y agitado, pero ¡todavía en nuestro Universo!
§. La compañera invisible
Pero, ¿existen realmente agujeros negros en nuestra Galaxia? Ciertamente, la teoría de la evolución de las estrellas así lo sugiere, ya que, a menos que todas las estrellas pesadas pierdan aproximadamente un 90% de su masa, sus núcleos no se quedarán en enanas blancas o estrellas de neutrones. La evidencia directa es difícil de obtener, pues los agujeros negros son muy pequeños y, por definición, invisibles. Sin embargo, los astrónomos han comenzado a pensar que ciertas fuentes de rayos X de nuestra Galaxia se relacionan con los agujeros negros, y aquí tropezamos nuevamente con los objetos más utilizados pollos astrónomos: las estrellas dobles.
Ya hemos presentado a las estrellas dobles dos estrellas en órbita, una alrededor de otra como una especie de balanza estelar. Únicamente en este vals gravitatorio resulta posible medir las masas de las estrellas de modo directo. Pero una de las estrellas del par puede afectar a la evolución de la otra, y en la actualidad los astrónomos han establecido adecuadamente la evolución de las estrellas individuales, verificando asimismo que muchos de los más apasionantes sucesos de nuestra Galaxia tienen su origen en los trastornos que una de las estrellas inflige a su compañera.
El más conocido de estos cataclismos es la explosión de una nova. La repentina y temporal aparición de una «nueva estrella» en el cielo es un acontecimiento registrado comúnmente en los anales de muchas civilizaciones. Los chinos las llamaron «estrellas invitadas», mientras que en Occidente tales explosiones tomaron su nombre del latín, «nuevas». Una nova es fácilmente visible a simple vista aproximadamente cada diez años, y las más débiles son detectadas incluso por astrónomos aficionados que exploran el cielo con prismáticos y pequeños telescopios. Durante su explosión, una nova es de diez a mil veces más brillante que en su estado normal, debilitándose gradualmente durante los meses sucesivos. La estadística sugiere que cada explosión es sólo una de una larga serie: una estrella susceptible de convertirse en nova repite su explosión en intervalos de aproximadamente 100.000 años. Existen estrellas variables relacionadas con ellas, las novas enanas, que sufren explosiones menores aunque con mayor frecuencia.
En los últimos años," las observaciones y la teoría han concordado en la explicación ele estas estrellas. En todos los casos, al parecer, la «estrella» original es de hecho un par muy próximo, una de las cuales se halla en proceso de expansión a gigante, y la otra ha pasado ya ese estadio y es una enana blanca. Sin embargo, la estrella en expansión enfrenta problemas. Sus capas de gas más externas, adyacentes a la enana blanca, se aproximan gradualmente a ésta, alejándose cada vez más del centro de la estrella.

Una simulación en ordenador del aspecto real del disco de captura que rodea a un agujero negro, calculado por J. P. Luminri, del observatorio de París. Aun cuando la forma del disco es bastante parecida a la de los anillos de Saturno, su aspecto está distorsionado como consecuencia de que su luz se halla afectada, tanto por su alta velocidad de rotación como por su intenso campo gravitatorio. El lado de la izquierda (brillante) está próximo a nosotros, mientras que el lado alejado (derecha) se ha apagado por completo. La luz que aparece encima del agujero proviene del lado alejado del disco, curvado por la gravitación como si hubiera atravesado una lente con distorsión.
Existe una lucha gravitatoria sobre este gas y, finalmente, la estrella alcanza un tamaño tal que la atracción gravitatoria de la enana arranca sus capas más externas; a medida que la estrella continúa expandiéndose, la enana le arranca un chorro continuo de gas. Dado que ambas estrellas se hallan en órbita mutua continua, este gas tiene una componente de velocidad que le impide caer directamente sobre la enana; en vez de ello, se sitúa en su órbita.
Desde cerca, el anillo de gas —disco de captura se parecería en mucho a los anillos de Saturno, pero brillando con luz propia. Existe una diferencia muy importante, puesto que donde el chorro de gas emitido por la gigante incide sobre el gas existente ya en el disco, la colisión produce un punto muy brillante, que (en los sistemas enana-nova) puede eclipsar a las propias estrellas. De esta forma, la enana blanca parece estar rodeada por un débil disco gaseoso con un intenso punto caliente blanco que parpadea en un lugar de su borde externo. Pero cada pocas semanas el disco completo (por razones que aún no se comprenden del todo) se abrillanta, y un observador próximo quedaría deslumbrado por el brillante anillo que rodea a la estrella enana blanca; mientras que, desde nuestra distancia, vemos una explosión de «enana nova».
Estos discos de captura de gas no se comportan de forma similar a los anillos de Saturno, constituidos por materiales sólidos que se mueven en órbitas independientes. Los átomos de gas colisionan de continuo unos con otros, y, en consecuencia, transfieren momento angular, spin hacia el exterior desde las partes centrales del disco. De esta forma, aunque lentamente, la materia del disco describe continuamente una espiral hacia adentro, y, en ocasiones, cae sobre la superficie de la enana blanca. Esta acumulación de gas rico en hidrógeno se degenera mantenido por la presión de los electrones, como en la propia enana blanca, pero existe un inconveniente. La materia degenerada puede tener cualquier tipo de núcleo con el fin de equilibrar la carga de los electrones que la mantiene, excepto núcleos de hidrógeno, que son simples protones. En estas condiciones de alta presión, los protones se combinan de forma explosiva para dar helio. El hidrógeno acumulado es expulsado al espacio en forma de concha en expansión, que temporalmente eclipsa el sistema de estrellas original, como una explosión clásica de nova. Finalmente, el sistema se recupera y el hidrógeno se acumula durante otros 100.000 años aproximadamente, hasta que haya el suficiente para producir otra erupción.
¿Qué relación existe entre esto y los agujeros negros? El disco de captura de un sistema binario es el eslabón. Pero antes de estudiar los discos en torno a los agujeros negros, investigaremos el caso intermedio de las estrellas de neutrones en un sistema doble.
Imaginemos el escenario anterior con la enana blanca sustituida por una estrella de neutrones. Puesto que la fuente compacta es mucho menor, el disco de captura se extiende más hacia el interior, y el gas, al girar allí con mucha mayor rapidez, está mucho más caliente, tan caliente que emite rayos X intensamente. Satélites de astronomía de rayos X han detectado en nuestra Galaxia aproximadamente un centenar de fuentes de rayos X, y la mayoría son de este tipo (o combinación similar, estrella de neutrones-supergigante, en la que la estrella de neutrones recoge el gas desprendido de la mayor como viento estelar y no como resultado de una batalla gravitatoria).

Un negativo de la región del cielo donde se encuentra la fuente de rayos X Gygnus X-1. La estrella brillante del centro es HDE 226868; los rayos X proceden de un disco de captura que rodea a la compañera invisible de esta estrella. Los cálculos indican que esta compañera es, casi con seguridad, un agujero negro. Fotografía de los Observatorios Hale (Palomar Sky Survey).
Sin embargo, el intenso campo magnético de la estrella de neutrones causa otras complicaciones. El gas caliente proveniente de la parte más interna del «disco de captura» se canaliza hacia los polos magnéticos y acaba creando puntos calientes de rayos X próximos a la superficie de la estrella de neutrones.

Fragmentos de roca en órbita alrededor de un agujero negro. El agujero es una región del espacio de la que nada puede escapar debido a su interna atracción gravitatoria; en este montaje, el agujero negro se destaca en un fondo estrellado, con un halo coloreado en el que su gravitación ha distorsionado la luz que pasa por su borde.
Cuando la estrella gira, estos fogonazos de rayos X se dirigen hacia nosotros (de igual manera que las ondas de radio de los pulsares, pero producidos de distinta forma) como impulsos de rayos X. Los «púlsares de rayos X», descubiertos por los satélites de rayos X, confirman la predicción de los teóricos de que una estrella de neutrones es la responsable de la mayoría de las fuentes de rayos X. Estas fuentes son de diferentes tipos: unas tienen cortas y repetidas explosiones; otras «parpadean» de continuo; otras más, se abrillantan y oscurecen de forma parecida a las novas ópticas. Sin embargo, los astrónomos de rayos X están seguros de que todas ellas pueden explicarse como variantes del modelo original de una estrella de neutrones en una binaria.
Pero siempre hay una excepción, y en este caso es la «picara» fuente de rayos X llamada Cyg X-l, la primera fuente de rayos X delectada en la constelación Cygnus. Al principio pareció ser un típico sistema binario de rayos X; con todo, su posición no estaba perfectamente determinada, como suele ocurrir en el nacimiento de una nueva rama de la astronomía. Pero en 1971 los radioastrónomos captaron este objeto como una fuente de radio y localizaron exactamente su posición, que coincidía con la de una supergigante azul catalogada como HDE 226868; y los astrónomos ópticos pronto verificaron que las líneas espectrales de esta estrella se desplazaban regularmente, mostrando que su velocidad cambiaba de manera uniforme. Se hallaba en órbita, claramente, en torno a una invisible compañera cada cinco días y medio. Hasta aquí, todo marchaba sobre ruedas: este tipo de órbita cercana es la que los astrónomos esperaban de una fuente de rayos X, pero había reservada una sorpresa: cuando calcularon la masa de la invisible compañera, la misma resultó ser al menos cinco veces más pesada que el Sol.
En la actualidad hay una serie de argumentos contundentes que conducen a una conclusión. Para que salgan rayos X desde un disco de captura, la estrella central debe ser pequeña. Las enanas blancas son suficientemente pequeñas como para constituirse en fuentes de rayos X blandos, pero casi todos los emisores de rayos X duros están asociados con estrellas de neutrones. Una estrella de neutrones o una enana blanca, si éste es el caso— no puede ser tan pesada como cinco veces el Sol. El único objeto suficientemente pequeño, y de esta masa, es un agujero negro.
Puede parecer contradictorio afirmar que la fuente Cyg X-l de rayos X es un agujero negro, ya que, después de todo, ningún tipo de radiación puede escapar del horizonte de sucesos de una estrella colapsada. Sin embargo, sólo se trata de una confusión de lenguaje, pues los rayos X provienen del disco de captura del gas que se halla en órbita en torno al agujero. Ya hemos señalado que un agujero negro no «absorbe» materia hasta que entra directamente dentro del «horizonte de sucesos». El gas del disco se halla en órbita bastante fuera de este radio, y el disco de captura siente una atracción gravitatoria muy similar a la experimentada por un disco situado en órbita alrededor de una estrella de neutrones. Dado que un agujero negro de la misma masa que una estrella de neutrones sería más pequeño que ésta, el gas está más en espiral, y, por consiguiente, más caliente, por lo que emite radiación con mayor libertad; hasta que alcanza el horizonte de sucesos y desaparece.
Así pues, la fuente Cyg X-l de rayos X es, estrictamente hablando, el disco de captura que rodea a la compacta compañera de la supergigante HDE 226868. Pero este «compacto objeto», ¿es definitivamente un agujero negro? Muchos astrónomos afirman que así lo prueba su gran masa; y, además, no hay ningún signo de pulsos regulares de rayos X que esperar si la implicada fuera una estrella de neutrones. Otros astrónomos no aceptan con facilidad la idea de que hay que admitir a los misteriosos y maravillosos agujeros negros dentro de nuestro Universo, y procuran otras explicaciones a su respecto: quizá la compañera sea, en realidad, dos estrellas de neutrones muy próximas; y tal vez HDE 226868 no sea una supergigante, sino una estrella más débil y más próxima cuyo espectro óptico se parece al de una supergigante. La mayoría de los astrónomos contemplan a los toros desde la barrera, en espera de que el futuro ofrezca alguna evidencia mayor.
Los propios astrónomos de rayos X buscan más fuentes de rayos X semejantes a Cyg X-l, y los satélites del Observatorio Astrofísico de Altas Energías registran esperanzados el cielo. Estos nuevos satélites, clasificados como de tamaño medio, son diez veces mayores que sus predecesores. Dado que están acondicionados para recoger más cantidad de rayos X, sus detectores pueden llegar a detectar fuentes de rayos X más débiles, y a facilitar sus posiciones a los astrónomos ópticos con suficiente precisión como para que se vean instados a buscar las estrellas compañeras. Se ha descubierto ya otra posibilidad semejante a un agujero negro en la constelación Circinus.
Pero las estrellas colapsadas no son los únicos agujeros negros posibles. Puede haberlos mucho mayores y mucho más pequeños, y, de hecho, existe la evidencia de que en el centro de otra galaxia hay un gran agujero negro. La colosal energía de las muy distantes y brillantes galaxias llamadas quásares se relaciona asimismo, probablemente, con los agujeros negros (se tratará este tema en el capítulo siguiente). El gran número de evidencias fuerza en la actualidad, a la mayoría de astrónomos, a aceptar en principio que los agujeros negros existen con suma probabilidad en nuestro Universo. El problema consiste en encontrarlos.
§. La explotación de los agujeros negros
Un agujero negro es invisible por definición. Sus únicos efectos sobre el resto del Universo son los causados por su gravitación, su carga eléctrica y su momento angular (spin), y, de hecho, éstos son los únicos tres aspectos mediante los cuales resulta posible saber algo del agujero negro desde fuera de él. Si comprimiéramos mil toneladas de agua para obtener un agujero negro, no le distinguiríamos de otro de mil toneladas de chatarra. Algo más sorprendente: un agujero negro hecho de antimateria es absolutamente idéntico a otro de materia. Las matemáticas implicadas en la tísica del agujero negro son tan complicadas que demostrar el teorema generalmente conocido como el de «un agujero negro no tiene pelo» ha llevado varios años a algunos de los mejores físicos del mundo.
Los agujeros negros tienen probablemente una carga eléctrica muy pequeña, pues la materia que se colapsa en su interior debe de ser eléctricamente neutra. Pero a juzgar por el rápido giro de los púlsares de estrellas de neutrones, las estrellas en colapso giran muy rápidamente. Los cálculos muestran que el espacio vacío que rodea a un agujero negro en rotación está «distorsionado». Si observamos un cohete que se dirige rectamente hacia el centro de un agujero negro en rotación, la naturaleza distorsionada del espacio que le rodea comenzará a atraer al cohete en la dirección de rotación, y el mismo se verá obligado a describir una espiral. Más aún, supongamos que contamos con tecnología para construir a cierta distancia del agujero una inmensa estructura de acero que lo rodee, y totalmente simétrica de manera que no pueda ser atraída. El espacio que gira alrededor del agujero hará girar a la estructura, pudiéndose producir de esta forma una colosal cantidad de energía. Una estrella colapsada produciría bastante más energía que la necesaria para abastecer nuestra actual necesidad de consumo durante un tiempo mayor que la edad del Universo; de hecho, miles de millones de veces mayor.
En otro ensueño de los teóricos, podríamos enviar un cohete no tripulado al espacio distorsionado que gira alrededor del agujero negro; una vez allí, una gran parte del mismo se desprendería de manera cuidadosamente controlada. Si esta división se realizase con cuidado, sería posible lograr que la parte separada se precipitara lejos del espacio distorsionado, mientras el resto del cohete caería a través del horizonte de sucesos. «Capturado» en la forma correcta, la velocidad de estos restos que se mueven rápidamente podría extraerse como energía.
En ambos casos teóricamente, al menos podríamos extraer energía de los agujeros negros en rotación. En el segundo ejemplo, podríamos disponer las cosas para obtener más masa-energía que la que gana el agujero engullendo al cohete. Sin embargo, existe un límite. Al extraerse su energía de rotación, el agujero negro se frena, y finalmente se detendrá, pasando a ser una mera trampa gravitatoria.
Esto nos conduce a otra forma de obtención de energía, no del propio agujero negro, sino de la materia que cae dentro de él. El Cyg X-l puede constituir un prototipo natural de esta clase de centrales de energía. Puesto que el gas en torno al agujero negro describe una espiral hacia adentro, radia rayos X cuya energía proviene básicamente del campo gravitatorio del agujero. Cuando una cantidad de gas, o de cualquier otra cosa, cae dentro de un agujero negro, puede emitir una cantidad de energía equivalente a casi la mitad de su propia masa. Un kilogramo de gas, por ejemplo, puede ser capaz de radiar 420 gramos en forma de energía (casi la mitad de su peso), dejando 580 gramos que, finalmente, caen a través del horizonte de sucesos. El agujero negro se vuelve más pesado con esta última cantidad, pero lograremos convertirla una vez más en energía; en el Sol, un kilogramo de hidrógeno, al fusionarse en helio, libera sólo siete gramos de energía.

Una antigua fotografía de Albert Einstein. Sólo tenía 26 años y trabajaba en una oficina de patentes cuando elaboró su primera teoría de la relatividad, que revoluciono nuestra concepción del espacio y del tiempo.
¿Cómo producir un pequeño agujero negro en el laboratorio que, al echarle toda nuestra basura, la convierta en energía? Asegurándonos de que el agujero posee carga eléctrica, podríamos mantenerlo suspendido en un campo eléctrico frente a la atracción de la gravedad terrestre (tal como en el antiguo experimento de Millikan con gotas de aceite cargadas). Este dispositivo podría generar tanta energía como una gran central convencional con sólo 500 gramos de basura al año; esto resolvería todos nuestros problemas de energía, aun cuando no el de la recogida de desperdicios.
De hecho, existen dificultades insuperables para la explotación de agujeros negros en la Tierra. En primer término, en la actualidad no hay ninguna forma conocida de comprimir materia por debajo de un pequeño tamaño y obtener esa increíblemente alta densidad.

El profesor Stephen Hawking, de la Universidad de Cambridge, ha realizado los avances más importantes en gravitación desde Einstein.
Tendríamos que comprimir una masa de un millón de toneladas hasta el tamaño de un núcleo atómico para lograr que la velocidad de escape de su superficie fuera igual a la velocidad de la luz.
Hay otra razón, más fundamental aún, por la cual no se puede construir una diminuta central de energía de agujero negro. Aun cuando resulte contradictorio, sucede que los agujeros negros no son realmente negros. Un agujero negro de un millón de toneladas permanecería incandescente a una temperatura de mil millones de grados, más caliente que cualquier otro cuerpo conocido en astronomía; y, al cabo de unos pocos años, explotaría en un cataclismo ante el cual la explosión de una bomba de hidrógeno parecería una simple explosión de gas grisú.
§. La explosión de los agujeros negros
¿Cómo puede un agujero negro no ser negro y explotar cuando su campo gravitatorio es suficientemente intenso como para mantener incluso a la luz dentro de su horizonte de sucesos? La idea original del agujero negro fue demolida en 1974, al incorporarse las ideas de la teoría cuántica hasta entonces no consideradas. La revolución resultante añadió nuevas y extrañas características desconocidas al ya de por sí exótico concepto de agujero negro. Y quizá lo más sorprendente de todo sea el hecho de que la fusión de las dos teorías físicas más intrincadas -teoría cuántica y relatividad general fue desarrollada de forma enteramente teórica por el notable físico Stephen Hawking, de Cambridge.
Aunque sólo cuenta treinta y tantos años, Hawking se ha acreditado ya como el científico que ha llevado a cabo los avances más importantes en el conocimiento de la gravitación desde el propio Einstein. Una agotadora enfermedad muscular le ha confinado a un sillón de ruedas desde hace algunos años, impidiéndole escribir sus ideas; así pues, la capacidad de su original pensamiento ha sido señalada por la adversidad, ya que debe mantener todas sus ideas en la cabeza y resolverlas por medio de una aritmética supermental. En Cambridge es conocido tanto por su sentido del humor como por sus audaces y originales teorías sobre los agujeros negros.
Hawking efectuó su más importante descubrimiento a finales de 1973. Las ecuaciones de la gravitación de Einstein consideraban la materia sólo como una masa que produce una atracción gravitatoria, e ignoraban todos los extraños fenómenos que tienen lugar a escala muy pequeña, como la dualidad onda-corpúsculo de la materia, el principio de incertidumbre y la creación y destrucción de materia y antimateria. Cuando se calculan problemas astronómicos, corno la órbita de Mercurio, estos refinamientos no son necesarios, pero Hawking investigaba las propiedades de los pequeñísimos agujeros negros, en los que la gravitación es intensa y varía fuertemente a distancias muy pequeñas. Desde el punto de vista de la teoría cuántica, su enfoque parecía demostrar que el agujero debería emitir partículas elementales al espacio. En un principio, admitió que «debe de haber un error»; pero no lo hubo, y su descubrimiento revolucionó el mundo científico en marzo efe 1974, situando a Hawking en un lugar eminente entre quienes han contribuido a la comprensión del Universo.
El principio de incertidumbre, esa extraña ley que nos dice que no podemos conocer simultáneamente la posición y la velocidad instantáneas de una partícula con precisión absoluta, también se refiere a la energía. Resulta imposible medir la energía precisa que posee un cuerpo o un sistema en un tiempo conocido exactamente. Dicho de otra forma, un pequeño paquete de energía puede aparecer repentinamente en el espacio vacío con tal de que desaparezca con suficiente rapidez como para que no se lo pueda detectar y se cumpla la ley de conservación de la energía. (Esta es, exactamente, la situación que permite que las fuerzas de la Naturaleza actúen intercambiando partículas virtuales, como vimos en el capítulo 6.) Este paquete de energía de corta vida se convertiría en un par partícula-antipartícula (por lo general, electrón y positrón), y, normalmente, éstas se aniquilarían casi al instante; y tampoco podríamos conocer su breve existencia, ya que esto ocurriría con suma rapidez.
Pero si un par materia-antimateria nace de la noche a la mañana en la región del espacio exactamente fuera de un agujero negro, uno de los componentes del par puede caer dentro de él y no podrá cancelarse con el otro de la forma habitual. La última viajará como una partícula abandonada por el espacio. Desde lejos, el agujero negro parece emitir electrones y positrones individuales que, realmente, provienen de la región que le rodea. La energía positiva de la partícula que escapa es equilibrada por la energía «negativa» que el agujero negro proporciona al absorber la antipartícula. En efecto, las partículas «libres» transportan masa desde el agujero negro, lo que disminuirá la masa y el tamaño de éste. Finalmente, toda la masa del agujero negro se «evaporará» de esta poco ortodoxa forma. Los agujeros negros no son la muerte final de la materia: aun cuando, efectivamente, destruyen la identidad de todo lo que cae en ellos, y nada puede salir intacto otra vez, acaban disociándose en una lluvia de las partículas más sencillas posibles. Parece poético que el corazón de un muerto, una estrella masiva que empezó como gas (hidrógeno) fundamentalmente constituido por protones y electrones, termine, después de todas sus vicisitudes (núcleos de la complejidad del hierro y la ignominia del total colapso gravitatorio), en una explosión de partículas fundamentales nuevas.
Sin embargo, los números muestran que los cálculos anteriores de los núcleos de las estrellas colapsadas son correctos a todos los efectos. La producción de partículas de Hawking es más efectiva cuando el campo gravitatorio varía notablemente en pequeñas distancias, lo que significa que su importancia es tanto menor cuanto más grandes y pesados son los agujeros negros. El agujero negro de Cyg X-l tardará en desaparecer un tiempo bastante mayor que la edad actual del Universo: de hecho, en la actualidad le arranca gran cantidad de gas a su compañera, que luego pierde por «evaporación» de partículas fundamentales.
La situación es dramáticamente diferente para los agujeros más pequeños, que a la sazón trataba Hawking. En el infierno del «Big Bang» con que comenzó el Universo hace unos 15.000 millones de años, es bastante posible que se produjese una gama completa de pequeños agujeros negros. Los más pequeños se habrán evaporado ya, pero los de cierta masa estarán desapareciendo ahora. Puesto que la «evaporación» hace los agujeros negros menos masivos y, por consiguiente, más prolíficos en el número de partículas que salen de ellos, el chorro de salida aumenta con el tiempo, y la desaparición final tiene lugar en una fracción de segundo con una gran explosión de energía. Literalmente, el agujero negro explota. Los astrónomos buscan ahora estallidos de rayos gamma y ondas de radio que puedan provenir de tales explosiones. Si los descubren, ello supondrá un tremendo triunfo de la perspicacia de Hawking en cuanto a la comprensión del exótico funcionamiento del Universo.
Las energías de las partículas que salen de un agujero negro verifican la distribución de radiación del «cuerpo negro». De esta forma, es posible decir a qué temperatura se halla un agujero negro. Un agujero negro de la masa del Sol —de unos 6 kilómetros de extensión está en realidad sólo una diezmillonésima de grado por encima del cero absoluto de temperatura. Otro, de la masa de la Luna —de 0,25 milímetros de extensión, debería ser confortablemente cálido, mientras que los agujeros negros de mil millones de toneladas, que pueden estar explotando en la actualidad, se hallan a unos 120 mil millones de grados. Por consiguiente, no puede afirmarse que los agujeros negros sean negros. Aunque absorben toda la luz que llega a ellos, hay una delgada región exactamente fuera del horizonte de sucesos que «brilla» de continuo y que drena la energía acumulada en el agujero.
¿Qué ocurre dentro de un agujero negro? Ignoramos a los agujeros negros que gira», pues la teoría indica que pueden transportarnos a otro Universo. Aun cuando los teóricos pueden alegremente describir «nuestro Universo» y «otros universos» mediante ecuaciones, y decir que están conectados por estos agujeros negros que giran, no es del todo cierto que una nave espacial que se aventurase dentro de un agujero negro emergiera en otro universo lleno de galaxias diferentes. Si volásemos directamente hacia un agujero negro que no girase, una vez dentro podríamos ver qué le ocurre al núcleo de nuestra masiva estrella en colapso. Ninguna fuerza conocida podría detenerlo; y Stephen Hawking y su maestro, el matemático Roger Penrose, demostraron en 1969 que el resultado inevitable es una «singularidad». Toda la materia se colapsa hasta un volumen prácticamente cero. Una singularidad es un punto matemático en el espacio, en el cual una masa se halla comprimida a densidad infinita en una región de tamaño exactamente nulo. Incidentalmente, este teorema confirma que una vez que nuestra nave esté dentro del agujero negro, deberá acabar siendo también una singularidad, infinitamente comprimida.
Las singularidades son aún más desconcertantes para los físicos cine los agujeros negros que las rodean. Algunos teóricos han intentado demostrar que las singularidades están siempre rodeadas por un agujero negro, y que por eso se hallan ocultas a nuestra vista. Pero esto no constituye una censura cósmica: las singularidades aisladas probablemente existan, y es deber de los teóricos el procurar explicarlas.
Existe una posible solución. Tal como John Wheeler, de la Universidad de Princeton, ha señalado apasionadamente, estas últimas singularidades provienen de una teoría gravitacional que ignora los efectos cuánticos de la materia; así pues, cuando comprimimos la materia de esta forma hasta tamaños muy pequeños y energías muy altas, los efectos cuánticos son extremadamente importantes.

Los agujeros negros pueden considerarse un ejemplo extremo de cómo la materia distorsiona d espacio y el tiempo, originando efectos gravitatorios. En esta analogía bidimensional, el «espacio» está representado por cuadrados sobre una lámina flexible. Una pesada bola (arriba) distorsiona el espacio, produciendo el efecto de la fuerza gravitatoria de un objeto masivo. Si se agrupase una masa mayor en la misma esfera, la región local de espacio podría llegar a distorsionarse tanto (abajo) que la parte central desaparecería del Universo como un agujero negro.
Al igual que las otras fuerzas, la gravitación tiene que ser transportada por «partículas de fuerza», los gravitones; pero éstos están «encubiertos» por la teoría de la relatividad general, que considera a la gravitación como una distorsión del espacio y del tiempo. Y resulta extremadamente difícil combinar ambas teorías para la misma fuerza. Existe asimismo la esperanza de combinar la gravitación con las demás fuerzas como aspectos diferentes de una única fuerza.
¿Desaparecerá la desconcertante predicción de las singularidades en el Universo cuando, como dice Wheeler, «se haya consumado el ardoroso matrimonio de la relatividad general con la física cuántica»? ¿Acabará realmente el centro de una estrella muerta como un punto de tamaño cero en el espacio, o la nueva física predecirá quizás algún pequeño y extraño cuerpo en su lugar?
El campo de los agujeros negros es la mezcla más intrincada de astronomía y física. Los astrónomos buscan a los agujeros negros grandes, por los efectos de su atracción gravitatoria; y a los pequeños, por sus explosiones.
La tísica, mientras tanto, puede guiar a los astrónomos en sus búsquedas; y puede asimismo proporcionar respuestas a alguna de las cuestiones que no se pueden responder experimentalmente, tal como revelar qué sucede realmente en el siempre invisible interior de un agujero negro.
Capítulo 10
Geografía del Universo
Al igual que la Tierra, el Universo posee su geografía. Nuestro Sol es un miembro típico de una galaxia típica; y nuestra Galaxia de la Vía Láctea, que tiene unos 100.000 millones de estrellas, es sólo una entre millones de galaxias.

Entre las galaxias grandes, la de Andrómeda es la más cercana a nosotros; se halla a «únicamente» 2¼ millones de años luz. Esta espiral difusa se compone de unos 200.000.000.000 de estrellas, demasiado débiles como para ser vistas individualmente. A simple vista aparece como una débil mancha brumosa. La Galaxia de Andrómeda es el objeto más distante visible sin telescopio. (Copyright del Instituto de Tecnología de California y la Institución Carnegie de Washington. Reproducido con permiso de los Observatorios Hale.)
§. El nacimiento de la Vía Láctea
§. Las espirales de la Vía Láctea
§. Hermanos en el espacio
§. Los quásares
§. Los mini-quásares
§. Los mensajes de las radio-galaxias
§. ¿Centrales de energía en los quásares?
Vivimos en una inmensa rueda de Santa Catalina de estrellas que gira lentamente: la Galaxia de la Vía Láctea. Nuestro Sol es un miembro intermedio de la familia de nuestra Galaxia, constituida por unos 100.000 millones de estrellas. Nuestras vecinas más próximas brillan en el cielo nocturno cual puntos parpadeantes, mientras que las cohortes distantes, demasiado débiles como para ser vistas individualmente, se acumulan en perspectiva formando la banda luminosa de la Vía Láctea. Los astrónomos han analizado al detalle la familia de estrellas de la Vía Láctea, y se ha logrado establecer la historia de la vida y la muerte de una estrella estudiando los distintos tipos de ellas en nuestra Galaxia. Observando lo que ésta contiene, los astrónomos han deducido los complejos procesos de las nubes de gas que se colapsan en estrellas, los de la explosión de éstas nuevamente en gas y polvo, y, también, los de las exóticas estrellas de neutrones y los agujeros negros.
Sin embargo, nuestra Galaxia es una más de los millones de galaxias del Universo. Nuestras dos vecinas más próximas, las Nubes de Magallanes, que pueden verse desde el hemisferio sur, brillan cual nubes ensortijadas tras el velo de las estrellas más cercanas de nuestra propia Galaxia. Por su parte, los observadores del hemisferio norte pueden detectar, en los atardeceres claros del otoño, la más débil y ovalada Galaxia de Andrómeda. Esta galaxia, el objeto más lejano que podemos ver a simple vista, se halla a dos millones de años luz de nosotros. Es una galaxia inmensa, constituida por el doble de estrellas que la Galaxia de la Vía Láctea, pero reducida debido a su distancia a una simple luminaria en el cielo.
Los telescopios, por supuesto, ponen de manifiesto muchas más galaxias, especialmente mediante fotografías de larga exposición que revelan sus débiles regiones más externas. Hay galaxias de todos los tamaños: además de las más pequeñas, de formas variadas, las mayores son galaxias, bien espirales o bien difusas bolas ovaladas, características de las galaxias elípticas. Las espirales son galaxias con carácter: con un poco de práctica, un astrónomo puede individualizar galaxias por los detalles de la estructura de sus brazos espirales, con la misma facilidad con que encuentra a un antiguo conocido en la calle. Sin embargo, las elípticas son mucho más anónimas, y sólo contados astrónomos podrían identificar de manera infalible una galaxia elíptica en especial únicamente a partir de su fotografía.
Las diferencias entre los tipos de galaxias las pequeñas e irregulares, las grandes espirales y las elípticas, que son de todos los tamaños— dependen, como veremos más adelante, de cómo se formaron originalmente. Quizá sean más sorprendentes sus similitudes que sus diferencias. En principio, el espectroscopio muestra que los espectros de galaxias están cruzados por líneas oscuras, correspondientes a las «huellas digitales» de los elementos que se encuentran en estrellas de nuestra Galaxia. En realidad, estudios efectuados con ordenador han mostrado que es bastante fácil simular el espectro de una galaxia combinando simplemente la luz de tipos de estrellas comunes en la Galaxia de la Vía Láctea.

Una hermosa galaxia espiral simétrica, catalogada como NGC (New General Catalogue) 1566. Fotografía del Observatorio Anglo-australiano.
Es decir, las otras galaxias están formadas por estrellas muy parecidas a las de la nuestra, y así lo han comprobado los astrónomos directamente en las más próximas. Las fotografías de las Nubes de Magallanes y de la Galaxia de Andrómeda (así como las de otras próximas) muestran brillantes estrellas individuales que tienen los colores y el brillo que cabría esperar.
Otras galaxias espirales —y las irregulares contienen gas y polvo interestelar, a los que, una vez más, el espectroscopio muestra como muy similares al gas y al polvo de nuestra Galaxia. Así pues, la Vía Láctea es una galaxia de tipo medio y sin nada especial dentro del escenario cósmico. Constituye una fuente de información muy eficaz para los astrónomos, ya que las estrellas y el gas de nuestra Galaxia son muy bien conocidos y, aparentemente, no hay razón por la que no pudiéramos transferir todo nuestro conocimiento a los elementos constituyentes de otras galaxias. Contrapuestamente, si observamos todos los tipos de galaxias del Universo, sus similitudes y diferencias, podremos apreciar cómo la Vía Láctea encaja en ellos, aprendiendo así algo más acerca del tipo de galaxia que ella es; de la misma forma que podremos entender más acerca de la Tierra si la comparamos con los demás planetas de la familia del Sol, o descubrir algo acerca del pasado y el futuro del Sol estudiando las otras estrellas de nuestra Galaxia.
Una galaxia como la nuestra contiene estrellas de todas las edades, al igual que cualquier galaxia espiral o irregular. Actualmente nacen estrellas jóvenes en medio de inmensas nubes de gas y polvo, como en la cercana Nebulosa de Orion. El Sol tiene unos 5.000 millones de años, y muchas estrellas son aún más viejas. No obstante, existe un límite de edad de aproximadamente 15.000 millones de años. Podrían detectarse estrellas —habría que decir cúmulos de estrellas— más viejas, pero no se las ha encontrado en nuestra Galaxia, por lo que los astrónomos han llegado a la conclusión de que ésta se formó hace unos 15.000 millones de años. Esto constituye una notable similitud, ya que virtualmente todas las demás galaxias parecen tener aproximadamente la misma edad. No es una medición que los astrónomos puedan efectuar con total precisión, pero existe certeza de que no hay galaxias extremadamente viejas. Investigaciones recientes han detectado galaxias que pueden haberse formado más recientemente, pero son raras y se las incluye en la insignificante categoría de «enanas». Las galaxias mayores se formaron aproximadamente al mismo tiempo.
En el ámbito de los físicos fundamentales, todas las galaxias son idénticas. Todas están constituidas por las mismas partículas fundamentales, influidas por las mismas fuerzas. En consecuencia, las constituyen estrellas y nubes de gas y polvo semejantes. Para el físico, el contraste entre los hermosos brazos de una galaxia espiral y la simplicidad de otra, elíptica, es apenas una diferencia de muy poca importancia que puede explicarse como un pormenor de la galaxia en formación. La gran semejanza entre los ingredientes básicos de las galaxias, y sus casi idénticas edades, indica a los astrónomos que se formaron a partir de una nube continua de gas que colmaba el Universo. Hace unos 15.000 millones de años esta «nube» (quizá «médium» fuere una denominación más adecuada, ya que llenaba el Universo por entero) comenzó a disgregarse en trozos que se colapsaron bajo su propia atracción gravitatoria y formaron las galaxias, dejando virtualmente vacío el espacio entre ellas.
§. El nacimiento de la Vía Láctea
Nuestra Galaxia empezó cual una inmensa nube de hidrógeno y helio de aproximadamente 300.000 años luz de extensión, una de las porciones del gas general que colmaba el Universo y que la gravitación había unido. Cuando se contrajo, bajo la fuerza de su propia atracción gravitatoria, esta «protogalaxia» (precursora de una galaxia) se hizo cada vez más densa, hasta que el gas comenzó a fragmentarse en una miríada de trozos más pequeños que se colapsaron en las primeras estrellas de la Galaxia de la Vía Láctea.
Eran estrellas bastante raras, ya que estaban constituidas únicamente por hidrógeno (tres cuartas partes en peso) y helio (una cuarta parte). Las estrellas posteriores, como el Sol, tienen una pequeña mezcla de elementos más pesados, por ejemplo carbono, silicio y hierro, que se formaron en una supernova anterior y fueron esparcidos por ella. Estos elementos forman también los granos de polvo del espacio interestelar; cuando las estrellas actuales se forman en densas nubes de polvo y gas, estos granos de polvo juegan un importante papel, ya que enfrían el gas central, permitiendo su colapso en estrellas. Pero en el comienzo de nuestra Galaxia, los únicos elementos que existían eran los dos más ligeros, el hidrógeno y el helio; y las primeras estrellas no pudieron haber nacido en el aislamiento de una cortina de polvo. En rigor de verdad, los astrónomos no pueden aún ofrecer exactas razones acerca de cómo aparecieron estas primeras estrellas; de todos modos, una vez que se hubieron formado, las reacciones nucleares en sus corazones comenzaron a convertir los «combustibles» básicos en elementos más pesados, y las estrellas más masivas pronto explotaron como supernovas, esparciendo los elementos más pesados a través de la Galaxia y empezando a formar la mezcla de elementos que hoy vemos en el espacio.
La protogalaxia debe haber comenzado siendo prácticamente esférica, cual un inmenso globo de gas en colapso que girase lentamente. La gravitación, al intentar atraer todo el gas hacia adentro, desafiaba la ley física que establece que la cantidad de spin (momento angular) debe conservarse siempre. Cuando gradualmente la nube se encogió, giró con mayor rapidez; y todo el gas, en vez de caer en el centro, acabó siendo un disco en rotación. Este era el único acuerdo al que podían llegar la gravitación y el momento angular. El efecto total de la materia en el disco da lugar a una complicada distribución del campo gravitatorio, pero la atracción gravitatoria total atrae a cada parte del disco hacia el centro, y esta fuerza es equilibrada por el giro del disco. Constituye algo bastante semejante a la rotación de los planetas alrededor del Sol, pero en este caso no hay únicamente un cuerpo muy pesado en el centro: cada estrella y la nube de gas del disco— experimenta la atracción gravitatoria de las otras, y, como promedio, una atracción hacia el centro, los brazos espirales de nuestra Galaxia forman parte de este disco, y el Sol es una de sus estrellas. Sin embargo, antes de observar esta parte de la Galaxia hay que examinar una región más antigua.
En las extensiones más externas de la protogalaxia original esférica, las estrellas comenzaron a formarse antes de que el gas se colapsara en el disco. Existe una diferencia muy importante en el modo en que se mueven el gas y las estrellas en una galaxia. En un gas, los átomos se mueven a alta velocidad y colisionan de continuo; así pues, las velocidades y movimientos muy rápidos se promedian. A esto se debe el que la protogalaxia, al contraerse, se aplanase, transformándose en un disco en rotación: cualquier átomo de gas que hubiera seguido el «mal camino» se habría visto obligado muy pronto a moverse de la misma forma que la mayoría. Y este colapso tuvo lugar muy rápidamente en la escala de tiempo astronómica: en apenas unos cien millones de años.
Sin embargo, el gas que se transformó en las estrellas primitivas siguió un destino diferente. Las estrellas se hallan en órbita en la galaxia sin aproximarse mucho unas a otras. Pensemos en lo pequeño que es el Sol comparado con las distancias entre las estrellas; si redujésemos la escala de las estrellas a la humana, ello supondría situar a las personas separadas unas de otras una media de 10.000 kilómetros; y, en consecuencia, la probabilidad de que dos personas se encontraran accidentalmente durante su vida resultaría mínima. De este modo, una vez nacida una estrella, sólo será afectada por la atracción gravitatoria media de toda la Galaxia. Las estrellas que se formaron cuando la Galaxia era todavía una bola inmensa siguen órbitas que las llevan de acá para allá, por encima y por debajo de la región del disco de nuestra Galaxia, a través de una gran zona esférica que los astrónomos llaman el halo de la Galaxia.
Pueden detectarse estas estrellas del halo de diversas formas. Suelen contener menos elementos pesados en la superficie que las estrellas del disco, simplemente porque se formaron antes. Además, describen grandes órbitas alrededor de la Galaxia y pueden seguir cualquier rumbo por el espacio, moviéndose sólo en ocasiones a través del disco. Cuando el Sol gira alrededor del centro galáctico con las otras estrellas del disco, nos adelantamos a cualquiera de las estrellas del halo que pasan a través del disco próximas a nosotros. Nos parece que estas estrellas, que se mueven lentamente, lo hacen muy rápidamente en dirección contraria, y por esto se han ganado el nombre completamente erróneo de «estrellas de alta velocidad», cuando en realidad quien lleva esta velocidad es el Sol. Antes de que los astrónomos especificaran la forma en que está construida nuestra Galaxia, parecía casi astrológico que existiera una relación entre la composición química de una estrella y su velocidad aparente a través del espacio.
Aproximadamente la décima parte de las estrellas del halo no siguen órbitas individuales, sino que se agrupan en cúmulos gigantes de hasta un millón de estrellas. Estos grandes cúmulos globulares son, naturalmente, lo más evidente del halo. A pesar de sus distancias al disco de unas decenas de miles de años luz, algunos de estos baluartes más externos de nuestra Galaxia pueden verse incluso sin telescopio. Desde el hemisferio sur, dos de ellos son visibles como «estrellas difusas» y se los ha designado con nombres de estrellas, Omega Centauri y Tucanae 47. En la constelación septentrional de Hércules hay uno más débil, que puede verse en noches realmente claras y tiene la misteriosa denominación de MI3.
Esto indica que se trata del decimotercer objeto del catálogo recopilado por Charles Messier, buscador de cornetas francés del siglo XVIII, apodado por Luis XV «el hurón de los cometas». A Messier le incomodaba cada vez más el número de objetos nebulosos del cielo que podían tomarse por cometas débiles a primera vista, y el resultado de su famoso catálogo de 103 «nebulosas». De algunas de ellas sabemos ahora que son auténticas nebulosas gaseosas, como la Nebulosa de Orion (M42); de otras, que son galaxias (la galaxia de Andrómeda es M31); y, de algunas más, que son cúmulos de estrellas como MI3 o Las Pléyades (M45). La numeración de Messier se emplea todavía como una manera útil de identificar las nebulosas más brillantes, los cúmulos y las galaxias, incluso aunque se haya sustituido su catálogo hace tiempo por otros mucho más comprensibles para uso de los especialistas. Resulta irónico que Messier sea recordado ahora, no como descubridor de cometas (trece en total), sino por su lista de «estorbos» celestes.
Los objetos más antiguos que es posible ver son los cúmulos globulares.

Uno de los más antiguos cúmulos estelares de nuestra Galaxia, un cúmulo globular catalogado como NGC 3201, fotografiado en el Observatorio Anglo-australiano.
Las estrellas que los forman brillan regularmente desde hace unos 15.000 millones de años, o sea tres veces más que la vida del Sol y casi desde el comienzo del propio Universo. (Nuestra Galaxia se formó poco después del nacimiento del Universo, como veremos en el próximo capítulo.) Los astrónomos se felicitan especialmente de que existan cúmulos globulares, que permiten fechar la formación de la Galaxia, ya que no resulta fácil medir las edades de las estrellas individuales del halo. Con los cúmulos, sin embargo, ello es «relativamente» fácil.
Cuando se formó el primer cúmulo, a partir de una nube de gas, aparecieron estrellas de masas diferentes y comenzó la fusión del hidrógeno en helio en sus núcleos. Pero las estrellas tienen una vida media limitada y, como vimos en el capítulo 8, las masivas derrochan a un ritmo prodigioso su «combustible» y terminan como supernovas al cabo de unas decenas de millones de años. Por consiguiente, los cúmulos globulares no pueden contener en la actualidad ninguna de estas estrellas. Una estrella con la masa del Sol de unos 10.000 millones de años en un cúmulo globular de 15.000 millones de años, habrá completado ya su evolución, y será ahora una insignificante enana blanca. Las estrellas algo menos pesadas atravesarán estadios de enormes gigantes rojas, y sólo cuando descendamos a estrellas muy ligeras encontraremos que todavía fusionan hidrógeno en sus núcleos. Estas estrellas de baja masa consumen hidrógeno con tanta lentitud que sus provisiones durarán prácticamente el tiempo de vida del Universo.
La teoría nos informa acerca del tiempo que durará la provisión de hidrógeno de una estrella de fusión de hidrógeno (una estrella de «la secuencia principal» en la jerga de los astrónomos). Así, si consideramos un cúmulo, podemos encontrar dónde se halla la estrella de fusión de hidrógeno más pesada dibujando un diagrama Hertzsprung-Russell de la luminosidad de cada estrella frente a su temperatura, y siguiendo la secuencia principal desde el extremo inferior derecho hasta donde termina abruptamente. Las estrellas que se encuentran al final de la secuencia son las que finalizan su fusión de hidrógeno; sus núcleos están a punto de colapsarse y la estrella completa su proceso de hinchazón hasta convertirse en una gigante roja. Sabemos teóricamente el tiempo que ha debido permanecer una estrella en esta posición de la secuencia principal (que corresponde a una determinada masa) con el fin de fusionar toda su provisión de hidrógeno central; este tiempo es, por consiguiente, la edad del cúmulo.

Una amplia perspectiva del centro de nuestra Galaxia en la Constelación de Sagitario. Las trazas de polvo, próximas al disco, constituyen una banda negra que atraviesa esta acumulación de viejas estrellas y oculta el diminuto núcleo central detectado por los radioastrónomos y astrónomos de infrarrojo, la raya es un satélite terrestre que ha atravesado el campo durante la exposición.
Como ya hemos mencionado, los cúmulos más viejos tienen del orden de los 15.000 millones de años. Este debe de ser el tiempo que hace que nuestra Galaxia se separó del gas general que colmaba el Universo, y los cúmulos globulares y otras estrellas del halo pronto quedaron desamparados. Al seguir órbitas que las llevan eternamente a través del gigantesco dominio original de nuestra protogalaxia, estas primeras estrellas quedaron detrás de los nueve décimos del gas que penetró profundamente para formar el disco de la Galaxia. Hasta hace pocos años, los astrónomos consideraban el halo como una parte menor de la Galaxia, y sólo se interesaban en él a causa de la edad de sus estrellas. Pero en la actualidad hay un sentimiento creciente por parte de algunos astrónomos en cuanto a que pueden haber subestimado nuestro halo galáctico, ya que en lugar de ser sólo un décimo de la masa del disco puede ser diez veces más pesado.
La primera indicación al respecto provino de los teóricos que estudiaban los brazos espirales del disco de la Vía Láctea: efectuaron el desconcertante descubrimiento de que sus ecuaciones no daban cuenta de brazos espirales tan largos, a no ser que el halo tuviera un fuerte efecto gravitatorio. Esto significa que la inmensa región del halo debe contener al menos tanta materia como el disco; y los últimos estudios de los cúmulos globulares y de las pequeñas galaxias cercanas a nosotros han mostrado que la Galaxia de la Vía Láctea parece tener una atracción gravitatoria mucho más fuerte que lo esperado. El único sitio en donde esta masa extra puede estar «escondida» es en el halo que se extiende por arriba, por debajo y en torno al disco. Por consiguiente, podría llegar a modificarse nuestra imagen de la Vía Láctea, pasando de ser un importante disco de gas y estrellas, rodeado por unas pocas estrellas más viejas, a convertirse en una inmensa región esférica constituyente de la mayor parte de la masa de la Galaxia y que contiene un disco relativamente poco importante, que sólo destaca por el resplandor de sus constituyentes.
Sin embargo, muchos astrónomos se muestran cautos ante esta imagen del «halo masivo», por la sencilla razón de que no pueden ver en la actualidad toda la supuesta materia extra; cada estrella del halo tendría que tener cien veces más materia, y ésta no es visible. ¿Qué es la materia extra? Ciertamente, no está constituida por estrellas o gas ordinario, ya que los astrónomos la podrían detectar con telescopios ópticos, radiotelescopios o telescopios de rayos X; y tampoco está formada por granos de polvo, pues éstos impedirían nuestra visión del Universo más lejano. Pero existen diversas posibilidades de que haya materia en el halo sin que los astrónomos puedan detectarla.
Una de ellas, obviamente, es la de que exista un vasto número de agujeros negros, por definición invisibles; o alternativamente una plétora de objetos del tamaño de planetas que se muevan de modo independiente en vez de situarse en órbita en torno a una estrella.

La galaxia espiral M83 fotografiada en el Observatorio Anglo-australiano. El disco posee brazos espirales constituidos por porciones de gas y estrellas de reciente formación, mientras que las regiones del centro se componen de viejas estrellas esparcidas de modo más uniforme. Por encima y por debajo del disco hay un gran halo de viejas estrellas débiles, que aquí no aparece.
Cuerpos menores y mayores que granos de polvo no bloquearían, de forma significativa, la luz procedente de más allá de la Galaxia; y al ser más ligeros que cincuenta veces Júpiter, no brillarían como estrellas. Si los astrónomos que creen en el halo masivo están en lo cierto, nuestra Galaxia no está constituida predominantemente por estrellas y nubes de gas. Estos constituyentes obvios serían en realidad sólo un componente minoritario, y la mole de la Galaxia sería esencialmente materia invisible: agujeros negros, planetas, icebergs. Esta controversia es de difícil resolución, ya que los astrónomos no pueden proceder a observaciones para decidir al respecto; así pues, los teóricos han tomado la delantera al declarar que la materia extra es invisible. Esta es la cuestión más importante que actualmente nos formulamos acerca de las galaxias en general, y de la nuestra en particular.
Dejemos ahora el todavía enigmático halo y sigamos el destino del resto del gas de la protogalaxia, que se asentara para formar el disco en rotación. Aquí nacieron las estrellas, aunque no todo el gas se transformó en estrellas. Hasta la fecha, una décima parte del disco está constituida por el gas primitivo mezclado con los restos expulsados en las explosiones de supernova de estrellas moribundas. Las supernovas arrojan elementos pesados dentro del gas, y, de este modo, las próximas estrellas que se formen tendrán abundancia de estos elementos y estarán rodeadas por granos de polvo que pueden condensarse en planetas.
La característica más obvia del disco de nuestra Galaxia, como lo vemos desde fuera, es que de ningún modo parece un «disco», sino un par de brazos espirales que se desenrollan desde el centro de la Galaxia, tal como se ve en las fotografías de otras galaxias espirales. Hasta cierto punto, esto es sólo una especie de ilusión, ya que los brazos espirales están ensartados de estrellas brillantes y nebulosas resplandecientes que les vuelven más visibles, mientras que las estrellas más débiles están esparcidas de modo más uniforme tanto entre los brazos como en ellos.
Desde que el tercer Marqués de la Rosa viera por primera vez brazos espirales en algunas galaxias próximas, con ayuda de su monstruoso telescopio, el modelo de espiral constituyó durante un siglo un enigma fascinante. El problema reside en que no todas las estrellas del disco de una galaxia se mueven en torno al centro a igual velocidad.

Los brazos espirales de nuestra Galaxia puestos de manifiesto por la emisión de radio de 21 cm del hidrogeno neutro. Esta «fotografía» de la Galaxia, en planta, está centrada en el centro de la Galaxia; la posición del Sol se identifica par el pequeño punto circular de encima. (La porción blanca de abajo se debe al método utilizado para confeccionar el mapa.) Cortesía de Gart Westerhout.
Si los brazos espirales estuvieran siempre constituidos por las mismas estrellas, las que dentro de cada uno de ellos se hallasen más próximas al centro de la galaxia girarían más deprisa que las más alejadas; y, así, los brazos acabarían enrollándose gradualmente cada vez más. Esto no condice con los brazos abiertos que vemos en la mayoría de las espirales, por lo que finalmente los astrónomos han sugerido una teoría que parece concordar con las observaciones.
Comencemos por suponer una galaxia de disco, en la que las estrellas (dejando a un lado el gas por el momento) estén esparcidas a través del disco, pero ligeramente concentradas en un modelo de dos brazos espirales. Cuando las estrellas se mueven a lo largo de sus órbitas, las que partieron de un brazo se mueven fuera de él en la región situada entre ambos, mientras que las que originariamente se encontraban entre los brazos, se situarán en órbita dentro de uno de ellos. Por consiguiente, las estrellas que forman un brazo cambian constantemente, y el brazo espiral es sólo un modelo que muestra dónde se concentran más intensamente las estrellas. Podría esperarse que el modelo de espiral se distorsionara con rapidez como resultado de los movimientos de las estrellas, pero aquí reside lo más bello de la teoría. Dado que en un principio las estrellas estaban más concentradas en los brazos espirales, éstos tienen una atracción gravitatoria mayor que cualquier otra parte del disco. Una estrella que se halla en órbita hacia un brazo, se acelerará al aproximarse a él e irá más lenta cuando se aleje. En consecuencia, a diferencia de un planeta que describe una órbita circular en torno al Sol, una estrella no circunda la galaxia a velocidad constante, sino que emplea más tiempo en la región de un brazo espiral. Pero mientras la estrella está en esa zona, su atracción gravitatoria contribuye a la atracción total de la misma, y esto lleva a que se alteren las velocidades de las demás estrellas, de modo que también ellas estarán más tiempo en la región del brazo.
El resultado es que el modelo no se altera. Este conjunto de dos brazos espirales gira en verdad despacio, pero a distinta velocidad que la de las estrellas, por lo que siempre conserva su bella forma. Si miramos ahora uno de los brazos espirales, y volvemos a hacer lo propio dentro de 50 millones de años, las estrellas que lo forman habrán cambiado, pero la espiral sólo habrá girado ligeramente. Sin embargo, el modelo de dos brazos espirales ha sido generado por el movimiento de las estrellas a través de ellos: este modelo es consecuencia de su propia gravitación y no tiene como objeto guiar las vidas de nuestros antepasados, como pretendían los insustanciales mitos de los antiguos transmitidos de generación en generación.
El modelo de espiral tiene un efecto más dramático sobre el gas del disco. El impacto de un cambio repentino de velocidad del brazo agrupa el gas en gigantescas nubes que se ensartan en el interior de los brazos, que los granos de polvo destacan cual un forro oscuro de los brillantes brazos. Además, la repentina compresión puede obligar a las nubes a colapsarse en estrellas, y fotografías de otras galaxias muestran los brazos enjoyados con nebulosas brillantes de estrellas recientes. Las estrellas de fusión de hidrógeno extremadamente masivas también iluminan los brazos, pero como estas estrellas muy brillantes viven sólo un breve periodo antes de explotar como supernovas, no tienen siquiera tiempo para situarse en órbita fuera del brazo en el que han nacido. Los brazos espirales son lugares emocionantes repletos de estrellas recién nacidas, de estrellas muertas y de otras más exóticas y brillantes.
§. Las espirales de la Vía Láctea
Dado que vivimos en el espeso disco de la Vía Láctea, a unos 30.000 años luz de su centro, no resulta fácil ver la estructura espiral de nuestra Galaxia. A este respecto, los astrónomos conocen menos de nuestra propia Galaxia que de otras. Una aproximación consiste en contemplar los tipos de objetos que viven únicamente en los brazos espirales, grandes nebulosas y estrellas brillantes masivas. De esta forma, los astrónomos han determinado que el Sol se encuentra aproximadamente a mitad de camino entre las espiras de los brazos. Unos 7.000 años luz más afuera se encuentra el brazo de Perseo, mientras que a la misma distancia hacia el centro galáctico está el brazo de Sagitario. Próximas al Sol se encuentran las jóvenes estrellas brillantes y nebulosas igualmente sobresalientes en la constelación de Orion, aun cuando en la actualidad los astrónomos piensan que este «Brazo Local» es apenas un apéndice del brazo de Perseo. Guando el Sol se halla en órbita a través de un brazo mayor, el cielo entero debe de ser tan brillante como la constelación de Orion.

Un distante cúmulo de galaxias, catalogado como Abell 1060, fotografiado en el Observatorio Anglo-australiano. Las manchas borrosas (arriba) son galaxias elípticas, y abajo es visible una gran galaxia espiral. (Los cuatro objetos, brillantes son estrellas de nuestra Galaxia; las cruces son efecto óptico del telescopio.)
Los radioastrónomos han dado un impulso mayor al intento de poner al descubierto la estructura espiral completa de la Galaxia. Afortunadamente, el átomo más común del espacio, el hidrógeno, emite radiación en la parte de radio del espectro. El átomo de hidrógeno es simplemente un electrón que se halla en órbita en torno a un protón, y ambas partículas giran sobre sus ejes. La teoría cuántica insiste en que sus ejes de giro están alineados, y en que pueden girar en igual dirección o en direcciones opuestas, pero nunca en otro plano. Al pasar del «mismo spin» al «spin opuesto», los electrones emiten un cuanto de energía: un fotón de longitud de onda de 21,106 centímetros. Aunque cada átomo de hidrógeno hace esto raramente una vez cada 11 millones de años de media- , hay' suficiente hidrógeno para que se emita una señal que pueda medirse.
Puesto que ésta es una línea espectral cuya longitud de onda se conoce con gran precisión, los astrónomos pueden medir la velocidad de cualquier nube de hidrógeno interestelar que se aleje de nosotros, o se nos acerque, observando el corrimiento Doppler de la longitud de onda que emite. Según los patrones ordinarios, la Galaxia gira rápidamente (el Sol se halla en órbita en torno al centro galáctico a 250 kilómetros por segundo), y la velocidad de rotación necesaria para equilibrar la atracción gravitatoria de la Galaxia depende de la distancia de la nube o de la estrella al centro. Así pues, casi todo el hidrógeno se mueve respecto a nosotros.
Sintonizando cuidadosamente la emisión de 21 centímetros de las nubes de hidrógeno, los astrónomos llegaron a dos importantes resultados. Primero: pueden «pesar» la Galaxia. Cada estrella y cada nube de gas tiene determinada su velocidad por la atracción gravitatoria de las demás estrellas y del gas más cercano al centro galáctico. Mediante cálculos, los astrónomos pueden determinar el modo en que se distribuye la masa de la Galaxia. Dentro de la órbita solar, la masa total es de aproximadamente 100.000 millones de soles; y puesto que el Sol se halla a aproximadamente dos tercios del borde del disco, la masa total de este es tal vez un 50% mayor. (Desgraciadamente, este método nada nos dice acerca del halo masivo que puede o no rodear al disco.)
Si se invierten estos resultados, una vez que se sabe cómo gira el disco, los astrónomos pueden emplear la velocidad aparente de una nube de gas para calcular su distancia. Luego, pueden representarse estas nubes de gas denso de los brazos espirales en un mapa que muestre la forma de gran espiral de nuestra Galaxia de la Vía Láctea. Los astrónomos ópticos no pueden ver estas distantes regiones de los brazos, pues los granos de polvo del espacio interestelar bloquean su luz, por lo que constituyó una etapa significativa en la historia de la radioastronomía el que los mapas del hidrógeno de los brazos mostraran lo que se podía aprender de otras radiaciones que no fueran la luz.
§. Hermanos en el espacio
Hemos dado un rápido vistazo a la Galaxia de la Vía Láctea, nuestro sistema familiar y una de las bellas espirales típicas. Nuestra gran vecina más cercana, la Galaxia ele Andrómeda, casi gemela de la nuestra aunque aproximadamente la mitad de extensa, es una de las espirales más grandes conocida. Básicamente, todas las espirales se parecen a la nuestra, con tenues halos y discos brillantes: para comprender la rica variedad de hermosas formas que estas galaxias pueden adquirir, lo mejor es contemplarlas en fotografías.
Los astrónomos clasifican las espirales según la abertura de sus brazos y el tamaño de la «joroba» de viejas estrellas del centro del disco. Incidentalmente, resulta improbable que las galaxias cambien de un tipo a otro cuando envejecen. Las formas de las galaxias están probablemente determinadas por la manera en que se colapsaron las protogalaxias originales. Un tipo de espiral ligeramente diferente corresponde a las clasificadas como espirales barradas, en las que la joroba central de viejas estrellas forma una corta barra y las estrellas se hallan en órbitas que conservan la forma de barra en vez de mantenerse como brazos espirales. Por consiguiente, no podemos excluir la posibilidad de que nuestra Galaxia sea una espiral barrada, Algunos astrónomos piensan que algunos sorprendentes movimientos de gases, próximos al centro galáctico, tienen su origen en la atracción gravitatoria de una barra en rotación.
Las galaxias espirales más pequeñas son aproximadamente un tercio de la nuestra. Hay otras galaxias más pequeñas con aproximadamente la misma mezcla de gas y estrellas, pero no tienen forma espiral, sino otra indefinida, por lo que se las denomina galaxias irregulares. La Nube Pequeña de Magallanes, visible desde latitudes australes, es una de estas pequeñas galaxias irregulares. Su compañera, la Nube Grande de Magallanes, es un fascinante caso límite. Es casi tan grande como para ser espiral, y sé tiene la convicción de que posee una barra central v un débil brazo espiral; hay astrónomos que sugieren clasificarla como una «espiral tipo Magallanes» de un brazo.

Las galaxias de un cumulo son invisibles para un telescopio de detección de rayos X. Los rayos X se originan en una nube de gas muy caliente situada entre las galaxias v que se condensa hacia el centro del cúmulo. Este «mapa de contorno» en color codificado muestra los rayos X emitidos por el gas del cumulo de galaxias Perseus. Cortesía de John Zarnecki.
Tanto las espirales como las irregulares contienen mucho gas, que, en la actualidad, da lugar a la formación de estrellas. Pero en el Universo hay otra clase de galaxias, sin gas y sin estrellas en formación. Al ser estas galaxias las primeras en condensarse, todo el gas de la protogalaxia debió convertirse en estrellas sin dejar nada para generaciones futuras, o bien sus gases residuales fueron expulsados de un modo u otro. Estas estrellas han estado en órbita indefinidamente durante los últimos 15.000 millones de años en un volumen prácticamente esférico de espacio, constituyendo una galaxia elíptica sin rasgos distintivos. Las galaxias elípticas carecen de carácter o individualidad; hasta hace pocos años, los astrónomos las consideraban simples reliquias descoloridas de un perdido esplendor, pero descubrimientos recientes han revelado algunas elípticas diferentes, como veremos más adelante.
Sin embargo, contemplemos ante todo el trazado general de las galaxias en el espacio. No están esparcidas al azar, sino agrupadas gregariamente en cúmulos de todos los tamaños. Nuestro Grupo Local de Galaxias está formado por la Vía Láctea alineada con la Galaxia de Andrómeda, una galaxia más pequeña en la Constelación del Triángulo, las Nubes de Magallanes y un par de docenas de galaxias enanas; es pequeño, a escala cósmica, pero es probablemente un rincón típico del Universo. Incluso en este Grupo Local, próximo a escala extragaláctica, se han efectuado interesantes descubrimientos: los radioastrónomos descubrieron una corriente de gas hidrógeno que liga a las Nubes de Magallanes con nuestra Galaxia, y cuyo rastro se extiende a través de 200.000 años luz por el casi vacío espacio intergaláctico; además, encontraron galaxias enanas, tan débiles que serían virtualmente invisibles fuera del Grupo Local, aunque probablemente sean el tipo más común en el Universo; y, por último, una galaxia gigante elíptica, Maffei 1, que puede ser el miembro mayor de nuestro grupo, pero que no se detectó hasta 1968 por encontrarse detrás del polvo que oscurece nuestra Galaxia.
Otros cúmulos de galaxias son mayores, con más de tres mil miembros que se mantienen juntos, cual un enorme enjambre, debido a sus atracciones gravitatorias mutuas. En el centro de los cúmulos mayores acechan las galaxias elípticas supergigantes, las más masivas del Universo. Muchos astrónomos piensan que han alcanzado este tamaño —cien veces más pesado que el de la Vía Láctea— por canibalismo. Tras iniciarse como grandes elípticas corrientes, han engullido a las galaxias que pasan por el centro del cúmulo, añadiendo estas estrellas a sus propias poblaciones e hinchándose hasta dimensiones enormes.
Entre las galaxias de estos ricos cúmulos hay una vasta cantidad de gas caliente (y aquí, «caliente» significa la inimaginable temperatura de 100.000.000 °C). Este gas emite rayos X de manera copiosa, aun cuando produce poca luz visible, y los satélites de astronomía de rayos X han detectado unas cincuenta de estas nubes de gas, extremadamente distantes, atrapadas por la gravitación de los cúmulos de galaxias. Este gas atrapado quizá sea la explicación de por qué las galaxias de los ricos cúmulos son, casi todas, elípticas, especie rara en el Universo. Cualquier galaxia que se mueva a través del gas del cúmulo será despojada del suyo propio, convirtiéndose en una galaxia formada únicamente por estrellas viejas. En los cúmulos, los astrónomos han señalado un subtipo de elípticas: galaxias en forma de lente de viejas estrellas que parecen ser restos de galaxias espirales corrientes, despojadas de su gas por este procedimiento y dejando sólo un disco de viejas estrellas. Una espiral ordinaria, como nuestra Vía Láctea, no sería afortunada si se encontrase en un rico cúmulo: si lograse escapar a las predaciones de la galaxia caníbal supergigante del centro, podría verse privada de sus bellos brazos espirales por el gas del cúmulo.
Existe todavía otro gran misterio en torno a los cúmulos de galaxias: la masa perdida.

Una imagen sobreexpuesta del brillante quásar más próximo, 3C 273; el quásar aparecería como un punto luminoso si su luz rio juera dispersada por la atmósfera terrestre.
Los astrónomos pueden calcular las masas de las galaxias elípticas a partir de la configuración de sus líneas espectrales, ensanchadas por el corrimiento Doppler de sus estrellas, o bien a partir de los pares de elípticas que se hallan en órbita una respecto a otra. Así, resulta bastante sencillo sumar las masas de todas las galaxias de un cúmulo y ver cómo sería la intensa atracción gravitatoria entre ellas. Pero las galaxias de un cúmulo se mueven con excesiva rapidez: la atracción gravitatoria no es suficiente como para mantenerlas juntas; por lo que los astrónomos han llegado a la conclusión de que debe de haber algo en el cúmulo que le proporcione una atracción gravitatoria extra, y que esta materia invisible suministra de cinco a diez veces la masa existente en las propias galaxias.
Las galaxias se distribuyen de forma que la masa desaparecida debe de hallarse extendida por el cúmulo. Aunque el gas caliente está esparcido de esta forma, las mediciones de rayos X muestran que no lo hay en grado suficiente; la masa desaparecida parece encontrarse en un número inmenso de cuerpos invisibles. Esto es factible si se tiene en cuenta que el hecho de que sólo veamos una décima parte de la materia de los cúmulos es una idea notablemente similar a la de que la mayor parte de la masa de nuestra Galaxia puede consistir en un halo invisible. Algunos de los más osados astrónomos actuales especulan acerca de que la mayor parte de la materia del Universo pueda ser invisible, tanto en lo que respecta a los radioastrónomos de rayos X y de otras radiaciones, así como en cuanto a los telescopios ordinarios. Sin embargo, el interrogante está aún lejos de obtener respuesta. Puede haber, de hecho, vías para resolver el problema de la masa desaparecida sin dar un paso osado, y por ello los astrónomos no cejan en sus intentos por comprender lo que ocurre en estos inmensos cúmulos, las concentraciones más grandes de materia del Universo.
§. Los quásares
En 1963, los astrónomos despertaron bruscamente de la contemplación efectuada desde siglos de un firmamento cual un paraíso de serena armonía, con planetas en suave órbita en torno a las estrellas, con estrellas circundando elegantemente a las galaxias, y con galaxias como islas tranquilas en el espacio.

Cuando este gran radiotelescopio de Jodrell Bank queda enlazado electrónicamente con otros radiotelescopios distantes, pueden discernirse detalles sutiles en la estructura de radioemisión de los quásares.
La joven ciencia de la radioastronomía se asoció a la astronomía óptica y el resultado fue otro descubrimiento sorprendente: los quásares.
Los radioastrónomos se hallaban en una primera etapa de su exploración de las ondas de radio procedentes del cielo. Su tarea consistía en catalogar las radiofuentes individuales y en medir con precisión sus posiciones, de modo que los astrónomos ópticos pudieran ver lo que sucedía en ese punto del cielo. Ya se sabía que las fuentes de nuestra Galaxia coincidían con nebulosas calientes (como la Nebulosa de Orion) y con conchas de gas que se expandían desde viejas supernovas, siendo la más famosa la Nebulosa del Cangrejo. Algunas galaxias, asimismo, parecían ser radiofuentes; y la segunda más intensa del cielo llamada Cignus A fue asociada con una distante y débil galaxia. Dado que esta fuente «eclipsaba», en términos de ondas de radio, a miles de galaxias más próximas, algo extraordinario debía de estar sucediendo allí. Sin embargo, el mundo astronómico no estaba aún preparado para la magnitud del nuevo descubrimiento.
La historia del quásar comenzó bastante inocentemente, al detectarse con precisión tres pequeñas fuentes de radio que coincidían con objetos semejantes a estrellas en las placas fotográficas del cielo. Los astrónomos supusieron que estos puntos de luz eran realmente estrellas de nuestra Galaxia, pero estrellas de una clase especial, pues constituían potentes transmisores de radio. Los espectros de estas estrellas eran en verdad peculiares. En vez de una banda luminosa de todos los colores, cruzada por líneas oscuras, estas «estrellas» mostraban líneas brillantes cuyas longitudes de onda resultaban aún más sorprendentes.
Como vimos en el capítulo 7, cada elemento emite y absorbe luz de longitudes de onda específicas, que únicamente varían por efecto Doppler cuando proceden de una estrella que se mueve en nuestra propia Galaxia. Pero las líneas de estos objetos, semejantes a estrellas, correspondían a un elemento desconocido que resultaría incluso peculiar para una estrella que emite ondas de radio.
La clave la proporcionó otra fuente de radio catalogada con el número 273 en el tercer catálogo de Cambridge de radiofuentes, con abreviatura 3C 273. La Luna pasó por delante de esta fuente en 1962; los radioastrónomos midieron el momento exacto en que estas señales de radio se interrumpían y volvían a aparecer, y así calcularon su posición exacta. Los astrónomos ópticos consideraron que era una «estrella» verdaderamente brillante —visible con un telescopio corriente y, asimismo, con un espectro peculiar. En febrero de 1963, el astrónomo holando-americano Maarten Schmidt encontró súbitamente la respuesta. En uno de esos momentos de intuición que constituyen hitos en una carrera científica, advirtió que el modelo de las líneas era simplemente la «huella dactilar» del hidrógeno, pero desviada hacia el extremo rojo del espectro en un 15,8%. Si se trataba de un corrimiento Doppler, el objeto se alejaba de nosotros a 45.000 kilómetros por segundo, demasiado velozmente como para ser una estrella de la Vía Láctea. Puesto que, evidentemente, no eran estrellas, estos objetos fueron denominados «objetos cuasiestelares», abreviados más tarde como «quásares».
Hay una interpretación natural al respecto. Como veremos con mayor detalle en el próximo capítulo, el Universo se expande de modo que, cuanto más distante se halle una galaxia, más rápidamente se aleja de nosotros, y sus líneas espectrales presentan un corrimiento Doppler mayor hacia el extremo rojo del espectro. Los quásares tendrían que situarse más allá del dominio de las galaxias, alejándose con la expansión general del Universo; y el cambio de longitud de onda debería informarnos acerca ele su distancia. 3C 273 se hallaría entonces a 2.000 millones de años luz de nuestra Galaxia.

El telescopio de 11 metros de diámetro del Observatorio Nacional Kitt Peale, en Atizona, detecta radiación en la frontera entre las ondas de radio y las infrarrojas, constituyendo así un puente entre los telescopios ordinarios de reflexión y los radiotelescopios. Estas longitudes de onda son emitidas intensamente par los quásares. Cortesía de Jan Robson.
Pero, dado el caso, los quásares son inmensamente brillantes. Muchos de ellos son cientos de veces más brillantes que una galaxia normal, y comparativamente diminutos, apareciendo en las placas fotográficas cual puntos de luz; se parecen más a una estrella que al extenso contorno de una galaxia distante. Y los astrónomos pueden apelar a un argumento muy simple para decir aproximadamente cuál es el tamaño de un quásar, como veremos a continuación.
Imaginemos que, de pronto, pudiera apagarse el Sol. Ahora bien, el borde del Sol se halla ligeramente más lejos de la Tierra que el centro del disco; así, las señales luminosas desde el borde tardan alrededor de dos segundos más en alcanzarnos. Aun cuando la superficie solar se oscureciese en un instante, veríamos al momento que el centro se vuelve negro, pero nuestros ojos registrarían todavía fotones del borde, que le habrían abandonado dos segundos antes, cuando el Sol aún brillaba. De este modo, percibiríamos que una onda de oscuridad avanzaría desde el centro hacia afuera, para alcanzar el extremo del Sol dos segundos después. La luz del Sol parecería apagarse con lentitud, simplemente a causa de su tamaño. Un astrónomo distante, que viera el Sol como un simple punto de luz, se atrevería a afirmar que nuestro Sol tiene unos dos segundos luz de radio, simplemente cronometrando su extinción.
Los quásares no son faros constantes en el espacio, sino que «titilan», se abrillantan y oscurecen tan irregularmente como una bujía con la brisa, aun cuando su titilación tiene lugar ' a escala de meses. Por consiguiente, los astrónomos pueden afirmar de inmediato que los quásares poseen únicamente una extensión de algunos meses luz. Y aquí reside el nódulo del problema. Si los quásares están tan lejos como sus corrimientos Doppler lo indican, producen tanta luz como un centenar de galaxias, y ello desde una región casi un millón de veces menor que una galaxia. Esto significa tanta luz como la de diez billones de estrellas agrupadas en una región espacial que tuviese 1/10 del tamaño de la distancia del Sol a la estrella más próxima.
Algunos astrónomos se resistieron a creerlo así, y la década de 1960 y los tempranos 1970 asistieron a la gran controversia sobre los quásares. Los astrónomos más destacados se enfrentaron unos a otros, y se cuestionaron la identidad de los quásares, su lejanía y la desviación de sus líneas espectrales hacia el rojo. Otros llegaron tan lejos como para exigir nuevas leyes de la física que explicaran los quásares. La controversia ha amainado en la actualidad, y la mayoría de astrónomos concuerda en que los quásares contienen realmente mucha energía en un pequeño volumen, y en que, en verdad, son los objetos más distantes del Universo.
Los quásares se descubrieron antes de tiempo. Los astrónomos de los primeros años de la década de 1960 no estaban preparados para aceptar este caos en su ordenado Universo. A partir de entonces, todas las ramas de la astronomía subrayaron este derroche de energía de la Naturaleza. A pequeña escala (en sentido galáctico), los astrónomos de rayos X descubrieron potentes fuentes binarias de rayos X —en las que el gas que incide sobre una estrella de neutrones ha convertido parte de su masa en energía —, así como los aún más dramáticos agujeros negros, en donde el gas que los rodea —que describe una espiral hacia adentro— ha convertido casi la mitad de su masa en energía. De hecho, en 1963 se desconocían las ultracompactas estrellas de neutrones y los aún más exóticos agujeros negros. Nadie por entonces advirtió que la Naturaleza había proporcionado formas de convertir de modo tan eficiente materia en energía y, por consiguiente, las fuentes de energía de los quásares constituían, naturalmente, un enigma.
A partir de ese momento, los astrónomos que estudian el escenario extragaláctico verificaron que el Universo es violento. Nada hay tranquilo, desde las galaxias ordinarias por un lado hasta los quásares por olio. La mayoría de las galaxias parecen poseer un diminuto «núcleo» central donde se supone que radicaría la clave del fenómeno quásar. Por ejemplo, algunos núcleos de galaxias son efectivamente «miniquásares»; y los hay en una gama completa de galaxias, desde aquéllas cuyos núcleos son demasiado débiles para brillar o afectar el entorno de la galaxia, pasando por las que brillan débilmente y expulsan nubes de gas desde el centro, hasta las galaxias cuyo núcleo es tan brillante que resulta difícil ver lo que las rodea. Los quásares «clásicos» parecen ser, simplemente, los núcleos más energéticos de todos, los más violentos criminales en un Universo en el que todos los núcleos de las galaxias son, en mayor o menor grado, malhechores. Y dado que los quásares son tan impetuosos, los astrónomos tuvieron, naturalmente, noticias de ellos antes que de sus hermanos más pacíficos, dando a conocer sus hazañas en las publicaciones de astronomía.
§. Los miniquásares
Incluso nuestra propia Galaxia puede abrigar en su corazón un «subminiquásar» o un «microquásar». El centro de nuestra Galaxia fue territorio desconocido hasta hace pocos años, supuesto que los astrónomos ópticos no podían estudiarlo por entero; los granos de polvo interpuestos absorben prácticamente toda la luz. Se ha estimado que sólo una parte en cien mil millones de la luz del centro galáctico llega hasta nosotros, y esto no es suficiente para detectarla ni siquiera con los mayores telescopios. Así pues, los astrónomos ópticos se hallan curiosamente en una posición que les permite saber más acerca de los núcleos de otras galaxias, a millones de años luz, que del núcleo de la nuestra.
Sin embargo, las radiaciones de longitud de onda más larga pueden penetrar el polvo, y los radioastrónomos saben, desde hace veinte años, que las enormes nubes de gas próximas al centro galáctico se alejan de él, como si hubiera habido una explosión hace unos millones de años. En la actualidad, con técnicas perfeccionadas, se han familiarizado con las regiones centrales al encontrar una pequeña radiofuente, de sólo el tamaño de la órbita de Júpiter en torno al Sol. A escala de nuestra Galaxia, esto supone un minúsculo volumen de espacio; y en comparación con su tamaño, es un radiotransmisor tremendamente potente: si se comparan volúmenes, es tan intensa como los núcleos emisores de los quásares.
Los astrónomos de infrarrojo han aportado otra pieza al rompecabezas al observar que el brillo del infrarrojo aumenta hacia el centro de la Galaxia, debido simplemente a que las estrellas están allí más agrupadas. Si viviéramos dentro del centro de la Galaxia, en una región de un año luz de extensión, el cielo estaría tachonado de millones de brillantes estrellas próximas, rivalizando la más brillante de todas con la Luna llena. No habría noche real, pues las estrellas mantendrían el cielo iluminado todo el tiempo.
El espacio entre las estrellas del centro está surcado por chorros de gas, y los movimientos de este gas informan a los astrónomos de infrarrojo acerca de la masa existente. En 1977, mediciones de este tipo mostraron que parecía haber mucha más masa próxima al centro que de la que pueden dar cuenta las estrellas. Una vez más, la «masa desaparecida», pero, ahora, en el corazón de nuestra Galaxia. A pesar de que es necesario comprobar estas dificultosas mediciones, algunos astrónomos han dado el paso decisivo sugiriendo que esta masa extra forma un gigantesco agujero negro en el centro de la Galaxia. Este masivo estómago, cinco millones de veces más pesado que el Sol (pero únicamente veinte veces mayor, no sólo explicaría con certeza la masa desaparecida; el gas y las estrellas desintegradas describirían una espiral hacia su interior, y su masa podría convertirse en las enormes cantidades de radioondas que captamos procedentes del centro galáctico. La radiofuente que constituye el «microquásar» podría ser la región que rodea a un masivo agujero negro, que indicase el centro preciso de nuestra Galaxia de la Vía Láctea.
Al parecer, hemos ingresado en el dominio de la ciencia ficción con los inmensos agujeros negros que se tragan a las estrellas. Pero hay razones de peso para pensar que los agujeros negros son la explicación «más aceptable» de los miniquásares y de los quásares, en opinión de Martin Rees, astrónomo de Cambridge. Rindámonos a la evidencia, pues un comportamiento tan extraño es difícil de explicar de otra forma.
Las demás galaxias espirales pueden poseer microquásares parecidos al nuestro, pero la mayor parte de ellos deben de ser demasiado débiles como para poderlos detectar. La siguiente etapa en la escala de miniquásares son las Galaxias de Seyfert. Observadas por vez primera por el astrónomo americano Cari Seyfert, en 1943, son aparentemente galaxias espirales normales, pero con un núcleo central excepcionalmente brillante al que ahora podíamos denominar miniquásar. En torno a él surgen chorros y nubes de gas a enormes velocidades de miles de kilómetros por segundo. Claramente, el miniquásar indica el lugar de algún tipo de tremenda explosión.
Resulta bastante interesante el que aproximadamente una de cada diez de las grandes galaxias espirales del mismo tipo que la Vía Láctea— posea uno de estos núcleos brillantes y nubes de gas en explosión. Y existen buenas razones para pensar que las Galaxias de Seyfert no hayan sido siempre tan activas. Es más probable que sus núcleos se inflamen bastante a menudo, lo que abre la fascinante posibilidad de que, ocasionalmente, se puedan inflamar los núcleos de todas las grandes espirales y se manifiesten como Galaxias de Seyfert de miniquásares. Quizás el microquásar del corazón de nuestra propia Galaxia esté ahora en reposo: en el pasado, y quizá nuevamente en el futuro, pudo y pueda inflamarse con la actividad del miniquásar del núcleo de una Seyfert.
Cuando investigamos el espectro del centro de una Seyfert, descubrimos que la denominación «miniquásar» resulta incluso más idónea. El núcleo es intrínsecamente más débil que un quásar, y las líneas espectrales muestran menor corrimiento Doppler de longitud de onda, simplemente porque las Seyfert están comparativamente más cerca a escala cósmica; pero, por otro lado, el espectro es casi idéntico al de un quásar. Cualquier cosa que suceda en un quásar ocurre también, a menor escala, en el núcleo de una Seyfert.
Estos núcleos fluctúan asimismo en brillo, como un quásar. Irónicamente, algunos de los núcleos más brillantes de las Galaxias de Seyfert se clasificaron en primera instancia como estrellas variables, pues en las fotografías de corta exposición no se ven los «difusos» alrededores de las estrellas que constituyen la galaxia, sino únicamente el brillante y parpadeante núcleo. Puesto que esto sucedió antes de que los astrónomos hubiesen aceptado la violencia a escala galáctica, estos puntos de luz variable se asimilaron a débiles estrellas variables de nuestra propia Galaxia.
En 1978, los astrónomos descubrieron una Galaxia de Seyfert relativamente próxima, cuyo núcleo es tan brillante: e intenso como un quásar real. Catalogada como ESO 113-IG45 o Fairall 9, acorde con su descubridor el astrónomo sudafricano Anthony Fairall, esta galaxia es «el eslabón perdido» entre las Seyfert y los propios quásares. Está suficientemente cercana a nosotros como para apreciar tanto el centro tipo quásar como las estrellas que rodean la galaxia. Si se pudiera llevar la Fairall 9 cada vez más lejos, los alrededores de la galaxia aparecerían difusos y borrosos, llegando a hacerse invisibles, mientras que el punto brillante del núcleo seguiría mostrándose aún en las fotografías. A esta distancia, la galaxia se movería con bastante rapidez debido a la expansión del Universo, y el espectro del núcleo presentaría un gran corrimiento Doppler; y los astrónomos dirían: «Esto es un quásar.»
El astrónomo americano Jerome Kristian abordó la misma cuestión desde el otro extremo para terminar ofreciendo igual respuesta. Kristian seleccionó los quásares más próximos, e intrínsecamente más débiles, y descubrió que las fotografías de larga exposición muestran un débil entorno «difuso», que es la luz combinada de todas las estrellas ordinarias de la galaxia que rodea el núcleo del quásar.
Por consiguiente, los quásares no son tan extraños, ni objetos completamente distintos, como parecían al principio. Son únicamente versiones superpotentes de los núcleos de galaxias, que difieren sólo en el grado de violencia de los que comenzó a estudiar Cari Seyfert en la década de 1940. Como era de esperar, estos núcleos galácticos, extremadamente violentos, son realmente raros en el Universo, ya que la mayoría de los potentes se hallan muy lejos. Únicamente en unos cuantos próximos, como Fairall 9, puede verse la galaxia que les rodea. La enorme potencia de estos núcleos, que hace que las regiones centrales brillen tan intensamente (el quásar 3C 279, por ejemplo, puede ser diez mil veces más resplandeciente que toda nuestra Galaxia), implica que los astrónomos puedan verlos incluso a enormes distancias. Los astrónomos pueden detectar quásares mucho más lejanos que una galaxia ordinaria. Estos faros celestes son los objetos más alejados que los telescopios pueden mostrarnos.
§. Los mensajes de las radiogalaxias
No cabe duda en cuanto a que los quásares son espectaculares. Pero muy poco revelan acerca de dónde se origina su asombrosa energía. Quizá los agujeros negros grandes constituyan una posibilidad para ello, pero los astrónomos necesitan una mayor evidencia antes de rechazar otras alternativas. Y he aquí que los radioastrónomos han descubierto una pista fundamental en unas galaxias que, aun no siendo insólitas en fotografías, son potentes radiotransmisores.
Gygnus A fue la primera radiogalaxia potente identificada. Como ya hemos visto, los astrónomos se mostraban sorprendidos por la potencia de su radiotransmisión, y el impacto fue mayor cuando mediciones más sensibles descubrieron que las ondas de radio no provenían del centro de la Galaxia; en vez de ello, las que generaban las ondas de radio eran enormes nubes, una a cada lado de la Galaxia. Cygnus A se convirtió en la radiogalaxia típica (ahora se conocen cientos de ellas), pero prácticamente todas las galaxias están formadas por un par de nubes radioemisoras. Si nuestros ojos fueran sensibles a las ondas de radio, veríamos el doble por la noche, pues aun cuando las propias galaxias seguirían siendo invisibles, contemplaríamos en cambio (despreciando las fuentes de radio de nuestra Galaxia) el ciclo colmado de estas «nubes» dobles.
El gran astrofísico soviético Josef Shklovsky fue el primero en calcular que el tipo de radioemisión de estas nubes debe proceder de electrones que se mueven a gran velocidad en un campo magnético. El problema que atormentó a los radioastrónomos durante los últimos veinte años consiste en saber cómo llegaron los energéticos electrones y el campo magnético al virtualmente vacío espacio exterior de la galaxia, y por qué se escindieron en dos nubes distintas a ambos lados de la misma.
Un par de grandes nubes radioemisoras puede no parecemos un suceso tan violento como la actividad encerrada en un núcleo de quásar, pero los cálculos muestran que hay involucrada allí una enorme cantidad de energía. En primer término, las radionubes de Cygnus A son emisoras tan potentes de radioondas como la luz de todas las estrellas de la Vía Láctea; y, además, estas nubes emisoras se hallan en un espacio prácticamente vacío. Cálculos posteriores muestran que la energía real que se mantiene encerrada en las nubes —en forma de campo magnético y energía de movimiento de los electrones es inmensamente mayor que lo esperado. Consideremos que para mantener al Sol brillando durante toda su vida es preciso que una milésima parte de su masa se transforme en energía, según la ecuación de Einstein: E = mc2

El mayor objeto conocido del Universo, la radiogalaxia 3C 236. Esta «fotografían generada por ordenador muestra su radioemisión; la galaxia en sí coincide con el rectángulo central, mientras que las dos «nubes» de radio exteriores están separadas por 20 millones de anos luz. (Copyright de Netherlands Foundation for Radio Astronorny, publicado con permiso del Observatorio de Leiden.)
Pensemos acerca de la continua emisión de luz y calor del Sol y multipliquémosla por diez mil millones de años; esto supone la cantidad de energía equivalente a sólo una milésima de la masa solar. Cada una de las nubes radioemisoras de Cygnus A contiene la energía equivalente a cien mil soles. En otras palabras, tendríamos que destruir totalmente esta cantidad de estrellas típicas y convertirlas por entero en energía, en forma de electrones rápidos y campo magnético, para producir una radiofuente tan potente. Más aún, estas nubes se hallan fuera de la propia galaxia, donde no hay estrellas que proporcionen toda esta energía.
No cabe duda de que la energía debe provenir del núcleo de la galaxia. Algunos quásares poseen un par muy similar de grandes nubes de radio, y en este caso la fuente de energía es, obviamente, el violento núcleo. Asimismo, muchas radiogalaxias tienen una diminuta radiofuente en sus corazones, lo que es señal de que ocurre algo especial, aun cuando esto no sea la causa de que el núcleo brille tan intensamente como un quásar.
La explicación más común entre los radioastrónomos actuales dice que de los núcleos de galaxia brotan «haces» de electrones rápidos en direcciones opuestas, que abren túneles a través del tenue gas que se extiende en torno a la galaxia. Al final de este túnel, los electrones, que se han movido sin trabas hasta entonces, se estrellan en el gas de los alrededores. Su movimiento se interrumpe, quedando todos enredados en el embrollado campo magnético (que se mueve con ellos o ha sido generado por el movimiento turbulento de los electrones), y su energía se emite en forma de ondas de radio. Los electrones, esparcidos hacia atrás por la colisión con el gas envolvente, se despliegan en una inmensa nube radiotransmisora, mientras que el final del túnel aparecería como un potente «punto caliente» de radio.
Se verifica, en verdad, que las radiogalaxias potentes poseen «puntos calientes» en los bordes más externos de las nubes. Y en 1977, los astrónomos descubrieron luz débil proveniente de estas regiones. Al igual que las radioondas, la luz procede de electrones que giran en un campo magnético tías haber rebotado en el gas estacionario del extremo del túnel. La luz proveniente de estas etéreas colisiones es tanta como la de millones de estrellas de una pequeña galaxia normal. Un astrónomo que viviera en un planeta de una radiogalaxia vería «galaxias» compañeras débiles, una a cada lado del cielo, que no serían galaxias ordinarias como las Nubes de Magallanes de la Vía Láctea.

Una galaxia en explosión, Centauras A, fotografiada en el Observatorio Anglo-australiano. Una explosión central ha lanzado un anillo de polvo oscuro, infrecuente en una galaxia elíptica. Los radiotelescopios ponen de manifiesto grandes nubes emisoras a ambos leídos de la galaxia alimentada por su energético núcleo central.
Aparecerían como misteriosas y brumosas manchas informes, que no se revelarían en el telescopio más que como un suave y blanco destello semejante a salpicaduras de pintura luminosa en la negra bola de la noche. Incidentalmente, sería mucha más la gente que en semejante planeta observase el cielo nocturno, ya que el intenso ruido de radio procedente de las «nubes» obstaculizaría cualquier transmisión de televisión.
Los radioastrónomos han procurado arduamente encontrar signos de los túneles a través de los que se mueven los electrones, y hay galaxias que muestran estas débiles conexiones de radio del núcleo con las nubes más externas. Algunos de estos túneles brillan incluso con luz ordinaria. Las fotografías de la galaxia elíptica gigante Messier 87 muestran una estrecha y burbujeante franja que se extiende desde su centro; y el famoso quásar 3C 273 posee un «chorro» aún mayor que se extiende sobre unos 200.000 años luz.
Una vez más, necesitamos un núcleo potente. La energía de las radiogalaxias procede del núcleo, y aquí es donde la mayor parte de la masa de un millón de estrellas debe transformarse en energía antes de transmitirse hacia afuera en forma de electrones rápidos. Muchas radiogalaxias han experimentado más de una explosión. Además de las gigantes nubes exteriores de la galaxia, hay otro par más pequeño próximo a ella. El haz parece apagarse durante un monumento; y, cuando se ilumina nuevamente, comienza a salir del túnel a través del gas de los alrededores. Empleando simultáneamente radiotelescopios en distintos continentes, lo que logra el efecto de un telescopio muy poderoso, los radioastrónomos han explorado los detalles de estas pequeñas radionubes nuevas; y, realmente, las han visto extenderse desde el centro hacia afuera algunos años luz. Sea como fuere, la energía que produce es tan concentrada como la fuente energética de los quásares. Y, algo más sorprendente aún, este segundo par de radionubes suele estar alineado exactamente con el par más exterior original. De alguna forma el haz «recordó» su dirección exacta cuando se encendió de nuevo.
§. ¿Centrales de energía en los quásares?
Todos estos resultados pueden aunarse si suponemos que, acechando en el centro de cada radiogalaxia y cada quásar, hay un masivo agujero negro unos mil millones de veces más pesado que el Sol, aunque de diámetro más pequeño que el sistema solar. (Para ser exactos, ésta no es la única explicación posible, pero sí la que mejor se ajusta a los hechos.) Cuando las estrellas se sitúan en órbita próximas al centro de una de estas galaxias, se acercan al agujero negro y llegan a desintegrarse. Esto tur se debe a que el agujero negro «las absorba» de alguna forma; como vimos en el capítulo 9, pues la atracción gravitatoria de un agujero negro a distancia es semejante a la de otro cuerpo masivo. Las estrellas pueden colisionar unas con otras en el denso cúmulo de estrellas que forma el centro de la Galaxia, y se romperán vertiendo chorros internos de gas caliente. Las estrellas que pasen demasiado cerca del agujero negro se estirarán a causa de las mareas tal como la atracción de la Luna distorsiona ligeramente a la Tierra hasta alcanzar el punto de ruptura y desgarrarse, todo el gas procedente de estrellas desintegradas forma una espiral dirigida al agujero negro, y se forma un gigantesco disco de gas caliente en rotación en torno al mismo. La radiación de este agostado disco caliente puede, en verdad, desgarrar las capas más externas de estrellas gigantes que estén demasiado cerca, y este despojo se unirá al disco gaseoso que rodea al agujero negro.
El gas en espiral que ingresa en un agujero negro produce cantidades copiosas de energía, como ya hemos visto. Un agujero negro codicioso puede generar la energía de quásares y radiogalaxias de la forma más eficaz conocida, y el pequeño tamaño del disco que produce la energía concuerda con los diminutos núcleos del quásar y de la radiogalaxia. Los cálculos muestran que un agujero negro semejante tendría que engullir el gas equivalente al de una estrella como el Sol, por año, para mantener la potencia de salida; y esto resulta bastante razonable para un agujero negro que se encuentre en el centro de una galaxia gigante. Los astrónomos discuten aún cómo esta energía de salida se convierte en luz, pero es fácil explicar que el «parpadeo» de los quásares se debe, simplemente, a las cantidades variables de gas en el disco de captura espiral.
El disco en rotación magnetizado también podría actuar como un generador, acelerando los electrones a velocidades próximas a la de la luz, y arrojándolos en dirección perpendicular por encima y por debajo del eje de rotación. Esto podría ser el origen del doble haz, que transporta la energía de las nubes emisoras de una radiogalaxia. Así se explica, por cierto, la «memoria» direccional, ya que el eje de rotación es prácticamente lo único que en astronomía suele señala)' la misma dirección. Si el disco se extingue gradualmente por falta de gas, los haces de electrones se interrumpen; pero tan pronto como fuentes de gas nuevo crean otro disco, los nuevos haces deben seguir las mismas trayectorias que antes.
Nuestra Galaxia contiene un microquásar, posiblemente una región activa en torno a un agujero negro de cinco millones de soles; los quásares y las radiogalaxias pueden albergar agujeros negros mil veces más pesados en sus núcleos. Los astrofísicos llegan a explicar aproximadamente por qué núcleos galácticos activos desde nuestro microquásar, pasando por los miniquásares centrales de las Galaxias de Seyfert, hasta las radiogalaxias y los propios quásares- pueden originarse a partir de las cantidades variables del gas que describe espirales hacia el interior de grandes agujeros negros. Aún es necesario investigar los detalles, pero entre los astrónomos existe la impresión de que al menos se ha encontrado una buena explicación para la violencia en los centros de las galaxias.
Con el fin de procurar comprobar esta imagen, ¿podríamos contemplar estos agujeros negros de modo más directo? Por definición, no podemos realmente ver un agujero negro; pero su atracción gravitatoria puede afectar suficientemente el movimiento de las estrellas en una vasta región en torno a él. Siguiendo esta idea, en 1977 un equipo de astrónomos de California estudió exhaustivamente la galaxia gigante elíptica próxima M87. Emplearon los últimos dispositivos de imagen electrónicos en grandes telescopios y contemplaron en detalle su centro. Allí, las estrellas estaban en verdad más agrupadas de lo que debieran, como si un objeto masivo central las atrajese; las mismas se movían más deprisa que lo esperado. Una vez más, con el propósito de mantener estas estrellas ele alta velocidad en sus órbitas, debería existir una fuerte atracción gravitatoria. Cuidadosas mediciones mostraron que tanto las agrupaciones como las altas velocidades indicaban la existencia de un cuerpo invisible central que contenía más materia que varios miles de millones de soles, y, ciertamente, de menor extensión que unos cuantos cientos de años luz. El único objeto adecuado, al respecto, es un agujero negro masivo. Y seguramente no es coincidencia que la M87 sea una radiogalaxia cuyo túnel de electrones se manifieste como el lamoso «chorro» óptico.
Hace cuarenta años, los astrónomos consideraban a las galaxias como plácidas ruedas de Santa Catalina y bolas de estrellas que giraban pacíficamente en las profundidades del espacio. Nuestra imagen moderna es bastante diferente, ya que las galaxias ocultan secretos que sólo los métodos de investigación más avanzados pueden descubrir. Los problemas más relevantes que ahora exigen solución son los de por qué la mayor parte de la materia de las galaxias es realmente invisible, y qué alimenta a los quásares. Los astrónomos afrontan la tarea ele descubrir en qué consiste la «masa desaparecida» de los halos y cúmulos de galaxias, así como la de explicar los desconcertantes resultados de forma diferente. Y aunque un masivo agujero negro parece la mejor explicación para la energía de los núcleos activos, válida a escala de quásares, debería existir una respuesta mejor. Sea como fuere, resulta indudable que sería incluso más extraña que los agujeros negros.
Por último, los astrónomos nada pueden afirmar todavía acerca del modo en que se formaron las galaxias en un principio. Más arriba hemos trazado un cuadro general de nuestra propia Galaxia, pero ni siquiera a esta altura se puede afirmar certeza alguna en cuanto a los detalles. Hemos alcanzado la etapa en que las emisoras visibles y de radio que contienen las galaxias sus estrellas y sus nubes de gas- sucumben a la exhaustiva investigación de las técnicas modernas, pero según una escala más amplia, las galaxias aún ocultan secretos. De cualquier manera, la investigación del mundo de las galaxias es una de las que más avanza de toda la astronomía. Hace diez años no se podría haber escrito la mitad de este capítulo, y algunos astrónomos se mostrarían cautos si tuviesen que anunciar qué podremos conseguir en los diez siguientes.
Capítulo 11
Comienzo y fin del tiempo
Todo es relativo. Si cada galaxia se aleja de las demás, ¿dónde se halla el «centro» del Universo? Quizás el propio tiempo comenzó con el «Big Bang». ¿Existiría ya el tiempo antes que el Universo?

Estos chorros de lava originaron en 1963 la nueva isla volcánica de Surtsey, próxima a Islandia. El Universo cambia continuamente; el paso del tiempo es irresistible. Es posible que el propio tiempo haya tenido un comienzo y pueda tener un fin.
§. El misterioso cielo oscuro
§. El Universo en expansión
§. Susurros desde el nacimiento del Universo
§. Muerte de la teoría del estado estable
§. El «Big Bang»
§. La primera centésima de segundo después
§. El fin del tiempo
La cosmología es una ciencia que comenzó cuando un primer hombre miró hacia los cielos y se preguntó: «¿Cuál es el origen de todo esto?» Según muchos antiguos mitos, la Tierra y el Cielo provienen del caos, y hasta años recientes aquéllos y el dogma religioso fueron nuestras únicas referencias del nacimiento del Universo. Por ejemplo, en el siglo XVII el obispo Ussher, de Arntagh, calculó la fecha exacta de la creación sumando las edades de los patriarcas bíblicos, y concluyó en que el primer día comenzó en el año 4004 aC.
Los científicos han sido más prudentes en el intento de establecer la edad del Universo. Hasta bien entrado este siglo, los geólogos aportaron evidencias sólidas, ya que las gruesas capas de rocas sedimentarias depositadas a velocidades microscópicamente lentas necesitaron, al menos, unos cientos de millones de años para su asentamiento.
Como va se ha visto, la dotación radiactiva de las rocas de la fierra, de la lama v de los meteoritos ha ayudado a establecer ron bastante precisión la formación de nuestro sistema en 4.600 millones de años. Obviamente, el Universo debe de ser aún más antiguo.

Una perspectiva medieval del Universo. Los cielos son una gran cúpula cuyos movimientos están controlados por algún mecanismo exterior. Este grabado en madera, aunque representa ideas antiguas, data del siglo XIX.
Sin embargo, en los últimos veinte años los astrónomos han acumulado una sorprendente cantidad de datos que indican no sólo cuándo sino también cómo se originó el Universo. Mediante estudios de los cúmulos de estrellas, los elementos del espacio, los movimientos de galaxias distantes y los débiles «ruidos» de radio procedentes de las profundidades del Universo, los cosmólogos de hoy descubren que emerge una imagen sorprendentemente simple y consistente. Estas observaciones nos permiten calcular, asimismo, el futuro del Universo. Estudiar el principio y el fin del Universo —así como los del espacio y del tiempo en una concepción moderna no es ya competencia de teólogos y filósofos. Los cosmólogos son ahora científicos que cuentan con hechos firmes sobre los que trabajar, y con teoría* comprobables mediante la observación y que pueden ser confirmadas desde distintos puntos de vista por científicos que trabajan en otros campos de investigación paralelos.
§. El misterioso cielo oscuro
Hay una observación cosmológica muy importante que todos hemos efectuado desde la infancia: el cielo nocturno (entre las estrellas) es negro. Algo que no parece muy trascendente. Verdaderamente, puede resultar obvio que el cielo sea oscuro por la noche; pero, ¿es correcta nuestra intuición?
El astrónomo inglés Edmund Halley 1656-1742), al parecer, fue el primero en ponderar la oscuridad del cielo, aunque el efecto es generalmente denominado paradoja de Olbers, acorde con el nombre de otro buscador de cometas, el alemán Heinrich Olbers (1758-1840). Supongamos que el Universo es infinito: se extiende desde siempre y para siempre y está colmado de estrellas. Dondequiera que miremos, hacia el cielo, encontraremos una estrella. Podemos ver entre las estrellas próximas, ya que sus tamaños son pequeños comparados con la distancia entre ellas; pero en cualquier dirección que miremos a través de un Universo infinito— deberemos encontrar una estrella. Así pues, cada punto del cielo que brilla sobre nosotros debería hallarse a la temperatura de la superficie de una estrella, una temperatura de miles de grados.
Puede argüirse que las estrellas más distantes tendrían que ser más débiles. Pero como hay muchas, ambos efectos se cancelan con exactitud; tampoco tienen efecto las agrupaciones de galaxias, ya que las galaxias se extienden indefinidamente en el espacio. La oscuridad del cielo es prueba de que nuestro Universo no está sólo hecho de galaxias que se extienden por el espacio infinito, situadas allí desde tiempo inmemorial.
Obviamente, podemos evitar el dilema sosteniendo que la región de las galaxias tiene un límite más allá del cual no hay nada. Pero existen otras dos posibles soluciones. Si recordamos que la luz se desplaza a velocidad finita, entonces mirar cada vez más allá en el espacio supondría asimismo retroceder en el tiempo. La luz por la que vemos la Galaxia de Andrómeda fue emitida hace dos millones de tinos; y la luz y las radioondas que recogemos de la perturbada Galaxia Cygnus A comenzaron su viaje hace 700 millones de años. Si todas las galaxias comenzaron a existir en un determinado momento del ¡rasado, debe de haber una cierta distancia correspondiente a ese tiempo, y cualquier cosa que proceda de más allá de esta distancia datará de un tiempo anterior a la existencia de cualquier galaxia.
Tal como hemos visto en el último capítulo, los astrónomos piensan ahora que las galaxias nacieron hace unos 15.000 millones de años. Cualquier elemento del Universo que se encuentre más allá de 15.000 millones de años luz nos indicará lo que había antes de la formación de las galaxias. La dificultad consiste en que antes de esto, el gas que colmaba el Universo estaba tan caliente como la superficie de las estrellas, de modo que este camino no nos es válido para superar la paradoja de Olbers.
El cielo nocturno sería oscuro si el Universo estuviera en expansión. Entonces, por efecto Doppler, se modificaría la longitud de onda de la luz de las distantes galaxias que se alejan. Todas las longitudes de onda se habrían alargado, convirtiendo la luz inicialmente visible de las estrellas en ondas del infrarrojo lejano o de radio, y, por consiguiente, las estrellas de las galaxias dejarían de ser visibles. En efecto, las estrellas más distantes serían negras. Por cierto, si pensamos en un fotón individual de luz procedente de una galaxia distante, este aumento de longitud de onda implica una disminución de energía, de manera que la energía total que recojamos de una galaxia distante, incluyendo todas las longitudes de onda, también decrece.
Los astrónomos saben actualmente que el Universo está en expansión. Aun cuando las galaxias y sus componentes sigan siendo de igual tamaño, y los cúmulos de galaxias permanezcan unidos por sus atracciones gravitatorias, cada cúmulo se aleja de los demás. Observar los detalles de esta expansión supone una forma aburrida de [rasar el tiempo, pero lo fascinante consiste en que la posibilidad de un Universo en expansión se preelijo hace siglos a partir cicla oscuridad del cielo nocturno. El cosmólogo Dennis Sciama, de Oxford, considera que ésta es la mayor oportunidad perdida de la historia de la cosmología.
§. El Universo en expansión
Muchos astrónomos considerarían la expansión del Universo como lo más importante que sabemos de él; pero el hombre que descubrió el singular movimiento de las galaxias no alcanzó la fama astronómica. Edwin Hubble (1889-1953) empezó su carrera como abogado en Louisville, Kentucky. Pero a los 25 años, según sus propias palabras, «abandoné las leyes por la astronomía, y supe que aun cuando me convirtiese en un astrónomo de segunda o tercera categoría, la astronomía era lo que me interesaba». Hubble no sólo no fue un astrónomo de segunda clase, sino que provisto del por entonces más grande telescopio del mundo, el reflector de 100 pulgadas de Monte Wilson, se convirtió en el principal astrónomo extragaláctico de su generación.
Su mayor descubrimiento fue consecuencia de una serie de largas y dificultosas observaciones realizadas por su ayudante Milton Humason (el propio Humason llegó a la astronomía a través de un camino poco corriente, pues inicialmente era conserje del observatorio de Monte Wilson). Investigaron ambos los movimientos de las galaxias a partir de la observación de los corrimientos Doppler de sus líneas espectrales, que muestran la rapidez con que las galaxias se acercan o se alejan de nosotros. Incluso con un gran telescopio esta tarea no resulta fácil, ya que la luz de una galaxia proviene de una extensa zona borrosa del cielo; y constituye un problema el que llegue luz suficiente para exponer una placa fotográfica, especialmente cuando la luz disponible se extiende por todo el espectro. Para obtener un espectro de una de las más distantes v débiles galaxias, Humason expuso la misma placa durante cinco noches sucesivas con el fin de obtener una exposición total de 15 horas. Allan Sandage, uno de los alumnos de Hubble y hoy importante astrónomo americano, señaló que con un dispositivo electrónico moderno adaptado al telescopio se puede obtener ahora un buen espectro en apenas diez minutos.
Desde hace pocos años, los astrónomos saben que la mayoría de las galaxias se alejan de la nuestra, de la Vía Láctea (excepción hecha de la Galaxia de Andrómeda, que parece acercarse a nosotros; aunque ahora sabemos que esto se debe principalmente a que la órbita del Sol alrededor del centro de nuestra Galaxia nos lleva, en la actualidad, rápidamente en la dirección de Andrómeda).

El Universo se expande en el sentido de que el espacio entre cada cúmulo de galaxias se dilata. Como resultado, un cúmulo más distante retrocede más deprisa que uno próximo

Esta expansión no significa que nuestra Galaxia de la Vía Láctea esté en el «centro» del Universo; el efecto sería el mismo desde una galaxia de otro cúmulo (derecha).
Hubble descubrió que la velocidad de alejamiento de una galaxia depende de su distancia, y que la velocidad aumenta con la distancia tal como observamos en galaxias cada vez más remotas. Si una galaxia se halla a doble distancia que otra, se alejará al doble de velocidad.
Esta regla tan simple que gobierna el movimiento de las galaxias- se conoce ahora como «Lev de Hubble». En la actualidad pueden medirse espectros de galaxias que se encuentran cincuenta veces más alejadas que la galaxia más distante de Humason. La galaxia más lejana que los astrónomos de hoy día conocen se aleja a aproximadamente la mitad de la velocidad de la luz, y los todavía mas distantes quásares viajan incluso más rápidamente.
Podemos apelar a una analogía si consideramos un avión. Supongamos dos aviones que despegan desde Nueva York hacia Londres, el primero a 500 kilómetros por hora, y el segundo a 1.000 kilómetros por hora. En una hora, el primero estará 500 kilómetros más cerca de Londres (o más lejos de Nueva York), mientras que el segundo estará el doble de lejos de Nueva York o dos veces más cercano a Londres. Conociendo sus posiciones y velocidades relativas, podemos calcular la hora de despegue. E igualmente sucede a escala cósmica.
En el pasado, todas las galaxias deben de haber estado extremadamente próximas entre sí, separándose a distintas distancias a causa de sus diferentes velocidades. Pero si se desea calcular el tiempo del «despegue» celeste es preciso conocer tanto las distancias entre galaxias como sus velocidades: tal era el problema de Hubble. Sabía cuáles eran las distancias relativas entre ellas, sencillamente porque las más alejadas parecen más débiles. Pero la distancia a que se hallan constituye un interrogante no contestado todavía con exactitud.
La mejor estimación de Hubble de las distancias entre las galaxias sitúa el momento del «despegue» hace 2.000 millones de años. Con anterioridad a esta época debían haberse hallado tan estrechamente agrupadas que no habrían podido ser reconocidas como galaxias. Esto debe de haber ocurrido, en verdad, antes del momento de la formación de las galaxias. Pero incluso cuando Hubble hizo esta estimación, las primeras medidas radiactivas de la Edad de la Tierra mostraron que tenía aproximadamente 3.000 millones de años, y era improbable que la Tierra fuese más antigua que las galaxias.
Sin embargo, los astrónomos continuaron trabajando desde entonces con el propósito de mejorar las mediciones de las distancias, y poco a poco descubrieron que las galaxias están considerablemente más alejadas de lo que pensó Hubble. No obstante, queda todavía alguna incertidumbre. Muchos astrónomos estiman un aumento de cinco veces en las distancias de Hubble, mientras que su mejor alumno, Allan Sandage, piensa que un aumento de unas diez veces resultaría más exacto. Por cierto, las galaxias son mucho más remotas que lo que indicaban los primeros trabajos. Así pues, su despegue debió de haber sucedido cinco o diez veces antes; consideraremos 15.000 millones de años como un patrón conveniente. Esto convertiría a las galaxias en más antiguas que la Tierra, lo que concuerda con la edad de nuestra Galaxia, calculada por los astrónomos a partir de los viejos cúmulos de estrellas (capítulo 10).
Otra estimación de la edad de nuestra Galaxia proviene de un tipo de datación radiactiva de algunos de los elementos pesados formados en una supernova (método designado con el difícil nombre de núcleo-cosmos-cronología). Tan pronto como se formó nuestra Galaxia, las estrellas pesadas empezaron a explotar cual supernovas, expulsando al espacio elementos pesados inestables. Tras examinar en la actualidad las cantidades de los diferentes isótopos de elementos tales como el renio, los astrofísicos calculan que la primera supernova de nuestra Galaxia apareció hace de diez a veinte mil millones de años.
Los astrónomos confían ahora en que la «edad del Universo» oscila entre estos límites, y la cifra de 15.000 millones de años no debe de estar muy alejada de la realidad. Lo que sucedió entonces se estudiará algo más adelante, ya que hay algo en la ley de Hubble que exige todavía nuestra atención. Si se parte del hecho de que todas las galaxias se alejan, puede parecer que nuestra Galaxia debe de ser el centro del Universo, lo que, por cierto, supondría una singular coincidencia.
La explicación de ello reside en otro resultado de la sencilla ley de Hubble. Supongamos que viviéramos en otra galaxia distante, una de las que los astrónomos terrestres ven alejarse a 1.000 kilómetros por segundo; por ejemplo, la galaxia elíptica gigante M87. Pensaríamos entonces que nuestra galaxia M87 está en reposo, y la Vía Láctea, respecto a nosotros, parecería escapar a 1.000 kilómetros por segundo en dirección contraria; realmente, si calculáramos el movimiento de las demás galaxias del Universo desde nuestro nuevo hogar en M87, comprobaríamos que la ley de Hubble se cumple también allí. Aun cuando en relación con nosotros las velocidades de todas las galaxias son ahora diferentes, al medirlas desde M87 sus distancias también cambian; cuando las medimos desde allí, ambos efectos se cancelan. Las velocidades galácticas aumentan con la distancia para el astrónomo de M87 exactamente del mismo modo que para el de la Vía Láctea.
En la analogía del avión, podríamos imaginarnos viajando en el más lento, a 500 kilómetros por hora. Pero nuestra velocidad es sólo relativa: supongamos que está oscuro y no podemos ver la tierra. Si nos imaginamos que seguimos en reposo, entonces el avión más rápido se alejará a 500 kilómetros por hora y Nueva York lo hará en dirección opuesta a la misma velocidad. En el Universo, todo movimiento es relativo. «Nueva York» es únicamente otro «avión».
Los astrónomos se felicitan que la Vía Láctea no ocupe sitial privilegiado en el Universo. Ya desde que Copérnico destronó a la tierra del centro del Universo, y mostró que era simplemente un planeta en órbita alrededor del Sol, los científicos han sido cautos a la hora de atribuirle un lugar especial. Desde la época de Copérnico hemos descubierto que el Sol es solamente una estrella media que gira a dos tercios del centro de una galaxia media. Y ahora, al parecer, la posición de nuestra Galaxia en el Universo no es nada infrecuente.
Dicho de otro modo, podemos afirmar que si nuestra posición en el Universo es típica, entonces la perspectiva desde cualquier otra galaxia debe de ser la misma. Obviamente, pueden existir distintas clases de galaxias en las proximidades, pero una vez que miremos más allá ciclas galaxias y los cúmulos de galaxias más cercanos, las diferentes partes del Universo nos parecerían muy similares a los que dicta nuestra perspectiva desde la Vía Láctea. En las épocas en que los cosmólogos contaban con muy pocos hechos y muchas teorías, esta idea constituyó una pauta muy importante, y se conservó como el denominado principio cosmológico. Los últimos resultados contradicen este principio, todavía muy importante para los teóricos que trabajan sobre cálculos detallados que consideran el Universo como un todo.
Los cosmólogos modernos entienden el Universo como un inmenso ruedo en el que todas las galaxias se separan unas de otras, de forma que cualquiera de ellas puede considerarse a sí misma el centro del Universo. Pero puede pensarse que debe de haber un «centro real», el punto en el que tuvo lugar la explosión original (o despegue: que dispersó a las galaxias.
Da la casualidad de que no existe tal centro. Nuestro trato con el Universo implica que trabajamos a la mayor escala posible de todo lo conocido, por lo que debemos procurar dejar de lado el sentido común, tal como hicimos cuando exploramos lo sumamente pequeño en el capítulo 6. Aquí debemos fiarnos de teorías matemáticas, que pueden parecer extrañas en un principio, pero que concuerdan, aun en contra del sentido común, con los experimentos y las observaciones. Para lo de mayor dimensión, los cosmólogos apelan a la teoría general de la relatividad de Einstein, que trata de la gravitación, el espacio y el tiempo.
Si aplicamos la teoría, verificamos que el Universo no sólo comenzó con una explosión en un punto del espacio, un «estallido de metralla» que expulsó a las galaxias; la teoría nos dice que el propio espacio se expande y transporta los cúmulos de galaxias consigo, tal como sucede con las barcas en una corriente rajada. Dentro de una galaxia, la atracción gravitatoria de las estrellas mantiene a éstas unidas* como una unidad simple, mientras que los cúmulos concentrados de galaxias producen asimismo una fuerza gravitatoria localizada que les mantiene unidos. Pero los cúmulos vecinos ejercen una fuerza gravitatoria menor sobre los demás. El espacio vacío entre ellos se expande de continuo, y los cúmulos se alejan irremediablemente. La idea de espacio vacío «en expansión» ¡Hiede parecer confusa; pero en la teoría ele Einstein el espacio tiene una existencia real, y la expansión del espacio debe ser entendida totalmente en serio.
Podríamos efectuar una analogía con un pastel de (rutas en el horno; cuando éste crece, las pasas se separan unas de otras, no a causa de una explosión, sino porque el pastel se hincha. Si donde reza «pasas» leemos «cúmulos de galaxias», y si sustituimos «pastel» por «espacio vacío», podremos darnos cierta idea de lo que ocurre en el Universo en expansión.
Pero puesto que los pasteles de frutas poseen bordes y los astrónomos piensan que el Universo carece de límites, la analogía no es exacta. La teoría muestra que son posibles dos tipos de Universo. En uno, los cúmulos de galaxias siguen su camino para siempre. El Universo es infinito, pero no lo vemos todo, ya que no es infinitamente viejo. Como hemos descubierto en la paradoja de Olbers, sólo podemos ver hasta 15.000 millones de años luz, ya que a esa distancia retrocedemos hacia el comienzo del Universo. Es lo que se llama un Universo «abierto».
Un Universo cerrado es aún más extraño. Si partimos en línea recta desde la Vía Láctea y viajamos durante mucho tiempo, nos hallaremos finalmente aproximándonos otra vez a la Vía Láctea, ¡por el otro lado! El espacio se ha curvado en torno a sí mismo. Supone algo semejante a viajar alrededor de la Tierra; se sale en una dirección y se encuentra uno volviendo al punto de partida desde la opuesta. Esta analogía es fácil de entender, a menos que creamos que la Tierra es plana. De igual modo, cuando el hombre empezó a comprender que la Tierra era redonda debió haber sido un tanto duro imaginar que la gravedad hace parecer todo boca arriba, y que los chinos no caminan boca abajo. La dificultad reside en que la curvatura del Universo está en una cuarta dimensión, y no la podemos visualizar. No podríamos ver todo el camino en torno a un Universo semejante, ya que el «viaje en redondo» total (recordemos que es en línea recta desde nuestra Galaxia hasta nuestra Galaxia) es más largo que 15.000 millones de años luz. Podremos ver nuevamente tan lejos como 15.000 millones de años luz en cualquier dirección, pero a esta distancia habremos retornado al comienzo del Universo.
Quedémonos de momento con el Universo abierto, ligeramente más fácil de comprender. Podemos entender ahora por qué el interrogante menos agradable ¡rara un astrónomo es el que le exige responder por cuál es el tamaño del Universo. Ello porque muy bien puede ser infinito, pero no podemos percibirlo en su extensión; y las razones dadas con anterioridad no son de las que se pueden explicar en dos minutos con palabras sencillas.
Cuando los astrónomos afirman que el Universo se expande, realmente quieren dar a entender que las distancias entre los cúmulos de galaxias se acrecientan. (Los arquitectos, los urbanistas y otros artistas por el estilo, por ejemplo, también son conscientes de que el espacio entre los objetos tiene tanta relevancia como los propios objetos.) Para nosotros, lo importante consiste en intentar comprender que el Universo, es decir el espacio, siempre ha sido infinito: hace 7.500 millones de años, los cúmulos de galaxias se hallaban separados en la mitad de la distancia actual, pero la mitad de infinito es, asimismo, infinito. (Esto es ligeramente diferente para un Universo cerrado, pero es incluso aún más complicado.)
Hay dos maneras de hablar de la historia del Universo. Los teóricos se ¡Nacen en pensar en una masa informe de gas que comenzó donde se encuentra ahora nuestra Galaxia, y que continúa su historia hasta nuestros días. Alternativamente, podemos escudriñar el espacio y emplear la velocidad de la luz. Vemos Cygnus A tal como fue hace 700 millones de años, y 3C 273 en el estado que mostraba hace 2.000 millones ele años, es decir 13.000 millones de años después del comienzo del Universo (ya que éste fue el momento en que el espacio empezó a expandirse, arrastrando materia consigo, denominado «Big Bang», aun cuando, según se cree, no se trató de una explosión en el sentido habitual).
Observando los aún más distantes quásares, los astrónomos retroceden nueve décimos en el tiempo. Incluso si se tiene en cuenta la expansión del espacio, hay muchos más quásares a estas distancias que los que existen en la «reciente» región del espacio próxima a la Vía Láctea. Al parecer, los quásares eran mucho más comunes en los orígenes del Universo, y su violencia es un síntoma de juventud. De hecho, muchos astrónomos lo esperaban así, ya que en las angustias iniciales de la vida de una galaxia había gran cantidad de gas alrededor, que podría caer en el centro de un agujero negro y dar lugar a un violento quásar en el corazón de la galaxia.
Más allá de los quásares, y anteriores a ellos en el tiempo, podríamos esperar «ver» galaxias en formación. Los astrónomos no han logrado detectar luz de estas «protogalaxias» tan lejanas, a pesar de sus intensas búsquedas. ¿Qué cabría esperar aún más lejos?
El notable físico ruso-americano George Gamow muy conocido por su personaje «Mr. Tompkins» de sus libros de divulgación científica- dio con la respuesta correcta hace treinta años, cuando la cosmología era casi magia negra para otros científicos. Gamow razonó que, en sus estadios primitivos, el Universo debió haber contenido gas caliente y radiación, y que esta radiación se habría alargado por efecto Doppler— en su viaje de miles de millones de años luz por el espacio en expansión para llegar hasta nosotros; y nos habría llegado como ondas de radio. Ahora bien, dado que los radiotelescopios de la época no eran suficientemente sensibles como ¡tara detectar tales señales provenientes de las profundidades del Universo, la predicción de Gamow se perdió hasta el incidente del «ruido» en las antenas de radio de la estación de seguimiento de satélites de Nueva Jersey.
§. Susurros desde el nacimiento del Universo
Los laboratorios Bell Telephone aparecieron ya en nuestra historia, pues fue uno de sus ingenieros el primero en detectar accidentalmente radioondas desde el espacio en la década de 1930. La antena gigante de la estación de seguimiento de satélites ele Holmdel, Nueva Jersey, fue diseñada con la intención de convertirse en una de las más sensibles del mundo para las longitudes de onda de pocos centímetros. Por esta razón, los radioastrónomos Arno Penzias y Robert Wilson la pidieron «prestada» en 1965 con el propósito de medir el débil ruido de radio procedente de las cercanías de nuestra Galaxia.
A fin de comprobar la antena, comenzaron a trabajar a una longitud de onda en la que no esperaban señales de radio desde la Vía Láctea. Esta antena es un instrumento largo en forma de cuerno, más sensible que los «platos» usados en radioastronomía.
De inmediato tropezaron con un problema: un débil «ruido» residual en la antena, que intentaron eliminar sin lograrlo ni siquiera quitando un nido de palomas existente en el cuerno de la antena.

Un corte del Universo visible. Al mirar desde nuestra Galaxia (centro) hada a fuera en el espacio, miramos hacia alias en el tiempo, ya que la luz no se propaga instantáneamente. Si nos alejáramos lo suficiente, veríamos el Universo en su infancia, cuando las galaxias estaban muy agrupadas y los quásares eran corrientes. A una distancia de 15.000 millones de años luz contemplamos el comienzo del propio Universo, el Big Bang que «vemos» en todas direcciones. (Obsérvese que esto no supone que nos hallemos ni un punto central especial del Universo; podría representarse el misino esquema centrado en cualquier galaxia.) EL segmento ampliado muestra los sucesos inmediatamente posteriores al Big Bang.
Por último, llegaron a la conclusión de que esta radiación procedía del cielo; lo más extraño es que parecía originarse de manera uniforme por todo el cielo. Si poseyéramos «ojos de radio», el fondo del cielo brillaría débil pero uniformemente.

Arriba. En un experimento aéreo realizado en 1977 con un avión U-2 modificado, George F. Smoot (en primer término, a derecha) y sus colaboradores estudiaron el «brillo» del fondo de radio permanente desde el Big Bang. El avión de gran altitud recabó muestras por encima de la molesta radiación de vapor de agua de la atmósfera terrestre.
El astrónomo Robert Dicke, de Princeton, se disponía por entonces a observar un fondo de radio como éste, después de haber realizado cálculos parecidos a los anteriores de Gamow, y rápidamente confirmó que el ciclo no es negro para las longitudes de onda de unos pocos centímetros.

Un primer plano del detector de radiación del U-2 sin cubierta. Los dos grandes conos reciben ondas de radio desde diferentes partes del cielo (una de los conos es visible en la fotografía de arriba, a izquierda de la cabina). La comparación entre intensidades de las seriales mostró que el radiocielo es ligeramente «más brillante» en la dirección de la constelación de Leo.
Sus observaciones, a diferentes longitudes de onda, confirmaron que el cielo brilla, al igual que el «cuerpo negro» de los físicos, a muy bajas temperaturas. Vimos en el capítulo 7 que el cuerpo negro teórico brilla de forma que sólo depende de su temperatura, y que la longitud de onda del pico de emisión se desplaza hacia las longitudes de onda más largas en los cuerpos más fríos. Experimentos posteriores permitieron verificar que el cielo por entero «brilla» como si estuviera a una temperatura de 2,7 °C por encima del cero absoluto, o — 270,5 °C.
La predicción original de Gamow abandonó finalmente el destierro en que se hallaba. No hay modo de explicar' esta radiación uniforme del cielo a menos que esté allí desde el principio del Universo. Ya anotamos que si observamos en cualquier dirección a una distancia de 15.000 millones de años luz, miramos hacia el nacimiento del Universo. El fondo de radio proviene casi desde esa distancia, incluso desde más allá que los quásares, pues se origina en un estadio anterior a la vida del Universo, antes de que hubieran nacido las galaxias y los quásares. En esta remota época, el Universo estaba colmado de gas caliente y radiación a tina temperatura de unos miles de grados, semejante a la de la superficie de una estrella en la actualidad. Esta radiación mostraba un pico en las longitudes de onda alrededor del visible y el infrarrojo, pero la expansión del Universo alargó las ondas hasta que llega- ion a nosotros como ondas de radio centimétricas. Sin pretenderlo, Penzias y Wilson habían detectado los susurros del Big Bang con el que comenzó nuestro Universo.
§. Muerte de la teoría del estado estable
El descubrimiento del fondo de radiación supuso la sentencia de muerte de una teoría alternativa del Universo, la del «estado estable». Esta popular teoría, defendida ardientemente por el astrofísico británico Fred Hoyle, constituyó una seria alternativa a la del Big Bang durante la década de 1950 v principios de la de 1960, y resultaba muy atractiva pues no comportaba el trauma de un Big Bang inicial, ni interrogantes tan desconcertantes como procurar averiguar qué sucedió antes del Big Bang. Muchos cosmólogos lamentan que se la haya superado, pues era mucho más elegante que la teoría del Big Bang. Pero esta teoría del estado estable fracasó ante el fondo de radiación: sin un Big Bang tío hay manera de producir un fondo uniformemente brillante de radioondas.
Sin embargo, merece la pena dedicar cierta atención a la teoría que se enfrentó al Big Bang. La teoría del estado estable constituyó uno de los más importantes debates astronómicos del siglo. Cuando se la concibió, en 1948, los astrónomos subestimaban todavía seriamente las distancias de las galaxias, y, tal como hemos visto, esto conducía a que la fierra pareciera más vieja que el Universo. Pero queramos suponer que no hubo origen del Universo. Entonces, además de considerar que el Universo parece el mismo desde dondequiera que estemos, deberemos también advertir que parece el mismo (a mayor escala dondequiera que le observemos. Siempre ha sido el mismo, y siempre lo será. Tal era el «principio cosmológico perfecto», la piedra fundamental de la teoría del estado estable.
Dado que los cúmulos de galaxias se hallan en proceso de separación, el Universo sólo puede mantener la misma apariencia si la materia surge de la nada en el espacio existente entre los cúmulos. Aun cuando Fred Hoyle sustentase esta parte de la teoría con una firme posición teórica, la «creación continua» de materia que la teoría del estado estable exigía se atascó en las gargantas de muchos astrónomos, quienes consideraron que así no se mejoraba la tesis del Big Bang, que aquélla procuraba evitar.
Sin embargo, la creación continua eliminó el problema de la gran edad de la Tierra. Hoyle y sus colegas afirmaban que todas las galaxias que vemos alejarse y que, al parecer, deben de haber coincidido con la nuestra en un Big Bang, llegaron realmente a existir a partir de materia comparativamente reciente creada en el espacio. Jamás la distancia media entre los cúmulos de galaxias fue menor que ahora; ni se acrecentará la separación media con la expansión del Universo, ya que aparecerían nuevos cúmulos entre los antiguos.
Aunque el estado estable era una hermosa teoría, pronto tuvo que enfrentar el problema del número de radiofuentes débiles que las perfeccionadas técnicas de los radioastrónomos habían encontrado en profusión. Puesto que la teoría del estado estable sostiene que el Universo ha sido siempre el mismo, el espacio medio entre las radiogalaxias tendrá que ser aproximadamente el mismo por muy lejos que miremos hacia el exterior del espacio, lo que significa retroceder en el tiempo.

Los restos de la explosión de una estrella la radiofuente Cassiopeia A se muestra aquí en una «fotografía» generada por ordenador, que pone de manifiesto su estructura de radioemisión. La concha de gas en expansión, que contiene materia del núcleo de la supernova, se ve más claramente que en la fotografía óptica de enfrente. Cortesía del Observatorio Radioastronómico de Mullard.
El radioastrónomo Martin Ryle, de Cambridge, descubrió que Babia demasiadas radio- fuentes (distantes) muy débiles comparadas con el brillo de las más cercanas. En otras palabras, en el pasado las radiogalaxias debieron haber estado más próximas, o simplemente haber sido más numerosas. El centro de la controversia del Big Bang frente al estado estable ha sido esta cuestión del «número de fuentes» de radio, en la que no ha habido acuerdo entre arribos adversarios, Hoyle y Ryle (quienes, posteriormente, habrían de ser condecorados)
Con todo, la radiación de fondo no admitía réplica, y los defensores del estado estable abandonaron la nave uno tras otro. Algunos, como el propio Hoyle, terminaron en teorías propias que combinan características de ambas; otros aceptaron la teoría del Big Bang.
La controversia no supuso una pérdida de tiempo. Los cosmólogos verificaron que bis observaciones astronómicas habían alcanzado un punto en el que se podía comprobar ambas teorías para luego proceder a una elección real. Además, Hoyle y sus colaboradores habían realizado el primer estudio serio acerca de cómo se podrían formar elementos pesados a partir del hidrógeno de las estrellas. Los primeros cosmólogos del Big Bang, Gamow incluido, habían supuesto que los diferentes elementos se formaban en las condiciones muy especiales del Big Bang; el creador de la teoría del estado estable encontró otra alternativa. La materia que se creaba de continuo tenía que ser el elemento más simple, el hidrógeno, y los demás elementos debían formarse en las estrellas y esparcirse por el espacio en explosiones de supernova. Hoyle, más los astrónomos Geoffrey y Margaret Burbidge y el físico nuclear William Fowler, mostraron cómo se podían producir los elementos pesados en el interior de las estrellas mediante procesos que los físicos nucleares habían elucidado a partir de experimentos realizados en la tierra.

En este negativo de Cassiopeia .4, las trazas de gas coloreado tienen un exceso de elementos «pesados», como el oxígeno, que se originan) en las reacciones nucleares del núcleo de la estrella original. La ahora desacreditada teoría del estado estable del l adverso condujo a los primeros cálculos de la producción de elementos en las estrellas: según la actual teoría del Big Bang, todos los elementas, a excepción del hidrógeno y el helio, se han producido en las estrellas. Cortesía de Sidney van den Bergh. (Copyright del Instituto de Tecnología de California y la Institución Carnegie de Washington. Reproducido con permiso de los Observatorios Hale.)
Acordes con esta iniciativa, los astrónomos llegaron a la conclusión de que todos los elementos pesados se producen en las estrellas.
Existe, sin embargo, un problema importante: el segundo elemento más ligero, el helio, es también muy abundante en el Universo. Es imposible que se produzca en tanta cantidad en las estrellas, cuando virtualmente cualquier teoría que incluya un Big Bang produce casi exactamente esa cantidad de helio en el propio Big Bang. Los astrónomos piensan ahora que el hidrógeno, y casi todo el helio del Universo, son residuos del Big Bang, mientras que los elementos más pesados se han formado en las estrellas. Los cálculos de Hoyle sobre la «construcción» de elementos pesados en las estrellas se han mantenido a lo largo del tiempo, aunque la propia teoría del estado estable haya caído aparentemente en el olvido.
§. El Big Bang
La evidencia de un Big Bang resulta actualmente aplastante. Con los datos disponibles de la Edad del Universo, la abundancia de helio y la temperatura del fondo de radiación, los cosmólogos pueden retroceder en el tiempo hasta el momento del propio Big Bang. Antes de que las galaxias se formaran, el Universo estaba colmado por un «gas» más o menos uniforme de partículas y radiación; a partir de aquí la física puede desarrollarse bastante sencillamente.
El momento real del propio Big Bang, el tiempo exactamente igual a cero, está envuelto en el misterio. (Hablaremos en lo que sigue sólo en términos de un Universo abierto, aun cuando los resultados esenciales son semejantes para un Universo cerrado.) Aunque el Universo es siempre infinito en tamaño, al retroceder en el tiempo la mayor parte de la materia queda agrupada en un determinado volumen (digamos el volumen de una caja de cerillas), y lo más caliente es la radiación que lo rodea. Podemos ver instintivamente y Stephen Hawking y otros lo han demostrado así que en el instante del Big Bang había literalmente una cantidad infinita de materia concentrada en el volumen de una caja de cerillas; y ('I fondo de radiación debe de haber tenido una temperatura infinitamente alta.
¿Ocurrió esto, realmente, en nuestro Universo? Nadie lo sabe. Los cálculos de Hawking se basan en la teoría gravitacional de Einstein, que describe la gravitación de una forma más llana. Para los campos gravitatorios que hoy día encontramos en el Universo es una teoría excelente. Sin embargo, teóricos como Hawking suelen tener presente que la teoría cuántica insiste en que la gravedad se transmite por partículas virtuales, los gravitones. Cuando la materia se comprime fuertemente, los campos gravitatorios llegan a ser tan intensos que las ecuaciones de Einstein no son válidas, y los físicos tienen que pensar en términos de gravitones. Desgraciadamente, los teóricos no han encontrado aún una adecuada teoría cuántica de la gravedad, a pesar de décadas de dedicación; y. así, los físicos hesitan en cuanto a la densidad de |a materia extremadamente densa. Ya tratamos este problema en el capítulo 9, en la controversia sobre las «singularidades» en el centro de los agujeros negros. Hasta que no pueda disponerse de una teoría mejor acerca de la gravitación a altas densidades, los cosmólogos nada pueden afirmar respecto a si el Big Bang comenzó realmente con una densidad infinita y una temperatura infinitamente alta.
Sin esta perfeccionada teoría no podemos retroceder en verdad al propio Big Bang, al «tiempo igual a cero». ¡Pero podemos conseguir vislumbrar lo que ocurrió únicamente un 1/10.000.000.000.000.000.000.000.000.000.000.000.000.000.000 de segundo después del Big Bang! La temperatura y la densidad eran inimaginablemente altas, pero no infinitas. Los teóricos pueden calcular ambas cantidades y escribirlas de forma precisa con gran cantidad de cifras: una temperatura de 100.000.000.000.000.000.000.000.000.000.000 °C y una densidad de 1.000.000.000.000.000.000.000.000.000.000.000.000.000.000.000.000.000.000.000.000.000.000.000.000.000.000.000.000.000.000 de veces la densidad del agua. Los cosmólogos pueden calcular cómo se enfrió el Universo y cómo disminuyó la densidad cuando el espacio se expandió progresivamente a partir de ese momento.
Sin embargo, no existe certeza acerca de la clase de partículas que colmaban por entonces el Universo. Nuestras teorías actuales de las diferentes partículas, y de sus interacciones, se han comprobado únicamente para un cierto rango de densidades; y recordemos que los astrofísicos tropiezan con dificultades cuando intentan predecir qué sucede en el núcleo muy caliente de una estrella de neutrones, en la que la materia está concentrada a una densidad de «sólo» 1.000 billones de veces la del agua. Lo que ocurre a densidades aún mayores depende en sumo grado de cómo se comportan las partículas fundamentales cuando la cantidad de energía del entorno es extremadamente grande. Los experimentos que se llevan a cabo en los aceleradores de altas energías proporcionarán algunas respuestas.
Con esta concentración de energía en el comienzo del Universo pueden aparecer, repentinamente, pares de partículas y antipartículas sin problemas: la energía de radiación puede surgir a continuación como la cantidad de masa equivalente. Para averiguar qué partículas estaban presentes, los físicos tendrán que aprender más acerca de las partículas fundamentales, es decir los quarks y los leptones. ¿Existe sólo un puñado de cada una, o hay una sucesión completa con masas cada vez mayores? Estos posibles quarks y leptones (con sus antipartículas), muy pesados, demasiado masivos como para ser producidos en la comparativamente insignificante fuente de energía de nuestros aceleradores terrestres, habrían sido casi tan corrientes como los más ligeros en los días del comienzo del Universo.
Además, el papel de las fuerzas es oscuro. Desde el instante que hemos descrito con anterioridad, la gravitación vuelve a su comportamiento habitual según las ecuaciones de Einstein; pero las otras tres fuerzas revelarían sus similitudes básicas si son correctas las actuales teorías de unificación. Antes de que la temperatura descendiera a 3.000 billones de grados, las fuerzas débil y electromagnética se comportarían exactamente de la misma forma, según la teoría de Weinberg-Salam que las relaciona. Cuando el Universo se enfrió, las fuerzas «se congelaron», y la fuerza electromagnética terminó siendo mil veces más intensa que la fuerza débil.
Steven Weinberg compara esta separación con la congelación del agua, en una analogía que no es exacta pero que ilustra las razones teóricas. Podríamos enunciarla como sigue. En la atmósfera, el vapor de agua está esparcido uniformemente, y un vidrio plano dejado al fresco nocturno adquiere una capa uniforme de rocío. Pero si el vidrio está frío, el hielo que se forma sobre él origina bellos remolinos: cuando el vapor de agua se condensa, se forma una figura que antes no existía. De modo similar, las fuerzas débil y electromagnética pudieron haber sido exactamente iguales en el comienzo del Universo, pero «se congelaron» en un «modelo» relativamente simple, en el que una terminó en débil —-fuerza de corto alcance , y la otra, más fuerte, como fuerza de largo alcance.
la fuerza fuerte entre quarks plantea otro problema. En el capítulo 6 vimos que cuando los quarks están próximos, la fuerza fuerte «se desconecta». Al principio del Universo, todos los quarks estaban suficientemente próximos como para que les afectase muy poco la fuerza fuerte.

Pero en alguna etapa la densidad se hizo demasiado baja, y la fuerza fuerte comenzó a agruparlos en partículas más pesadas, en especial protones y neutrones (y antiprotones y antineutrones). De algún modo, esta fuerza resultó tan eficiente que no quedó ningún quark libre. Pese a una falsa alarma en 1977, no han tenido éxito los sensibles experimentos llevados a cabo para intentar separar los quarks.
Los cosmólogos tendrán que esperar los resultados de los aceleradores de partículas, así como las correspondientes afinaciones de la teoría fundamental, antes de poder conocer con precisión qué ocurrió en este remolino del comienzo del Universo. Si mirar a través del espacio supone retroceder en el tiempo, ¿podríamos emplear la distancia como una especie de máquina del tiempo? De alguna manera, esto es cierto. Si pudiéramos detectar el fondo de neutrinos que sobrevivió desde este periodo, así como el probable fondo de gravitones, podríamos aprender bastante acerca de los primeros momentos de nuestro Universo. Para desgracia nuestra, las técnicas actuales no son ni mucho menos suficientemente sensibles; y hasta resulta difícil detectar neutrinos del Sol.
El fondo de radio nos dice muy poco. En su principio, el Universo caliente se hallaba en un estado de equilibrio térmico. La radiación y las partículas estaban tan densamente agrupadas que interaccionaban de continuo, y todo se mantenía, por cierto, a igual temperatura. El todo se asemejaba bastante al «cuerpo negro» que emite radiación según su temperatura, pero en este taso la radiación concentrada controlaba la temperatura de la materia. A causa del equilibrio térmico, quedaron ocultos todos los detalles de lo que ocurrió en los primeros minutos. Steven Weinberg lo señaló acertadamente de esta forma: «Es como si se hubiera preparado un banquete con gran atención: los ingredientes más frescos, las especias elegidas con el mayor de los cuidados, los vinos más finos; y, después, se echaran todos juntos a un gran puchero con el fin de que se cocieran durante unas horas.» El fondo de radiación es una suave amalgama de la exótica física que debió haber habido entonces.
§. La primera centésima de segundo después
Sin embargo, después de la primera centésima de segundo el Universo se enfrió hasta «apenas» unos 100.000 millones de grados, y las teorías actuales pueden decirnos lo que debió ocurrir. Para ese instante, los antiprotones y los antineutrones habían desaparecido del Universo, Las colisiones con protones y neutrones habían originado desde un principio las aniquilaciones mutuas, pero cuando la temperatura y la densidad fueron altas aparecieron espontáneamente nuevos pares. Ahora hace demasiado frío para que esto ocurra, y las partículas de antimateria que quedaron han desaparecido para siempre excepto los positrones, como veremos más adelante.
Pero si todos los protones y antiprotones hubieran estado en igual número de «pares», entonces los protones también deberían haber desaparecido, dejando radiación pura. Todos sabemos que hay protones y neutrones: que forman estrellas, planetas y nuestros propios cuerpos. La razón por la que la Naturaleza pareció preferir la materia a la antimateria constituye todavía uno de los enigmas sin resolver de la cosmología. De hecho, su favoritismo no fue muy notable: en un principio había aproximadamente un protón, extra por cada mil millones de pares protón-antiprotón; pero cuando estos pares fueron aniquilados, los protones desparejados se encargaron de construir nuestro Universo.

El primer reloj atómico de cesio desarrollado en el .National Physical Laboratory, Inglaterra, tenía una precisión de un segundo en cien años. Los modernos relajes de cesio son aún más precisos. Aun cuando el paso del tiempo parece natural e inevitable, algunos físicos creen que el propio tiempo tuvo su comienzo en el Big Bang, hace unos 15.000 millones de años.
El mismo argumento es válido, asimismo, para los neutrones y los antineutrones. Con el tiempo, sin embargo, los neutrones en exceso se desintegraron gradualmente en protones (y en electrones y antineutrinos), ya que el neutrón no es una partícula básicamente estable. Su vida media, de aproximadamente quince minutos, es mucho mayor que la edad del Universo en la época de que estábamos hablando.
En este tiempo inicial, entre la centésima de segundo y unos pocos segundos después del Big Bang, el Universo estaba principalmente lleno de radiación, neutrinos y pares electrón-positrón. La temperatura y la densidad eran aún bastante altas para la aparición, de la noche a la mañana, de estos pares materia-antimateria de muy baja masa. Esparcidos alrededor, y muy poco importantes entonces, había un número relativamente pequeño de protones y neutrones.
Hacia los dos segundos, el Universo se enfrió hasta el punto de que los pares electrón-positrón no pudieron aparecer espontáneamente; se aniquilaron entonces unos a otros, dejando un pequeño residuo de electrones para equilibrar los protones cargados positivamente. La radiación domina el Universo en este momento. Hay del orden de mil millones de fotones electromagnéticos por cada protón, neutrón o electrón; y estas partículas de radiación energética son las que tienen la sartén por el mango al controlar la temperatura del Universo, a medida que se enfría en el siguiente millón de años.
Resulta importante para nosotros saber qué les sucedió a las partículas de materia durante los primeros minutos de esta «era de dominación de la radiación», ya que entonces es cuando protones y neutrones se unen con el fin de formar los núcleos de helio. Se trató de un proceso por etapas: primero se tienen que unir un protón y un neutrón para formar un núcleo de hidrógeno pesado, el deuterio, a los que se deben añadir después otro protón y otro neutrón (en cualquier orden) para formar el núcleo de helio de dos protones y dos neutrones. El deuterio es un núcleo débilmente enlazado, y en el caos de las primeras etapas del Universo se habría desintegrado tan pronto como se hubiera formado. Pero cuando el Universo tiene aproximadamente una edad de tres minutos y medio, el deuterio puede sobrevivir lo suficiente como para capturar partículas extra y convertirse por último en el extremadamente estable núcleo de helio. Entonces, prácticamente todos los neutrones se asocian con protones para acabar como helio. Si se sabe qué fracción de neutrones ha sobrevivido este tiempo, resulta bastante fácil calcular que aproximadamente un cuarto de la materia del Universo se convertiría en helio; y, como hemos visto, ésta es justamente la cantidad de helio que contienen las estrellas más antiguas.
Hay otras dos fechas importantes en la vida del Universo. Siguiendo un largo camino desde los tres minutos y medio hasta que cumple el millón de años, el Universo sólo se ha enfriado a 3.000 °C, es decir que está más frío que la superficie solar. En este momento, los electrones pueden combinarse con los núcleos de los alrededores para formar átomos de hidrógeno y helio sin ser inmediatamente golpeados otra vez por los ahora mucho más débiles fotones. A diferencia del plasma anterior de núcleos y electrones libres, el gas es ahora transparente a la radiación que, aun cuando permanece por los alrededores durante el resto de la historia del Universo, se debilita de continuo y jamás vuelve a tener efecto serio sobre la materia. Cuando miramos hacia el espacio y retrocedemos en el tiempo, nuestros instrumentos de mayor alcance pueden escudriñar hasta el millón de años del Universo. Más lejos (más atrás en el tiempo), el Universo estuvo lleno de gas opaco, o, para mayor exactitud, de plasma. La radiación que lo colmaba cuando tenía un millón de años está esparcida a través del ahora transparente Universo y, a medida que se esparcía, se debilitaba. Este es el débil susurro que se detectó por vez primera en la gran antena de Holmdel, en 1965.
La última fecha importante en esta historia es aquella en la que el gas empezó a agruparse para formar galaxias. Los astrónomos no pueden afirmar cuándo ni cómo ocurrió este importante suceso. Cuando el Universo tenía unos cientos de millones de años, nubes individuales de gas empezaron a colapsarse como protogalaxias, y el gas de su interior comenzó a formar las estrellas. Se sintetizaron los elementos más pesados, las explosiones los lanzaron al espacio y, más tarde, las estrellas pudieron formar sistemas planetarios. Nuestra atención se extiende desde el Universo completo —ahora un conjunto de cúmulos de galaxias en expansión— hasta las propias galaxias y sus contenidos: la astronomía toma posesión de la cosmología.
§. El fin del tiempo
Nuestro Universo en expansión empezó en un Big Bang. Hemos llamado al momento del Big Bang «el comienzo del tiempo»; y hemos cronometrado las diversas contracciones del Universo desde ese instante. Puede pensarse que ésta es una aproximación muy arbitraria. Seguramente debe de haber existido el tiempo antes del Big Bang. Como veremos más adelante, hay cosmólogos que consideran que el Universo «oscila», es decir que se expande v se contrae durante largos ciclos, de modo que nuestro Big Bang constituye únicamente la última vez en que el Universo alcanzó su tamaño mínimo. Con anterioridad a haberse contraído, e incluso antes, le encontraríamos expansionándose desde un Big Bang siempre precedente. El Universo existiría desde tiempo inmemorial, si bien todas las partículas que nos rodean hoy, y tal vez hasta las actuales leyes de la Naturaleza, existen serlo desde el último Big Bang.
Los hay que entienden que este Universo oscilante, sin principio en el tiempo, es filosóficamente confortable. Pero, ¿resulta tan extraño pensar que el tiempo comenzó hace apenas 15.000 millones de años? Después de todo, existe un cero absoluto de temperatura: nunca podemos enfriar nada por debajo de — 273,15 °C. Quizá haya también un límite de tiempo, en 15.000.000.000 aC. Nuestra experiencia cotidiana es contraria a esto: el tiempo es una «corriente siempre en movimiento», algo poderoso le mueve implacablemente desde el pasado infinito hasta el futuro indefinido. A pesar de todo, nuestra experiencia cotidiana no es siempre un índice fiable; así, por ejemplo, el suelo bajo nuestros pies parece sólido, aunque consiste fundamentalmente en espacio vacío entre los electrones y los núcleos de los átomos. Fuera de la escala cotidiana no se puede confiar siempre en el sentido común.
Hoy día, los científicos se acercan al Universo con cautela. Para Newton, el tiempo y el espacio eran absolutos. Einstein nos enseñó que espacio y tiempo podían cambiar por movimientos rápidos y por la atracción gravitatoria de cuerpos masivos. Con el propósito de definir un concepto científico, los científicos hablan en términos de cómo medirlo: si no podemos medir, y ni siquiera detectar algo, nos deslizamos sobre una pátina de hielo al afirmar que ese algo existe. Tal es el caso con el tiempo. Actualmente podemos definirlo en términos de latidos de corazón o del giro de nuestro planeta, o ele modo más fundamental, por las vibraciones de los átomos. Empleamos ya la vibración del átomo de cesio para definir nuestra escala de tiempo, y los laboratorios patrones del mundo entero emplean este tiempo atómico: a medida que la Tierra se retrasa gradualmente, añaden un «sallo de un segundo» a nuestro tiempo civil.
«Antes» del Big Bang no había latidos de corazón, ni planetas que girasen, ni siquiera átomos. Aun en el caso de que nuestro Universo haya tenido otra fase de oscilación, no hay forma de que retrocedamos más allá del Big Bang para ver si existieron átomos idénticos a los nuestros. No hay forma lógica de definir el tiempo antes del Big Bang, y, por consiguiente, no supone ninguna falacia afirmar que el propio tiempo empezó con el Big Bang, junto con el espacio que nuestro Universo ocupa y las partículas de materia que hay en él.
¿Qué hay del fin del Universo? ¿Habrá un fin del tiempo? Los cosmólogos se muestran divididos cuando discuten sobre el futuro lejano del Universo. Aun cuando en la actualidad el mismo se expanda furiosamente, existe una débil fuerza gravitatoria que atrae cada cúmulo de galaxias hacia los otros. El destino del Universo depende de si esta tensión gravitatoria será suficiente para frenar a las apresuradas galaxias, detenerlas v hacerlas retroceder nuevamente en una rápida contracción del Universo. Si los astrónomos supieran con exactitud cuánta materia hay en la actualidad en el Universo, los cosmólogos podrían decidir fácilmente si es suficiente como para detener la expansión, o si las galaxias se alejarán para siempre. Culpable de esta situación es la «masa desaparecida». Si las galaxias que vemos son la única materia del Universo, su atracción gravitatoria es demasiado pequeña para detener la expansión. A pesar de todo, es posible que exista una cantidad de materia invisible oculta en torno a las galaxias y entre ellas, como veremos en el último capítulo. Los astrónomos trabajan con ahínco, siguiendo esta alternativa, con el fin de determinar cuánta materia invisible hay; pero se está lejos de que exista acuerdo general.
Si el Universo se estuviese retrasando en su expansión, entonces, cuando miramos a largas distancias y tiempos anteriores, veríamos a las galaxias allí (y sólo entonces) separándose con mayor rapidez que ahora. El propio Hubble comenzó buscando este efecto, y Allan Sandage lo persiguió hasta los límites de las técnicas actuales. Pero los resultados son decepcionantes, ya que sólo pudo afirmar que el Universo continuará expandiéndose durante al menos otros 50.000 millones de años, y las observaciones no pueden ayudarnos a decidir si entonces empezará a contraerse.
Otros astrónomos han ensayado una plétora de métodos diferentes. La simple extrapolación de la masa desaparecida de los cúmulos de galaxias constituye, a escalas mayores, una aproximación. Otra vía consiste en utilizar el efecto de enfoque de la «curvatura» del espacio en el modelo de Einstein del Universo, Vimos ya que hay dos clases de espacio, «abierto» y «cerrado»; y según las ecuaciones más sencillas de la cosmología, corresponden exactamente a un Universo en expansión continua y a otro que, finalmente, empezará a contraerse. El Universo que se expande para siempre es el modelo abierto, también infinito en «tamaño». Por otro lado, el Universo que tiene materia suficiente como para frenar la expansión hasta su paralización es el modelo «cerrado», que se curva sobre sí mismo, y en donde, si no fuera por la complicación de la expansión, podríamos describir una trayectoria recta a través del espacio y llegar al punto de partida por la puerta de atrás.
En ambas clases de Universo, los rayos de luz se focalizan ligeramente cuando viajan a través del espacio vacío entre las galaxias. Si un objeto de tamaño fijo por ejemplo, una regla se alejase de nosotros, lo veríamos en principio encogerse como podríamos esperar, pero una vez que superase una distancia de aproximadamente 10.000 millones de años luz, volveríamos a verlo aparecer más largo, ¡aunque siempre haya estado alejándose! No es sorprendente que este efecto de enfoque sea más intenso para la «curvatura» del Universo cerrado; y los astrónomos han investigado diversos objetos —cúmulos de galaxias y radiogalaxias en particular - con el propósito de ver cómo su tamaño depende de la distancia. Las respuestas, sin embargo, no son concluyentes, ya que la Naturaleza no nos ha proporcionado patrones, es decir reglas idénticas para nuestras mediciones.
El método más fascinante de predecir el fin del Universo depende de algo que ocurrió muy cerca de su comienzo: la producción de deuterio. Casi todos estos núcleos pesados de hidrógeno recogen protones y neutrones extra para convertirse en helio; pero resta permanente una diminuta proporción, y la teoría relaciona esta fracción con la densidad de materia en el tiempo. Los satélites de ultravioleta han detectado las líneas espectrales del gas deuterio en el espacio, y su intensidad parece mostrar que el Universo es relativamente bajo en densidad: la teoría cosmológica relaciona la cantidad actual de deuterio con la densidad del Universo primitivo, y a partir de aquí resulta posible averiguar que el Universo se expandirá por siempre.
En su conjunto, la cuestión está lejos de esclarecerse, aun cuando todos los métodos conducen finalmente a la misma respuesta. Por el momento, consideremos brevemente los dos posibles resultados.
En un Universo cerrado, la expansión se desacelera gradualmente; y en algún tiempo futuro, digamos aproximadamente 75.000 millones de años a partir de ahora, la gravitación triunfará por completo. El Universo empezará a colapsarse nuevamente. Los cúmulos de galaxias comenzarán a juntarse, cada vez más rápido, hasta que 160.000 millones de años a partir de ahora, el Universo entero desemboque en el «Big Crunch». La materia se comprimirá cada vez más, y, cuando esto ocurra, la fuerza gravitatoria crecerá aumentando de intensidad; la teoría predice para entonces una singularidad de densidad infinita. Algunos cosmólogos del Big Crunch creen que éste es olio Big Bang, y que el Universo empezará de inmediato a expandirse nuevamente en otro ciclo de su existencia. Este nuevo Universo tendrá diferentes tipos de materia, fuerzas, e incluso leyes físicas distintas que las nuestras.
Sin embargo, quizá resulte justo decir que la mayor parte de los astrónomos actuales considera que el Universo es comparativamente vacío, es decir abierto, y que se expansionará por siempre. Tampoco en este caso el panorama para nuestros descendientes es prometedor. Aun cuando no se enfrenten al inminentemente irremediable Crunch, caerán en la trampa de la «muerte térmica» que preelijo lord Kelvin en 1851, antes de que se conocieran otras galaxias y la expansión del Universo.
Será una muerte prolongada y describirla en términos de años sería inconveniente. En vez de ello, denominaremos a la Edad del Universo hasta aquí a los 15.000 millones de años como «un segundo cósmico». En esta nueva escala, nos hallamos en la actualidad a un segundo cósmico después del Big Bang, y nuestro Sol y la fierra tienen una edad de un tercio de segundo.
Las estrellas mueren de continuo dentro de cada galaxia, y nacen estrellas nuevas a partir del gas en las galaxias espirales e irregulares, lo que agota la provisión disponible del mismo. Aun cuando las estrellas moribundas exploten o expulsen algo de gas al espacio interestelar con el fin de reponerlo, la cantidad que devuelven suele ser menor que la que originalmente han lomado; como resultado de ello hay cadáveres compactos de estrellas, enanas blancas, estrellas de neutrones o agujeros negros. Así pues, la provisión de gas disminuye gradualmente, y, por último, cesará el nacimiento de las estrellas. Las galaxias se convertirán en cementerios de estrellas, con cadáveres que permanecerán girando en sus órbitas.
Después de unos pocos minutos cósmicos íes decir diez mil billones de años de tiempo corriente), nuestro Sol se habrá apagado ya hace tiempo cual una tibia «enana blanca» negra, circundada por un séquito de planetas helados. Incluso si nuestros descendientes se hubieren trasladado a los planetas de estrellas más jóvenes, también estas estrellas habrían de desaparecer en unos pocos minutos cósmicos más a partir de ahora. Nuestra Galaxia será completamente negra y fría, sin ninguna fuente de luz o calor para mantener en funcionamiento el proceso de la vida. Resulta difícil entrever qué tipo de vida podría continuar cuando las fuentes de energía de la Naturaleza se hubieren agotado.
Pero no seamos demasiado pesimistas. Si avanzamos por la máquina del tiempo de la teoría cosmológica, verificamos que las galaxias de estrellas muertas no son el fin de la historia. Cuando las estrellas se hallan en órbita, pierden energía de continuo en forma de radiación gravitacional (la versión gravitacional de la radiación electromagnética que se produce cuando se acelera una carga eléctrica).

Dos posibilidades para el último destino del Universo: el colapso en un «Big Crunch», o la expansión eterna. Las observaciones que se efectúen durante los próximos anos decidirán cuál es más probable.
Todos los cuerpos en órbita —la Luna, la Tierra y el Sol, en órbitas muy distintas pero similares en este sentido— pierden en la actualidad energía de esta forma, pero a un ritmo lento. Para lapsos ordinarios, o incluso para la edad del Universo, en un segundo cósmico no se puede detectar una diferencia en la órbita.
Sólo cuando hablamos de lapsos de años cósmicas se contraen, poco a poco, las órbitas de las estrellas en torno al centro de las galaxias. Si esperamos durante muy largo tiempo —lo que significa un billón de años cósmicos, comprobaremos que las estrellas muertas de nuestra Galaxia (incluyendo los rescoldos de lo que fuera el Sol) han descrito una espiral hacia el centro para formar un masivo agujero negro.
En los cúmulos de galaxias, las galaxias individuales describirán espirales hacia el centro del cúmulo, y se agruparán como un agujero negro supergaláctico aún más pesado. El Universo consistirá en inmensos agujeros negros, cada uno tan pesado como galaxias o cúmulos de galaxias, separados por enormes extensiones de vacío.
Existe un último acto en la historia del Universo. Recordemos que Stephen Hawking mostró que los agujeros negros se evaporan lentamente, perdiendo en efecto su masa en un flujo de electrones y positrones, lentamente al principio, pero dando lugar a una explosión final. El agujero negro más pesado es el que más tarda en evaporarse. Un agujero negro de estrella permanecería durante un periodo mucho más largo que los considerados hasta aquí, y otros agujeros negros desaparecerían intactos dentro de los agujeros negros del centro de las galaxias. No obstante, aun cuando más lentamente, estos agujeros negros galácticos y supergalácticos están en proceso de evaporación. Poco a poco se convierten en electrones y positrones, en un periodo de unos 1.000.000.000.000.000.000.000.000.000.000.000.000.000.000.000.000.000.000.000. 000.000.000.000.000.000.000.000.000 años cósmicos.
En esta apabullante fecha del futuro, la bola de cristal empieza a confundirse. Nuestra máquina del tiempo nos muestra que el Universo contiene casi únicamente electrones y positrones separados por vastas distancias. En el Universo, aún en expansión, es probable que estas partículas nunca se encuentren ni se aniquilen. Y con ellas, increíblemente separados, estarán los fotones del fondo de radiación, ya enfriados y estirados hasta longitudes de onda más largas que todo lo que podamos imaginar.
Quizás estos fotones tengan la última palabra. A partir de! momento en que la materia se atrevió a formar átomos y seguir su propio decurso independiente de la radiación, sólo un millón de años (terrestres) después del Big Bang, los fotones de radiación han sido principalmente pasivos espectadores. Desde la formación de galaxias y estrellas, y desde la época de la vida fuere ella lo que fuere hasta la muerte de la materia en agujeros negros y su resurrección en forma de electrones y positrones esparcidos, estos fotones se han mantenido al margen. El estoico fondo de radiación ha permanecido ausente de los triunfos y tragedias del Universo, Pero algunos de estos fotones inciden favorablemente sobre nuestros radiotelescopios y nos hablan de cuando empezó nuestro Universo.
Capítulo 12
La búsqueda continúa
La búsqueda del conocimiento no tiene fin. Percibimos el Universo como un lugar ordenado porque estarnos aquí para observarlo. ¿Hay otros Universos? ¿Existen otras formas de vida?

Las fronteras de la ciencia están en continua expansión. En el primer alunizaje, en 1969, Edwin Aldrin lleva a cabo un experimento para comprobar el viento solar de partículas cargadas. A partir de entonces, nuestro conocimiento del sistema solar interior ha aumentado enormemente; sondas no tripuladas desvelarán pronto tos secretos de los planetas exteriores. Y el espacio es apenas una de las muchas fronteras que hay que explorar.
§. ¿Algo más que los quarks?
§. Hacia la «realidad más remota»
§. La gravitación, ¿hasta dónde?
§. El espacio inquieto
§. El labora torio del Universo
§. El principio antrópico
§. El viaje inconcluso
El universo en toda su extensión es el campo de investigación de los modernos científicos. Hemos visto el modo en que experimentadores y teóricos colaboran en el estudio completo de todo lo que implique tamaño, edad y energía del Universo y los progresos logrados en la comprensión de éste han sido colosales.
La legión de científicos que actualmente trabaja en la materia supera a todas las anteriores generaciones de científicos. Si a esto añadimos los aceleradores de partículas y los telescopios de multimillones de dólares que han rebasado las fronteras del conocimiento, así como los ordenadores que acaban con la tediosa tarea de los largos cálculos, la celeridad de los actuales descubrimientos puede no parecemos tan sorprendente. La tradicional estampa del científico aislado, que por casualidad efectúa un descubrimiento en su laboratorio, ha dejado de ser real. La mayoría de los proyectos de investigación compromete a grandes equipos de científicos, cada uno de los cuales contribuye con sus técnicas especiales y ayuda a los demás, lo que favorece la rapidez en el análisis de los resultados.
A pesar de existir una saludable rivalidad en cuanto a nuevos descubrimientos, las modernas comunicaciones han dado lugar a un importante aumento en la colaboración a nivel internacional. Existe un sentimiento auténtico de comunidad internacional, en especial en una ciencia como la astronomía, donde hay un número relativamente pequeño de científicos en activo. Es estimulante experimentar el espíritu de total franqueza que caracteriza a las conferencias científicas internacionales.
Un peligro del ímpetu de la investigación reside en que los resultados no pueden llegar hasta el publicó en general, que, en definitiva, es quien costea esta exploración de lo desconocido. Naturalmente, los investigadores de primera línea se concentran en sus programas de investigación y, salvo relevantes excepciones, carecen de tiempo para divulgar sus trabajos. Y puesto que el mundo de los quarks y de los quásares se halla lejos de nuestro mundo «lógico», esos resultados no se pueden resumir como noticias de última hora; requieren una explicación previa para que la persona media pueda comprender su importancia.
Aun cuando lo ilógico del Universo haga difícil la comunicación de ideas, ésta es, en si, fascinante. Seríamos excesivamente ingenuos si pensáramos que resultaría fácil comprender lo muy pequeño, lo muy grande y lo muy poderoso en términos de las cosas habituales. Nuestro mundo cotidiano Constituye sólo uno de los niveles del Universo. Si, por ejemplo, viviéramos habitualmente a la pequeña escala en la que el principio de incertidumbre es relevante, y fuéramos transportados al mundo humano, nos parecería milagroso que un jugador de golf ¡pudiera predecir exactamente la posición donde quiere enviar su pelota!
La esencia del avance científico consiste en elaborar teorías que concuerden con los posteriores resultados experimentales, y que permitan asimismo predecir correctamente lo que ocurrirá en experimentos futuros. Si se verifican estas predicciones, la teoría tiene que ser una descripción totalmente exacta de lo que ocurre.

Los avances científicos involucran a menudo técnicas nuevas: esta fotografía de la constelación de Orion muestra sólo unas cuantas estrellas más de las visibles a simple vista: pero empleándose un filtro especial se pueden resallar das nubes de hidrógeno. La pequeña forma de pera es la nebulosa de Orion, el circulo grande (Lazo de Bernard) es quizás una «burbuja» hinchada por las calientes estrellas centrales.
Las teorías científicas deben aportar resultados numéricos para su comparación con los obtenidos experimentalmente; y esto las hace necesariamente matemáticas. Para los científicos que trabajan en este campo, esto no representa un inconveniente; pero cuando se trata de explicar en lenguaje simple el significado científico de una teoría extraña, comienzan a surgir las dificultades.
La teoría de la relatividad es quizás el ejemplo más destacado al respecto. Alcanzó su fama de incomprensible por estar en gran parte expresada en términos matemáticos; y aun cuando se la explique de forma simple quien tal vez mejor lo hizo fue el propio Einstein —, sus aparentes contradicciones con la lógica confunden a muchos lectores. La teoría cuántica constituye otro buen ejemplo, pues sus ecuaciones predicen que una porción de energía se comportará a veces como una «onda», y en otras situaciones como una «partícula sólida». La contradicción onda-partícula no existe en la propia Naturaleza, sino únicamente cuando intentamos explicar esta exótica situación en términos comunes. Una teoría debe de estar construida coherentemente, y aquí entran en juego las matemáticas con el propósito de que no existan contradicciones y haya correspondencia con el conjunto de teorías ya establecidas y confirmadas. De otra manera, estas conclusiones resultarían desechables.
La eficacia con que la ciencia accede al Universo se ha puesto de manifiesto a todo lo largo de este libro. La totalidad del Universo puede explicarse en {Unción de unos cuantos tipos de partículas, unas cuantas fuerzas y unas pocas leyes de la Naturaleza. Entre el pequeño mundo de los quarks y las enormes centrales de energía de los quásares; entre una fracción de segundo después del nacimiento del Universo y la compleja comunidad de las galaxias con sus estrellas constituyentes, nubes de gas, planetas, todo parece estar relacionado,
A la pequeña escala de los quarks, la Naturaleza parece relativamente simple; y lo mismo sucede cuando los cosmólogos piensan en el Universo como en un todo y consideran a las galaxias como meros trozos de materia uniformemente distribuidos en un Universo que se expande en el espacio vacío.

Una aurora se origina en el «viento» que fluye del Sol y que es canalizado por el campo magnético terrestre en La atmósfera. Pero tal como sucede en muchas investigaciones científicas, estudios más detallados han mostrado que la situación es más complicada: son necesarias más investigaciones para comprender por entero el fenómeno de las auroras boreales.
La distribución uniforme de la radiación de fondo del Universo desde sus primeros momentos muestra que, a gran escala, éste es extremadamente uniforme. Por cierto, los astrónomos consideran muy difícil comprender por qué el gas uniforme que originalmente colmaba el Universo se distribuyó en agrupaciones como las protogalaxias. También las estrellas, a pesar de su impresionante apariencia, son bastante simples. La complejidad del Universo alcanza su mimo máximo en los seres vivos, en los que el fenómeno de la vida se debe a intrincadas reacciones químicas y complejas moléculas.
§. ¿Algo más que los quarks?
A pesar de toda esta armonía, los científicos modernos no han explicado exhaustivamente los secretos de la Naturaleza, Si lo hubieran hecho, no habría posibilidad de realizar posteriores observaciones del Universo. Siempre habrá nuevos hechos que concuerden con los anteriores; nuevos experimentos que contradigan las teorías establecidas. Actualmente la ciencia se encuentra en un punto donde, al parecer, la estructura del Universo está establecida; pero nadie pretende que los detalles estén acabados.
En el mundo de la física de partículas debemos preguntarnos por las partículas aparentemente «superfinas». Para la construcción del Universo únicamente se necesitan los quarks «arriba» y «abajo» y el electrón y su neutrino. Todavía hay, al menos, otros dos quarks y otros dos leptones. Esto puede relacionarse sutilmente con la forma en que se manifiestan las cuatro fuerzas, aparentemente diferentes, que actúan en la Naturaleza, las cuales probablemente no son sino manifestaciones diferentes de una única fuerza básica.
Existen cuatro quarks bien conocidos, y otros dos probables. Pero hay una complicación adicional que hasta este momento no se mencionó. Los quarks han de tener una nueva clase de «carga», además de sus cargas eléctricas. Las leyes cuánticas no permiten que puedan existir dos quarks idénticos en una partícula; sin embargo, en una de ellas como la omega minus hay tres quarks «extraños» aparentemente idénticos. Los teóricos creen y existen observaciones que apoyan esta idea que hay tres variedades de «carga» en los quarks a diferencia de la carga eléctrica, que es de dos clases, positiva y negativa. En una partícula como el protón o la omega minus, cada quark tiene una de estas tres cargas diferentes; así pues, para los propósitos de la teoría cuántica, incluso los tres quarks «extraños» que constituyen la omega minus no son idénticos. (Las «cargas» se denominan habitualmente «colores», para distinguirlas de las cargas eléctricas ordinarias.)

Punto de intersección de los anillos de almacenamiento de intersección (ISR) del CERN. En este punto colisionan las partículas que viajan en direcciones opuestas por los dos grandes anillos, liberando energía que puede dar lugar a la creación de nuevos pares partícula-antipartícula. En la actualidad está en construcción un ISR más potente, que podría producir las partículas fundamentales más pesadas, predichas por las actuales teorías.
De inmediato comprobamos que nuestra familia de cuatro (o seis; quarks ha aumentado. Dado que cada tipo de quark puede adoptar uno de tres colores, la familia se: acrecienta en doce (o dieciocho) miembros. Esto conlleva el aumento del número de partículas «fundamentales», ¿Son los quarks simplemente el reflejo de una unidad más elemental aún no descubierta? ¿Hay un número definido de quarks, o construyendo aceleradores que operen a energías cada vez mayores podríamos obtener cada vez más clases diferentes? Los físicos de partículas están convencidos de que detrás de todo esto existe un único modelo.
Podríamos asimismo plantearnos los mismos interrogantes para los leptones. La diferencia quizá resida en que los leptones más pesados pueden establecer un vínculo aparente entre los quarks y los leptones que significa que: existe una simetría entre los quarks «arriba» y «abajo» y los electrones y sus neutrinos; y entre los quarks «extraño» y «encantado» y los muones y los neutrinos asociados a los mitones.
Todos estos interrogantes se relacionan estrechamente con el problema de la unificación de las fuerzas; al menos, a esto aspiran los teóricos. Las fuerzas débil y electromagnética han logrado ser unificadas por la teoría de Steven Weinberg y Abdus Salam; aun cuando en este libro las hayamos mencionado generalmente por separado, debido a que sus efectos son tan diferentes. Esta teoría de la unificación se confirmó con un crucial experimento, llevado a cabo en 1978 en el gran acelerador de electrones de Stanford.
Este experimento aprovechó una propiedad particular de la fuerza débil descubierta ya a finales de la década de 1950: el sinistrorsum. Un neutrino producido por una interacción débil tiene un «spin»; esto es, cuando está viajando por el espacio describe un movimiento como el de un sacacorchos. Todos sabemos que un sacacorchos posee un «sentido de avance»: un tornillo ordinario (a derechas) avanza cuando le giramos en el sentido de las agujas del reloj; pero es igualmente posible fabricar un tornillo a izquierdas que retroceda cuando le giremos en el sentido de las agujas del reloj. Los destornilladores empleados por los expertos que reparan maquinaria operan según este principio. Un neutrino describe siempre el movimiento de un tornillo a izquierdas, mientras que su antipartícula, el antineutrino, avanza cual un tornillo a derechas.

Un temprano experimento que indica que la teoría que relaciona las fuerzas débil y electromagnética es correcta. Exactamente debajo del centro de esta fotografía de la cámara de burbujas del CERA, un antineutrino (invisible) afecta a un electrón estacionario en una interacción de «corriente neutra» predicha teóricamente; produce otro antineutrino (invisible) y un electrón en movimiento (la fina traza horizontal curvada). Dos rayos gamma originados en este proceso crean dos pares electrón-positrón, que pueden verse claramente a la izquierda de la traza del electrón original.
Si se siguiese considerando que las fuerzas electromagnética y débil están realmente relacionadas, las interacciones electromagnéticas habrían también de presentar un débil efecto «a izquierdas»; teóricamente, esto ocurriría incluso en los electroimanes o en un peine (rolado cuando se lo acercase a trozos de papel, si bien, muy posiblemente, no podríamos detectar el hecho en tales circunstancias. En Stanford, los experimentadores bombardearon protones con electrones, y este simple experimento electromagnético en el que la fuerza eléctrica del protón positivo atrae al electrón negativo puso de manifiesto una ligera preferencia «de mano». Los electrones emergentes no quedaban uniformemente distribuidos entre spines «a derecha» y «a izquierda»; la diferencia era exactamente la cantidad predicha por Weinberg y Salam. A partir de junio de 1978 hubo una fuerza considerada como fundamental menos en la Naturaleza.
Pero existen todavía muchos problemas importantes; y en los próximos años los físicos de partículas continuarán investigando las relaciones entre fuerzas y partículas, ayudados por las nuevas generaciones de potentes aceleradores ahora en procesó de diseñó y construcción. Resulta prioritario encontrar las partículas W y Z. que transportan la fuerza débil. También están en agenda los gluones, partículas responsables del intercambio de la más poderosa fuerza fuerte. I .a teoría predice la existencia de ocho tipos de gluones, número relacionado con las tres clases diferentes de «carga» o «color» que pueden poseer los quarks.
A pesar de la aparente proliferación de «partículas fundamentales» y «partículas transportadoras de fuerza», existe ahora una estructura básica en la física de panículas. El «edificio bloque», los quarks y los leptones, giran sobre sus ejes con spin un medio. Las partículas que transportan fuerza (radiaciones) —el fotón, las partículas W y Z, los gluones y los gravitones— tienen un número entero de unidades de spin: dos para el gravitón, y uno para los demás. Los físicos procuran dar sentido a este hecho aparentemente extraño. Las teorías que lo intentan se denominan «teorías de gauge» (de contraste; NT), Weinberg y Salam emplearon con éxito una teoría de gauge para unificar las fuerzas débil y electromagnética; otra teoría de gauge describe el modo en que la fuerza fuerte del gluón mantiene unidos los quarks en protones u otros hartones. Los físicos esperan que exista una teoría de gauge más general que armonice ambas, y que combine asimismo la fuerza fuerte con la débil y la electromagnética. Las teorías de gauge fueron verificadas por un joven físico belga, entonces estudiante de doctorado, llamado Gerard ’t Hooft. El problema que complicaba a estas teorías residía en la imposibilidad de renormalizar las partículas masivas de «spin uno». Esto es, no tenían sentido matemático poique daban resultados infinitos. Hooft demostró que una clase particular de teorías que involucraban partículas masivas daba resultados finitos, desarrolló nuevas técnicas para tratarlas.
Tres de las cuatro fuerzas que operan en la Naturaleza estarán entonces cobijadas bajo el mismo techo. Seremos capaces de observarlas sólo como manifestaciones diferentes de una única fuerza básica, al igual que los científicos han pensado durante un siglo de la electricidad y el magnetismo como la misma fuerza básica electromagnética). Para proceder a una analogía simple, consideremos un cilindro que parece diferente cuando lo miramos desde distintas direcciones: desde la base semeja un círculo, mientras que visto de lado es un rectángulo. Realmente, no sorprende que la fuerza básica de la Naturaleza pueda comportarse de diferentes maneras cuando están implicadas partículas distintas en circunstancias diferentes: se manifiesta como la fuerza fuerte que enlaza estrechamente a los quarks, como las interacciones que implican a los leptones en las desintegraciones controladas por la fuerza débil, y como todas aquellas situaciones que involucran cargas eléctricas, como la polifacética fuerza electromagnética de la electricidad, el magnetismo y la luz.
§. Hacia la «realidad más remota»
Hoy día las teorías de gauge nos dicen algo acerca de cómo está estructurado el Universo a un nivel aún más profundo, allí donde podemos observarlo como tina mezcla compleja de «orden completo» y de «completo desorden». Una vez más, no podemos entenderlo en los términos de la lógica, pero podernos efectuar otra analogía. Un terrón de azúcar es altamente simétrico: sus seis caras están maravillosamente ordenadas, y no existe razón lógica alguna para preferir una a otra; giremos el cubo, y todas serán idénticas. Pero si lo dejamos caer sobre la mesa, una de las caras quedará hacia arriba. La simetría «se ha roto», pues ahora hay una característica distinguible (¡solamente una cara se llena de polvo!). Un grado de desorden ha penetrado en nuestra teoría ordenada del cubo de azúcar: no un completo desorden, sino una contribución que podríamos considerar que hace al cubo más interesante.

Un serio contendiente en la unificación de todas las fuerzas y partículas es la teoría de la «supergravedad». Sólo una clase de partícula—la llamada «superpartícula» puede manifestarse como cualquier tipo de partícula de fuerza, de quark o de leptón. La atención se centra ahora no en las propias partículas, sino en los procesos por los que la superpartícula desempeña sus distintos papeles.
En el mundo real de las partículas fundamentales el «orden» completo implicaría que todas las partículas de fuerza tienen masa cero. Esto es realmente cierto para los fotones de la fuerza electromagnética y para los gravitones, pero las partículas W y Z de la fuerza débil poseen una gran masa: probablemente son unas 150.000 veces más pesadas que el electrón. Quizás, asombrosamente, el «desorden» del Universo puede dar lugar a partículas masivas. En términos muy vulgares, podemos pensar en las partículas W y Z como si fueran fotones que han «adquirido» masa porque se ha introducido una cierta cantidad de desorden. Esta es la esencia de la teoría de Weinberg-Salam: las partículas básicas que transportan las fuerzas débil y electromagnética son las mismas, pero las primeras implican cierto desorden que les confiere masa, y esto (como vimos en el capítulo 6) significa que solamente actúan a corta distancia.
El físico Peter Higgs, de Edimburgo, fue el primero en combinar, en 1969, esta sutil clase de desorden («ruptura espontánea de la simetría») con las teorías de gauge y establecer el escenario de las actuales teorías. Sus cálculos demostraron que el «desorden» puede realmente aparecer como una nueva clase de partícula, relativamente pesada, el mesón de Higgs, cuyo comportamiento sería radicalmente distinto al de los quarks, leptones y «partículas de fuerza» ahora conocidos. Weinberg, por lo menos, cree que en la próxima década pueden verificarse experimentalmente estas «partículas de desorden»; aun cuando algunos otros teóricos piensan que únicamente se trata de elucubraciones matemáticas de la teoría.
En el campo de la física de partículas nos alejamos del interrogante que nos pide saber de qué están hechas las cosas. Al parecer, los quarks y los leptones son los pilares básicos del edificio. La relación entre estas partículas y las fuerzas es ahora prioritaria; y los físicos esperan poder alcanzar un conocimiento más profundo del modo en que «partículas» y «fuerzas» se pueden relacionar con conceptos aún más básicos, tales como el conflicto entre «orden» y «desorden» («simetría» y «ruptura de la simetría» en el lenguaje de los físicos).

El bello modelo espiral de los discos de las galaxias se origina en la gravitación, la fuerza natural menos intensa, cuya naturaleza básicaaún no ha sido comprendida. Esta fotografía de M83, del Observatorio Anglo-australiana, se ha procesado especialmente para mostrar los detalles de los brazos espirales: compárese con la fotografía normal de M83 de páginas anteriores.
El tipo de «orden» al cual los físicos se refieren aquí, se vincula estrechamente con las «leyes de la Naturaleza», como la que establece que la carga eléctrica no se puede crear ni destruir. Así pues, los físicos procuran extender las leyes de la Naturaleza que conocemos, y anticipan que con la adición de un factor extra de «desorden» resultaría finalmente posible probar, de forma bastante natural, que las fuerzas y las partículas del Universo serían las ya encontradas. Tales teorías, mucho más profundas, nos conducirían a responder cuestiones sobre las que las actuales teorías permanecen mudas: ¿cuántos quarks y leptones hay?; y ¿por qué los quarks individuales y los leptones tienen masas particulares que podemos medir?
§. La gravitación, ¿hasta dónde?
Siguiendo uno de los últimos progresos de la física de partículas, nos hemos aventurado en un terreno especulativo. Pero hay una fuerza que los científicos no pueden medir en sus experimentos: la increíblemente débil fuerza gravitatoria, las teorías gravitacionales cambiarán indudablemente en los próximos años, porque —como hemos visto varias veces en este libro— no hay modo alguno de combinar la teoría general de la relatividad do Einstein con la teoría cuántica de los gravitones. En astronomía, la relatividad general funciona allí donde la teoría original de Newton, y las de otros muchos, habían fallado. Pero el intercambio de gravitones tiene que estar implicado incluso a un nivel básico. Y en las extrañas condiciones de una «singularidad» dentro de un agujero negro, o en el Big Bang del comienzo del Universo, la relatividad general no explica nada. En tales circunstancias, se hace precisa una muy sofisticada teoría cuántica de la gravitación.
Nadie tiene aún mucha idea del modo en que, finalmente, esta teoría saldrá a la luz, o de qué extrañas predicciones contendrá. Para cuando se llegue aquí, los físicos se habrán dedicado con empeño a la tarea de relacionar la teoría gravitatoria Con la de las otras tres fuerzas. Esto es el que persigue la teoría del campo unificado, a la que Einstein dedicó muchos infructuosos años (aun cuando trabajó en una época en la que se ignoraban otras fuerzas).
Un fuerte contendiente capaz de lograr una teoría cuántica gravitacional y una unificación con las otras fuerzas, vinculándolas finalmente con los quarks y leptones, es un reciente descubrimiento llamado supergravedad.
Esta parte de la idea de un «orden» fundamental, extendiéndolo, para abarcar a «partículas» y «panículas de fuerza», como una supersimetría: aquí, la gravitación aparece, bien como «partícula de fuerza», bien como el tipo de campo que describe la relatividad general. La supergravedad es una forma elegante de combinar las fuerzas, las partículas y la idea básica de «orden» en el Universo; pero sólo se halla en sus primeras etapas.
§. El espacio inquieto
Algunos físicos, dirigidos por el americano John Wheeler y el soviético Andrei Sajarov, desean comenzar por el nivel más fundamental posible y seguir de modo ascendente con la esperanza de llegar hasta las fuerzas y partículas conocidas desde el espacio vacío que es el fondo de todo lo que ocurre en el Universo. Señalan una analogía simple con el mundo cotidiano. Una banda de goma es «elástica» por la forma en que están organizadas sus moléculas constituyentes, Sin embargo, aun cuando midamos con exactitud la elasticidad de la goma, nunca podremos deducir a partir de ello que la goma está formada por moléculas. Solamente cuando sepamos a priori que la materia está formada por moléculas a partir de innumerables experimentos físicos y químicos), podremos demostrar cómo estas moléculas confieren a la goma la extraña propiedad de ser elástica.
¿Es quizá la gravitación una especie de «elasticidad» del espacio, debida a una desconocida estructura a pequeña escala del propio espacio? Desde esta perspectiva, por mucho que estudiemos la gravitación no podremos aprender nada más básico acerca de ella. Los físicos deben comenzar por estudiar qué es el espacio. Pero, seguramente, se podrá argüir que el espacio es únicamente vacío. Aunque ya no sería ésta la opinión de los físicos modernos. Recordemos que en el capítulo 6 discutíamos el modo en que las fuerzas eran transportadas por partículas «virtuales», partículas de fuerza que aparecen y desaparecen en tiempos tan cortos (pie nos resulta imposible medirlas directamente. El principio de incertidumbre de Heisenberg nos impide observarlas como partículas reales. El único modo en que sabemos que se intercambian reside en que existe la fuerza. Pese a que ningún físico ha encontrado un gluón en sus experimentos, el poder ríe la bomba de hidrógeno es adecuado testimonio de que son muy reales los gluones de tan corta vida que transportan la fuerza fuerte.
Asimismo, en la explosión de agujeros negros de Stephen Hawking vimos que los pares electrón-positrón pueden existir durante el breve tiempo permitido por el principio de incertidumbre (a menos que uno de ellos caiga dentro del agujero y el otro escape como una partícula real). Así pues, el espacio vacío entero está lleno de efímeras partículas que aparecen y desaparecen demasiado rápidamente como para que las apreciemos, Pero, indudablemente, existen.
Se ha medido el efecto de estas partículas virtuales sobre el movimiento del electrón en el átomo de hidrógeno, y el mismo concuerda con la teoría. Wheeler y Sajarov van más lejos, y sostienen que esta «estructura espumosa» de fugaces partículas y antipartículas en el espacio es la causa de la fuerza que llamamos gravitación, tal como la estructura de la molécula de goma determinaba su elasticidad.

El mayor radiotelescopio del mundo es un plato enrejado fijo de 305 metros de diámetro, suspendido en una hondonada natural cerca de Arecibo, Puerto Rico. Esta antena se utiliza tanto en radio como en astronomía de radar, y se la ha empleado para transmitir el primer mensaje humano interestelar intencionado al espacio. Posee potencia suficiente para comunicar con una antena similar situada en cualquier lugar de nuestra Galaxia.
El decano de los agujeros negros, Hawking, lleva estas «fluctuaciones del vacío» aún más allá. Las fugaces partículas podrían constituir brevemente minúsculos agujeros negros de sólo 0,00000000000000000000000000000000001 metros de diámetro, y 0,0000001 gramos de peso que se evaporarían de inmediato. Aun cuando estos efímeros agujeros negros, de vida tan corta que no nos permite detectarlos directamente, pueden parecer inconsecuentes, Hawking piensa que a largo plazo pueden tener profundos efectos.
Su trabajo sobre la teoría de los agujeros negros le llevó a considerar que estos objetos son una limitación más fundamental que la del principio de incertidumbre de Heisenberg, lo que de por sí significa que nunca podremos calcular con absoluta seguridad cuál será el resultado de un experimento. El «principio de ignorancia» de Hawking establece que en un agujero negro se pierde toda la información (excepto la masa total, el spin y la carga del agujero). Y los diminutos y efímeros agujeros negros, que continuamente aparecen y desaparecen a través del esparció, en algún sentido pueden estar sustrayéndonos conocimiento sobre el Universo:.
Se sabe que Einstein jamás aceptó realmente el principio de Heisenberg, o sea la idea efe que el puro azar juega un papel importante en el Universo: y sí insistía en que «Dios no juega a los dados». Hawking va más lejos que Heisenberg, y con los agujeros negros in mente dirá esta frase ampliando la de Einstein: «Dios no sólo juega a los dados, sino que a veces los arroja allí donde no se puede ver.»

Sólo recientemente han aceptado los geólogos que los continentes terrestres se mueven; ahora se piensa que la India y Sri Lanka, vistas aquí desde una cápsula tripulada Géminis, estuvieron originalmente, mudas a África y a la Antártida. Indudablemente, nuestro planeta reserva aún muchas sorpresas a los científicos.
§. El laboratorio del Universo
Después de nuestra excursión por las tortuosas sendas que los físicos siguen actualmente en su búsqueda de la estructura básica del Universo, volvamos nuestros ojos hacia el cielo. Los astrónomos se han beneficiado profundamente de los descubrimientos de los físicos: después de todo, éstos habían predicho las estrellas de neutrones y los agujeros negros mucho antes de que los astrónomos los encontraran; y la teoría de la evolución de las estrellas se hallaría en precario estado sin el conocimiento de las reacciones nucleares aportado por los físicos. Aun cuando el proceso no ha sido unívoco, pues los astrónomos también han efectuado su contribución a la física.
En primer lugar, muy poco sabríamos acerca de la gravitación si nuestra ciencia se limitase a la Tierra. Únicamente en un laboratorio a escala cósmica obtenemos suficiente materia concentrada como para permitir que la gravitación venza a las otras fuerzas. Los agujeros negros son el experimento gravitatorio más reciente de la Naturaleza que tenemos el privilegio de estudiar. Pero los ensayos astronómicos de la teoría gravitatoria tienen una larga historia; datan de tiempo atrás, cuando Newton comparó la velocidad de caída de una manzana con el movimiento de la Luna alrededor de la Tierra.
Las estrellas de neutrones, que se nos presentan como púlsares, son una clase de materia demasiado densa como para que la podamos fabricar en la Tierra: y las supernovas son explosiones de una potencia que no podemos emular. Ambas implican situaciones ante las cuales los astrofísicos simplemente toman asiento en el laboratorio de la Naturaleza y observan los resultados de un «experimento» situado más allá de nuestra propia capacidad.
En la interrelación entre físicos y astrónomos hay un tema fascinante al que solamente pueden acceder los astrónomos. ¿Cambian con el tiempo algunas cantidades fundamentales, tales como la carga del electrón y el número que relaciona la energía y la longitud de onda de un fotón (constante de Planck}? Los físicos tienen que realizar sus experimentos en el presente, pero los astrónomos pueden introducirse en el pasado cuando observan objetos muy lejanos: al examinar la «línea» de radio de 21 cm. del hidrógeno, así como las líneas del espectro óptico de los quásares lejanos, comprueban que las constantes físicas no varían (o, si lo hacen, ello sólo puede ocurrir de una forma muy especial). Las observaciones astronómicas nos dicen que las fuerzas y partículas básicas del Universo no han cambiado desde los primeros momentos.
Para seguir con la astronomía, las próximas dos décadas asistirán al envío de sondas espaciales que visiten a todos los planetas (excepto al remoto Plutón); y posiblemente incluso al cometa Halley en su retorno en 1986. Los planetólogos podrán ajustar con mayor precisión las desviaciones individuales de los planetas y, de esta forma tan fascinante, comenzarán a explorar las misteriosas lunas de los planetas exteriores. El estudio de la fierra también progresará, ya que no hace mucho que los geólogos han aceptado que la corteza de la fierra está rota y se mueve continuamente en grandes placas que transportan los continentes. Desconocemos todavía el modo en que esos enormes y pesados trozos de corteza son propulsados con energía suficiente como para que emerjan, al colisionar, cordilleras como la del Himalaya.
Los neutrinos desaparecidos del Sol experimentan el acoso de una nueva generación de detectores de neutrinos más sensibles que el de Raymond Davis, que recogerán mayor cantidad de neutrinos de más baja energía. Los astrónomos tendrán así, al menos, evidencia directa del horno termonuclear que mantiene brillando a nuestro Sol. Esto se complementará con estudios de las diminutas y regulares pulsaciones de la superficie del Sol, objeto de debate en los últimos años, que eventualmente podrían revelar alguna evidencia independiente sobre la estructura del Sol. Ambos estudios constituyen pruebas de nuestras ideas actuales sobre el interior de las estrellas y su evolución.
Los astrónomos mantendrán asimismo sintonizados sus radiotelescopios con el propósito de recibir posibles señales de otras civilizaciones. Es ésta una búsqueda en la que no podemos estimar la probabilidad de éxito. Ciertamente, llegar a captar un mensaje de otro mundo supondría el acontecimiento más emocionante forjado por los astrónomos. Sus probables consecuencias no competen ni a astrónomos ni a físicos, sino que pertenecen a la esfera de psicólogos y sociólogos.
En este breve panorama de algunos de los problemas y retos con que se enfrentan los astrónomos, terminaremos con las regiones más externas del Universo. Explicamos por extenso, en el capítulo 10, las dificultades que afrontan los investigadores de las galaxias, tales como el problema de la «masa desaparecida» y los terriblemente potentes quásares que albergan algunas galaxias. Tampoco está aún resuella la formación de las galaxias.

Las naves espaciales Pioneer 10 y 11, ahora fuera del sistema solar, llevan esta tarjeta de visita interestelar. Los círculos (arriba) representan átomos de hidrógeno; las líneas radiales (centro), las direcciones de ciertos púlsares desde el Sol; la hilera de círculos (abajo), el Sol y los planetas. Los dibujos (derecha) pueden ser comprensibles al menos en parte para una cultura ajena.
Aquí habrá de prestar su ayuda la radiación de fondo de radio. Este tenue susurro del espacio bien podría contener el secreto de algunas de las más arduas cuestiones que nos planteamos acerca del Universo. Ya se ha demolido la teoría del estado estable, esa elegante teoría cosmológica que afirmaba que el Universo siempre es el mismo. Continuamente se construyen instrumentos más perfeccionados, con el propósito de medir lo uniformemente «brillante» que es el cielo (en términos de radio), Los astrónomos esperan que haya extensiones un poco más calientes, y otras algo más frías; pues el gas no permaneció uniforme, sino que se agrupó en nubes que finalmente se colapsaron en galaxias. Hasta ahora nadie las ha descubierto, pero, en cualquier caso, nos dirían algo acerca de cómo se formaron las galaxias.
Dejando de lado este posible remiendo a pequeña escala de la radiación de fondo, hay razones para sospechar que no puede existir la misma temperatura en todo el cielo. Recuérdese que nuestra cosmología mostraba que el espacio se expande como la masa entre las pasas di' un creciente pastel de frutas. El fondo de radiación nos llega desde todas partes; y podríamos esperar que todo permanece a la misma temperatura sólo si estuviéramos en reposo relativo con respecto al espacio que nos rodea, es decir como si fuéramos una pasa que no se mueve a través del pastel. Pero en el Universo real no estamos en reposo. Incluso si nuestra Galaxia fuese lija respecto a su espacio local, el Sol transporta al sistema solar a unos 250 kilómetros por segundo, y el fondo parecerá más caliente en la dirección en la que el Sol se dirige. Los cálculos han demostrado que la variación debería ser de únicamente unas cuantas milésimas de grados en la temperatura del fondo, pero en 1977 un sensible receptor de radio instalado en un avión U-2 captó una variación. El cielo parece estar ligeramente más «caliente» en la dirección de la constelación de Leo.
Desgraciadamente, osa no era la dirección que los astrónomos habían predicho. Si tomamos el resultado como valor nominal y permitido por el movimiento del Sol, resulta que nuestra Galaxia atraviesa rápidamente su espacio local a la asombrosa velocidad de 600 kilómetros por segundo. De hecho, todo el grupo local de galaxias tendría que hallarse en movimiento a esta alta velocidad; y lo mismo debería sucederle a nuestro inmenso cúmulo de galaxias vecino en la constelación de Virgo. A los astrónomos no les satisface este resultado. La mayor parte de las mediciones anteriores habían sugerido que cada galaxia está bien «fijada» a su zona local del espacio. (Aunque las galaxias distantes se separen unas de otras, esto sólo ocurre así porque se expande el espacio entre ellas.) Si posteriores experimentos confirman este primer resultado, habrá de alterarse la opinión de los astrónomos acerca del modo en que se relacionan las galaxias y el espacio que las rodea.
Stephen Hawking ha mostrado que el fondo de radiación uniformemente repartido prueba que el Universo como conjunto no está girando. Si situásemos un giróscopo tal el espacio, apuntaría siempre en la misma dirección. Hawking demostró asimismo que, en relación con tal giróscopo, el Universo ha girado, en su vida media de 15.000 millones de años, un ángulo menor que una millonésima del diámetro aparente de la Luna. Algunas teorías cosmológicas relacionan la dirección que señalan constantemente los giróscopos y nuestras ideas de inercia resistencia a la aceleración con las masas lejanas del Universo; y el resultado de Hawking es buena evidencia de que puede ser así. De esta forma se hace patente el hecho de la observación astronómica moderna acoplada con las teorías de la física.
§. El principio antrópico
Hemos concentrado este libro en las fronteras obvias del conocimiento: lo muy grande y lo muy pequeño. Sin embargo, la investigación científica no se centra únicamente en los extremos. Por ejemplo, los físicos también estudian cómo se comportan los átomos en los sólidos y en los líquidos; y de este tipo de investigación surgen dispositivos como los transistores y los circuitos integrados, que están transformando nuestras vidas cotidianas. Los químicos investigan cómo cambian las moléculas durante el curso de una reacción química y cómo, asimismo, producen una amplia variedad de nuevos productos.
Desde un punto de vista «ortodoxo» extremo, esta investigación es de nivel muy intermedio. Sólo interviene la relativamente bien conocida fuerza electromagnética; las únicas partículas son los núcleos atómicos y sus electrones, otra vez amigos. ¿Qué hay tic nuevo o qué hay que averiguar aquí? Realmente, la respuesta se encuentra en la complejidad de las interacciones que tienen lugar ruando se agrupan los átomos. 'Teóricamente, sería posible predecir el resultado de cualquier reacción química calculando todas las fuerzas existentes entre todos los núcleos y electrones que intervienen; pero en la práctica esto se sitúa mucho más allá del alcance de los más modernos ordenadores. Resulta más sensato dejar que la Naturaleza efectúe estos cálculos en su forma habitual, mezclándose los componentes de dos tubos de ensayo y estudiando los resultados.

Los cráteres del meteorito de Henbury, en Australia, devastación originada por la caída de restos interplanetarios. En una reciente y controvertida teoría, sil Fred Hoy le y Chandra Wickramasinghe sostuvieron que la vida fue traída a la Tierra desde el espacio en pequeños granos meteoríticos. Estas controversias son esenciales para La ciencia, pues obligan a los científicos a reexaminar sus evidencias y sus interpretaciones.
En las ciencias biológicas, la complejidad ha ido incluso más allá de cualquier esperanza de cálculo. Como vimos en el capítulo 5, hay excesivas reacciones involucradas, y todas interrelacionadas; los bioquímicos se hallan todavía en el estadio de procurar descifrar los secretos de la vida. Aun cuando los experimentos que emplean materiales de la Naturaleza nos brindan la oportunidad de forjar la ingeniería genética, ésta supone en verdad sólo lo que su denominación implica: ocuparse de las partes que las células ya han proporcionado. Algunas de las moléculas más simples de la vida, como la insulina, pueden sintetizarse en el laboratorio (en un futuro veremos que se producen muchas más); pero la posibilidad de construir una célula viva de la nada está lejos de nuestro alcance. Y si, en efecto, pudiéramos lograrlo, se trataría de una mera copia de lo ya hecho por la Naturaleza. Planificar un nuevo programa de vida, utilizando distintas moléculas y procesos diferentes a los de la Naturaleza, es algo que se sitúa más allá de nuestra imaginación.
Gomo ya hemos visto, las criaturas vivas tienen una evolución algo extraña en el Universo. A partir de elementos sencillos, reforzados mediante algo tan exótico como la fuerza electromagnética, la vida ha evolucionado hasta sistemas de tremenda complejidad. Y no sólo como una mezcla compleja al azar: los procesos de la vida constituyen el culmen de la organización. Los millones de moléculas de cada célula están dirigidos para actuar al unísono: para contraer un músculo, para portar un mensaje eléctrico, para alimentar, para reproducir. En cierto modo, todos los procesos gobernados por el ADN central y ejecutados por las proteínas han creado agregados maravillosos de materia en nuestro planeta, materia que está viva: el encantador donaire de un abeto de Douglas; la llamativa belleza de una libélula; los pensamientos y los sueños del homo sapiens.
De hecho, todo es sumamente maravilloso: la vida parece realmente milagrosa cuando la contemplamos desde el contexto del Universo. Así pues, deben de haberse dado muchas «coincidencias» para que la vida pueda existir. Las fuerzas de la Naturaleza tienen que estar equilibradas, tal como los quarks constituyen los protones estables y los neutrones de los núcleos son estables para mantener a los protones frente a sus mutuas repulsiones eléctricas. La acción recíproca de las fuerzas fuerte y electromagnética en los núcleos tiene que ser así para asegurar que los núcleos más pequeños sean estables, al menos durante miles de millones de años. Y debe de haber otras partículas que no experimenten la fuerza fuerte y puedan, por consiguiente, situarse en órbita en tomo al núcleo sin ser arrastradas por él; estas partículas, los electrones, tienen que tener asimismo un «principio de exclusión» que los mantenga en órbitas diferentes; si todos los electrones pudieran hallarse en la órbita más pequeña, todos los elementos tendrían idénticas propiedades químicas.

¿Implosión o explosión? A pesar de tratarse de una de las galaxias anormales más próximas, la controversia sobre la apariencia distorsionada de M82 aún entusiasma. Únicamente mas observaciones, con nuevas técnicas, pueden resolver estas disputas astronómicas. (Copyright del Instituto de Tecnología de California y la Institución Carnegie de Washington. Reproducido con permiso de los Observatorios Hale.)
Tiene que existir una disposición particular de electrones en un elemento, el carbono, que le permita formar las largas cadenas indispensables para los complejos procesos de la vida.
Y así, suma y sigue. Si no existiera la fuerza débil, el Sol no hubiera podido mantenerse brillando el tiempo suficiente para que la vida evolucionara. Si el propio Big Bang se hubiese atenido al ideal de los teóricos y hubiera contenido cantidades exactamente iguales de materia y antimateria, no habría existido materia después de haberse enfriado hasta el punto de aniquilación; y el Universo de hoy sería aburrido, sólo consistiría en radiación...
Pero dejemos esta especulación. Si el Universo difiriese, aunque sólo fuera ligeramente, en la intensidad de sus fuerzas, o en cifras como las de la constante de radiación de Planck, la vida no habría aparecido y nosotros no estaríamos aquí. Explicar o comprender un milagro no implica necesariamente que sea menos maravilloso. Los investigadores científicos no son menos «religiosos» que cualquier otro grupo de hombres; cuando alguien se enfrenta día a día con las maravillas del Universo, resulta natural experimentar un sentimiento de temor.
Existe además otra manera de apreciar el notable orden del Universo, su curiosa propiedad de admitir vida e inteligencia. Supongamos un número infinito de universos. Si nuestro Universo oscila perpetuamente desde el «Big Crunch-Bang» hasta el «Big Crunch-Bang», podríamos imaginar que los demás universos tienen ciclos de existencia anteriores o posteriores a los nuestros. Sin embargo, incluso si nuestro Universo es «abierto», podría haber fuera otros universos tridimensionales en una cuarta dimensión; no podemos imaginarlo, pero es algo tan posible como apilar hojas de papel «bidimensional» en una tercera (altura) dimensión.
Ahora bien, cada uno de estos universos podría poseer diferentes leyes físicas, partículas fundamentales distintas y diferentes fuerzas.

Una galaxia espiral, NGC 4X5, vista de canto. Tanto las observaciones astronómicas como las de física fundamental muestran un orden básico en el Universo. Las complejidades tienen lugar a una escala intermedia, pues la complejidad es esencial para la existencia de seres inteligentes como el hombre. Fotografía de los observatorios Monte Wilson v Palomar.
Y la gran mayoría de ellos serían un caos total; sólo en unos cuantos, entre todos estos universos, la estructura inicial de la Naturaleza habría sido tal como para permitir que resplandeciesen las estrellas y se diesen todas las demás «coincidencias» antes mencionadas que requiere la vida. Por consiguiente, cualquier universo en el que evolucionara la vida habría de ser ordenado, con un determinado equilibrio crítico de fuerzas y partículas. Según este «principio antrópico», no es coincidencia el que vivamos en un Universo ordenado.
Además, ahora contamos con la fascinante posibilidad de predecir algo acerca del Universo, simplemente por el hecho de estar en él. Hasta el momento, estas predicciones han sido retrospectivas, pero astrónomos y físicos han señalado que habríamos sido capaces de predecir hechos ahora conocidos. Kl físico americano Robert Dicke fue el primero en mostrar que el Universo debe de ser «muy grande» —la distancia que pueden alcanzar los astrónomos debe de ser de varios miles de millones de años luz sólo por el hecho de encontrarnos aquí. Para los complejos procesos de la vida necesitamos elementos más pesados que el hidrógeno y el helio del Big Bang. Como éstos se forjan en las estrellas, y sus vidas medias son aproximadamente de un millar de millones de años, el Universo tiene que haber estado expandiéndose durante este tiempo para que la vida apareciera.
Stephen Hawking y sus colegas divulgaron el principio antrópico en los círculos astronómicos. Estaban particularmente intrigados por el fondo uniforme de ruido de radio. Por dondequiera que se mire, el fondo de radio se halla a la misma temperatura (ignorando el movimiento de nuestra Galaxia). Así, en la época en que la radiación abandonó el gas inicial, cuando la edad del Universo era solamente de alrededor de un millón de años, las diferentes partes del Universo que vemos en el cielo estaban a más de un millón de años luz unas de otras. Cada parte del gas ignoraba la temperatura que tenía el resto, y era de esperar que el cielo variara bruscamente de temperatura de un lugar a otro.
Stephen Hawking y Harry Collins arguyen que sólo en aquellos escasos universos en los que ocurrió que todo el gas estuviese a igual temperatura pudieron formarse galaxias; y sin galaxias no habría habido estrellas, ni planetas, ni vida. «Desde esta perspectiva», sostienen, «el hecho de que observemos que el Universo es isótropo sería simplemente un reflejo de nuestra propia existencia».
§. El viaje inconcluso
Los investigadores que emplean sus vidas en tratar de responder, aunque más no fuere, a una fracción de nuestras cuestiones, tienen mucha tarea por delante. Cualquiera que sea el campo de investigación, existe la emoción de encontrar algo nuevo. Aunque sólo sea un descubrimiento muy pequeño, un científico puede llegar a pensar; «He sido el primero en conocer tal o cual cosa acerca del Universo.»
La ciencia ofrece tanta satisfacción intelectual y personal como cualquier otra actividad humana, Y es un campo en el que cualquier esfuerzo, por pequeño que sea, acaba siendo compensado. En música resulta relativamente simple escribir una buena melodía; se le da vueltas hasta adaptarla o incluirla en determinada estructura. Hay compositores que opinan que tan pronto como una pieza está escrita, se pierde la idea puramente musical. Por (-I contrario, en ciencia, una idea o una observación crucial de un científico puede encontrar su realización en el trabajo de otro. La ciencia implica una búsqueda mucho más social que la de componer o escribir, ya que la colaboración y la discusión de las ideas constituyen su alma.
El dominio de la ciencia se ha ensanchado gradualmente, hace cincuenta años habría parecido absurda la idea de que pudiéramos observar el interior del protón, hablar acerca de la primera centésima de segundo de la existencia del Universo, manipular el material hereditario de nuestras células o viajar a la Luna. Sin embargo, un dominio que la ciencia sólo ha hollado ligeramente es el de la actividad de nuestra mente. Las incursiones en la psicología, las ciencias del comportamiento y la bioquímica del cerebro reducen paulatinamente nuestro propio desconocimiento, tanto como los intentos, cada vez más frecuentes, en el terreno de la parapsicología; y ello, pese a que la mente humana es un emplazamiento terriblemente complicado. En ella se encuentra todo lo que no es «ciencia»: amor, alegría, éxtasis, las más íntimas emociones, así como los misteriosos estados de trance y —¿tal vez?— la energía psíquica. La acción recíproca entre la deducción científica y estos rasgos fundamentalmente humanos promete ser un drama fascinante. Hasta podríamos retroceder a las actitudes de los pueblos antiguos, que no distinguían entre ciencia y filosofía.
¿Tan lejos hemos llegado desde Empédocles, con su simple mundo de cuatro «elementos» y dos «fuerzas»? En términos prácticos, un camino muy largo. Nuestro progreso en el conocimiento de la materia nos ha traído electricidad a nuestros hogares, fuentes de energía situadas mucho más allá de la comprensión de Empédocles, nuevos materiales, tecnología para explorar el espacio; de hecho, todos los avances que hacen que nuestro mundo sea tan diferente al de los antiguos griegos.
Sin embargo, al diseccionar la materia en sus constituyentes más menudos, hemos dejado atrás el sentido común. En contraposición con la tierra, el agua, el aire y el fuego de Empédocles, carecemos de una sensación instintiva de los quarks y de los leptones; al parecer, éstos se comportan de formas tan extrañas que los físicos sólo pueden expresarlos sensiblemente mediante ecuaciones matemáticas. No nos emocionamos ante las unidades básicas que constituyen nuestro Universo; incluso pensamos que es realmente sorprendente que su dominio sea tan diferente en tamaño del nuestro. A pesar de todo, cuando los físicos intentan explicar las partículas y las fuerzas como continuación de un «orden» y un «desorden» fundamental, surgen sorprendentes reminiscencias con las «fuerzas» de Empédocles de amor y odio, traducidas a veces en términos de «contienda».
Nosotros ocupamos un terreno neutral. Cada cual constituye una interacción entre las fuerzas y las partículas fundamentales de la Naturaleza, entidades que no podemos comprender intuitivamente, pero que se agrupan de a trillones para constituir el mundo y constituirnos. De una forma casi mágica, la falta de lógica de lo infinitamente pequeño construye la lógica del mundo cotidiano.
Somos una minúscula parte de un Universo infinito, motas insignificantes sobre un pequeño planeta en órbita alrededor de una estrella inedia en una galaxia típica. Al contemplar una clara y estrellada noche sentimos lo remoto que es el resto del Universo, y lo pequeño que es el hombre. Pero somos inteligentes: con diligencia y rigor hemos sondeado el Universo, desde lo inimaginablemente pequeño hasta lo que está infinitamente más allá de nuestro entendimiento. Sin embargo, la ciencia continúa requiriendo nuevas respuestas a nuevos interrogantes. Estamos a punto de descubrir el armazón que liga i o muy pequeño con lo excesivamente grande; el telón comienza a alzarse. Respondemos así a las antiguas cuestiones; comenzamos, aunque sólo sea en cierta medida, a comprender el Universo.
| aceleración | Rapidez con que aumenta la velocidad; es decir, incremento de velocidad por unidad de tiempo |
| acelerador | Física: dispositivo que aumenta por medio de un campo eléctrico la energía cinética (movimiento) de una partícula, |
| ADN | Acido desoxirribonucleico. Moléculas en forma de largas hebras que almacenan la información genética; se encuentran en los cromosomas del núcleo celular. |
| agujeronegro | Cuerpo tan condensado que su velocidad de escape es mayor que la velocidad de la luz, de forma que no puede escapar nada que caiga en él, ni siquiera la luz. Los agujeros negros pueden originarse en la última etapa de la evolución de una estrella; los mayores pueden aparecer en los centros de las galaxias, y los muy pequeños pueden haber sobrevivido desde el comienzo del Universo |
| alquimia | Arte precientífico que floreció desde aproximadamente el año 500 dC hasta finales del Medievo, y que pretendía transmutar metales básicos en oro, lograr la inmortalidad humana, etc., por medio de la astrología, el misticismo y lemas afines. Es la antecesora de la química moderna |
| aminoácidos | Grupo de unos veinte ácidos que se presentan en la Naturaleza y que se unen para formar cadenas llamadas proteínas. Son esenciales para la vida; aunque los aminoácidos esenciales son específicamente aquellos que el organismo no puede sintetizar y debe obtener de su entorno (ocho en el hombre |
| anillo de almacenamiento | Dispositivo empleado en física de partículas que mantiene a las partículas circulando para generar haces de altas intensidades. |
| antimateria | Materia compuesta de antipartículas |
| antipartícula | Partícula que tiene la misma masa, pero características (carga eléctrica, etc.) exactamente opuestas a su correspondiente «ordinaria». Guando se encuentran una partícula y su antipartícula, se aniquilan instantáneamente liberando energía. |
| año luz | Distancia que recorre la luz en un año. Se utiliza para medir las grandes distancias fuera de nuestro sistema solar. ARN Acido ribonucleico. Sustancia de la célula viva que recoge y transfiere la información hereditaria almacenada en el ADN. |
| asteroide | Uno de los miles de planetoides, o planetas menores el mayor de apenas 1,000 kilómetros de diámetro— situados en órbita alrededor del Sol entre las órbitas de Marte y Júpiter |
| astrofísica | Rama de la astronomía a la que incumbe la composición de los astros, así como la interacción entre materia y energía en su interior y en el espacio que los rodea |
| astrología | Antiguo arte de predecir el destino humano mediante la observación de los astros. |
| astronomía | Estudio de los astros, de sus posiciones relativas, de su movimiento y de su naturaleza |
| átomo | Parte más pequeña de un elemento. |
| barión | Tipo de partícula subatómica, como el protón o el neutrón, de peso relativamente alto y compuesta por tres quarks |
| binario | Dual; que se refiere a un par. Astronomía: sistema de dos astros que giran alrededor de su centro de gravedad común, es decir una «estrella doble». |
| biología | Estudio de la vida. Tiene dos ramas fundamentales, botánica y zoología (plantas y animales), así como otros temas conexos. |
| bioquímica | Química de la materia viva, una especialidad de la biología. |
| blanco | Luz blanca: una luz que se puede descomponer en lodos los colores del espectro. Agujero blanco: teóricamente opuesto a agujero negro, una fuente de energía que en la actualidad se piensa que no existe. Enana blanca: estrella pequeña y densa de baja luminosidad; a causa de su pequeño tamaño es muy caliente y por ello aparece blanca |
| bomba atómica | Arma basada en el principio de la fisión, en la que se retinen tíos masas de un material fisionable adecuado, cada una menor que una masa crítica. La masa total es mayor que la masa crítica necesaria para la fisión nuclear, y da lugar a una reacción en cadena incontrolable que libera grandes cantidades de energía. |
| bomba de hidrógeno | La bomba termonuclear (bomba de hidrógeno, o bomba H: es un dispositivo de fusión nuclear. Comprende una bomba de fisión rodeada por un recubrimiento de isótopos de hidrógeno (y a veces de litio); la explosión de la bomba de fisión origina temperaturas extremadamente altas, que dan lugar a la fusión de los núcleos de hidrógeno para formar núcleos de helio liberando cantidades de energía aún mayores. |
| campo | Campo de fuerza: región del espacio en la que una fuerza actúa entre dos o más cuerpos. Un cuerpo con masa tiene un campo gravitatorio, pero puede también tener un campo eléctrico y/o magnético; la fuerza nuclear crea «campos» sólo a distancias subatómicas. |
| capa electrónica | Término empleado en mecánica cuántica para designar las series de círculos concéntricos descritos por los electrones cuando se hallan en órbita en torno al núcleo a distintas distancias. |
| carga | Carga eléctrica es la cantidad de electricidad (estática) de un cuerpo. De la materia ordinaria que contiene un número igual de electrones y protones se dice que es eléctricamente neutra, pero de la que contiene un exceso de electrones se dice que está cargada negativamente (o positivamente, si es deficitaria en electrones). Aun cuando esta terminología es arbitraria, la carga eléctrica es una propiedad básica de las partículas fundamentales que constituyen la materia. |
| célula | Unidad más pequeña de la vida. Los microorganismos, como las bacterias, sólo constan de una célula, mientras que un ser humano está compuesto de casi un billón de células |
| cero absoluto | La temperatura más baja teóricamente posible. Se escribe OK (cero Kelvin), y es igual a —273,15 °C |
| coherente | Referido a la radiación electromagnética: cuando todas las ondas presentan una relación fija de fase, como ocurre en un haz de láser, pero no en la luz ordinaria |
| cometa | Nube gaseosa que rodea a un pequeño núcleo de hielo sólido y que sigue una órbita alargada en torno al Sol, Los cometas más brillantes tienen una cola que siempre apunta hacia el Sol. |
| compuesto | Referido a lentes: sistema que consta de más de una lente. En química: sustancia que contiene dos o más elementos cuyos átomos están ligados por enlaces químicos |
| conservación | En física, principio que expresa que la cantidad total de energía, momento, etc., de cualquier sistema que no esté sometido a acciones externas permanece constante. Por ejemplo, la ley de conservación del momento establece que el momento de dos cuerpos antes del choque es igual a su momento total después del choque. La ley de conservación de la materia, que establece que la materia no se puede crear o destruir, ha sido modificada a partir de Einstein. Las teorías de éste han dado Jugar a la ley de la conservación de la masa y la energía, que establece que la suma total de la energía y de la masa multiplicada por el cuadrado de la velocidad de la luz (masa-energía) es constante para cualquier sistema. |
| constelación | Grupo de estrellas que representan una figura en el cielo, por ejemplo Scorpius, el Escorpión. Aun cuando ahora se sabe qué las estrellas que constituyen una figura están normalmente a distancias muy diferentes, todavía se utilizan las constelaciones para describir la localización de un objeto en el cielo. |
| corriente | Movimiento de cargas eléctricas a través de un conductor; se mide en amperios (A;. La corriente eléctrica se debe al movimiento de electrones cargados negativamente en el conductor. |
| corrimiento hacia el rojo | Aumento en la longitud de onda de la luz (que la hace más roja) de las estrellas y galaxias que se alejan de la Tierra a altas velocidades. También se lo denomina corrimiento Doppler. |
| cósmico | Se refiere al Universo, para distinguirlo de la Tierra |
| cosmología | Estudio del origen, historia y naturaleza del Universo. |
| cristal | Sustancia solidificada en una forma geométrica definida. En esta forma se pueden obtener las sustancias más puras; los sólidos que no forman cristales se denominan amorfos. La disposición característica de los átomos en un cristal se denomina red |
| cuanto | La unidad más pequeña posible de energía. Los cuantos de energía electromagnética también se denominan fotones. La teoría cuántica establea: que la energía se presenta en cuantos en vez de en forma continua; fue propuesta a principios de este siglo por Max Planck (1858-1947). |
| densidad | Masa por unidad de volumen. Cuando se mide en gramos por centímetros cúbicos es la gravedad específica de una sustancia. |
| desintegración | De una sustancia radiactiva, su transmutación en otra sustancia. También, la disminución de intensidad de radiactividad cuando tiene lugar la transmutación. En relación con partículas subatómicas, la transformación de partículas inestables en otras más estables. |
| discreto | Separado, distinto; por ejemplo, la radiación electromagnética se emite en cuantos ¡paquetes; discretos llamados fotones. |
| efecto Doppler | Aparente aumento de la frecuencia de las ondas luminosas o' sonoras procedentes de un objeto que se aproxima, o la disminución cuando el mismo se aleja |
| electricidad | Término general que se emplea para fenómenos ocasionados por la carga eléctrica, estática (véase carga) o en movimiento (véase corriente). |
| electromagnetismo | Término general que describe los fenómenos eléctricos y magnéticos. Un dispositivo electromagnético utiliza ambos, como un motor eléctrico en el que la corriente que circula genera un campo magnético que origina el giro del rotor, o un generador ¡dinamo), en el que una energía externa hace girar al rotor y el campo magnético que resulta genera un flujo de corriente. |
| electrón | Partícula fundamental, de la familia de los leptones. Se halla en órbita en torno al núcleo en los átomos, crea enlaces químicos entre ellos, y su movimiento es responsable de los fenómenos eléctricos. |
| elemento | Sustancia que consta de átomos de la misma clase, |
| energía | Capacidad, o capacidad potencial, para realizar trabajo. Pueden existir diversas formas de energía, y convertirse unas en otras por medios adecuados. |
| energía de enlace | Energía que mantiene unido un núcleo atómico. Así, la suma de las masas de las partículas de un núcleo es mayor que la masa del núcleo; la diferencia es la energía de enlace, según Einstein, quien demostró que masa y energía son estados diferentes de la misma cosa. Por ello la energía de enlace se llamó inicialmente «defecto de masa». La energía de enlace es también la cantidad de energía que sería necesaria para descomponer el núcleo. Si todos los núcleos de hidrógeno de un vaso de agua se combinaran para formar núcleos de helio, se liberaría energía suficiente como para impulsar un transatlántico a través del Atlántico; desgraciadamente, aún no se ha desarrollado la tecnología que sería necesaria para lograr una reacción de fusión controlada. |
| enlace | Unión de los átomos en una molécula, ocasionada por algún tipo de transferencia de electrones. También se la llama enlace de valencia. Algunos átomos, como el carbono, pueden originar tanto enlaces sencillos como dobles o triples |
| enrarecimiento | Reducción de presión que da lugar a que una sustancia sea menos densa. Lo contrario de la compresión, |
| entropía | Medida del desorden o incapacidad para realizar trabajo. La entropía de un sistema cerrado siempre aumenta; esto es, la energía siempre pasa de un estado utilizable a uno no utilizable, pero nunca al revés. |
| enzima | Cualquiera de las complejas sustancias de las proteínas fabricadas por las células vivas y que facilitan los procesos químicos esenciales para la vida. Dado que no se transforman ni consumen en las reacciones químicas (como cualquier catalizador), son efectivas en cantidades muy pequeñas |
| equivalencia masa-energía | Relación matemática entre la masa y la energía que transforma una en otra. E = mc2, o energía es igual a la masa por la velocidad de la luz al cuadrado |
| espectro | Resolución o separación de las ondas electromagnéticas según su longitud de onda. Los ejemplos más conocidos son la selección de colores que se ven en un arco iris y cuando la luz pasa a través de un prisma. El espectro electromagnético se extiende desde las ondas de radio de larga longitud de onda hasta los rayos gamma de longitud de onda torta |
| espectro de absorción | Espectro de líneas o bandas que se produce cuando la luz pasa a través de un gas en un espectroscopio. Las líneas se relacionan con el espectro de emisión del gas |
| espectro de emisión | Espectro que se obtiene cuando la luz procedente de un gas incandescente se examina por medio de un espectroscopio; consiste en líneas brillantes sobre un fondo negro |
| espectroscopia | Ciencia que analiza el espectro electromagnético de un objeto. |
| estado de energía | Configuración de un átomo, núcleo, ele., que tiene una energía determinada. La teoría cuántica sólo permite ciertos estados de energía; en el caso de los electrones de los átomos, son los que corresponden a órbitas de tamaño diferente. |
| estrella de neutrones | Cuerpo pequeño y denso formado en la última etapa de la evolución de una estrella masiva, cuando ha consumido todo su combustible nuclear y se colapsa debido a la gravitación, llegando a ser tan densa que sólo contiene neutrones. Las estrellas de neutrones en rotación emiten pulsos de radio y son conocidas como pulsares. |
| evolución | Biología: teoría según la cual las especies se originan por mutaciones genéticas accidentales, algunas de las cuales son beneficiosas y permiten la supervivencia de las más aptas a expensas de la original. Astronomía: cambio que experimenta una estrella, galaxia, etc., cuando envejece |
| excitar | Adición de energía a un núcleo, átomo o molécula que cambia su estado de energía. |
| fase | Estado del movimiento de una onda; dos puntos están en fase si sus ciclos tienen lugar en la misma dirección al mismo tiempo. |
| física | Estudio de los diferentes estados de la materia, incluyendo la energía. |
| fisión | División, como en la fisión nuclear, en la que un núcleo pesado se divide en dos más pequeños liberando energía (véase energía de enlace). |
| forma de vida | Forma de la materia que incluye compuestos complejos de carbono y que experimenta una continua evolución; lo que nosotros llamamos «vivir». |
| fotón | Partícula de energía electromagnética que tiene masa cero y se desplaza a la velocidad de la luz. En algunas facetas de su comportamiento debe ser considerada simultáneamente como onda y como partícula subatómica. También transporta la fuerza electromagnética, como una partícula virtual |
| frecuencia | Número de repeticiones de un ciclo en un tiempo dado. Por ejemplo, la frecuencia de la corriente alterna es de 50 Hz (ciclos por segundo) en el Reino Unido, y de 60 H z en Norteamérica. |
| fuerza | Agente exterior capaz de modificar el movimiento de un cuerpo. Según la física moderna, existen en la Naturaleza cuatro fuerzas: la fuerza electromagnética, la gravitación y las fuerzas nucleares fuerte y débil. Se considera que estas fuerzas son manifestaciones diferentes de una única fuerza básica, y su unificación constituye una de las metas de la física moderna |
| fuerza nuclear débil | La más débil de las cuatro fuerzas de la Naturaleza, excluida la gravitación. Responsable de la forma de desintegración de las partículas. Se ha encontrado una relación teórica entre la fuerza nuclear débil y la fuerza electromagnética; éste es el primer paso hacia una teoría unificada tic todas las tuerzas. |
| fuerza nuclear fuerte | La más fuerte de las cuatro fuerzas de la Naturaleza, responsable del control de las interacciones de las partículas nucleares. Es cien veces más intensa que la fuerza electromagnética. |
| fusión | Derretimiento, o mezcla de sustancias derretidas; de aquí el uso del termino fusión nuclear, la combinación de núcleos atómicos de elementos ligeros para dar forma a otros más pesados. Si la energía de enlace del producto es mayor que la energía total de enlace de los dos átomos ligeros, parte de la masa aparece espontáneamente como energía (véase equivalencia masa-energía); éste es el proceso que tiene lugar en las estrellas y en la bomba de hidrógeno. |
| galaxia | Enorme cúmulo de estrellas ligadas gravitacionalmente, a menudo con gas y polvo interestelar. El Sol es una de las aproximadamente 10.000.000.000 de estrellas que constituyen una galaxia típica, llamada Galaxia de la Vía Láctea, o simplemente la Galaxia. |
| genética | Rama de la biología que trata de la herencia, las diferencias y las semejanzas entre organismos relacionados, y de su variación y evolución. |
| gigante | Estrella brillante de densidad media baja, varias veces mayor que el Sol. Un estado avanzado en la evolución de cualquier estrella. |
| gluón | Partícula que transmite la fuerza nuclear fuerte. La teoría actual postula ocho gluones, pese a que aún no se los ha detectado experimental mente. |
| gravedad | Específicamente, la fuerza gravitatoria que ejerce la Tierra sobre cualquier cuerpo situado dentro de su campo gravitatorio. |
| gravitación | Atracción de cada partícula de materia por cada una de las otras partículas. La gravitación es la más débil de las cuatro fuerzas conocidas, pero de gran importancia en astronomía. |
| hadrón | Clase de partículas subatómicas constituidas por quarks; incluye tanto a los bar iones como a los mesones |
| holografía | Método de registro y reproducción de una imagen tridimensional (holograma), que utiliza una placa fotográfica y dos haces tic luz coherente. Se registran las características ondulatorias de la luz en vez de la intensidad, como sucede en la fotografía ordinaria, |
| inercia | Tendencia de un cuerpo a permanecer en estado de reposo o de movimiento rectilíneo y uniforme |
| infrarrojo | Radiación electromagnética de longitud de onda ligeramente mayor que la de la luz. emitida por objetos calientes y que produce calor. |
| interferencia | Adición o combinación de ondas, como las sonoras o las electromagnéticas, liste fenómeno da lugar a «compases» adicionales en la interferencia musical, o a un «silbido» en un receptor de radio en el caso de interferencias de ondas de radio. |
| ión | Átomo o grupo de átomos eléctricamente cargados |
| isótopo | Una de las configuraciones de los átomos de un elemento que difiere en el número de neutrones del núcleo, pero que es químicamente idéntico. |
| isótropo | Que tiene las mismas propiedades físicas fibrana, etc.) en todas las direcciones. |
| kaón | Véase mesón. |
| láser | Siglas de Light Amplification by Stimulated Emission of Radiation (amplificación de la luz por emisión estimulada de radiación), un dispositivo que produce un intenso haz de luz coherente al excitar átomos para que emitan fotones de idéntica longitud de onda. |
| leptón | Una de las dos «familias» de partículas subatómicas básicas (la otra es la de los quarks). El leptón más importante es el electrón. |
| ley | De la Naturaleza: declaración que describe una secuencia inevitable de fenómenos o condiciones especificados. Las leyes científicas son generalizaciones basadas en muchos experimentos; pueden set refutadas o ampliadas, dependiendo de los resultados de experimentos posteriores. |
| libre | Química: elemento sin combinar, física: un electrón libre no está ligado a un átomo, pero puede moverse en un campo eléctrico aplicado. |
| longitud de onda | Distancia entre «crestas» sucesivas de una onda. |
| magnetismo | Un aspecto de la fuerza electromagnética. Las cargas eléctricas en movimiento producen, además de su fuerza eléctrica normal, una fuerza magnética; en un imán, la fuerza se debe a una descompensación del spin de los electrones en la órbita más interna de un átomo en un elemento. Normalmente se distribuyen de modo aleatorio; pero si están alineados, la sustancia es magnética. |
| magnitud | Sistema de clasificar las estrellas según su brillo aparente. |
| manchas solares | Grandes manchas oscuras sobre la superficie del Sol, que parecen cruzar su superficie cuando gira, y que se presentan en mayor número cada once años |
| masa | Cantidad de materia que contiene un objeto, o sea la cantidad de inercia. A diferencia del peso, la masa no varía por la acción de la gravedad. |
| máser | Siglas de Microwave Amplification by Stimulated Emission of Radiation (amplificación de microondas por emisión estimulada de radiación), un método de excitar los átomos para producir un haz coherente de una longitud de onda determinada. Se pueden utilizar dispositivos similares para producir un haz. de luz visible, en cuyo caso se denomina láser |
| materia | Lo que tiene masa; en otras palabras, lo que no es energía pura (como la radiación . |
| mesón | Clase de partícula subatómica que consta de un par quark-antiquark. Entre los mesones se encuentran el mesón-K (kaón), el mesón-pi (pión, etc. pero el mesón-mu muón) ha sido reclasificado como un leptón. |
| microondas | Radiación electromagnética cuya longitud de onda se halla entre las de las ondas de radio y las del infrarrojo |
| molécula | Combinación de átomos unidos por enlaces químicos; la parte más pequeña de una sustancia un elemento o un compuesto)., que conserva las propiedades químicas de esa sustancia. |
| momento | Masa multiplicada por velocidad |
| momento angular | Producto del momento de inercia por velocidad angular. El momento de inercia de un cuerpo respecto de un eje es la suma de los productos de la masa de cada demento del cuerpo por el cuadrado de su distancia a dicho eje; velocidad angular es el ángulo descrito alrededor del eje por unidad de tiempo. Véase también spin. |
| muerte térmica | El estado teórico del Universo en el que la entropía ya no puede aumentar: la energía o calón estará distribuida uniformemente, de forma que todo se hallará a igual temperatura. Predicha por el segundo principie) de la termodinámica, si el Universo es un sistema cerrado |
| muón | Partícula fundamental inestable uno de los leptones . 207 veces más pesada que el electrón. |
| nebulosa | Nube de polvo y gas en la que se forman las estrellas, |
| neutrino | Partícula fundamental (uno de los leptones) sin masa y sin carga, y muy difícil de detectar. Existen dos o tres tipos de neutrinos, asociados con el electrón, el mi ion y, posiblemente, con el recientemente descubierto lepton-tau. |
| neutrón | Partícula subatómica clasificada como un barión sin carga, que consta de dos quarks «abajo» y uno «arriba». Los neutrones se encuentran en los núcleos de lodos los átomos, excepto en el de hidrógeno. |
| nova | Estrella que arroja parte de su materia en forma de una nube de gas, haciéndose más luminosa durante la explosión. Se cree que las explosiones de novas se originan en una enana blanca de un sistema doble de estrellas próximas, |
| nuclear | Lo relacionado con el núcleo atómico; por ejemplo, reacción, explosión, fisión, fusión, etc. |
| núcleo | Física: parte central de un átomo que contiene prácticamente toda su masa, y que consta de protones y neutrones (excepto el de hidrógeno) y tiene carga positiva. Biología: parte central de una célula que contiene el ADN del material hereditario. Astronomía: centro de una galaxia. |
| onda | Perturbación periódica que transporta energía. Puede producirse en un medio, como el agua o el aire, o estar constituida por la propia energía, como la electromagnética, en cuyo caso puede propagarse en el vacío. El periodo (distancia entre ondas) se denomina longitud de onda |
| orgánico | Referido a los compuestos químicos: los que contienen carbono y están generalmente relacionados de alguna forma con los procesos de la vida. Algunos compuestos muy simples, como los carbonatos metálicos, quedan arbitrariamente excluidos. |
| paridad | Ley de conservación, también llamada propiedad de simetría espacial, que establece que no hay distinción entre izquierda y derecha en lo que concierne a las leyes físicas. Esta ley es violada por las partículas que reaccionan ante la fuerza nuclear débil. Esto fue probado por Chien-Shiung Wu en 1956: enfrió átomos de cobalto 60 hasta una centésima de grado del cero absoluto y los colocó en un campo magnético; sus núcleos emitieron la mayoría de los electrones hada arriba (con spin a izquierdas) en vez de hacerlo aleatoriamente hacia arriba y hacia abajo. |
| parsec | Unidad de medida de distancia astronómica igual a 3,26 años luz. Se basa en el fenómeno de paralaje, que es el desplazamiento aparente de un objeto originado por el cambio del punto de observación. |
| partícula | Término generalmente empleado para designar una partícula de tamaño subatómico, incluyendo cualquier partícula de las que constituyen los átomos {protón, neutrón, electrón, etc.;, otras que generalmente se observan por separado (fotón, neutrino, etc. y los quarks, de los que están constituidos los protones, los neutrones, etc., aunque aún no han sido observados experimentalmente. Todas las partículas subatómicas o «fundamentales» son, bien partículas de fuerza (por ejemplo, el fotón), bien leptones, o están constituidas por quarks |
| peso | Fuerza de la atracción gravitatoria sobre una masa, especialmente cuando ésta está sobre la Tierra. El peso de un cuerpo en otro planeta cambiaría, pero no así su masa |
| pión | Véase mesón. |
| plasma | Gas ionizado en el que la proporción de iones positivos y negativos es más o menos igual. También, el gas ionizado muy caliente (10.000.000 °C), en el que tiene lugar la fusión nuclear. El plasma es eléctricamente neutro y muy conductor |
| polarización | De la luz: vibración de las ondas transversales cicla luz en un plano particular en lugar de en uno cualquiera; pueden usarse algunos materiales como filtros de polarización que permiten pasar a la luz, cuyas ondas vibran en un cierto plano e impiden el paso de las otras. |
| polvo | Polvo cósmico, granos sólidos muy pequeños que se encuentran en el espacio interestelar. La absorción de la luz por estos granos interfiere la observación astronómica de objetos muy distantes. |
| positrón | Antipartícula del electrón; tiene la misma masa que el electrón, pero está cargada positivamente |
| principio | Regla científica general que gobierna los fundamentos en vez de los detalles, como lo hace una ley de la naturaleza; por ejemplo, el principio de incertidumbre de Heisenberg comparado con la ley de la conservación de la masa y la energía |
| principio de incertidumbre | Postulado por Werner Heisenberg: establece que, debido a la naturaleza dual (partícula-onda) de la materia, no se pueden conocer exactamente la posición y el momento de una partícula; cuanto más se conoce la posición, menos se conoce el momento. Similarmente, no se puede conocer la energía de una partícula en un instante determinado |
| prominencia | Nube de gas luminoso que se proyecta por encima de la superficie solar. |
| proteínas | Compuestos orgánicos complejos cuyas moléculas están constituidas por moléculas muy pequeñas de aminoácidos; son esenciales para toda la materia viva. Las plantas pueden sintetizarlas; los animales deben de hacerlo directa o indirectamente a partir de las plantas. |
| protogalaxia | Enorme nube tic polvo y gas en el proceso de formación de una galaxia. |
| protón | Partícula subatómica compuesta de tres quarks (dos «arriba» y uno «abajo»). Los protones se encuentran en cantidades variables en todos los núcleos atómicos y están cargados positivamente. |
| pulsar | Estrella de neutrones en rotación que emite ondas de radio, luz o rayos X. La emisión parece «pulsar» cuando la estrella gira. |
| quark | Una de las dos «familias» de partículas fundamentales; la otra es la de los leptones. Un esquema matemático llamado simetría unitaria un método de clasificar propiedades de comportamiento fue el empleado originalmente por Murray Gell- Mann para postular que las partículas fundamentales conocidas como bariones (protón, neutrón, etc.) y mesones estarían constituidas por sólo tres partículas dispuestas de letrinas diferentes. Sin embargo, ahora se conocen cuatro quarks («arriba», «abajo», «extraño» y «encantado»); otro («fondo» o «belleza») se ha encontrado en recientes experimentos; y se sospecha que existe un sexto («cima» o «verdad»). Los quarks aún no han podido ser aislados. |
| quásar | Objeto astronómico muy distante y fuertemente luminoso. Casi con seguridad, los quásares son centros muy activos de galaxias remotas. La fuente de energía es desconocida, pero puede tratarse de gas que incide en un gran agujero negro |
| química | Estudio de la composición de la materia y de los efectos de unas sustancias sobre otras. |
| radiación | Emisión a impulsos regulares o longitudes de onda concretas de ondas o partículas. La radiación electromagnética es una forma de energía que abarca desde las ondas de radio hasta los rayos gamma (de sustancias radiactivas), incluyendo la luz; es generada, detectada y clasificada según su longitud de onda. También debería existir la radiación gravitatoria, y en la actualidad se investiga sobre ello. |
| radiactivo | Adjetivo que describe el comportamiento de ciertos elementos pesados, cuyos núcleos están en proceso de desintegración y emitiendo partículas y radiación. En forma concentrada, esta radiación es perniciosa a causa de su energía extremadamente alta. |
| radioastronomía | Empleo de distintos tipos de receptores (en lugar de telescopios ópticos) para recoger información del espacio exterior en forma de radiación electromagnética de longitud de onda larga (ondas de radio). La energía recibida es extremadamente baja, y la ciencia comenzó hace sólo cincuenta años, pero la información es de un valor incalculable |
| radioisótopo | Isótopo radiactivo de cualquier elemento. Puede ser natural o producirse artificialmente. Se emplea como fuente de radiación en medicina, en la industria, etc. |
| radiotelescopio | Antena muy sensible utilizada en radioastronomía. Normalmente tiene la forma de un gran plato |
| rayo | Estrictamente hablando, camino a lo largo del cual viaja la radiación. También se usa para describir la propia radiación |
| rayos gamma | La radiación electromagnética de menor longitud de onda, emitida por los núcleos de los átomos radiactivos en los procesos de desintegración. Muy peligrosa a causa de su alta energía. |
| rayos X | Parte del espectro electromagnético que tiene mayor energía (longitud de onda más corta; que la luz y el ultravioleta, pero inferior a los rayos gamma. Tiene un efecto similar al de la luz sobre la película fotográfica, pero atraviesa la materia en una extensión que depende de la densidad y del peso atómico de la misma. Por ejemplo, resulta posible tomar fotografías de rayos X de los huesos de un ser vivo. La exposición prolongada a los rayos X puede ser peligrosa a causa de su alta energía |
| reacción | Química: interacción de dos o más sustancias que ocasiona cambios en ellas |
| red | Se emplea para designar la estructura regular de átomos en un sólido cristalino, por ejemplo red cristalina |
| refracción | Desviación de la luz (u otra radiación) cuando pasa de un medio a otro. |
| relatividad | Dos teorías propuestas por Einstein en 1905 y 1916, que han implicado la modificación de las leyes de la física. Basadas en el hecho de que la velocidad de la luz es siempre la misma, independientemente del movimiento relativo del observador, estas teorías describen cómo afecta el movimiento a la longitud, a la longitud, al tiempo y a la masa, e incluyen una nueva teoría de la gravitación. |
| resolución | Capacidad de una lente o de un conjunto de lentes para separar dos objetos muy pequeños. |
| singularidad | Centro teórico de un agujero negro, en el que la materia se comprime hasta que ocupa un espacio cero. Una teoría aún más esotérica postula una singularidad sin agujero negro que la rodee, en cuyo caso se llama singularidad desnuda |
| spin | Momento angular de partículas subatómicas que giran en torno a un eje contenido en ellas. Aparece en unidades discretas: los quarks y los leptones tienen spin un medio; y las partículas de fuerza, uno o dos. |
| supernova | Explosión de una estrella, un raro suceso en el que la estrella llega a ser mil millones de veces más brillante que el Sol. Cuando una estrella masiva agota su «combustible» nuclear, puede colapsarse a causa de su propia gravitación, con tal fuerza que origina altas temperaturas y reacciones termonucleares incontroladas. |
| tectónica de placas | Teoría del movimiento continental, que considera a los continentes como «balsas» que viajan sobre grandes placas que se deslizan sobre la Tierra |
| teoría | Idea —o sistema de ideas— basada en principios generales, pero que explica fenómenos específicos. Si aparecen nuevos fenómenos que no concuerdan con la teoría, ésta debe ser modificada o descartada, |
| termodinámica | Literalmente significa «movimiento del calor». Ciencia y estudio del calor, su transferencia, comportamiento, etc. Fundada por el físico francés Sadi Carnot (1796-1832). |
| termonuclear | Literalmente significa «calor del núcleo», y se utiliza para describir la fusión nuclear como opuesta a la fisión. Para la fusión se requiere una tempera tura muy alta |
| transmutación | Cambio de un elemento en otro. Una de las metas de la alquimia que después se asumió como imposible. Los elementos radiactivos lo hacen de forma natural, aunque minien lamen te, Es la base de la industria de la energía nuclear y de las armas nucleares. |
| transparente | Física: que permite que las ondas electro magnéticas pasen a su través. Por ejemplo, una delgada capa de hormigón es transparente a las ondas de radio, pero no a la luz. |
| ultravioleta | Energía electromagnética de energía mayor (longitud de onda más corta) que la luz, pero inferior a la de los rayos X en el espectro. |
| unidad astronómica | Distancia media desde el centro de la Tierra hasta el centro del Sol (1,495 × 1011 metros). |
| vacío | La completa ausencia de materia. No se conoce ningún vacío perfecto; incluso el espacio interestelar no es un vacío completo, pues contiene gas hidrógeno muy tenue |
| valencia | Capacidad ríe un átomo para combinarse con otros. Véase también enlace. |
| velocidad | Relación entre la variación del espacio y la variación del tiempo; se mide como longitud por unidad de tiempo, por ejemplo «kilómetros por hora». |
| vida media | De un elemento radiactivo: tiempo que tardan en desintegrarse la mitad de sus átomos. |
| virtual (partícula) | Partícula fundamental que transporta una fuerza. Por ejemplo, la fuerza electromagnética, considerada como tal y no como radiación, es transportada por fotones que son «virtuales» porque existen durante un tiempo demasiado corto para ser detectados. |
Para la preparación de este libro se han consultado diversos artículos de investigación, así como libros y revistas especializados. Entre las publicaciones particularmente útiles puede citarse:
- Annual Reviews of Astronomy and Astrophysycs
- Astrophysical Journal Physics Bullelin
- Quarterly Journal of the Royal Astronomical Society
- Sky and Telescope
- Gravitation, de C. W. Misner, K. S. Thorne y J. A. Wheeler (Freeman, 1973)
Los lectores que deseen mantenerse informados de los últimos descubrimientos pueden encontrar artículos recientes en New Scientist (Reino Unido) y Scientific American(Investigación y Ciencia es una edición en español de esta revista). Su lectura requiere, generalmente, un pequeño bagaje científico. Se pueden encontrar asimismo lecturas de aproximadamente el mismo nivel que el de este libro, pero que tratan con más detalle temas específicos, en los siguientes libros:
Astronomía general
- Constellations, de J. Klepstra y A. Rükl (Hamlyn, 1977)
- Norton's Sun Atlas, de A. P. Norton (Gall and Inglis, 1973)
- Cambridge Encyclopedia of Astronomy, editada por S. A. Mitton (Jonathan Cape, 1977)
- Partículas y fuerzas fundamentales Key to the Universo, de N. Galder (BBC, 1977)
Biografía
- Biographical Encyclopedia of Science and Technology, de I. Asimov Doubleday, 1964; Pan UK 1975)
La Tierra
- Restless Earth, de N. Calder (BBC, 1972) Futura, 1975
Estrellas y galaxias
- Violent Universe, de N. Calder (BBC. 1969; Futura. 1975
Cosmología
- The First Three Minutes, de S. Weinberg Deutsch, (1977). Hay edición en español (Alianza Editorial, 1978
Otros
- Radio Astronomy, de F. G. Smith (Penguin, 1975)
- Matter de R. E. Lapp (Time-Life Books, 1969;
- The Cell, de J. Pfeiffer (Time-Life Books, 1969)
- The Cosmic Comection, de C. Sagan (Hodder and Stoughton 1974)
- Signs of Life, de F Ridpath (Kestrel, 1978
Notas: